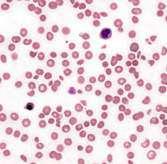
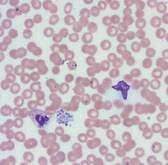
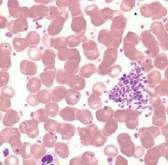

Náhle úmrtia



22 Dobrý sonografický prístroj je pre mňa najväčšie lákadlo I Rozhovor s MUDr. Dášou Viszlayovou aj o význame



robotickej rehabilitácie po náhlej cievnej mozgovej príhode 46 Ak chceme dieťa ochrániť, vstúpme do jeho online sveta | Výzvy na sociálnych sieťach 94 Akútne brucho
ako príčina smrti pri náhlych úmrtiach | Rozhoduje rýchla diagnostika a včasné terapeutické opatrenia
 časopis o laboratórnej diagnostike | 2. číslo, 11. ročník | jún/2023
časopis o laboratórnej diagnostike | 2. číslo, 11. ročník | jún/2023
Už 25 rokov prinášame najkvalitnejšiu laboratórnu diagnostiku vo všetkých odboroch.
Budeme v tom pokračovať naďalej.
www.unilabs.sk
inVitro 2. číslo, 11. ročník
júl/2023
Vydavateľ:
Unilabs Slovensko, s. r. o. Záborského 2, 036 01 Martin
IČO: 31647758
Adresa redakcie:
Unilabs Slovensko, s. r. o. Digital Park II, Einsteinova 23 851 01 Bratislava, Slovensko
Šéfredaktor:
Ing. Eva Šabová
Odborný garant:
MUDr. Jana Koporcová
Redakcia:
Ing. Eva Šabová
Ing. Josef Pazdera, CSc.
Jana Klimanová
Elena Akácsová
Danka Šoporová
MUDr. Antonín Polách
MUDr. Ivana Gondová, PhD.
Doc. MUDr. Mária Hulíková, PhD.
MUDr. Natália Vaňová, PhD.,MBA
MUDr. Pavol Fülöp
MUDr. Zuzana Jedináková, PhD.
MUDr. Arpád Panyko, PhD., MPH
MUDr. Ivo Topoľský, PhD., MPH
MUDr. Marek Brenišin, PhD.
RNDr. Vladimír Jurina
PharmDr. Slavomír Kurhajec, PhD.
MUDr. Igor Gaľa, PhD., MPH
Fotografie: Martin Giertl
Shutterstock
archív respondentov a autorov rozhovorov archív Unilabs Slovensko
Layout a grafický dizajn: Studio Milk
Tlač: printio, s. r. o.
Periodicita:
vychádza 3-krát ročne
Náklad:
1 500 ks, nepredajné
Copyright: Unilabs Slovensko, s. r. o., 2023
ISSN 1339-5912
Evidenčné číslo: EV 4948/14. Časopis je indexovaný v Bibliographia medica Slovaca a zaradený do citačnej databázy CiBaMed
InVitro je nezávislý časopis. Za obsah, pôvod, úplnosť, odbornú úroveň článkov, pravdivosť textov zodpovedajú výlučne ich autori, ktorých názory v článkoch sa nemusia zhodovať s názorom vydavateľstva alebo redakcie.
Pripomienky a podnety môžete zasielať na invitro@unilabs.com

Milí priatelia,
v súvislosti s pandémiou covidu, ale aj v súvislosti s pretrvávajúcou vojnou v susednej krajine či s nedávnymi prírodnými katastrofami, sme si možno trochu viac zvykli hovoriť a aj počúvať o smrti. Znamená to, že sme sa s jej prítomnosťou zžili alebo sa degradovala jej „sila“? Nemyslím si. Skôr mám pocit, ako keby sme sa navonok obrnili, tvárili sa, že sa nás netýka, no vnútorne akumulujeme bolesť či iné súvisiace emócie. Ako to z dlhodobého hľadiska vplýva na ľudskú psychiku, možno vedia odpovedať odborníci.
Hlavnou témou tohto čísla sú náhle úmrtia. Neraz sa stane, že smrť nastane náhle u zdanlivo úplne zdravého pacienta. Môže za to viacero faktorov. Samozrejme, môžeme k nim počítať aj pandémiu a s ňou spojenú inak poskytovanú zdravotnú starostlivosť, ale sú tu aj trendy, ktoré pandémia iba posilnila. To platí napríklad pre zlú životosprávu, ale významný je aj trend dlhodobo klesajúceho záujmu o preventívne prehliadky vrátane tých špecializovaných, ako sú mamografie či kolonoskopie. Pričom štatistiky zo Slovenska hovoria, že nádory sú druhou najčastejšou príčinou úmrtí.
Dá sa náhlym úmrtiam vôbec predchádzať? Ako som už spomenul, v niektorých prípadoch by určite prospela prevencia a lepšia diagnostika pacientov. Pitva totiž nezriedka odhalí jasnú príčinu náhleho úmrtia, ktorej sa dalo ľahko predísť. Preto je namieste permanentne pacientov edukovať, aby o seba dbali, hoci zdanlivo nepociťujú žiadny problém. Čoraz viac dostupná skríningová diagnostika z krvi nahrádza v prvom kroku množstvo invazívnych vyšetrení, z ktorých mali ľudia ešte donedávna obavy. Často zaúraduje aj pohodlnosť – veď povedzme si úprimne, kapacity slovenského zdravotníctva nie sú nafukovacie a predlžujú sa aj čakacie doby u lekárov. Mnohí pacienti preto radšej na preventívnu prehliadku nejdú, lebo to jednoducho dlho trvá. K lekárovi sa vyberú, až keď ich dotlačí neodkladný subjektívny problém, ak vôbec návštevu stihnú.
A asi mi dáte za pravdu, že pre ľudí, ktorí pracujú v zdravotníctve, či už v diagnostike, alebo v iných odboroch, je zrejme najhorším poznanie, že ak by bola reakcia včasnejšia, mohlo sa zachrániť o pár životov
viac. Či už sa to týka rýchleho prevozu pacienta, alebo odberov a ich vyhodnotenia, prípadne určenia správnej diagnózy a stanovenia efektívnej liečby.
Naša úloha ako siete laboratórií začína v momente, keď je odobratá vzorka, respektíve keď je pacient indikovaný na odber u nás. Bez toho laboratóriá nevedia podať pomocnú ruku. Vyšetriť vieme iba to, čo nám do laboratória dorazí. Vtedy prichádza na rad naša kompetencia a ambícia poskytnúť presný a spoľahlivý výsledok čo najrýchlejšie, a tým napĺňať našu snahu urobiť pre pacientov maximum.

Takže pri odpovedi na otázku, či je možné aspoň niektorým náhlym úmrtiam predchádzať, je namieste, ako to už býva, začať „od seba“. V našej spoločnosti sa snažíme neustále napredovať v digitalizácii, inovovať naše technické vybavenie, ale aj pracovné postupy vrátane logistiky, aby sme ponúkali stále širšie možnosti vyšetrení za čo najkratšie reakčné časy.
Dôležité je v tomto poslaní nepoľaviť. Nevnímať náhle úmrtia ako niečo, čo sa nedá eliminovať, snáď len s výnimkou tých, kde smrť zasiahne vis major. Lebo také prípady ešte stále, aj napriek všetkému pokroku a ľudskému úsiliu, nevieme ovplyvniť. Nedokážeme ľudskej bytosti zabrániť, aby bola v nesprávny moment na nesprávnom mieste.
Zamyslime sa aj nad našimi chybami a poučme sa z nich. Francúzsky filozof Fontenelle vyslovil myšlienku, že „dejiny ľudského ducha sú predovšetkým dejinami ich omylov, ktoré hrajú pozitívnu rolu pri vzniku poznania“. Vďaka nim sa môžeme neustále zlepšovať, majúc aj v ťažkých časoch na pamäti, že tým najcennejším kapitálom, ktorý spoločnosť má, je práve ľudský život.

EDITORIÁL 5
Mgr. Stanislav Čársky generálny riaditeľ spoločnosti Unilabs Slovensko
8 AJ TY SI DÔLEŽITÝ!
Operátor call centra
predstavujeme kolegyňu z tímu call centra v Bratislave, Michaelu Zrnčíkovú
12 UDIALO SA
Čo je nové v Unilabs Slovensko
30 REPORTÁŽ
Môj mesiac na JIS-ke
Jana Klimanová
36 BLOG
Náhla smrť
MUDr. Antonín Polách

16 BLOG
Čo robí mozgovú mŕtvicu ešte smrteľnejšou
Ing. Josef Pazdera, CSc.
22 PROGRESÍVNE ZDRAVOTNÍCTVO
Dobrý sonografický prístroj je pre mňa najväčšie lákadlo
rozhovor s MUDr. Dašou Viszlayovou, PhD., primárkou Neurologickej kliniky FNsP

v Nových Zámkoch
Danka Šoporová
40 OSOBNOSŤ
Moja smrť ma zaujíma najmenej
rozhovor s hercom Jurajom Ďurdiakom
Elena Akácsová
46 AKTUÁLNE
Ak chceme dieťa ochrániť, vstúpme do jeho online sveta
Jana Klimanová
57 KOMENTÁR
Ako nezomrieť v spánku
Elena Akácsová
OBSAH
6 inVitro
TÉMA ČÍSLA — NÁHLE ÚMRTIA
60 Akútne respiračné zlyhanie
MUDr. Ivana Gondová, PhD.
66 Hemoragický šok doc. MUDr. Mária Hulíková, PhD.
LABORATÓRNA DIAGNOSTIKA
Praktická príručka/Technická príručka
2 Unilabs Slovensko — partner č. 1 v laboratórnej diagnostike
3 Procesná mapa
4 1. Žiadanka a objednanie vyšetrení
5 Vyplnenie žiadanky
6 Výber vyšetrení
6 Značenie vzoriek
9 Telefonické doobjednanie
10 Biochémia a hematológia



19 Imunológia a alergológia

26 Mikrobiológia

38 Genetika
42 Patológia
45 2. Odber
46 Žiadanka na odberový materiál
47 3. Transport
48 Mapa pokrytia zvozovými trasami
50 4. Registrácia a príprava vzorky
74 Kardiálne príčiny náhlych úmrtí
MUDr. Natália Vaňová, PhD., MBA
MUDr. Pavol Fülöp
82 Trombocyt pod drobnohľadom špecialistu
MUDr. Zuzana Jedináková, PhD.
94 Akútne brucho ako príčina smrti pri náhlych úmrtiach
MUDr. Arpád Panyko, PhD., MPH
102 Intoxikácia etylénglykolom
MUDr. Ivo Topoľský, PhD., MPH
108 Smrtiace plyny
MUDr. Marek Brenišin, PhD.
116 Akútna choroba z ožiarenia
RNDr. Vladimír Jurina
122 Neživý, nemŕtvy: účinky rastlín a húb navodzujúce stav podobný smrti
PharmDr. Slavomír Kurhajec, PhD.
130 Právne a medicínske aspekty darcovstva orgánov na Slovensku
MUDr. Igor Gaľa, PhD., MPH
52 5. Komplexná diagnostika
54 6. Kvalita a akreditácia
56 7. Analýza
62 8. Validácia a distribúcia výsledkov
63 Výsledkový list
64 9. Kontakty
65 Manažment
68 Sieť laboratórií a pracovísk

OBSAH
Unilabs Slovensko 7
Aj ty si dôležitý!
Práca každého z nás je súčasťou jedného veľkého a užitočného celku. V Unilabs Slovensko máme stovky šikovných ľudí, bez ktorých by to skrátka nefungovalo. Aj vy ste zvedaví, ako vyzerá deň bežného smrteľníka z našej firmy, ktorého možno poznáte z telefónu, cez e-maily, spoza volantu či dokonca osobne, ale nič o ňom vlastne neviete? Aké radosti a starosti majú naši kolegovia pracujúci na rôznych úsekoch spoločnosti? To sa dozviete práve v rubrike, prostredníctvom ktorej vám postupne predstavujeme bežný pracovný deň zástupcov všetkých dôležitých pozícií (napr. obchodného reprezentanta, človeka z call centra či centrálneho príjmu, administratívnu silu na zadávanie žiadaniek, šoféra na zvozovej trase, laboranta a mnohých iných), bez ktorých by Unilabs Slovensko nebol tým, čím je.
Chceme tak zviditeľniť každú pracovnú pozíciu, každý dielik skladačky, ktorá už celé roky vytvára obraz Unilabs Slovensko. A zároveň chceme povedať, že o vás vieme, potrebujeme vás a ďakujeme vám. V ďalšej časti predstavujeme Michaelu Zrnčíkovú, ktorá v Unilabs Slovensko pracuje na pozícii operátora call centra.
8 inVitro
Zodpovednosť
Práca na pozícii operátora call centra vo firme Unilabs je veľmi zaujímavá. S istotou môžem povedať, že každý deň je iný, zaujímavý a niečím špecifický. Teda nie je šanca nudiť sa. (Úsmev.) Vo firme Unilabs Slovensko pracujem síce len 1 rok, ale naučila som sa tu už veľa vecí.
Mojou hlavnou úlohou na call centre je riešiť a vybaviť požiadavky ambulancií, ktoré s nami spolupracujú, ale aj klientov, ktorí majú záujem o odbery. Čo znamená zodpovedať

správne a promptne všetky otázky, na ktoré sa naši klienti pýtajú. Keďže niektoré otázky sú veľmi špecifické, za nevyhnutnú považujem aj spoluprácu s ostatnými kolegyňami na call centre, s ktorými zdieľame všetky informácie.
Mojou nadriadenou je manažérka call centra, Ing. Monika Kalčíková, ktorá nás pravidelne informuje o dôležitých veciach, usmerňuje v prípade zmien, a tým pomáha zlepšovať procesy. Ak sa vyskytne nejaký problém, práve ona ho promptne rieši. Taktiež je zodpovedná za tvorbu interných dokumentov a nastavovanie procesov v call centre, vďaka čomu všetko funguje ako má. Veľmi oceňujem, že máme manažéra, na ktorého sa môžeme kedykoľvek obrátiť.
Spolupráca 7:00
Naše call centrum má 2 pobočky – v Bratislave a v Stropkove. Keďže všetci kolegovia na oboch pobočkách riešia požiadavky v rámci celého Slovenska, zdieľanie informácií navzájom je pri tejto práci kľúčové, rovnako ako aj spolupráca so všetkými oddeleniami spoločnosti Unilabs Slovensko.
Moja pracovná doba síce začína o 7.30, reálne však začínam pracovať už od 7.00. Toto je čas, keď musím skontrolovať telefonické záznamy z predchádzajúceho dňa, to znamená, či sú vyšetrené všetky parametre, ktoré nám boli telefonicky hlásené z jednotlivých ambulancií. Ak boli požiadavky na odoslanie výsledkov e-mailom, treba odoslať výsledky, prípadne ráno šoférom nahlásiť potrebné zvozy.
Pred 7.30 začínam vybavovať e-maily a chaty, ktoré boli doručené offline, čiže pred začiatkom pracovnej doby mám vybavených minimálne 7 klientov v rámci offline komunikácie.
Operátorka call centra
Michaela Zrnčíková Operátor call centra
Mám ukončenú Masarykovu univerzitu v Brne.
1 rok v Unilabs Slovensko – call centrum Bratislava
1
Svoj voľný čas venujem rodine, škole a fotografovaniu.
My v call centre sme na to, aby sme odbremenili laboratóriá a našich diagnostických pracovníkov od požiadaviek, ktoré vieme zodpovedať alebo zastrešiť u nás na call centre. Dôležitá je teda vzájomná komunikácia s jednotlivými laboratóriami, hlavne v prípadoch, keď treba preveriť, či bola dodaná konkrétna vzorka do laboratória, či je dostatok séra, a teda môžeme doordinovať určité parametre. Unilabs Slovensko 9
Čo pre mňa znamená moja práca?
Vďaka práci v call centre som spoznala úžasných ľudí. Mám skvelé kolegyne, s ktorými si rozumieme aj ľudsky.

Práca v call centre často prináša nielen vážne, ale aj humorné situácie, ktoré sú pre náš tím tak trochu spestrením. Neraz sa stalo, že si klienti pomýlili naše telefónne číslo s číslom na elektrárne a hlásili nám, že nesvietia pouličné lampy. K príjemným telefonátom patria zas tie, keď sa nám chcú klienti len poďakovať za rýchle vybavenie požiadavky (ako napríklad dodanie výsledkov alebo preverenie, kedy budú dodané výsledky). Niekedy počujeme na druhej strane linky šťastné sestričky, keď im poradíme, do akej skúmavky majú odobrať požadované parametre. V neposlednom rade nás poteší aj poďakovanie z laboratórií, ak im pomôžeme vyriešiť niektoré situácie, s ktorými si nevedia poradiť.
Na to, aby bol na konci spokojný klient či pacient, je potrebné, aby fungovala celá reťaz spolupráce, od ambulancie cez call centrum až po laboratórium a o to sa celý náš tím snaží.
S úderom 7.30 začnú zvoniť telefónne linky a ja začínam vybavovať prvé telefonáty. Typy telefonátov sa opakujú, uvediem najčastejšie z nich. Hneď ráno je zvykom volať z ambulancií, v ktorých robia odbery a sestričky potrebujú dohlásiť parametre, ktoré nezadali do elektronickej žiadanky. Prípadne riešime, do ktorých skúmaviek majú odoberať jednotlivé parametre, respektíve špecifikujeme požiadavky v rámci predanalytickej fázy vyšetrení. Ďalší typ hovoru je informovanie sa ohľadom výsledkov v prípade, že ešte nemajú v ambulancii k dispozícii vytlačené výsledkové listy, pričom lekár má pacienta v ambulancii a potrebuje ho vyriešiť.
Ďalej evidujeme hovory, keď si ambulancie telefonicky hlásia objednávky odberového materiálu a my ich prepájame do príslušného skladu alebo nahlásime objednávky priamo my. Medzi 8.30 až 9.00 nám zvyknú telefonovať aj klienti, ktorí sa informujú ohľadom odberov.
11:30
Počas dňa riešime rozmanité záležitosti, ktoré prináša ambulanciám ich bežný pracovný deň, ako napríklad doordinovanie parametrov, hlásenie výsledkov, informácie ohľadom doby dodania výsledkov, urgovanie CITO odberov, objednávky odberového materiálu, ale nemôžeme zabudnúť ani na nevyhnutnú súčasť práce s ľuďmi, a to sťažnosti. Aj chvíľkový výpadok systému znamená nárazový nával telefonátov z ambulancií. Všetky opodstatnené sťažnosti zároveň evidujeme pre oddelenie kvality.
Samozrejme, pokračuje e-mailová, chatová komunikácia a aj komunikácia na sociálnych sieťach.
Najrušnejšia časť dňa je okolo obeda, t. j. medzi 11.30 – 13.30, čo súvisí jednak s tým, že v tomto čase už majú ambulancie k dispozícii výsledky odberov, preto nastáva čas riešiť s nimi súvisiacu agendu, a tiež s tým, že je to zároveň
čas obedňajších prestávok v práci, keď si ľudia zvyknú vybavovať, čo od nás potrebujú.
AJ TY SI DÔLEŽITÝ!
7:30
10 inVitro
Keďže v tomto období prechádzame u niektorých našich klientov na novú digitálnu platformu Unilabs.pro, ktorá zabezpečí jednoduchší a rýchlejší systém práce v ambulancii (postupne nahradí AlphaLAB), časť našej práce sa týka aj tejto agendy.
Pri telefonických hovoroch, ktoré sa týkajú elektronických žiadaniek cez Unilabs.pro, zatiaľ nepociťujeme výraznejší „nával“, lebo systém je pomerne zrozumiteľný a ambulancie si v ňom vedia poradiť. Kontaktujú nás len v prípade technických problémov, ktoré sú prirodzené vždy, keď sa zavádza niečo nové. Typickým technickým problémom je dlhé načítavanie žiadaniek a výsledkov. V takom prípade kontaktujeme IT oddelenie, ktoré si s daným problémom vždy poradí.
16:30


Môj pracovný deň v call centre sa končí o 16.00, respektíve o 16.30, keď sa vypína telefónna linka a vtedy vypínam aj ja. (Úsmev.)
Keďže popri práci ešte externe študujem na Pedagogickej fakulte Univerzity Komenského, voľného času nie je veľa, ale keď sa nájde, naplno si to užívam. Rada trávim čas s manželom – obaja sa venujeme turistike a bicyklovaniu a mámi radi aj cestovanie. Okrem toho si plním svoj sen a venujem sa amatérskemu fotografovaniu.
Denne vybavím:
telefonické hovory e-maily online chaty asi 160 počas kovidu
Call centrum denne vybaví:
asi 60 asi 6 asi 2 asi 30 asi 10 asi 300
Operátorka call centra
Unilabs Slovensko 11
Čo je nové v Unilabs Slovensko
Novinky, zmeny a aktuality z prostredia našej spoločnosti. Prečítajte si viac o našich aktivitách.
Veľtrh práce v zdravotníctve
Martinská genetická konferencia 2023
Laboratórna diagnostika má pre zdravotníctvo obrovský význam aj vďaka genetickým vyšetreniam.


Tohtoročný Veľtrh práce v zdravotníctve sme opäť podporili ako hlavný partner. Konal sa už tradične na Jesseniovej lekárskej fakulte v Martine, a to 22. februára 2023. Študentom medicíny – ale aj iných zdravotníckych odborov – sme netradičným spôsobom predstavili zaujímavé pracovné možnosti v Unilabs Slovensko. Záujem o informácie bol naozaj veľký, rovnako ako aj účasť na podujatí.
V stánku Unilabs Slovensko si mohli návštevníci v prítomnosti našich patologičiek preveriť svoje odborné a praktické znalosti. Mnohí študenti ocenili aj našu geocaching hru určenú všetkým návštevníkom veľtrhu a pre úspešných hráčov boli pripravené aj drobné odmeny.


Sme veľmi radi, že o svoje znalosti a ponuku genetických vyšetrení sme sa tento rok mohli podeliť s návštevníkmi Martinskej genetickej konferencie 2023, konajúcej sa 16. – 17. marca 2023 v Hoteli Turiec v Martine. Jej pestrý odborný program obohatili prednáškami aj naši kolegovia – MUDr. Martin Mistrík, MUDr. Mária Giertlová, PhD., a RNDr. Michaela Matúšová.
V rámci tejto konferencie prebiehala aj „Súťaž o National Fellowship z ESHG“ o najlepšiu prezentáciu mladého autora. Súťažilo 7 mladých autorov, ktorí spĺňali vopred určené podmienky a prednášali na tejto konferencii. Sme hrdí, že súťaž tento rok vyhrala naša kolegyňa – RNDr. Michaela Matúšová s prednáškou „Nálezy microarray analýzy z pohľadu poskytnutých klinických informácií a zistených asociovaných ochorení“. Víťazka má zaistenú osobnú účasť na ESHG konferencii, ktorá sa koná tento rok v Glasgowe v Škótsku, a to 10. – 13. júna.

UDIALO SA 12 inVitro
XV. konferencia sekcie cervikálnej patológie a kolposkopie

XXX. deň primára
MUDr. Jána Straku
31. marca – 1. apríla 2023 sa konal už 30. ročník významnej gynekologicko-pôrodníckej konferencie – XXX. deň primára MUDr. Jána Straku, a to v hoteli Družba v Demänovskej Doline Podujatia sme sa zúčastnili aj my a v kontexte tohtoročnej témy „Starostlivosť o ženu, matku a dieťa” sme si pre návštevníkov nášho stánku pripravili prezentáciu vyšetrení GynTectR a LBC – Liquid Base Cytology.
V dňoch 23. – 24. marca 2023 sme sa zúčastnili ďalšieho z radu odborných podujatí, a to XV. konferencie sekcie cerkvikálnej patológie a koloskopie, ktorá sa konala v hoteli DIXON v Banskej Bystrici. Náš kolega MUDr. Ľudovít Mateček takisto prispel do odborného programu, a to prednáškou „Korelácia cytologických vyšetrení a punch biopsií na našom pracovisku v rokoch 2018 – 2022“.
Účastníkom konferencie sme v stánku Unilabs Slovensko predstavili našu širokú ponuku služieb a testov, v rámci ktorých sme sa zamerali na vyšetrenia GynTectR a LBC – Liquid Based Cytology.

so Siemens Healthineers

Naša spoločnosť v marci tohto roku oznámila strategickú spoluprácu v oblasti najnovšej diagnostickej infraštruktúry so spoločnosťou Siemens Healthineer. V praxi to znamená, že postupne všetky naše laboratóriá na Slovensku prejdú obnovou laboratórnej technológie od spoločnosti Siemens Healthineers a dočkajú sa tak komplexného technologického vylepšenia.
Tento ročník bol pre nás výnimočný. Spolok lekárov SLS v Žiari nad Hronom nám udelil pamätnú medailu MUDr. Jána Straku za dlhoročnú spoluprácu.
Denne v našich laboratóriách realizujeme vyše 90-tisíc vyšetrení. Takýto výkon je možné dosiahnuť iba dokonalým zvládnutím všetkých úkonov, od odberu vzorky až po doručenie výsledku s permanentným monitorovaním kvality každej etapy procesu. Nič z toho by nebolo možné bez pokročilých automatizovaných analytických postupov.
V prvých rokoch spoločnosť Siemens Healthineers nainštaluje veľkoobjemové a strednoobjemové analyzátory pre stanovenie parametrov klinickej biochémie a imunochémie, vrátane špičkových riešení Atellica Solution a Atellica CI 1900, analyzátorov hemostázy a automatizačných riešení. Nová plne automatizovaná linka Aptio Siemens Healthineers pribudne do technologického vybavenia laboratória Bratislava-Polianky. Naše najnovšie laboratórium v rámci nemocnice Bory v Bratislave je vybavené špičkovou technológiou Atellica Solution, ktorá dokáže spracovať až 2 000 vzoriek za deň.

Čo je nové v Unilabs Slovensko
Ďalší krok k modernizácii zdravotníctva spolu
Unilabs Slovensko 13
Spoločnosť Unilabs Slovensko otvorila najmodernejšie laboratórium v Nemocnici Bory


Nemocnica Bory v Bratislave je najmodernejšou nemocnicou v strednej Európe. Spoločnosť Unilabs Slovensko tu na ploche vyše 500 m2 otvorila svoje laboratórium, ktoré slúži primárne potrebám nemocnice. Od 1. marca 2023 poskytuje komplexné laboratórne a diagnostické služby, a to v oblasti klinickej biochémie a hematológie, sérológie, mikrobiológie, patológie a genetiky.
Veľkou výhodou je prepojenie na nemocničný systém potrubnej pošty, ktorý zabezpečí, že sa vzorky dostanú do laboratória takmer okamžite. „Vďaka laboratóriu priamo v nemocnici a využívaniu digitálnej platformy sú výsledky dostupné lekárom ihneď po analýze a následnej klinickej validácii. Digitalizácia a prepojenie laboratórnej techniky s platformou, ktorú využívajú lekári, eliminuje ľudský faktor a spoľahlivo tak zabezpečuje bezchybný prenos výsledkov k pacientovi a ku klientom nemocnice,“ hovorí
Veronika Dudová, vedúca nového laboratória Unilabs Slovensko na Boroch.
UDIALO SA
14 inVitro
Laboratórium klinickej biochémie a hematológie spolu s laboratóriom patologickej anatómie je vybavené najmodernejšou technikou od dodávateľov Siemens Healthineers, Roche, Mindray, Sysmex, BioG a Biomerieeux. Novinkou bude niekoľko doteraz neponúkaných vyšetrení ako napríklad vyšetrenie liečiv v krvi a rozšírenie toxikologických vyšetrení z krvi a moču.


Náš generálny riaditeľ Stanislav Čársky pri tejto príležitosti zdôraznil, že v roku 2023 je jedným z pilierov nového nastavenia firemnej stratégie a plánov aj modernizácia vybavenia vo všetkých našich laboratóriách. Preto je obzvlášť hrdý na to, že môžeme našim zákazníkom ponúknuť najmodernejšie prevádzky na Slovensku vrátane nového diagnostického laboratória v Nemocnici Bory.
Našou ambíciou je vyšetriť v novom laboratóriu až 200 000 vzoriek ročne, vďaka čomu sa staneme dominantným poskytovateľom laboratórnych služieb v rámci Bratislavy.
Čo je nové v Unilabs Slovensko
Unilabs Slovensko 15
Čo robí mozgovú mŕtvicu ešte smrteľnejšou
Ing.
Josef
 Pazdera, CSc. Objective Source E-Learning www.osel.cz
Pazdera, CSc. Objective Source E-Learning www.osel.cz
Písané exkluzívne pre
Upchatie, prípadne ruptúra ciev v mozgu patrí nielen k najčastejším zdravotným príhodám, ale aj k tým najštudovanejším. Vzhľadom na nespočet publikácií a haldu hrubých kníh by si na nejaký prekvapivý objav v tejto oblasti stavil len málokto. Medzinárodnému tímu vedenému Sergejom Kirovom sa ale najskôr niečo také teraz pošťastilo.
BLOG
16 inVitro
Vúzko špecializovanom odbornom neurologickom časopise Glia vyšiel článok, v ktorom autori šermujú s termínmi ako napríklad

„AGQS“. Aby sme pochopili, na čo prišli, bude dobré si zopakovať, ako to v našom mozgu vlastne chodí. Alebo presnejšie – ako sme si mysleli, že to v ňom chodí.
Mozog nie sú len neuróny, tie sú tam v úplnej menšine. 90 % mozgového tkaniva tvoria bunky, ktorým sa hovorí gliové. Spočiatku sa im prisudzovala rola len akéhosi podporného lešenia. Aj keď majú glie viacero typov, nás dnes budú zaujímať len tie najväčšie z nich – astrocyty. Meno im dali anatómovia, lebo im v mikroskope svojimi dlhými výbežkami trčiacimi do strán pripomínali hviezdičky. Keď mikrobiológovia zistili, že náplňou ich práce je vyživovať neuróny, prekrstili si ich na „dojčenské“.
90 %

Ani neurológovia nelenili. Tí pre zmenu odhalili, že astrocyty fungujú ako izolant brániaci tomu, čomu sa – ako pri telefónoch – hovorí „presluchy“. Je to zásluha astrocytov, že sa vzruch medzi neurónmi nešíri tam, kam nemá, ale dodržiava smer vytýčený synapsami.

Až teraz sa dostávame k tomu, čo začína súvisieť s dnešnou témou. Ide o ďalšiu prospešnosť astrocytov. Vlastne nie celých, ale iba ich dlhých výbežkov. V prepletencoch obaľujú krvné cievy a spolu s bunkami endotelu vytvárajú hustú sieťovinu pôsobiacu ako membrána. Hovorí sa jej hematoencefalická bariéra (haema = krv a encephalos = mozog). Ako latinčina naznačuje, jej účelom je chrániť vonkajšie hranice mozgu, aby do neho neprúdili neprispôsobiví migranti. Mozog si rozmaznávame ako výsostné územie striktne oddelené od okolitého krvného obehu s mnohými škodlivinami z látkovej výmeny a tu a tam aj s vírusmi a baktériami.

Čo robí mozgovú mŕtvicu ešte smrteľnejšou
Pri poruche funkcie hematoencefalickej bariéry dochádza k prestupu aminokyselín z krvi do mozgovomiechového moku v nežiaducej miere.
90 % mozgového tkaniva tvoria gliové bunky.
Unilabs Slovensko 17
Obrázok č. 1: Astrocyty sú charakteristické hojnosťou svojich výbežkov. Pôvodne mali byť len lešením udržujúcim tvar mozgových záhybov. (Kredit: Gerry Shaw. Licencia CC BY-SA 3.0)
Mozog ale nemôže žiť len zo vzduchu, musia doň vstupovať vyživujúce látky. Z toho dôvodu je dovolené prechádzať demarkačnou líniou hematoencefalickej bariéry nielen plynom, ale aj látkam rozpustným v tukoch. Dlho sa usudzovalo, že voľný pohyb majú aj aminokyseliny. Bola to rozumná predstava. Jednak preto, že aminokyseliny sa v hojnej miere vyskytujú na oboch stranách barikády (v krvnom riečisku aj v mozgovomiechovom moku). Okrem toho sa mozog bez nich nezaobíde a bolo by nelogické, keby prísunu aminokyselín niečo prekážalo.
Dôveruj, ale preveruj
Potom ale vedci prišli na to, že glukóza, ktorá je pre úspešný chod mozgu tiež potrebná, smie dovnútra len na povolenie. Jej transport nie je pasívny (daný koncentračným spádom), ale ide o aktívnu záležitosť,
ktorej sa zúčastňujú „prevádzači“ účtujúci si za službu istú dávku energie. Nasledovalo zistenie, že podobne sú na tom aj aminokyseliny a predstava, že si hranicu prechádzajú, ako sa im zachce, padla. V ich prípade to pripomína skôr šikanovanie na colnici. Má to svoj dôvod. Aj keď ich k správnej funkcii mozgu treba, dokážu sa tiež na mozgu nepekne a nezvratne vyšantiť.
Aminokyseliny v role škodcov Ak dôjde k poruche funkcie hematoencefalickej bariéry, čo je pri poranení hlavy otrasom, úderom či mozgovou mŕtvicou takmer pravidlom, dochádza k prestupu aminokyselín z krvi do mozgovomiechového moku v miere, ktorá nie je žiaduca. Vtedy sa z dobrých sluhov stávajú zloduchovia. Netýka sa to všetkých aminokyselín, ale len štvorice z nich – tzv. neexitačných
Obrázok č. 2: Najčastejším symptómom zvýšeného vnútrolebečného tlaku je bolesť hlavy. Pri pomaly sa rozvíjajúcej vnútrolebečnej hypertenzii, napríklad pri raste mozgového nádoru, je nárast intenzity bolestí hlavy pozvoľný. Pri krvácaní do mozgu je bolesť okamžitá. V prípade otrasu s postupujúcim opuchom a utláčaním odtokových ciest mozgovomiechového moku sa bolesť hlavy rozvíja niekoľko hodín. Bolesť sa typicky zvyšuje pri predklone, položení sa, pri kašli. (Kredit: Patrick J. Lynch, lekársky ilustrátor, CC BY 2.5)

BLOG
18 inVitro
Odhaliť, že na začiatku neblahého sledu udalostí stojí zvýšenie koncentrácie 4 aminokyselín, sa podarilo až s pomocou fotónových laserových mikroskopov.
Až 90 %
Až 90 % pacientov s poraneným mozgom postihne za niekoľko hodín (niekedy aj dní) od udalosti dodatočné poškodenie mozgového tkaniva priľahlé k miestu poranenia.
aminokyselín (tie vedci vo svojej práci označujú oným vyššie menovaným termínom AGQS). Ich pričinením astrocyty napučiavajú a spúšťajú kaskádu dejov vedúcich k odumieraniu nervových buniek, často aj s fatálnym koncom. Až 90 % pacientov s poraneným mozgom postihne za niekoľko hodín (niekedy aj dní) od udalosti dodatočné poškodenie mozgového tkaniva priľahlé k miestu poranenia.
Začarovaný kruh

Problém je v tom, že aminokyseliny sú prítomné v krvi v hojnejšej miere než v mozgovomiechovom moku. Akonáhle prestane hematoencefalická bariéra z nejakého dôvodu „tesniť“, L-alanín, glycín, L-glutamín a L-serín zaplavia okolie astrocytov. Tie sa v snahe ochrániť neuróny doslova prepchajú.
Astrocytom narastie obsah vnútrobunkového sodíka, čo sa odrazí v ich smäde a nadmernom vstrebávaní vody.
Ako astrocyty napučiavajú, stanú sa (vyvíjaným tlakom) pre svoje okolie nebezpečnými. Vzájomné utláčanie zhorší prísun kyslíka a hypoxia je tým, na čo sú neuróny veľmi citlivé. Zatiaľ sa popísaný problém týkal len najbližšieho okolia postihnutia. Žiaľ, situácia sa ďalej zhoršuje. Astrocyty nemôžu zostať nafúknuté natrvalo. Po čase začnú „vypúšťať paru“ – otvárajú svoje membránové kanály, aby sa aspoň čiastočne zbavili nadbytku vody. Spolu s vodou vyplavia do prostredia aj glutamát. Ten, ako je známe, zastáva v mozgu funkciu prenášača vzruchov (neurotransmiteru). Viaže sa neurónom na NMDA receptor a privedie ich k excitácii.
Obrázok č. 3: Uvádza sa, že prvým, kto si začal uvedomovať vážnosť intracerebrálnej hypertenzie, bol Alexander Monro. Svedčí o tom jeho zmienka z roku 1783: „Lebka je uzavretý obal, ktorého obsah je prakticky nestlačiteľný“. Ale aj on mal zrejme predchodcu, lebo trepanácie pomocou obsidiánových nožov vykonávala staroveká civilizácia na území Peru 400 rokov pred naším letopočtom. Asi kvôli liečbe opuchu. Zákrok prežívalo 40 % pacientov. Kredit: David Octavius Hill (1802 – 1870) a Robert Adamson (1821 – 1848) – Flickr, CC BY 2.0
Čo robí mozgovú mŕtvicu ešte smrteľnejšou
Unilabs Slovensko 19
Obrázok č. 4: Sergei Kirov, zodpovedajúci autor štúdie: „Existuje mnoho spôsobov, ako prísť o neuróny. Toto je ten, o ktorom ľudia zatiaľ nepremýšľali.“ Vpravo na obrazovke je prvá autorka štúdie Iris Álvarez-Merz. (Kredit: Mike Holahan, Augusta University)

Obrázok č. 5: Prekvapivým vinníkom zhoršovania mŕtvice sa ukázali byť neexcitačné aminokyseliny. (Kredit: Voľné dielo)
Samotná väzba glutamátu na receptory neurónov nie je nič zlé. Pokiaľ sa deje s mierou, je to proces podporujúci učenie a pamäť. Keď sa to ale preženie, čo je náš prípad, enormná excitácia sa na neurónoch podpíše hromadením sodíka. Podobne ako u astrocytov, aj u neurónov sa to prejaví nasávaním vody a napučaním. Hromadná extáza spôsobí, že toho napučania začne byť v mozgu až príliš a vnútrolebečný tlak ďalej rastie. Teraz už aj pričinením samotných neurónov. Odhaliť spúšťací mechanizmus, že na samom začiatku neblahého sledu udalostí stojí zvýšenie koncentrácie štyroch aminokyselín, sa vedcom podarilo až s pomocou fotónových laserových mikroskopov umožňujúcich v reálnom čase nazerať do živého tkaniva.
BLOG
L-alanín glycín L-serín L-glutamín NH2 OH O H 3C OH O H 2N NH2 OH O O H 2N NH2 OH HO O 20 inVitro
Vyzerá to tak, že aj na úrovni buniek sa stáva, že v ťažkej chvíli niekedy zradia tí najbližší. Aj keď sú aminokyseliny a astrocyty pre regeneráciu a úspešný chod mozgu nenahraditeľnými parťákmi, v prípade problému mozgový edém zhoršujú. Aj keď sa dnes opuch mozgu lieči celým radom techník, stále ide o veľmi vážnu komplikáciu znižujúcu pacientom šance, že sa z toho v zdraví dostanú. S novým poznatkom sa liečba mŕtvice či otrasu mozgu zrejme dočká zmien. Jednak v zmysle eliminácie aminokyselín. Ponúka sa možnosť robiť z prenášačov aminokyselín invalidov, ktorí by v kritických situáciách neboli schopní prepravovať hematoencefalickou bariérou do mozgu obvyklé množstvo. Druhú sľubnú cestu ukázali už vykonané pokusy s farmakologickým utlmením NMDA receptorov. V tomto prípade ide o to zhatiť
neurónom ich chúťky privádzať sa glutamátom do extázy. Oba smery sa vzájomne nevylučujú a podľa objaviteľov by sa ich uplatňovanie malo zúročiť poklesom počtu ochrnutých, dementných i úbytkom rozosielaných oznámení začínajúcich slovami: „So smútkom si Vám dovoľujeme oznámiť…“

Literatúra
Iris Álvarez-Merz, et al.: Novel mechanism of hypoxic neuronal injury mediated by nonexcitatory amino acids and astroglial swelling, Glia (2022).
Aj keď sú aminokyseliny a astrocyty pre regeneráciu a úspešný chod mozgu nenahraditeľnými parťákmi, v prípade problému mozgový edém zhoršujú.

Čo robí mozgovú mŕtvicu ešte smrteľnejšou
Unilabs Slovensko 21
Dobrý sonografický prístroj je pre mňa najväčšie lákadlo

PROGRESÍVNE ZDRAVOTNÍCTVO
22 inVitro
Náhla cievna mozgová príhoda (CPM) bola minulý

rok treťou najčastejšou príčinou úmrtí na Slovensku. Ročne postihne približne 17 miliónov ľudí na celom svete. Dôsledky CMP možno výrazne zmierniť, ak sú príznaky rozpoznané včas a postihnutým je v nemocnici poskytnuté rýchle lekárske ošetrenie. Slovensko v akútnej liečbe nezaostáva ani za najvyspelejšími krajinami. Disponujeme relatívne dobre pokrytou sieťou iktových centier, kam sú pacienti privezení priamo s príznakmi mozgovej príhody. Práve tam sa zrealizuje diagnostika a následná liečba. Tá v ostatnom období zahŕňa tiež robotickú rehabilitáciu, ktorá v oblasti neurológie na Slovensku predstavuje výnimočný progres. Na svojom pracovisku ju využíva i MUDr. Daša Viszlayová, PhD. – primárka Neurologickej kliniky FNsP Nové Zámky, pričom jej význam v každodennej praxi považuje za neoceniteľný.
Čo znamená iktus, aké sú najmodernejšie metódy liečby mozgovej mŕtvice a ktorú krajinu považujete v tomto smere za najväčšieho inovátora?
Iktus je cievna mozgová príhoda a je charakterizovaná náhle vzniknutým ložiskovým neurologickým deficitom, spôsobeným fokálnym postihnutím centrálnej nervovej sústavy s cievnou príčinou. Zahŕňa ischemické príhody, pri ktorých dochádza k rozvoju infarktu z dôvodu zúženia či uzatvorenia mozgovej tepny, aj príhody hemoragické, pri ktorých sa cieva poruší, pričom dochádza ku krvácaniu. V prípade mozgových infarktov, ktoré tvoria asi 85 % všetkých cievnych mozgových príhod, je cieľom dosiah-
nuť rekanalizáciu a reperfúziu mozgovej tepny. Rekanalizácia znamená obnovenie prietoku v mieste primárnej oklúzie. Reperfúzia je obnovenie prietoku v terminálnom riečisku, ktoré vychádza z miesta primárnej oklúzie. Na liečbu využívame dve stratégie – intravenóznu trombolýzu (infúzne podanie trombolytika do žily) a mechanickú trombektómiu (priame endovaskulárne odstránenie trombu). U mozgových krvácaní je to liečba konzervatívna, čiže podávanie liekov na korekciu krvného tlaku, korekcia hypokoagulačného stavu a podobne. Ďalej je to liečba chirurgická, ktorá zahŕňa odstránenie hematómu, komorovú drenáž a odstránenie príčiny krvácania (ošetrenie aneuryzmy, arteriovenóznej malformácie, tumoru).
Dobrý sonografický prístroj je pre mňa najväčšie lákadlo
Autor: Danka Šoporová
Foto: Martin Giertl, archív D. V.
Unilabs Slovensko 23
„Niektoré ľahké CMP majú príznaky, ktoré sa dajú spliesť s iným ochorením, alebo sú príznaky prechodné, prípadne vznikne
CMP v lokalite, ktorá nespôsobí žiadne príznaky. Vtedy hovoríme o tzv. tichej mozgovej ischémii.“
asi 85 %
Lídrami akútnej i následnej starostlivosti sú krajiny ako USA, Nemecko, ale aj škandinávske štáty.
Kedy možno hovoriť o mozgovej porážke u mladších ľudí? Sú rizikové faktory CMP u tejto vekovej skupiny osôb odlišné od starších pacientov?
O cievnej mozgovej príhode u mladých ľudí hovoríme, keď má pacient menej ako 50 rokov, ale keďže populácia starne, podaktorí neurológovia uprednostňujú hranicu 55 rokov. Rizikové faktory, ktoré nedokážeme ovplyvniť, sú faktory geografické, rasové, vek, pohlavie a ďalšie. Ovplyvniteľné faktory sú nesprávna životospráva, kam spadá obezita, fajčenie, nedostatok pohybu atď., čiastočne ovplyvniteľné sú ochorenia typu vysoký tlak, cukrovka, porucha metabolizmu lipidov a podobne. Čo sa týka mladých pacientov, príčiny CMP sú jednoznačne iné v porovnaní so staršími pacientmi, a síce: krvné, genetické, infekčné, srdcové ochorenia, aneuryzma, disekcia, migréna, arteritídy, drogy, lieky, ale aj tehotenstvo.
O prevencii aj varovných príznakoch mŕtvice sa toho už popísalo veľa. No ktoré indície alebo symptómy môžu jej nástup indikovať pomerne spoľahlivo? Hoci sa v laickej populácii považuje mozgový infarkt za ochorenie starších, môže sa vyskytnúť v akomkoľvek veku. Incidencia CMP je pochopiteľne vyššia u starších. Súvisí to s výskytom rizikových faktorov, akými sú artériová hypertenzia, diabetes mellitus, srdcové arytmie. Avšak v posledných rokoch stúpa výskyt CMP vo všetkých vekových kategóriách, mladých ľudí nevynímajúc. Najčastejšími príznakmi bývajú porucha reči, ochrnutie končatín či vykrivený ústny kútik. V takých prípadoch netreba na nič čakať.
Môže sa stať, že človek prekoná cievnu mozgovú príhodu bez toho, aby o tom vedel?
Určite sa to môže stať. Dôvodom je fakt, že niektoré ľahké CMP majú
príznaky, ktoré sa dajú spliesť s iným ochorením, alebo sú príznaky prechodné a pacient nepodstúpi vyšetrenie u lekára, prípadne cievna mozgová príhoda vznikne v lokalite, ktorá nespôsobí žiadne príznaky. Vtedy hovoríme o tzv. tichej mozgovej ischémii.
V tejto súvislosti by som rada zdôraznila taktiež typy cievnej mozgovej príhody. Hemoragické CMP tvoria asi 15 %. Z praxe však môžem povedať, že hemoragické CMP sú ťažšie a fatálnejšie. Deštrukcia mozgu je podstatne rozsiahlejšia než pri ischémiách a aj liečba býva podstatne limitovanejšia.
Zaujala vás v ostatnom období na túto tému konkrétna štúdia? Aké prekvapivé informácie v nej odzneli?
Na túto otázku neexistuje odpoveď v podobe jedinej štúdie. Akútna neurológia je predsa len obzvlášť široká oblasť. Bolo obdobie, keď sa pozornosť venovala zobrazovacím vyšetreniam v rámci „stroke protokolu“, na základe ktorých sa podarilo postupne posúvať časové okno na podanie rekanalizačnej liečby. Treba spomenúť takisto štúdie porovnávajúce jednotlivé liečebné stratégie, práce o plasticite a cerebroprotekcii či optimalizácii sekundárnej prevencie.
Hoci štúdie zaoberajúce sa perfúznym zobrazením mozgu v akútnej fáze iktu už nepovažujeme za nové, práve tie boli, a naďalej sú, pre mňa prelomové. Tie najvýznamnejšie boli DAWN (DWI or CTP Assessment with Clinical Mismatch in the Triage of Wake-Up and Late Presenting Strokes Undergoing Neurointervention with Trevo), DEFUSE 3 (Endovascular Therapy Following Imaging Evaluation for Ischemic Stroke 3) a takisto EXTENT (Extending the Time for Thrombolysis in Emergency Neurological Deficits).
Nedávno bol uverejnený rozhovor s českým neurológom Alešem Tomekom, ktorý tvrdí, že najťažšie je,
PROGRESÍVNE ZDRAVOTNÍCTVO
Hemoragické CMP sú ťažšie a fatálnejšie. Deštrukcia mozgu je podstatne rozsiahlejšia než pri ischémiách a aj liečba býva podstatne limitovanejšia.
Mozgové infarkty tvoria asi 85 % všetkých cievnych mozgových príhod. 24 inVitro
keď mŕtvicu prežijete, no uzdravíte sa len tak napoly. Súhlasíte s týmto tvrdením?
Pán docent Tomek je mimoriadny človek, lekár a významná osobnosť. Povedal to naozaj krásne. Myslel tým fakt, že mnohí pacienti majú po CMP následky, ktoré sú síce miernejšie, ako keď iktus utrpeli (alebo by ho vôbec neprežili, akonáhle by neboli liečení), no ich neurologické poškodenie značne ovplyvňuje kvalitu ich života. Znamená to, že nedokážu žiť rovnako ako predtým. Nedokážu myslieť ako predtým, hovoriť, pohybovať sa a ešte oveľa viac.
Aká je starostlivosť o pacientov s cievnou mozgovou príhodou na Slovensku v porovnaní so zahraničím? Dokážu slovenskí špecialisti konkurovať tým zahraničným?
Slovensko v akútnej liečbe nezaostáva ani za najvyspelejšími krajinami. Horšie je to u nás s následnou starostlivosťou po ikte. Máme relatívne dobre pokrytú sieť iktových centier, kam sú pacienti privezení priamo s príznakmi mozgovej príhody. Práve tam sa zrealizuje diagnostika a následná liečba. Horšie je to s ďalšou starostlivosťou. Tam máme veľké rezervy.
Následná starostlivosť vyžaduje komplex odborníkov – lekárov, sestry, fyzioterapeutov, logopédov, psychológov. Od včasnej fázy po ikte treba začať trénovať motorické, rečové, kognitívne funkcie. Nemáme kapacity personálne, odborné, chýbajú nám taktiež zariadenia na špeciálnu starostlivosť, na Slovensku nemáme ani „neurorehabilitáciu“ ako samostatný odbor. Starostlivosť o pacienta po cievnej mozgovej príhode je dlhodobá. Preto si celá táto problematika vyžaduje personál, vybavenie, čas, ale i organizáciu. A toto všetko nám chýba.
Na Slovensku vzniklo 8 špecializovaných pracovísk intervenčnej rádiológie a endovaskulárnej liečby, ktoré realizujú vysokošpecializované zákroky. Do akej miery s nimi spolupracuje vaša klinika?

Naše pracovisko funguje ako primárne iktové centrum. Pacientom podávame intravenóznu trombolýzu a v prípade uzáveru veľkej cievy pacienta prevážame na najbližšie intervenčné pracovisko. Keďže máme v nemocnici neurochirurgiu, väčšinu mozgových krvácaní vieme vyriešiť u nás. Počet iktových centier na Slovensku považujem
V roku 2006 ukončila štúdium na Lekárskej fakulte Univerzity Komenského v Bratislave, európsku atestáciu z neurológie absolvovala v roku 2013 a postgraduálne štúdium v odbore neurológia ukončila v roku 2021 na Lekárskej fakulte Univerzity Karlovej v Hradci Králové.
Už takmer sedemnásť rokov sa plne venuje neurológii – 14 rokov na Neurologickej klinike v Nitre, od roku 2020 zastáva funkciu primárky Neurologickej kliniky v Nových Zámkoch. Zároveň pracuje ako odborný asistent na Lekárskej fakulte Univerzity Karlovej v Hradci Králové.
Dobrý sonografický prístroj je pre mňa najväčšie lákadlo
MUDr. Daša Viszlayová, PhD.
Unilabs Slovensko 25
„Slovensko v akútnej liečbe nezaostáva ani za najvyspelejšími krajinami.“
vo všeobecnosti za postačujúci, ich geografické rozmiestnenie ale nie je ideálne. Podľa môjho názoru je problém najmä v Bratislave a na východnom Slovensku, kde nie je región dostatočne pokrytý počtom centier.
Po odznení dopadov cievnej mozgovej príhody je zvyčajne ďalším krokom na ceste k zotaveniu už načrtnutá rehabilitácia. Teraz sa zamerajme na prístroj Lite Gait, ktorý sa ako mobilný odľahčovací systém osvedčil pri nácviku stability postoja a chôdze. Je robotická rehabilitácia v našich končinách novinkou?
Robotická rehabilitácia v neurológii na Slovensku je niečo absolútne výnimočné. Nemám vedomosť o tom, že by niektoré pracovisko disponovalo robotmi. Nám tieto prístroje významne uľahčujú prácu. Môžeme zahájiť rehabilitáciu oveľa skôr, ušetríme fyzickú prácu

fyzioterapeutom, počítačom vieme vyhodnotiť rôzne parametre rehabilitácie. Tieto prístroje si nedokážeme v dennej praxi vynachváliť. Samozrejme, robotická rehabilitácia musí ísť ruka v ruke s konvenčnou rehabilitáciou.
Čím vyniká práve tento mobilný odľahčovací systém a pre aké typy pacientov je určený?
Je to prístroj na nácvik postoja a chôdze. Má štyri nezávisle nastaviteľné popruhy horného postroja, tie kontrolujú držanie tela i pohyb v troch rovinách. Vhodný je primárne pre pacientov s asymetrickým postihnutím končatín, pretože koriguje, okrem iného, aj ťažisko podľa telesného postihnutia. Zároveň podporuje symetrické vzpriamené polohovanie. Je to určitý vozík na kolieskach, v ktorom je pacient odľahčený a učí sa stáť i chodiť. Robotická rehabilitácia predstavuje atraktívnu me-
PROGRESÍVNE ZDRAVOTNÍCTVO
26 inVitro
„Ročné riziko rekurencie ischémie sa uvádza asi u 8 – 10 % prípadov, päťročné u 15 – 20 %.“
tódu rehabilitačnej liečby pacientov po cievnej mozgovej príhode. Odliečili sme desiatky pacientov a prvé výsledky sú veľmi sľubné. U väčšiny pacientov pozorujeme možnosť skoršej vertikalizácie, ako aj významný efekt na zlepšenie stability postoja i chôdze.
Iným prístrojom, ktorý využívate, je počítačom ovládané robotické zariadenie Erigo. Čím sa stalo – ako pomôcka na vašej klinike – nenahraditeľným a na akej báze funguje?
Tento prístroj umožňuje vertikalizovať celkom imobilných pacientov v podstate od prvých hodín iktu. Reč je o robotickom zariadení, ktoré je ovládané počítačom. Prístroj pozostáva z vertikalizačného stola a integrovaného mechanizmu pohybu nôh. Znamená to, že pacienta na stole vertikalizujeme a zároveň prístroj pohybuje jeho nohami. Pritom je možné realizovať elektrické stimuly na dolných končatinách. Týmto systémom minimalizujme riziko nežiaducich ortostatických príznakov a pacienta dokážeme postupne vertikalizovať. Robotická rehabilitácia sa ale môže využívať aj na liečenie pacientov trpiacich inými mozgovými ochoreniami, než je cievna mozgová príhoda. Oba prístroje boli zakúpené v rámci projektu Rehabilitácia pacienta po mozgovej porážke robotickým systémom (SKHU/1902/4.1/112) – RoRehab, ktorého cieľom je posilnenie a takisto zvýšenie úrovne cezhraničnej spolupráce medzi inštitúciami dotknutých regiónov a rozšírenie ich kolektívnych aktivít (výskum a vývoj) za účelom zavedenia robotickej rehabilitácie. V rámci nášho projektu sa jedná o spoluprácu s maďarskou nemocnicou v Kisbéri.
O koľko pacientov s cievnou mozgovou príhodou sa na Neurologickej klinike v novozámockej nemocnici ročne staráte? Má táto diagnóza tendenciu sa opakovať?
Ročne ich je asi 500. Ročné riziko rekurencie ischémie sa uvádza asi u 8 – 10 % prípadov, päťročné
u 15 – 20 %. Pochopiteľne, odstránenie ovplyvniteľných a čiastočne ovplyvniteľných rizikových faktorov (fajčenie, nadváha, správna liečba hypertenzie či porúch metabolizmu lipidov a iné), ako aj správna sekundárna prevencia mozgového infarktu, riziko znížia.
Ako primárka neurologickej kliniky a dlhoročná odborníčka v tejto oblasti medicíny máte poznatky o najnovších trendoch v liečbe. Aký prístroj aktuálne považujete za to najlepšie na trhu?
Verím, že diagnostika i liečba CMP sa budú naďalej vyvíjať dynamickým, flexibilným a perspektívnym spôsobom a že zachránime stále viac pacientov, pričom výsledkom bude aj čo najmenší neurologický deficit. Sú prístroje, ktoré využívame v praxi denne, niektoré primárne na výskumnú činnosť. Ja som sonografista, vždy ma nadchýnalo, čo všetko vieme vyšetriť ultrazvukom – či sa to týka štruktúry, alebo funkcie mozgovej cirkulácie. Dobrý sonografický prístroj je pre mňa vždy najväčšie lákadlo. Samozrejme, pracujeme aj na tom, aby sme rozšírili naše možnosti robotickej rehabilitácie, máme v pláne zakúpiť napríklad zariadenie na robotickú rehabilitáciu ruky.

Dobrý sonografický prístroj je pre mňa najväčšie lákadlo
Robotická rehabilitácia predstavuje atraktívnu metódu rehabilitačnej liečby pacientov po cievnej mozgovej príhode.
Unilabs Slovensko 27
„Robotická rehabilitácia musí ísť ruka v ruke s konvenčnou rehabilitáciou.“
Zaujímavé fakty o cievnej mozgovej príhode
Prístroj Erigo
Počítačom ovládané robotické zariadenie, ktoré pozostáva z vertikalizačného stola a integrovaného mechanizmu pohybu nôh. Erigo postupne privádza pacienta do zvislej polohy pri pohybe nôh a pri aplikácii cyklického zaťaženia nôh. Cieľom prístroja je príprava pacienta na nácvik chôdze. Prístroj vďaka elektrickej stimulácii dolných končatín a aktívnej simulácie chôdze minimalizuje nežiaduce účinky u pacienta.

Cievna mozgová príhoda je 3. najčastejšou príčinou úmrtia a invalidity vo vyspelých krajinách, a to po srdcových a onkologických ochoreniach. Úmrtnosť na mozgovú príhodu sa pohybuje v rozmedzí približne 100 – 200/100 000 obyvateľov Slovenska.

15 – 20 %
Prístroj Lite Gait
Ako mobilný odľahčovací systém slúži na nácvik stability postoja a chôdze. Pacientom poskytuje bezpečné prostredie pri nácviku státia, presunu i tréningu chôdze. Prístroj možno použiť pri chôdzi po zemi alebo s bežiacim pásom, pri aktivitách zameraných na rovnováhu a státie, ako je napríklad terapeutické cvičenie, ale aj na podporné polohovanie v sede. Lite Gait poskytuje štyri nezávisle nastaviteľné popruhy horného postroja, ktoré kontrolujú držanie tela – pohyb v 3 rovinách. Prístroj je určený pre pacientov s asymetrickým postihnutím.
Spotreba kyslíka je asi 3,5 ml na 100 gramov mozgového tkaniva, čiže 50 ml za jednu minútu pre celý mozog. Táto hodnota predstavuje
15 – 20-percentnú potrebu kyslíka pre celý organizmus.
Glukóza je jediným zdrojom energie pre nervové bunky a denne jej mozog spotrebuje približne 115 g. Spotreba predstavuje približne 5,5 mg na 100 gramov mozgového tkaniva, čo predstavuje 75 mg za minútu pre celý mozog.
Nezvratné poškodenie mozgu nastáva po 3 až 4 minútach. Po 9 minútach nie je možné prežitie, a to pre úplnú ischémiu mozgu. Výnimkou je iba stav podchladenia, čiže hypotermie, keď sa energetická a kyslíková náročnosť mozgu podstatne znižuje.
PROGRESÍVNE ZDRAVOTNÍCTVO
28 inVitro
Experimentálne sa zistilo, že mozgová ischémia, teda úplná spotreba kyslíka v mozgu, nastáva približne po 2 – 8 sekundách. Po dvanástich sekundách dochádza k poruche vedomia, kolapsu, bezvedomiu.

















































Elektrická aktivita nie je na EEG (elektroencefalografia, t. j. vyšetrenie registrujúce aktuálnu elektrickú aktivitu mozgu vyšetrovaného) prítomná po 30 – 40 sekundách od mozgovej ischémie.
Do jedného roka zomrie asi 1/3 ľudí postihnutých ischemickou CMP.
Každú minútu sa v nedokrvenej časti poškodí približne 1,9 milióna neurónov.
Dobrý sonografický prístroj je pre mňa najväčšie lákadlo
Unilabs Slovensko 29
Môj mesiac na JIS-ke
Prísť o zdravie aj blízkeho človeka v jednej sekunde je scenár, do ktorého sa nikto netúži začítať. Všetci sme predsa nesmrteľní, zdraví, neohroziteľní. Do chvíle, kým sa na ceste vodič auta v nesprávnej chvíli nevenuje niečomu inému ako riadeniu. Do chvíle, kým svojím autom nevojde do cesty dvom motorkárom, ktorí si chceli iba užiť krásny, slnečný marcový deň.








REPORTÁŽ
Autor: Jana Klimanová
30 inVitro
Foto: archív J. K., Shutterstock








Môj mesiac na JIS-ke Unilabs Slovensko 31
Náraz do auta bola taký nečakaný a prudký, že Janu vymrštilo do vzduchu a po dvoch saltách dopadla na strechu auta, ktoré vošlo do cesty ich motorke. Vo veľkej rýchlosti sa zošmykla po boku karosérie a dopadla chrbtom na cestu. Nasledovalo šmýkanie zopár metrov po vozovke, kým sa jej telo zastavilo. Ležala na chrbte, vnímala modrú oblohu a príšerný strach. Pohla nohou, aj druhou – vydýchla si – išlo to. No keď sa pokúsila nohy odtiahnuť od seba, do tela sa jej zarezala príšerná bolesť a vydral sa z nej doslova zvierací rev. „Bolo to ako dvadsať pôrodov naraz. Nič podobné som dovtedy nezažila,” spomína na najhorší deň vo svojom živote 57-ročná Bratislavčanka. Od tej chvíle kričala neustále. V tom kriku bola bolesť, strach, zúfalstvo…
Operujte, prosím!
O pár minút po nehode sa nad Janou skláňalo niekoľko hláv. Jedna z nich patrila dievčine – záchranárke, ktorá sedela v aute, ktoré pred nehodou išlo za motorkármi. „Upokojovala ma, držala pri vedomí a zavolala záchranku. Na otázku, či Ivan, ktorého oživovali neďaleko mňa, žije, mi však neodpovedala. Teraz sa sústreďte na seba, dýchajte,“ tíšila ma.
Do záchranky ju nakladali s polytraumou – trojnásobnou otvorenou zlomeninou členka, niekoľkonásobnou zlomeninou panvy a vnútorným krvácaním, zlomeným chodidlom a poškodeným kolenom. V nemocnici nasledovala séria vyšetrení. „Každý, aj nepatrný pohyb vyvolával neznesiteľnú bolesť panvy. Doslova som cítila, ako sa mi trú o seba jej zlomené časti. A hoci nie som žiadna padavka, určite ma počuli kričať na všetkých poschodiach nemocnice. Aj z vystuženého motorkárskeho oblečenia ma doslova vystrihli. Odmietla som urobiť akýkoľvek pohyb navyše, ktorý by mi privodil tú príšernú bolesť.“
Janu čakala operácia rozdrúzganého členka aj panvy. Nie všetci lekári však boli pre operáciu panvy. Mala sa roz-
hodnúť sama. Nebol to jednoduchý zákrok a vtedy – vo svojich 55 rokoch – už nebola najmladšia. Na druhej strane, bola úplne zdravá a vďaka intenzívnemu cvičeniu počas covidovej izolácie aj vo výbornej fyzickej kondícii. Ak by sa nedala operovať, čakali by ju minimálne dva mesiace nepohnute na lôžku. „V týchto bolestiach? To ma rovno odtiaľto odveziete na psychiatriu. Operujte ma, prosím,“ s odpoveďou neváhala ani sekundu, na riziká sa nepýtala.
Zrútil sa mi svet
„Sestrička, zistite prosím, či Ivan žije a v ktorej nemocnici je,“ pýtala sa po celý čas, kým jej robili vyšetrenia a pripravovali ju na operáciu. Sestrička prikývla, ale Jana sa odpovede nedočkala. „Prvú noc na JIS-ke, deň pred operáciou, som siahla po telefóne. Neviem ako, ale ukrytý vo vrecku mojej motorkárskej bundy to prežil. Bol plný správ od kamarátov, ktorí ma povzbudzovali, dávali mi vedieť, že na mňa myslia a majú ma radi. Písali mi aj moji najbližší. Vonku totiž zúril Covid-19 a dostali sa len pred dvere oddelenia. Čítala som jednu správu za druhou, až kým… „Jana, neviem, čo mám povedať. Úprimnú sústrasť. Ivo bol môj kamarát. Chcel by som ísť na pohreb, ak sa to len trochu dá…“
Bác. Jane sa v tej chvíli zrútil svet. Koniec. Milovaný človek, ktorý stál po jej boku desať rokov, s ktorým cestovali, prežívali zlé aj dobré, s ktorým si plánovali spoločné starnutie, už nie je. „Moji najbližší čakali na vhodnú chvíľu, ako mi to povedať, ale nestihli to. Keď sestrička prišla ku mne, už som sa jej na Ivana nepýtala. Utrela mi slzy, pohladkala ma po hlave a držala za ruku.“
Na dne dôstojnosti Operácia trvala šesť a pol hodiny. Jana sa prebrala opäť na JIS-ke s katétrom v močovej trubici a s externým fixátorom v panve, ktorý ďalšie dva mesiace nenávidela, ale napriek tomu mu hovorila nežne – vešiačik na uteráčik. Z operovanej nohy jej trčali hadičky, ale bolesť necítila.
,,Po mojej pravici lekári a sestričky neustále monitorovali pacientku, ktorá vyskočila z okna. Bojovali o ňu dva dni, ale márne. Ďalšieho pacienta zase našli na ulici. Po úraze hlavy bol v umelom spánku. Pri vyšetrení mu zistili rakovinu pažeráka…“
Jana sa prebrala na JIS-ke s katétrom v močovej trubici a s externým fixátorom v panve.
REPORTÁŽ
32 inVitro
Na
Jana
„Do ruky mi sestrička vložila balónik s opiátom a povedala: Keď budete cítiť bolesť, stlačte ho. Stláčala som ho celý deň, ale na druhý deň som ho už odmietla. Celý život som sa liekom vyhýbala a môj strach zo závislosti bol veľký. Do žily mi však aj tak neustále tiekli analgetiká a antibiotiká,“ vracia sa ku chvíľam tesne po operácii Jana.
Pomaly si začala zvykať na svoju posteľ a izbu JIS-ky, z ktorej sa celý nasledujúci mesiac nedostala. „Po mojej pravici lekári a sestričky neustále monitorovali päťdesiatročnú pacientku, ktorá vyskočila z okna. Bojovali o ňu dva dni, ale márne. Ďalšieho pacienta zase našli na ulici. Bez dokladov, bez mena, nikto sa k nemu nehlásil. Po úraze hlavy bol tento veľký chlap v umelom spánku. Pri vyšetrení mu zistili rakovinu pažeráka… Treťou v našej čudnej partii bola staručká pani po porážke. Mala
krásne upravené, zafarbené vlasy, isto sa o seba do poslednej chvíle príkladne starala. Bola však dezorientovaná v čase aj priestore a nemohla jesť ani piť.“
Ani Jana prvé dni po operácii nič nejedla. Keď zacítila akékoľvek jedlo, obracal sa jej žalúdok. Bola slabá, ale uvedomovala si, že musí do seba niečo dostať. Keď sa jedna milá praktikantka ponúkla, že ju nakŕmi polievkou, súhlasila. A začala bojovať. Ako malé dieťa. Jedna lyžička, druhá lyžička… „To sa neviete sama najesť?“ prerušila to jemné spojenie sestrička, ktorá Janu v ten deň videla prvý raz.
„Žalúdok sa mi opäť vzpriečil, slzy sa rozkotúľali po lícach a hrdlo sa mi stiahlo. Bolo dojedené. Tá istá sestrička neskôr zdôrazňovala, aby som nejedla banány, lebo sa zapečiem. Neposlúchla som, lebo to bolo jediné jedlo, ktoré som do
 motorke prešli
s Ivanom bezpečne takmer celý svet. Osudnou sa im stala bratislavská Petržalka.
motorke prešli
s Ivanom bezpečne takmer celý svet. Osudnou sa im stala bratislavská Petržalka.
Môj mesiac na JIS-ke
Unilabs Slovensko 33
,,Hnačka ma pripravila o akúkoľvek dôstojnosť a ja som sa novej situácii musela prispôsobiť rýchlejšie, než je bežné.“
seba dostala. Aj tak sa jej predpoveď nenaplnila,“ spomína Jana, ktorá začala bojovať práve s opačným problémom.
„Silné antibiotiká narobili šarapatu v mojich črevách. Bez probiotík sa k slovu prihlásila hnačka. V črevách mi krútilo a ja som ten moment odďaľovala, ako sa len dalo. V mojom stave bola misa tabu. Jediným riešením boli plienky…“ Keď ju sestrička so sanitárom prebaľovali prvý raz, hlavu si zakrývala rukami. Ako malé dieťa – ak vás nevidím ja, ani vy ma nevidíte. „Hnačka ma pripravila o akúkoľvek dôstojnosť a ja som sa novej situácii musela prispôsobiť rých-

lejšie, než je bežné. Našťastie, v čase pandémie nosili sestričky aj sanitári na JIS-ke nie jedno, ale dve rúška naraz, čo mi dávalo akési plusové body. Boli to však otrlí bojovníci a aj pri takej činnosti, ako je prebaľovanie, si vymieňali recepty na guláš,“ hovorí, dnes už s úsmevom, Jana.
Klobúk dole
Hoci je oddelenie JIS vybavené dekubitnými matracmi, ktoré pri istých pohyboch začali masírovať telo, bolesť chrbta, ktorý bol neustále v jednej polohe, sa stupňovala.
Rúško ocenila aj ona. Hoci pre pacientov nebolo povinné, keď mužovi s rakovinou pažeráka v umelom spánku čistili sestričky dýchacie cesty, rýchlo si ho nasadila. „Klobúk dole, sestričky, ten zápach bol neznesiteľný. A hoci sa pri hygiene tohto veľkého tela útle ženy natrápili, robili ju dôkladne a nevynechali žiaden úkon. Rovnako pri mne. Umyť, prebaliť, vymeniť posteľnú bielizeň, chrbát natrieť tým príjemne chladivým gélom… Bola to jedna z vecí, ktoré ma na chvíľku vytrhli z kolotoča bolestí, prebdených nocí a smútku.“
Nechutenstvo sa začalo prejavovať aj na Janinom tele – bolo vychudnuté, svaly bez pohybu zmizli ako mávnutím prútika. Kvôli externému fixátoru mohla ležať len na chrbte. A hoci je oddelenie JIS vybavené dekubitnými matracmi, ktoré pri istých pohyboch začali masírovať telo, bo-
REPORTÁŽ
Vzácne chvíle „samoty“ na JIS-ke trvajú len pár hodín. Kým neprivezú ďalšieho nešťastníka...
,,Dlhé, skutočné rozhovory som viedla so psychologičkou, ktorá pravidelne prichádzala na oddelenie.“
34 inVitro
lesť chrbta, ktorý bol neustále v jednej polohe, sa stupňovala. Najhoršie boli noci. „Odmietla som lieky na spánok, a tak som sa pravidelne budila o druhej ráno. Každý deň som sa snažila trochu nadvihnúť a asi po dvoch týždňoch som si dokázala na pár sekúnd sadnúť. Táto poloha však bola bolestivá, lebo fixátor sa mi nepríjemne zarezával do otvorov v koži. Bol to čas, keď sestričky oddychovali – bolo počuť len prístroje, dýchanie pacientov a moje vzdychy. Nenávidela som tie dlhé, bolestivé hodiny. A prežila som ich len vďaka audioknihám a podcastom v mobile.“
Bilancovanie
Po druhom týždni na JIS-ke poznala už všetky sestričky. Aj ich slabé a silné stránky. „Vedela som, ktorá mi utrie slzy, ktorá mi rozčeše vlasy ležaním zmotané do jednej veľkej guče, ktorá sa mi zdôverí so svojím trápením. A tiež som vedela, ktorá sa ráno nepozdraví a ktorá – ak nebude mať náladu – zabudne na večernú hygienu pacientov. „Bola som na vás zo začiatku zlá. Som tu už dlho, podpísalo sa to na mne,“ povedala mi po jednom rozhovore sestrička, ktorá mi prvé dni vyčítala, že sa neviem najesť sama… Nakoniec sa stala práve ona mojou spriaznenou dušou. Potrebovala som to ako soľ. Návštevy v tom čase totiž stále neboli povolené,“ hovorí Jana.
Jej jediným spojením s vonkajším svetom, ktorý odrezal Covid-19, boli telefonáty s najbližšími a priateľmi. „Tí prví telefonovali od prvej chvíle, niektorých priateľov som musela k prvému zavolaniu povzbudiť ja. Bolo to pochopiteľné – báli sa mojej reakcie, obávali sa, že budem počas rozhovorov plakať. Keď pochopili, že nič také sa nebude diať, osmelili sa. Dlhé, skutočné rozhovory som viedla so psychologičkou, ktorá pravidelne prichádzala na oddelenie. Mohla som na ňu hodiť všetko svoje trápenie, všetky obavy a smútky a to som aj robila,“ priznáva Jana.
„Pán doktor, budem môcť športovať?“
spýtala sa na jednej z vizít traumatológa, ktorý jej operoval členok. „Budem rád, keď budete chodiť,“ odpovedal bez ser-
vítky lekár. Vtedy si nedokázala predstaviť, ako veľmi blízko bol k pravde. „A že dva roky po úraze ma bude trápiť artróza, pre ktorú budem musieť podstúpiť výmenu členkového kĺbu. Ten istý doktor ma po štyroch týždňoch na lôžku doslova prinútil postaviť sa do g-aparátu – chodúľa s kolieskami.“ Hlava sa jej krútila a keďže svaly na nohách už nemala, držala sa len silou vôle. Bol to však najvyšší čas, lebo o týždeň mali Janu previezť do inej nemocnice na rehabilitáciu. „Vybrali mi katéter, takže mojou kamarátkou sa stala misa. A konečne som sa zbavila plienok. Po ďalších troch dňoch som dokonca na veľkú prešla sama, v g-aparáte. Bol to môj výstup na Everest. A veľká motivácia, aby som sa s chodúľom pre veľkých skamarátila.“
Z JIS-ky odchádzala po piatich týždňoch. Vlastne, sanitári ju viezli na lehátku, k chôdzi ešte viedla dlhá cesta. „Lúčili sa so mnou lekári, sestričky stáli na chodbe v špalieri a kývali mi,“ vracia sa k poslednému dňu na JIS-ke Jana. Mesiac tohto zvláštneho, nedobrovoľného spolužitia v každom niečo zanechal. Zabrať dostala empatia, trpezlivosť a obyčajná ľudskosť. A hoci boli niektoré kopce vysoké, u všetkých sa nakoniec tie dobré vlastnosti vydriapali na povrch.
 Viacnásobná zlomenina nohy si vyžiadala niekoľko operácií.
Viacnásobná zlomenina nohy si vyžiadala niekoľko operácií.
Môj mesiac na JIS-ke
Unilabs Slovensko 35
,,Po ďalších troch dňoch som na veľkú prešla sama, v g-aparáte. Bol to môj výstup na Everest.“
Náhla smrť
Nik z nás tu nie je naveky. S výnimkou biblického Henocha sme všetci smrteľní a k pobytu na Zemi máme vyhradený len určitý čas. Spočiatku bezstarostný, potom naplnený povinnosťami a ku koncu stále namáhavejší. To je ten čas, keď si človek položí hamletovskú otázku: „Žiť, alebo nežiť?“ A keď sa váhy osudu začnú nakláňať k tej druhej alternatíve, objaví sa obava z toho, či bude možné tento svet opustiť dôstojne a bezbolestne. Pokiaľ možno náhle a neočakávane.

BLOG
MUDr. Antonín Polách internista Landeskrankenhaus Südsteiermark Wagna, Rakúsko www.apolach.cz
36 inVitro
Zomrieť v spánku, bez utrpenia, bez bolesti, odísť na druhý svet bez hurhaja, bez lámania rebier pri reanimácii. Bez dlhej cesty utrpenia z chronickej choroby s opätovnými pobytmi v nemocnici, s pichaním do žily a ďalšími nepríjemnosťami. Všetci si to prajú, len málokomu sa to splní. Choroby si nevyberáme, ony si vyberajú nás.
Moja stará mama mala také šťastie. Mala už vyše osemdesiatosem rokov, keď zatelefonovala svojej sesternici, že nepríde na oslavu jej narodenín, lebo sa necíti celkom dobre, potom si sadla do kresla a zaspala na večnosť. Zrejme sa dostavili poruchy srdcového rytmu, najčastejšia príčina takého pokojného odchodu na druhý svet. Priali sme jej taký koniec, zaslúžila si ho, keď jej ani perzekúcie fašistov a neskôr komunistov nevedeli zobrať radosť zo života a dobrotu, s ktorou sa správala aj k tým, ktorí jej škodili. Práve o takom konci života v deväťdesiatke snívame, s poruchami srdcového rytmu, pokiaľ možno bez predchádzajúceho infarktu – to aby to nebolelo. Aj môj dedo, jej muž, zomrel náhle. Príčinou bola pľúcna embólia. Pre pacienta náhla bezbolestná smrť, pre prítomných ale oveľa dramatickejšia. Bohužiaľ nevieme, nakoľko pacient cíti, že sa náhle udusil a nakoľko tým trpí. A navyše, dedo mal len 58 rokov, to je na smrť, aj náhlu, jednoducho priskoro. Pretože dedo zomrel v čase násilnej komunistickej kolektivizácie poľnohospodárstva, babička komunistom jeho smrť nikdy neodpustila.
Zomrieť sa dá na veľa rôznych spôsobov, niekedy to môže byť aj veľmi dramatické, napríklad keď sa to stane za volantom pri jazde autom. Môj priateľ Mirek sníva o tom, ako zomrie v osemdesiatke za volantom Mercedesu, v ktorom sa povezie s dvadsaťročnou milenkou. Samozrejme mu
želám, aby sa mu to splnilo. Len rozmýšľam, ako to urobiť, aby to dievča prežilo. Ale keď už si so starkým sadlo do auta, musí mu byť predsa riziko takého konania známe.
Bezvedomie za volantom je vždy zlá vec, je to jedno, či sú jeho príčinou poruchy srdcového rytmu, epilepsia, či hypoglykémia. Tak zomrel manžel našej nemocničnej psychologičky. Mal 47 rokov a jeho žena mala nemalé problémy, aby sa dostala k volantu a hlavne k brzde a auto zastavila. Kedysi dávno pred Žilinou som pomáhal ošetrovať ľudí z autonehody, ktorú spôsobil muž, ktorý dostal za volantom infarkt, prešiel do protismeru a zrazil sa frontálne s iným autom. Našťastie, ľudia v tom druhom aute prežili, aj keď boli doráňaní. Najviac ma ako mladého doktora vydesilo veľké množstvo červenej tekutiny rozliatej po celom aute. Ako sa ukázalo, nebola to krv, ale malinová šťava, ktorú viezla babka k príbuzným, ktorých chcela rodina navštíviť.
Za môjho pôsobenia v Hranovnici mi niekoľkokrát priviezli mladého diabetika v hypoglykemickej kóme. Pichal si inzulín, ako ho napadlo a jedol rovnako nepravidelne. O to radšej sa nalieval alkoholom. Po treťom takom stave som si uvedomil, že má vodičský preukaz a pretože naďalej – napriek môjmu varovaniu – chodil po dedine autom, dal som podnet, aby mu ho odobrali. Veru som si tým veľmi nepomohol, ani u neho, ani u jeho kamarátov z krčmy. Práve nemierna spotreba alkoholu vo výčape, kde sa nevarilo, bola hlavnou príčinou jeho opakovaných nízkych hladín krvného cukru. Desiatu si so sebou do krčmy očividne nenosil.
Problémom je, keď náhla smrť, hoci aj tichá a bezbolestná, príde priskoro. A vek, v ktorom koniec života akceptujeme ako prirodzený, sa stále posúva nahor. Zatiaľ čo v devätnástom
Náhla smrť
Unilabs Slovensko 37
Nebezpečenstvo, že sa dýchacie cesty pri apnoe neotvoria a človek zomrie, sa zvyšuje požívaním alkoholu alebo tabletiek na spanie – benzodiazepínov.
Pľúcna embólia – pre pacienta náhla bezbolestná smrť, pre prítomných ale oveľa dramatickejšia: nevieme, nakoľko pacient cíti, že sa náhle udusil a nakoľko tým trpí.
storočí oslovili študenti päťdesiatročného profesora Palackého „ctihodný kmete“, dnes sa ani sedemdesiatnici necítia byť starí a sú v živote plne aktívni s vôľou užívať si život.
Existuje ale veľa príčin, ktoré im v tom môžu zabrániť. Zomrieť v spánku je síce pekné, nie ale, keď to postihne 53-ročného muža. Tak sa stalo môjmu redaktorovi, ktorý pripravoval na vydanie moju prvú knihu. Trpel na spánkové apnoe, vtedy ešte celkom neznámu diagnózu. Títo ľudia majú v noci pauzy pri dýchaní, pričom sa im uzatvoria dýchacie cesty zapadnutým jazykom. V čase dychovej pauzy klesá saturácia kyslíka v krvi, väčšinou to vyvolá záchranný reflex, keď sa za hlasného chrápania (takzvaný Aroussal) dýchacie cesty otvoria a postihnutý pacient hyperventiláciou doháňa stratený kyslík. Toto ochorenie postihuje prevažne ľudí s nadváhou (nie ale výhradne, zažil som aj celkom štíhlych ľudí s touto poruchou), nebezpečenstvo, že sa tie dýchacie cesty neotvoria a človek zomrie, sa zvyšuje požívaním alkoholu alebo tabletiek na spanie – benzodiazepínov. Čo práve títo ľudia radi berú, lebo majú pocit, že sa bez liekov dobre nevyspia. Že môže existovať určitá dedičná
predispozícia, na to ma upozornil fakt, že z rovnakej príčiny zomrel vo veku 48 rokov aj syn môjho redaktora – po oslave, na ktorej sa alkoholom nešetrilo.
Človek môže zomrieť na vykrvácanie v takzvanom hemorhagickom šoku. Keď krv strieka z tela von, nedá sa to prehliadnuť, niekedy ale môže byť situácia oveľa zákernejšia, keď krv vyteká nepozorovane niekde do telesnej dutiny, najčastejšie do žalúdka.
Pani, ktorú budem nazývať Jelínek (mala síce iné, ale tiež slovanské meno ako pozostatok niekdajšieho rakúsko-uhorského mocnárstva), dorazila do našej ambulancie, pretože sa cítila slabá. O chvíľu nasledoval reanimačný alarm. Keď som pribehol do ambulancie, stláčala kolegyňa panej Jelínek hrudník a na monitore bola rovná čiara – zástava srdca. Zaintubovali sme a pokračovali v reanimácii. Všimol som si, že pri každom stlačení hrudníka vychádza pacientke zo zadnej časti tela čierna kaša – stolica bola plná natrávenej krvi. Po adrenalíne a infúziách sa podarilo ako tak stabilizovať jej obeh, s anesteziológom sme ju odviezli na endoskopiu a tam sa mi podarilo kovovým klipom utesniť krvácajúcu artériu v žalúdku. Keď prišiel jej krvný obraz, nechceli sme výsledkom veriť. Pani Jelínek mala desatinu normálnych hodnôt, prežila len preto, že bola mladá. Dostala neúrekom transfúzií a poobede som ju už mohol extubovať a odpojiť od dýchacieho prístroja. Keď sa anesteziológ prišiel večer na pacientku pozrieť a ona ho pozdravila „Dobrý večer, pán doktor,“ skoro odpadol. Aj tak sa dá prežiť náhla smrť. Príčinou žalúdočného krvácania bola neliečená cirhóza pečene spôsobená autoimúnnou chorobou. Pani Jelínek sa podarilo presvedčiť, aby si dala pečeň transplantovať, asi pred rokom som ju stretol na ulici a jej
BLOG
38 inVitro
„Dobrý večer, pán doktor“ ma naozaj potešilo. Našťastie, nežijeme v čase antiky, aby som sa musel báť o život. Vtedy bolo gréckymi bohmi prísne zakázané priviesť naspäť do života ľudí, ktorí už sedeli v Charónovej loďke na ceste na druhý svet. Tým rozzúril Asklépios do nepríčetnosti boha podsvetia Hádesa a Jupiter ho za to zabil bleskom. Neviem, nakoľko Asklépia potešilo, keď ho neskôr ako odškodnenie prijali na Olymp medzi bohov ako boha lekárstva.









Iný pacient také šťastie ako pani Jelínek nemal. Pretože sa staral o svoju nemohúcu ženu, priviezli ho do nemocnice, až keď upadol do bezvedomia. Cievu v žalúdku sa síce podarilo klipom utesniť a krvácanie zastaviť, ale nasledovala zástava krvného obehu, ktorú sa nám nepodarilo zvládnuť. Pacient mal 88 rokov a bolo mi ho naozaj ľúto. Zomrel, pretože nechcel nechať svoju ženu samu. Príčinou bol vedľa stresového vredu v žalúdku aj liek na antikoaguláciu, ktorý berie z najrôznejších dôvodov väčšina starých ľudí. Čo čert nechcel, práve v ten deň prišla do nemocnice zástupkyňa farmakologickej firmy robiť na tento liek reklamu. Povedal som jej, čo sa stalo, viackrát ma už nenavštívila. Asi si to zobrala osobne.
Náhlou smrťou je aj samovražda. Najčastejšie sú v hre tabletky. Ľudia si myslia, že pokojne zaspia. To sa podarí len menšine. Oveľa viac ľudí zomiera na udusenie zvratkami alebo v dôsledku zápalu pľúc vyvolaného vyvracanou potravou, ktorá sa dostala do dýchacích ciest. Absolútna väčšina takýchto samovrahov ale samovraždu tabletkami iba predstiera, aby potrestali partnera, s ktorým sa pohádali, alebo je to zúfalé volanie o pomoc. Niektorí si dokonca sami zavolajú sanitku.
V Murau, v rakúskych horách, boli ľudia oveľa tvrdší a so samovraždami to mysleli vážne. Kolegyňa mala výjazd k mužovi, ktorý sa obesil a pre istotu sa pritom ešte aj strelil svojou loveckou puškou do hlavy. Napriek tomu žil ešte tri dni.

O čom muži snívajú v súvislosti s náhlou smrťou, je zomrieť pri najpríjemnejšej činnosti, teda pri sexe. Tak sa o tom rozprávali vo filme Podivné dedičstvo s Terencom Hillom v hlavnej úlohe. Skutočnosť môže byť oveľa viac stresujúca, ako to popísal vo svojej poviedke Služka Jiří Wolker. Najviac sú ohrození páni, ktorí majú choré srdce a berú na neho lieky, takzvané nitráty a chcú si pomôcť viagrou alebo látkami z rovnakej kategórie. A najmä, keď sa jedná o sex mimomanželský. Pri ňom údajne muži vyvíjajú v porovnaní s milovaním v manželskej posteli o 25 wattov vyšší výkon – zrejme je za tým ctižiadosť. Ako to grazskí profesori Schumacher a Brussee merali, som nezisťoval, ale čítal som to čierne na bielom.
Takže páni, opatrne. Ak pri návšteve milenky nejde o samovražedný pokus, dajte si radšej pokoj!
V čase antiky bolo gréckymi bohmi prísne zakázané priviesť naspäť do života ľudí, ktorí už sedeli v Charónovej loďke na ceste na druhý svet.



Najviac sú ohrození páni, ktorí majú choré srdce a berú na neho lieky, takzvané nitráty a chcú si pomôcť viagrou alebo látkami z rovnakej kategórie.

Náhla smrť
Unilabs Slovensko 39
Moja smrť ma





















zaujíma najmenej







Dve jeho sestry zomreli v mladom veku a za nevyjasnených okolností. On však po tom nepátral, pretože zaoberať sa smútkom a strachom považuje za mrhanie energiou, ktorú si treba šetriť pre živých. Princ z rozprávky Princ a Večernica s Libušou Šafránkovou, herec JURAJ ĎURDIAK sedel na javisku skôr, než dočiahol zo stoličky nohami na zem, no v živote si vyskúšal aj iné roly ako herecké. Bol spevákom, kaviarnikom, podnikateľom i riaditeľom divadla. Ak má predsa len z niečoho strach, tak je to nedostatok zaujímavej práce a závislosť od pomoci iných.









Autor: Elena Akácsová, publicistka, foto: TV JOJ
OSOBNOSŤ 40 inVitro
Témou tohto čísla sú náhle úmrtia. A vy s tým máte celkom blízku skúsenosť, pretože vaša sestra, herečka Judita Ďurdiaková, mala v roku 1992 smrteľnú autonehodu. Čo sa vtedy vlastne stalo?
Vracala sa v aute so svojím manželom, rakúskym veľkopodnikateľom z Trnavy. V tom čase sme mali sieť predajní, ktorú som ja viedol a ona chodila na kontroly. Niekde medzi Sencom a Bratislavou sa otáčal kamión a jej muž do toho kamiónu vrazil. On bol za volantom, jemu sa nestalo nič. Ona bola vedľa a zomlelo ju to strašným spôsobom. Ešte nejaký čas žila, ale aj lekári a aj ja – už vtedy som bol taká povaha – sme sa modlili, nech to skončí, lebo to by už nebol človek. Nikdy sme sa nedozvedeli, ako to vlastne bolo, nikto to nevyšetroval a ak aj vyšetroval, tak to veľmi rýchlo vysublimovalo.
Prečo to nikto nevyšetroval?
Čo ja viem? Keď ste v tej situácii, asi človeku nenapadne po tom pátrať. Ale čo by sa tým zmenilo? Ona už tu nie je. Možno ten chudák v tom bol nevinne, možno bol ožratý. Neviem. Nikdy som nemal túžbu to riešiť, lebo by som robil zle len sebe. Najlepšie je odblokovať sa, vypnúť emócie, vziať to ako fakt a ide sa ďalej. Navyše, v našej rodine to bol už druhý prípad. Mal som ešte jednu sestru Evu, ktorá emigrovala okolo roku 1968, vyštudovala dejiny umenia a veľmi rýchlo sa vypracovala ako odborná pracovníčka vo viedenskej Albertine. Mala tam partnera zo Slovenska, ale od neho sme sa nikdy nič nedozvedeli. Len k nám nejako presiakli informácie, že Eva leží v nemocnici a je na tom zle. Nemohli sme tam ísť, ani mama, ani otec, a odrazu len bolo po nej a riešilo sa, či rakvu, alebo urnu… Viete, ja som si zvykol.
Dojíma ma, keď je niekto ťažko chorý, keď sa má zle a keď
ho niečo bolí.
Ale keď niekto zomrie, tak čo?
Nebáli ste sa, že do tretice ste na rade vy?
Nie. Moja smrť ma zaujíma najmenej. Verte tomu. Aj keď mám toľko rokov, je to stále taká nepravdepodobná situácia, že sa ma emocionálne vôbec nijako nedotýka. Keby som bol vážne chorý, možno by som nad tým uvažoval. Mám tisíc zdravotných problémov, ale ani jeden nie je taký, že by ma priviedol na smrteľnú posteľ.
Máte zvláštny vzťah ku smrti. Veľmi zvláštny. Mňa to nedojíma, ani keď mi nedávno zomrela kamarátka, ktorú som dlhšie nevidel. Myslím si, že smrť je súčasťou života, hoci to znie ako paradox alebo nezmysel.
Dojíma ma, keď je niekto ťažko chorý, keď sa má zle a keď ho niečo bolí.
Ale keď niekto zomrie, tak čo? Zavriem knihu a hneď otváram ďalšiu.
Nie som ochotný nechať sa ovplyvňovať touto témou.
Nie je smútok za zosnulým v podstate sebaľútosť? On už to má za sebou, to my sme tu zostali...
Mal som kamaráta, ktorý bol psychiater. Veľmi zvláštny psychiater. Jeho obľúbená liečebná metóda – teda liečebná, ja som nebol taký
chorý, že by ma bolo treba liečiť, ale chodil som sa s ním radiť, lebo som si myslel, že o duši vie viac ako bežný človek – bola: Kopni si jeden fernet a neotravuj! Keď bola chorá moja mama a prišla na pretras téma smrti, povedal mi: Ona zomrie. Zajtra, pozajtra. Tak sa na to priprav.
Ako sa dá na to pripraviť?
Dá sa sústrediť na to, aby ste zomierajúcemu ten čas, čo mu zostáva, spríjemnili čo najviac, odpútali jeho pozornosť, ak sa dá, ak ho to veľmi nebolí. Proste sústrediť sa na komunikáciu, ktorá ešte je, vycicať z tej príležitosti, zo vzájomného spolubytia, čo sa dá – možno je to škaredé slovo, ale dobre myslené. A potom, keď sa to stane, tak si dokážem povedať, že som urobil všetko pre to, aby to dopadlo čo najlepšie. Ide sa ďalej.
Aký ste mali vzťah s mamou?
Veľmi dobrý, i keď ona bola Nemka a to v jej prípade niečo znamenalo. (Smiech.) Bola kvadratický človek. Nebola to matka zamilovaná do svojich detí, hoci sme od nej dostali všetko a v tomto bola hrdinka, lebo mala dve nevlastné deti, bolo nás päť.
smrť ma zaujíma najmenej
Moja
Unilabs Slovensko 41
Keď bol v hoteli Brežnev, vyžadoval 17 stupňov, aby ho neporazilo, aj vo výťahu, úplne všade.
A vôbec za ňou nesmútite?
Smútok a pocit, že tu ostane prázdne miesto, ten tu, samozrejme, je. Ale ten kamarát ma ešte naučil toto: nezodieraj si organizmus tým, že budeš rumázgať, to ti nič neprinesie. O to menej životnej sily budeš mať pre človeka, ktorému je zle a ty mu nebudeš vládať pomôcť, lebo ho uvidíš a zasa sa rozplačeš, utečieš preč. Nemyslím to ani cynicky, ani bezcitne.
Sú ľudia, ktorí majú premyslený aj svoj pohreb. Aj aká hudba sa tam má púšťať.
To majú v našej rodine všetci. Otec nie, lebo on mal o sebe predstavu, že je nesmrteľný ako rímsky cisár. Ale moja mama má sestru, ktorá ešte žije v Budapešti, má asi 190 rokov a už mi dávno odovzdala obálku, že tu máš program, tam je asi všetko napísané, aj hudba.
A vy už máte program?
Viem, ako by som chcel, aby to bolo. Ale ja vôbec nepociťujem potrebu niečo po sebe zanechať, v zmysle nejakého pomníka, hrobu. Je vtipné, že sa bavíme o smrti pre časopis o zdraví.
Dobre, tak ako sa stalo, že ste hercom?
Celkom prirodzene. V dnešnom prezidentskom paláci bol Dom pionierov a mládeže Klementa Gottwalda. Boli
tam rôzne zaujímavé krúžky, boli tam bábkari, herci aj baníci…
Baníci?
Áno, banský krúžok tam bol.
Tam ste sa prihlásili?
Nie. Vy sa smejete, ale oni mali v suteréne normálne uhlie, učili sa nakladať a vykladať. To bola nádherná doba plná absurdít. Moja sestra Judita sa ocitla v bábkarskom krúžku a mňa nemal kto strážiť. Tak jej nakázali, aby ma zobrala so sebou.
Vedúca súboru, Milka Mikulková, nádherná osoba, výtvarníčka, milovala deti a okamžite si poradila aj s týmto votrelcom.
Koľko ste mali rokov?
Tri. Niektorí sa potom vyjadrovali, že ešte si nedočiahol nohami zo stoličky na zem, keď si sedel na javisku.
Ona ma vyzvala, aby som niečo rozprával, ja som asi niečo rozprával, to bolo moje prvé vystúpenie – a ostal som tam do maturity. Bol to na tú dobu kvalitný súbor, ona robila nádherné výtvarné bábky a mal som tam kamarátov, takže potom tak nejako prirodzene som si dal prihlášku na herectvo.
Ako ste si v detstve predstavovali, že bude vyzerať váš život?
Nespomínam si, ale pamätám si a sem-tam sa mi to stane aj teraz,
že keď počúvam hru na klavíri, predstavujem si, že som to ja. Určite som sníval aj o svetovej hereckej kariére. Lenže herectvo má jedno veľké obmedzenie, a to jazyk. Dnes trochu menej, ale v divadle to platí stále, tolerujú vás nanajvýš v Česku. Moja generácia považovala za vrchol pyramídy Národné divadlo. To bola špica a odtiaľ už vlastne nebolo kam. Dnes je to všetko z rôznych dôvodov inak, ale určite som sníval o svetovej kariére. Podarilo sa mi to v tom, že som nakrúcal nemecké a maďarské filmy, v podstate som sedem rokov žil v hoteli. Aj s Brežnevom som býval!
A to sa vám ako podarilo?
Býval som v hoteli Stadt Berlin, bol to komunistický výstavný hotel v strede mesta. Za tie roky som sa už poznal s personálom, vždy som mal pripravenú tú istú izbu, číslo 2202. Poznal som sa aj s námestníčkou riaditeľa a tá mi raz hovorí:
Budeš tu, alebo pôjdeš domov?
Lebo príde Brežnev. Z toho vyplývali rôzne obmedzenia, nemohli sme dnu ani von a keď už, tak inokade.
A odrazu bola v hoteli zima, lebo on vyžadoval 17 stupňov, aby ho neporazilo, aj vo výťahu, úplne všade. Ukazovala mi, na ktorom poschodí nikdy nezastaví výťah, lebo sú tam len odpočúvacie miestnosti, magnetofóny, kamery.
OSOBNOSŤ
42 inVitro
Z čoho máte strach?
Nechcel by som sa ocitnúť v bezmocnej situácii. Aby ma niekto kŕmil a prebaľoval. Z toho mám strach, nie som za umelé predlžovanie života, lebo to nikam nevedie. A potom mám strach, že by som zostal bez práce. Som naučený neustále pracovať. Bol som kaviarnik, hral som v troch divadlách naraz, Nová scéna, Národné divadlo, Komorná opera, točil som filmy, herectvo som neopustil, aj keď podnikanie fičalo naplno. Neviem vypnúť.
A ako oddychujete? Čítam.
O dom a záhradu sa nestaráte?
Mám malú záhradu a záhradná architektka mala zadanie urobiť takú, v ktorej netreba robiť. Čiže žiadny trávnik, pár stromov a samé okrasné kríky, len tie treba strihať, lebo to rastie ako bláznivé a treba zbierať hovienka po psoch. Mám tam sedenie, bazén, tri krby, lebo mám rád oheň, takže ja sa viem prezabávať bez toho, aby som sa zodral.
Keby u vás horelo, nechali by ste všetko zhorieť, aj tých 1 006 anjelov, čo vám kedysi ľudia nanosili do vašej slávnej kaviarne U anjelov?
Naopak. Mne by bolo ľúto za všetkým. Nič som nezískal ľahko.
Zhoreli by ste tam s tým?
To nie je vylúčené. Som veľmi materiálne založený, mám rád svoje veci, svoje auto, svoj dom. Našťastie, lebo to považujem za kľúčovú záležitosť, aby mal človek domov, ktorý má rád. Ja hovorím, že sa nevraciam domov, ale len vychádzam z domu – na rozhovor, do práce, nakúpiť, ale tam je moje miesto, kde sa cítim najlepšie a bezpečne.
Keby ste sa mohli vrátiť strojom času do nejakej časti svojho života, kam by ste išli?
Mám dva také úlety. Prvý do doby, keď som veľa točil. V pondelok Budapešť, v utorok Praha, v stredu Budapešť, štvrtok Praha, všade som bol hosťom a tak sa ku mne aj správali. S Brežnevom som nielen býval, ale vozil som sa aj v rovnakom aute, v čajke. Mafilm v Budapešti totiž jednu vlastnil. Spravili mi vzadu ležovisko a vozil som sa v čajke. Ja a Brežnev. A potom by som sa
Juraj Ďurdiak (71)

● Je slovenský herec.
● Vyštudoval herectvo na VŠMU v Bratislave a operný spev na Konzervatóriu v Bratislave.
● Pôsobil v Divadle pre deti a mládež (dnešné Divadlo Jána Palárika) v Trnave, v Poetickom súbore Novej scény, v Komornej opere pri SF a v Komornej opere SND.
● Bol umeleckým šéfom aj riaditeľom Divadla Nová scéna, manažérom Štúdia L+S.
● 15 rokov prevádzkoval legendárnu bratislavskú kaviareň U anjelov.
● Hral v slovenských, českých, maďarských a nemeckých filmoch, v mnohých slovenských rozprávkach, najviac ho preslávil princ Velen v rozprávke Princ a Večernica po boku Libuše Šafránkovej.
● Aktuálne hrá v seriáloch Iveta a Nemocnica.
Moja smrť ma zaujíma najmenej
Unilabs Slovensko 43
V
chcel vrátiť do takých období, nebolo jedno, keď som bol najviac zamilovaný. Hoci to nebolo sladké, ani presvetlené slnkom, obyčajne sú to skôr obdobia strachu, bolesti, pocitu nedostatočnosti, že nedostávate toľko, koľko by ste chceli, ale malo to čosi do seba.
A zmenili by ste niečo vo svojom živote, keby ste mohli?
Samozrejme, že by som si vedel predstaviť urobiť tisíc vecí inak. Napriek tomu, že nemám za sebou neúspešný život, jednu zásadnú výhybku by som asi veľmi zvažoval – že by som nežil tu. Lebo život v tejto krajine ma nesmierne obťažuje. Prekážajú mi politické situácie, nastavenie spoločnosti na rôzne témy, nielen na témy, ktoré sa ma osobne dotýkajú. Neviem, či by to bolo inde lepšie, lebo som to neskúsil.
A prečo ste neodišli? Práca? Láska?
Zbabelosť. Tak sa to volá. Keď som točil v Maďarsku, mal som ponuku
od riaditeľa Národného divadla a to bolo, ako keby mi Werich povedal, že mi pomôže. Nepredstaviteľné. Zľakol som sa tej príležitosti. No a keď v roku 1980 emigroval môj brat na mojom aute, išiel som si do Nemecka pre to auto. Bola tam spoločnosť emigrantov, ľudí, ktorí robili v divadle, a tí mi ponúkli pomoc. Ešte tu, vo Wolfsthale, pred hranicami, pozerajúc na Bratislavský hrad, som rozmýšľal: Idem? Nejdem? Ale nebolo to nikdy myslené naozaj. To bola len taká hra samého so sebou.
V tom čase ste boli slávny princ z Princa a Večernice, nie?
Vonku nie. V Hainburgu už ste nikto. Len tu som vždy dostal v zelovoci väčšie mandarínky ako druhí.
Naozaj?
No samozrejme. Veľa som hral, v inscenáciách som bol buď princ, alebo ten chudák chudobný chlapec. Nikdy som nehral družstevníka, to so mnou nefungovalo.
A lekára ste niekedy hrali? V seriáli Nemocnica teraz hráte doktora Srnčíka, ale on má Alzheimera, tam už z toho povolania asi veľa neukážete. Boli tam situácie, keď ho jeho syn, tiež lekár, zobral do nemocnice a jemu pamäť naskočí. To sa vraj kľudne môže stať. Vrazí do operačky a presne povie: „Urob to takto. Dobre to robíš. Zle to robíš.“ A potom zasa vypne. Ale toto je „tepláková“ rola, čo je pre mňa celkom zážitok, lebo ja som tepláky nikdy nemal, ani nemám, my sme neboli teplákové deti v našej rodine. Užívam si aj zážitok hrať s Emilom Horváthom, až teraz vidím, aký je on veľmi presný. A je s ním sranda.

Predtým ste s ním nikdy nehrali?
Robil som s ním Búrlivé víno, ale tu sme spolu tak nejako intímnejšie. Pri jednom stole. Mám veľmi rád kolegov, ktorí svoje remeslo perfektne ovládajú, majú naučený text a udržia situáciu tak, ako si ju vymysleli. To je krásna práca.
OSOBNOSŤ
seriáli Nemocnica hrá bývalého lekára.
44 inVitro
Keď už spomíname lekárov, aký k nim máte vzťah?

Veľmi dobrý. Naozaj. K lekárovi prichádzam ako pacient, s dôverou, čo mi povedia, to urobím, čo mám prehltnúť, to prehltnem. Snažím sa nepreháňať svoje problémy ani ich nepodceňovať, hoci každý, pokiaľ ide o jeho zdravie a jeho telo, je sebastredný. Ale priznám sa vám, že ma obťažuje, keď musím podstúpiť zmenu lekára. Mám lekárov, ku ktorým chodím tridsať rokov. Poznajú moje diagnózy naspamäť a mne sa to nechce niekomu znovu vysvetľovať. Pri takejto príležitosti veľmi rád poznamenávam jednu z najhlbších životných právd, ktorá nie je z mojej hlavy, ale stotožňujem sa s ňou, že keď niekto povie, že staroba je zlatý vek života, mohol to vysloviť len veľmi mladý človek alebo idiot. Vek vám prinesie určité bonusy, ale tvrdo si vypýta iné veci.
Dostali ste niekedy radu, ktorú teraz dávate ďalej?
Umelcom stále radím, aby sa naučili nehrať. Mám rád bytostné herectvo, bytostný prejav. Keď som preberal Cenu za celoživotné dielo, označili ma za minimalistického herca. To som prijal, aj som si osvojil ten výraz, lebo nenávidím prehrávanie, grimasy a som pyšný na to, že také ponuky dokážem odmietnuť. A pre ostatných mám radu, ktorá znie trošku v protiklade s tým, že tu už hodinu rečním: Nehovor nič! Vnímaj, počúvaj, mysli si a len tam, kde to narazí na hranicu toho, že je bezcharakterné niečo neubrániť, to tam povedz, ale ináč netreba hovoriť.
V minisérii Iveta si zahral majiteľa striptízového klubu.
Moja smrť ma zaujíma najmenej
Unilabs Slovensko 45
Vek vám prinesie určité bonusy, ale tvrdo si vypýta iné veci.
Ak chceme dieťa ochrániť, vstúpme do jeho online sveta



S cieľom prilákať čo najväčší počet sledovateľov sa výzvy na sociálnych sieťach stávajú čoraz extrémnejšie. Deti nabádajú k tomu, aby zadržiavavali dych až do straty vedomia, skákali pod idúci vlak, či jedli paracetamol… O tom, ako urobiť internet bezpečným miestom pre deti a tínedžerov, sme sa porozprávali so Zuzanou Juránekovou z občianskeho združenia IPčko.










AKTUÁLNE
Autor: Jana Klimanová
46 inVitro
Foto: Shutterstock, archív Z. Juráneková, M. Madro












Ak chceme dieťa ochrániť, vstúpme do jeho online sveta Unilabs Slovensko 47
Zážitky pozornosti, podpory a povzbudenia by mali prichádzať aj z offline priestoru a od najbližších.
Prečo sú výzvy na sociálnych sieťach pre deti a tínedžerov príťažlivé aj napriek tomu, že sú nebezpečné?
Pretože sa odohrávajú v prirodzenom prostredí mladých ľudí, teda v online priestore. Vďaka tomu môžu byť virálnejšie, oveľa intenzívnejšie, aj reakcie na ne sú v oveľa väčšom rozsahu.
Každá generácia v tínedžerskom veku plní rôzne výzvy, podstupuje dobrodružstvá, ktoré k tomuto vývinovému obdobiu prirodzene patria. Aj my sme ich kedysi plnili na našej ulici, v našej skupine rovesníkov. Takisto sme sa hecovali – toto zvládneš, to nedokážeš… Mali sme publikum, ktoré nás povzbudzovalo a tlieskalo nám.
Publikum v online priestore je však oveľa väčšie… Áno, môže byť dokonca z celého sveta a odpovede prichádzajú rýchlejšie. Naplnenie pocitov prichádza oveľa skôr a je intenzívnejšie. Práve toto instantné nasycovanie potrieb je na internete rizikové. Dôležité je, aby mladí ľudia nemali k dispozícii len tento jeden zdroj, ale aby zážitky pozornosti, podpory a povzbudenia prichádzali aj z offline priestoru a od najbližších.
Čo všetko sa ukrýva za potrebou zúčastňovať sa výziev – túžba po pozornosti a pochopení, ktoré deti a mladí ľudia nenachádzajú vo svojom okolí? Je za tým potreba zaujať, odlíšiť sa, zabodovať u kamarátov alebo naopak splynúť s davom a nebyť outsiderom, ktorý nič nedokáže?
Zapájanie sa do online výziev je spôsobom, ako mladí ľudia získavajú pozitívnu pozornosť okolia a pocit, že sú súčasťou väčšej komunity. Každý mladý človek si chce napĺňať potreby pozornosti a záujmu okolia. Ak sa mu ich nedarí napĺňať offline, tak sa do výzvy zapojí oveľa ľahšie, pretože veľmi túži po tomto zážitku. Ak ho k zapojeniu do výzvy povzbudzuje skupina, do ktorej chce patriť
a nechce z nej byť vylúčený, môže viesť k nasledovaniu očakávaní skupiny. Mladý človek nechce vytŕčať z davu, byť čiernou ovcou skupiny, a tak sa podvolí tomu, čo od neho očakáva skupina.
Aká je situácia u nás? Zapájajú sa do výziev aj slovenské deti?
Rok 2022 bol plný online výziev. Na Slovensku sme sa stretli s paracetamolovou výzvou, s blackout challenge – zadržaním dychu až do straty vedomia, či s trainsurfingom – vozením sa na strechách a vagónoch idúcich vlakov. Mnohé z výziev tu už boli pred rokmi, napríklad paracetamol tu bol už v roku 2015. Niekto ich len opráši, zavesí na novú sieť a dostane opäť do hry.
S akými problémami sa na vás deti v súvislosti s online výzvami obracajú?
Je to rôzne, kontaktujú linku pomoci s obavami, že príde rad na nich a niekto ich vyzve, ale aj s tým, že sa do výzvy zapojili. Boja sa, že nie sú dostatočne silní na to, aby výzvu odmietli, majú strach, že ich ostatní vylúčia z kolektívu. Do plnenia výzvy však nejdú bezhlavo – rozmýšľajú, zvažujú. A hoci v tomto veku už vedia identifikovať teoretické riziko, ak sa ocitnú v reálne nebezpečnej situácii, pri rozhodovaní viac podliehajú emóciám. Konečné rozhodnutie ovplyvňuje viac snaha zapáčiť sa rovesníkom než reálne zhodnotenie rizikovosti a potenciálnej nebezpečnosti situácie.
Strach, že budú vylúčení z kolektívu, je oveľa väčší než strach z následkov?
V tínedžerskom veku, keď zohráva skupina najdôležitejšiu úlohu, je zlyhanie takmer nepredstaviteľné. Túžba niekam patriť, byť prijatý, hrá v živote mladých ľudí dominantnú úlohu. V období dospievania či adolescencie sa odpútavajú od rodičov, čo sa prejavuje v oslabení noriem a hodnotového systému. V tomto čase získavajú v ich
AKTUÁLNE
48 inVitro
Dieťa do desiatich rokov prijíma svet tak, ako mu ho rodič podáva.
životoch omnoho väčšiu váhu rovesníci. Preto sú na hodnotenie zo strany rovesníkov a okolia veľmi citliví.
Čo poradíte tínedžerovi, ktorý zavolá na vašu linku pomoci?
Mladí ľudia s nami prevažne chatujú, je im to prirodzenejšie, telefón viac využívajú iné vekové kategórie. Aj keď sa na nás v jednej chvíli obrátia dvaja mladí ľudia s veľmi podobnou témou, nikdy to nie sú dva rovnaké rozhovory. Ani nemôžu byť, pretože každý z nás je iný, máme iné prežívanie a u každého pomáha na to, aby sme sa cítili lepšie, niečo iné. Naši psychológovia preto pristupujú ku každému individuálne. Nedávame žiadne univerzálne rady, pretože nefungujú. Ak by mne napríklad povedali – choď si zabehať, bude ti lepšie, budem nešťastná, pretože vôbec nie som športový typ a pri behaní by som trpela ešte viac. Inému to, samozrejme, môže pomôcť. Dávame len odporúčania, ako otvoriť citlivé témy s rodičmi. Prípadne radíme priamo rodičom, ako tieto témy s deťmi otvárať.
Koľko detí sa na vás obracia práve kvôli téme online výziev?
Naša štatistika sa venuje fenoménom internetu. V roku 2021 sme v tejto oblasti zaznamenali nárast asi o 170 %, v minulom roku sa v rámci tejto témy na nás obrátilo 2 212 detí
a mladých ľudí. Máme tiež samostatný pomáhajúci web s názvom stalosato.sk, ktorý sa špecializuje na témy fenoménov internetu a online bezpečnosti. Predtým, než v roku 2019 vznikol, sa na nás v akútnej samovražednej kríze obrátilo približne 600 detí a mladých ľudí s úmyslom ukončiť svoj život. Na túto hranu ich dostal práve kybergrooming, psychická manipulácia detí dospelými v online priestore. Deti a mladí ľudia nevedeli, ako z toho von, nemali pri sebe nikoho, komu by sa mohli zdôveriť. Nemali bezpečný priestor, v ktorom by mohli svoje „tajomstvo“ zdieľať. V čase, keď túto tému v spoločnosti otvoril film V sieti, sme na pomoc mladým ľuďom pripravili spomínaný web, kde im ponúkame anonymnú pomoc. Po zriadení webu stalosato.sk sme v roku 2020 mali asi 700 kontaktov, ale ani jeden nebol v akútnej kríze. Deti a mladí už vedeli, na koho sa môžu obrátiť. Ak sa im na internete dialo niečo nepatričné, požiadali nás o pomoc oveľa skôr.
Ktorá veková skupina je najviac ohrozená?
Najviac ohrození sú 11- až 14-roční a potom je to tiež veková kategória 15 – 18 rokov. Práve obdobie puberty je zlomovým pri stotožňovaní sa s istými modelmi správania. Skrýva sa za tým túžba po pozornosti a pochopení.
Ak
online
chceme dieťa ochrániť, vstúpme do jeho
sveta
Unilabs Slovensko 49
Túžba niekam patriť, byť prijatý, hrá v živote mladých ľudí dominantnú úlohu.
Dnešní tínedžeri sa neboja trestu, ani zákazov, ale toho, že im dospelý, resp. rodič povie: Sklamal si ma. Zlyhal si.
To už nie sú celkom malé deti, ktoré by si neuvedomovali dôsledky svojho konania. Kde sa stala chyba?
Online výzvy na sociálnych sieťach sa v posledných rokoch stali bežnou súčasťou relatívne veľkej skupiny mladých ľudí. Ak by sme sa na zapájanie do online výziev pozreli z vývinového hľadiska, do istej miery by sme takéto správanie mohli považovať za relatívne normálne. Okrem toho, že sa mladí ľudia v období dospievania odpútavajú od rodičov, častejšie zneisťujú autoritu dospelých, konfrontujú ich pravidlá a zároveň sa pri hľadaní nových hodnôt a noriem často uchyľujú k nekritickému prijímaniu iných názorov. K zapájaniu sa do online výziev napomáha aj presvedčenie o jedinečnosti zážitkov a prežívania, a teda pocit, že ich nikto nemôže pochopiť, nikto nemôže zažiť to, čo oni, a teda aj to, že negatívne následky či riziká, ktoré sa stali ostatným, sa ich netýkajú – lebo im sa to nemôže stať.
Správajú sa mladí ľudia viac rizikovo?

Pre obdobie dospievania je typická aj istá miera rizikového správania, egocentrizmus a pocit jedinečnosti, ktorými sa vytvára vlastná identita. Veľmi jednoducho povedané, mozog ešte nie je úplne pri-
pravený a túžby sú dominantnejšie. Ak sa dospievajúci zapoja do online výzvy, v ktorej si v toalete „splachujú“ hlavu, nemyslia na to, že tento post zanecháva nejakú digitálnu stopu, ktorá sa nezmaže a ak by o pár rokov chceli kandidovať na prezidenta alebo prezidentku, je možné, že toto video sa objaví v médiách. Riešia len to, akú reakciu dostanú od svojich rovesníkov a svojho publika.
Kedy by mali rodičia začať hovoriť so svojimi deťmi o nástrahách internetu?
Deti a mladí ľudia nepoznajú iný svet ako s technológiami. Tak ako
s malými deťmi vstupujeme do offline sveta, ukazujeme im, na čo si majú dávať pozor, mal by byť súčasťou našej výchovy aj spoločný vstup dospelého a dieťaťa do online sveta, spoznávanie spôsobov ako sa chrániť, aké sú riziká a najmä to, kde a na koho sa obrátiť, keď sa v online prostredí deje niečo znepokojujúce. Dieťa do desiatich rokov prijíma svet tak, ako mu ho rodič podáva, dospelý je pre neho zdrojom dôveryhodných informácií a bezpečia. Do online sveta by mal rodič vstupovať so svojím dieťaťom – hovoriť mu o tom, kde sa nastavuje bezpečie a prečo sa to robí…
AKTUÁLNE
50 inVitro
Na stránkach občianskeho združenia IPčko nájdu deti, mladí ľudia, rodičia či učitelia aj takéto názorné pomôcky, ako čeliť nebezpečným online výzvam.
Je riešením blokovanie obsahu, ktorý sa rodičom nepozdáva? Majú zmysel rodičovské zámky?
Do desiateho roku života určite. Nie však za chrbtom dieťaťa. Mali by sme mu naše konanie vysvetliť, opísať, prečo to robíme a ubezpečiť ho, že ak by sa mu niečo v online priestore stalo, sme tu pre neho. V tínedžerskom období to už nemá zmysel, lebo mladí ľudia tieto zámky ľahko obídu. V tomto veku by mal byť pohyb detí v online priestore založený na dôvere a nie na kontrole. Už potrebujú aj svet bez dospelých, ale zároveň mať istotu, že ak by sa niečo stalo, môžu prísť za rodičom, ktorý im pomôže.
Čo trápi dnešné deti najviac? S čím sa na vás obracajú najčastejšia?
Je to najmä pocit osamelosti a strachu. Zdôraznila by som slovo strach, ktorý sa u mladých ľudí vystupňoval po období pandémie, vojny, ekonomickej krízy a tragickej udalosti na Zámockej ulici v Bratislave. Po tomto období sme zaznamenali 83-percentný nárast žiadostí o pomoc zo strany mladých ľudí. Skutočne prežívali existenciálny strach o seba, o kamarátov, ktorých majú v queer komunite. Druhým často skloňovaným slovom v rozhovoroch bol hnev. Hnevali sa na nás dospelých, mali pocit, že v takej závažnej veci musia kompe-
tentní niečo urobiť. Mali pocit, že dospelí sa na nich vykašľali, že okrem statusov na Facebooku neurobili nič pre to, aby sa zvýšila ich bezpečnosť a niečo sa zmenilo. Počas pandémie vzrástlo tiež sebapoškodzovanie.
Je prežívanie puberty náročnejšie než kedysi? Aký je rozdiel medzi súčasnými deťmi a deťmi spred desiatich rokov?
Dnešní tínedžeri žijú v dobe veľmi orientovanej na výkony. Musia podávať výkony na každom kroku – byť dobré deti svojich rodičov, dobre prospievať v škole, excelovať v partnerských aj v rovesníckych vzťahoch. Kedysi sa

Ak chceme dieťa ochrániť, vstúpme do jeho online sveta
Unilabs Slovensko 51
Nedávame žiadne univerzálne rady, pretože nefungujú.
Nebezpečné výzvy na Slovensku
● Výzvy neobchádzajú ani slovenské deti. Koncom marca minulého roka hospitalizovali v Národnom ústave detských chorôb v Bratislave niekoľko detí s otravou paracetamolom. Liek Paralen, ktorý túto látku obsahuje, jedli v nadmerných množstvách dobrovoľne ako súčasť takzvanej paralenovej výzvy – užiť čo najviac tabletiek či liečiva, nakrúcať svoje symptómy a zverejniť video na internete.
● Po niekoľkých minuloročných výzvach sa začiatkom tohto roka objavil nový trend medzi našimi tínedžermi a tínedžerkami – „vystreliť si“ zo záchranky alebo sa nechať zavrieť na psychiatrii. Odborníci pred týmito výzvami varujú – lôžok na psychiatrických oddeleniach, vrátane detských, je totiž akútny nedostatok.
● Na železničnej stanici v Devínskej Novej Vsi sa v júni 2021 fotili štyri 13-ročné dievčatá. Záber robili z koľajníc spred idúcej lokomotívy na podnet neznámeho človeka z Instagramu. Dve dievčatá odskočili pred lokomotívou na perón a vyviazli živé. Ďalšie dve však skočili na druhú stranu, priamo pod koľajnice, na ktoré prichádzal druhý vlak a na mieste zomreli.
● Na urgentnom príjme Detskej fakultnej nemocnice Kramáre v máji 2015 ošetrili deväť detí vo veku od šesť do dvanásť rokov, ktoré skombinovali drogy s alkoholom. Dievčatá aj chlapci od 6 do 12 rokov sa lekárom v nemocnici priznali, že na sociálnych sieťach kolujú výzvy, podľa ktorých skombinovali rôzne návykové látky.
Mladí ľudia Facebook nepoužívajú, lebo na tejto sociálnej sieti je veľa dospelých a komunikuje sa tam jazykom, ktorý im nič nehovorí.
mohli deti posťažovať rovesníkom, ale to už neplatí. Tlak na výkon je aj v rovesníckych vzťahoch. Naučili sa dávať si na tvár masky a hrať roly, napĺňať očakávania. Majú totiž pocit, že aj ich hodnotu okolie vníma cez výkon. Keď sa na to pozrieme pohľadom desaťročnej existencie našej organizácie IPčko, tak pri našom vzniku nám mladí ľudia hovorili: Ach, toto som pokazil, dostanem trest, zaracha. A pred svojimi kamarátmi sa na nič nehrali, mohli byť sami sebou.
Dnešné deti to vnímajú inak?
V kontexte trestu, o ktorom sme hovorili, je to dnešným tínedžerom jedno. Neboja sa trestu, ani zákazov, ale toho, že im dospelý, respektíve rodič povie: Sklamal si ma. Zlyhal si. Nesplnil si moje očakávania. Cítia sa osamelo, aj napriek tomu, že sú obklopení ľuďmi. Práve preto, že musia neustále niečo dokazovať a podávať výkon. Ak v tom ostávajú sami, prichádzajú ťažkosti, ktoré riešia podľa svojich možností. Ak pozornosť nedostanú doma, hľadajú ju v online priestore. Tu ju dostávajú intenzívne a vo veľkom počte a túžia tento zážitok opakovať.
Ako sa pod zmenu v psychike mladých ľudí podpísala izolácia počas pandémie?
Tínedžeri zvládali pandémiu najťažšie. Na rozdiel od dospelých nepo-
AKTUÁLNE
52 inVitro
znali mechanizmy, ako sa o seba postarať. Izoláciu podstúpili v čase, keď sa mali „odtŕhať“ od dospelých, žiť vo svete rovesníkov, ktorí sú v tejto vývinovej etape pre nich najdôležitejší. V tomto veku sa majú spoznávať, formovať, hľadať a tvoriť svoju identitu. To všetko sa umelo zastavilo a oni ostali uväznení doma.
Mladí ľudia prišli o mnoho možností a zdrojov, ktoré im pomáhali zvládať náročné situácie. Pred pandémiou mohli pred niektorými ťažkosťami „uniknúť“ do školy, stretávali sa s kamarátmi, chodili von, do kina, ku psychológom aj psychiatrom, venovali sa aktivitám, ktoré mali radi. Takmer o všetko prišli a na dlhé obdobie zostali doma so svojimi bolesťami.
Prišli o mnoho zvládacích mechanizmov a zdrojov, mnohé zdroje prestali fungovať a nové sa nemali kde vytvárať. Veľakrát nám hovorili o tom, že sebapoškodzovaním prekričali vnútornú bolesť, lebo nevedeli ako inak.
Počas minulého roka sa odborníci z IPčka rozhodli zrealizovať online prieskum „Online výzvy“ medzi mladými ľuďmi. S akým cieľom?
Naším cieľom bolo získať čo najviac informácií o tomto fenoméne, poznať názory, postoje, motiváciu do zapojenia sa a vyzývania, ako aj informácie o možnostiach pomoci, ktoré mladí ľudia využívajú, keď sa ocitajú v rôznych situáciách v súvislosti s online výzvami a online prostredím. Anonymný prieskum „Online výzvy“ sme zrealizovali na slovenských školách a získali vzorku 2 770 respondentov s priemerným vekom 14,3 rokov, ktorý je z pohľadu vývinovej psychológie veľmi citlivým a zraniteľným obdobím.
Aké sú výsledky prieskumu?
Z mladých ľudí, ktorí sa dostali do priameho kontaktu s online výzvou, sa až 71,5 % do výzvy aj zapojilo. Až 36,6 % mladých ľudí
nemá nikoho dospelého, s ktorým by mohli hovoriť o rizikách online výziev. Takmer 30 % opýtaných sa nemôže s rodičmi otvorene rozprávať o týchto rizikách a až 37 % sa nemôže rozprávať o tejto téme s učiteľmi. Ak by sa mladí ľudia ocitli v nebezpečenstve počas online výzvy, viac ako 53 % považuje za zdroj bezpečia rodičov alebo rodinu, 44 % by sa obrátilo na kamarátov a len 27 % by využilo učiteľov alebo školských psychológov. A nakoniec, 25 % mladých ľudí vôbec nezvažuje riziká, ktoré by mohla online výzva priniesť.
Ako vám pomôžu tieto štatistiky? Využijete ich vo svojej ďalšej práci? Pripravujeme sériu školení pre rodičov a odborníkov s názvom Diagnóza Digi. Spoznajú svet technológií a online fenoménov, ktoré v živote ich detí fungujú. Pre slovenské školy pripravujeme kampaň o tom, ako sa ochrániť, keď sa niečo v online prostredí stane. Budeme robiť rôzne diskusie, máme projekt Online terénna práca. Vytvorili sme tím, ktorý denne mapuje sociálne siete, streamovacie platformy či uzatvorené skupiny a snaží sa zachytiť trendy a mladých ľudí, ktorí potrebujú pomoc. V týchto prostrediach sa totiž môže objaviť téma, ktorá momentálne mladých ľudí zaujíma.
Vďaka tomu zareagujete včas, o krok vopred?
Pozrieme sa, ako na danú tému reaguje Google a keď odpoveď nie je dostatočná alebo dokonca nesprávna, vytvoríme ju my – článok, video, blog alebo podcast. Ponúkneme informácie, ktoré sú užitočné a prinášajú pomoc. Pri často skloňovanej téme sebapoškodzovania sme napríklad vytvorili preventívny a intervenčný projekt Krabička bezpečia, ktorá mladým ľuďom ponúka ďalšie možnosti, ako zvládnuť bolesť bez toho, aby si ublížili.
Ak chceme dieťa ochrániť,
do jeho online sveta
vstúpme
Unilabs Slovensko 53
Kedysi sa mohli deti posťažovať rovesníkom, ale to už neplatí. Tlak na výkon je aj v rovesníckych vzťahoch.
Dnešné deti trápi najviac pocit osamelosti a strachu, potom hnev a počas pandémie vzrástlo aj sebapoškodzovanie.
Na to, aby sme poznali svoje dieťa, by sme sa mali aktívne zaujímať aj o to, čo robí v tom virtuálnom svete? Mali by sme do neho vstúpiť? Mnohí rodičia nerozumejú tomu, prečo ich dieťa sleduje influencerov. Pýtajú sa, čo z toho má, keď pozerá na niekoho, ako hrá hry, pričom ono samo tie hry nehrá. Pre deti sú to idoly rovnako ako pre nás boli herci, speváci či športovci. Požiadajte dieťa, aby vám pustilo nejaké vlogy, streamy alebo príspevky svojho obľúbeného influencera či influencerky. Takto vstúpite do jeho sveta a hoci si o tom celom môžete myslieť svoje, zahryznite si do jazyka a to, čo vidíte, neodsudzujte, ani nekomentujte, skôr sa opýtajte, prečo je práve tento influencer obľúbený, čo sa im páči na ich tvorbe a podobne. Dajte najavo skutočný záujem. Prípadne si spolu zahrajte hry a vytvorte si spoločné

zážitky. Deti sa pri hraní hier totiž rozprávajú o celkom inom – preberajú vzťahy, rodiny, známky…
Takto môžeme aj my prostredníctvom technológií vstúpiť do sveta našich detí. Len vďaka tomu môžeme vidieť a poznať ich názory na mnohé témy a vnímať aj prípadné medzery, ktoré môžeme spoločne vypĺňať. Ak to všetko vzniká v dialógu, ak sa mladí ľudia cítia rešpektovaní, budú oveľa otvorenejší iným názorom.
Na ktorých sociálnych sieťach kolujú najčastejšie online výzvy?
Je to Instagram, TikTok, Snapchat a YouTube. Platformy, kde sa komunikuje krátkymi videami, nie dlhými statusmi. Mladí ľudia Facebook nepoužívajú, pretože na tejto sociálnej sieti je veľa dospelých a komunikuje sa tam jazykom, ktorý im nič nehovorí, ale majú tam vytvorené profily.
AKTUÁLNE
54 inVitro
Najviac ohrození sú 11- až 14-roční a potom je to tiež veková kategória 15 – 18 rokov.
Ako s nebezpečným obsahom nakladajú samotné platformy?
Európsky parlament schválil začiatkom júla 2022 Zákon o digitálnych službách (DSA), prvý rozsiahly súbor pravidiel pre online platformy, ktorý by mal zabezpečiť bezpečnejší online priestor. Nové pravidlá zahŕňajú opatrenia na boj proti nelegálnemu online obsahu a povinnosť pre platformy promptne reagovať. Určite by sme potrebovali zefektívniť nástroje na ochranu detí a mladých ľudí v online priestore.
Pre rodičov ste napísali aj príručku Bez nástrah online – sprievodcu bezpečným internetom. Čo v nej rodičia nájdu? A čo v nej hľadať nemajú?
V knihe popisujeme sociálne siete a ich špecifiká, fenomén internetu, sociálne médiá, prepojenie na duševné zdravie. Sú tam návody ako otvárať témy rozhovorov s deťmi na tému online priestoru.
Rodičia v príručke určite nenájdu to, že jediná cesta, ako ochrániť dieťa pred nástrahami internetu je vytrhnúť ho z tohto sveta alebo odpojiť internet. Vytrhnúť dieťa z online sveta, ktoré je pre neho prirodzeným, nie je riešením. Naopak, vieme mu tým veľmi ublížiť. Ak do online sveta vstupujeme spolu, učíme dieťa postupne spoznávať jeho možnosti a riziká, informácie dokáže absorbovať. Ak mu však internet zakážeme, aj tak si nájde cestu. S tým rizikom, že sa v ňom stratí a pri nebezpečných situáciách nebude vedieť, ako si pomôcť, lebo sme sa s ním o tom nikdy nerozprávali.
Rodičia chcú počuť konkrétne tipy, nie vetu: Rozprávajte sa! Aké otázky má v rozhovoroch klásť rodič?
Bola by som veľmi rada, keby sa rodičia stali partnermi svojich detí. Moja skúsenosť je však opačná – názor dieťaťa nebýva vypočutý. A hoci prichádzajú snahy o rozhovor, aj na tému online výziev, často sa
z neho stáva direktívny monológ rodiča: Toto keď urobíš, tak si ma neželaj! Všetko sa točí okolo toho, čo dieťa nemá robiť a čo bude nasledovať, keď to urobí. Skúsme v rozhovoroch viac komunikovať o našich pocitoch a o možnostiach, ako takéto situácie riešiť. Povedať dieťaťu, že ho máme radi, že nás zaujíma, čo si o tom myslí, že sme tam pre neho a nemusí sa báť prísť aj vtedy, keď urobí chybu. To je pre dieťa veľmi oslobodzujúce a prehlbuje to dôverný vzťah. Je tiež dobré používať otvorené otázky, na ktoré nedostanete iba odpoveď áno alebo nie.
Ako by to teda malo vyzerať?
Rodič by napríklad mohol povedať svojmu dieťaťu, že počul o paracetamolovej výzve a že ho to vystrašilo, pretože sa to týka presne detí v jeho veku. Mohol by sa opýtať, čo si jeho syn alebo dcéra o tom myslí. Čo o tom vedia, ako by sa zachovali, keby ich niekto vyzval. Prípadne, či už ich niekto vyzval a ako sa zachovali. Len vtedy rodič zistí, ako jeho dieťa uvažuje a odkiaľ má zdroje svojich myšlienok. V takejto diskusii dieťa oveľa prirodzenejšie prijme názor a skúsenosť rodiča. Zároveň si tiež rozvíja svoje kritické myslenie.
S dieťaťom sme sa porozprávali, spolu sme vstúpili do online sveta, no napriek tomu splnilo nebezpečnú alebo nedôstojnú výzvu. Ako máme zareagovať?
To, že sa rozprávame s dieťaťom, že nám nie sú žiadne témy tabu, je výborné. Nemali by sme však podľahnúť ilúzii, že nášmu dieťaťu sa také niečo nikdy nestane. Nie je to chyba, ani zlyhanie rodiča. V tej chvíli je dôležité, že vaše dieťa vie, že sa s vami o tom dá rozprávať, že môže za vami prísť, podržíte ho a neodsúdite.
71,5 %
Z mladých ľudí, ktorí sú vyzývaní do online výziev, sa 71,5 % do online výziev zapája.
Najčastejšie využívané sociálne siete mladými ľuďmi sú Instagram (66,3 %), TikTok (57 %), Snapchat (40,9 %) a YouTube (55,1 %).
36,6 %
Z mladých ľudí, ktorí sa zapájajú do online výziev, nemá 36,6 % nikoho dospelého, s kým by mohlo hovoriť o rizikách online výziev, 29,9 % sa nemôže otvorene rozprávať o rizikách online výziev s rodičmi a 37 % s učiteľmi.
53,3 %
Ak by sa mladí ocitli v nebezpečí počas online výzvy, 53,3 % sa môže spoľahnúť na rodičov/rodinu, 43,4 % na kamarátov a 27,2 % na učiteľov/školských psychológov.
25,2 %
25,2 % mladých ľudí, ktorí sa zapájajú do online výziev, nezvažuje riziká predtým, než sa do online výzvy zapojí.
Ak chceme dieťa ochrániť, vstúpme do jeho online sveta
Unilabs Slovensko 55
Bez nástrah online Sprievodca bezpečným internetom pre rodičov

Príručka Bez nástrah online ponúka rodičom, učiteľom, vychovávateľom a všetkým, ktorí pracujú s deťmi a mladými ľuďmi, pomoc a sprevádzanie prostredím internetu s cieľom naplno využívať jeho potenciál a nástroje na predchádzanie rizikám. Podporuje a povzbudzuje rodičov k tomu, aby sa pre nich a ich deti stal internet bezpečným miestom plným zábavných, zmysluplných objavov či priestorom, v ktorom nájdu inšpiráciu, ľudí so spoločnými záujmami aj aktivity, ktoré ich nadchnú i v offline svete. So správnymi nástrojmi a nastaveniami môže byť aj tento svet skutočne bez nástrah.

PaedDr. Zuzana Juráneková, MBA

Supervízorka projektu Online terénna práca v občianskom združení IPčko. Špeciálna pedagogička a koordinátorka poradne dobralinka.sk, zodpovedná za vzdelávanie, poradenstvo, PR a fundraising Dobrej linky. Je držiteľkou ocenenia Dobrovoľníčka Slovenska za rok 2019.
Marek Madro
Je zakladateľom a dušou projektu Internetovej poradne pre mladých IPčko.sk. Je psychológ, zodpovedá za profesionalitu a odbornú pomoc klientom združenia. Stojí za viacerými projektami, ktoré sa snažia pomôcť deťom a mladým ľuďom v zložitých životných situáciách.
IPčko.sk Internetová poradňa pre mladých ľudí
Adresa: Na vŕšku 6, 811 01 Bratislava Bezplatná nonstop krízová linka pomoci: 0800 500 333
Kontakt do kancelárie:
+421 949 760 570
Email: ipcko@ipcko.sk

Projekty:
• krizovalinkapomoci.sk
• dobralinka.sk
• chcemsazabit.sk
• stalosato.sk
• beznastrah.online
AKTUÁLNE
Autormi sprievodcu bezpečným internetom pre rodičov s názvom Bez nástrah online sú Marek Madro a Zuzana Juráneková z IPčka.
56 inVitro
Ako nezomrieť v spánku
Elena Akácsová publicistka
Predstava pokojnej smrti v spánku bez predošlých komplikácií, trápenia a nemocničných štrapácií je krásna. Ideálna. Ale nie vtedy, keď sa udeje nečakane, nevysvetliteľne a u príliš mladého človeka.
Koncom 70. rokov začalo v Amerike zomierať v spánku zarážajúce množstvo hmongských prisťahovalcov z Laosu vo veľmi mladom veku, v priemere mali 33 rokov. Zalapali po dychu a kým stihla prísť pomoc, bolo po nich. Pitvy nič neodhalili. Epidemiológovia to nazvali „syndrómom náhleho neočakávaného nočného úmrtia“. Syndróm zabil viac Hmongov ako päť hlavných príčin smrti dohromady.
Až antropologička Shelley Adler (autorka knihy Sleep Paralysis: Night-mares, Nocebos, and the Mind-Body Connection) prišla s teóriou, ktorá to vysvetľovala. Dala si dohromady dve veci – folklór a spánkovú paralýzu. Počas spánku v najhlbšej fáze naše telo vypne všetky svaly ovládané vedomím (okrem očných) a pri zobudení ich zas zapne. Ale istá časť ľudí sa občas zobudí skôr, ako sa svaly „zapnú“ a zažije nepríjemný stav – spánkovú paralýzu. Sú už pri vedomí, ale nemôžu sa hýbať. Antropologička súčasne vedela, že v hmongskej kultúre sa verilo na nočného ducha menom „dab tsog“, ktorý dokáže obete v noci znehybnieť a zadusiť ich. Hmongskí šamani doma v Laose proti nemu praktikovali magické rituály a vedeli démona zahnať. Ale v USA bolo šamanov veľmi málo. A väčšina Hmongov nemala príležitosť praktikovať v zahra-

ničí svoje náboženstvo. Keď však na nich prišla nočná mora, spomenuli si na ducha, prepadli panike a dostali infarkt. A ako sa šírili správy o spánkových úmrtiach v ich komunite, zomieralo stále viac mužov.
Západná medicína bola na iracionálny strach krátka, a tak povolala do služby hmongských šamanov. Keď muži prišli k lekárovi, okrem bežného vyšetrenia dostali aj trochu magických úkonov. Jeden šaman napríklad umiestnil nad dvere na obranu pred démonmi meč. Muži verili, že teraz sú chránení. Keby démoni prišli, mohli ich odraziť. Úmrtí prestalo pribúdať. Len preto, že sa zmenili ich očakávania.
Naše očakávania môžu dramaticky a v niektorých prípadoch až bolestne a smrteľne ovplyvniť náš život. Ak toto vieme, môžeme to využiť vo svoj prospech.
Môžeme si myslieť, že Hmongovia boli hlúpi a spiatočnícki, ale viera je mocná čarodejka aj v západnom svete. Napokon podobného démona, čo v noci dusí ľudí, prípadne im inak robí zle, nájdeme vo folklóre takmer všade na svete, len jeho mená a podoby sa menia. A schopnosť ľudí uveriť, že im niečo škodí tak veľmi, až im to ublíži aj skutočne, nie je ani v civilizovaných krajinách záležitosťou len zaostalých a nevzdelaných ľudí.
Naopak, môže sa to stať aj ľuďom, čo priveľa čítajú. Napríklad také negatívne účinky statínov, o ktorých sa pred časom veľa písalo v anglicky hovoriacich krajinách. Len tam sa potom objavili po požití liekov silné bo-
lesti svalov až u 10 – 12 % pacientov. V Japonsku a vo Švédsku sa vedľajšie účinky prejavovali len u 2 % pacientov, čo je normálna miera výskytu v kontrolných skupinách užívajúcich placebo. V USA a Spojenom kráľovstve negatívnym účinkom verili, a tak sa aj prejavili.
Naše očakávania môžu dramaticky, a ako naznačujú prípady vyššie, až bolestne a smrteľne ovplyvniť náš život. Ak toto vieme, môžeme to využiť vo svoj prospech. V knihe The Expectation
Effect: How Your Mindset Can Change Your World autor David Robson píše, že ak napríklad budeme veriť, že máme pevnú vôľu, dokážeme veľa. Ak si myslíme, že naša pevná vôľa na dosiahnutie našich cieľov nestačí, bude to tak, ako si myslíme. A tak je to i so šťastím, chudnutím či starnutím.
David Robson tvrdí, že ľudia s pozitívnejším prístupom k seniorskému veku majú menšiu pravdepodobnosť, že sa u nich rozvinie strata sluchu, osteoporóza a ďalšie choroby, dokonca aj Alzheimerova choroba než u ľudí, ktorí si starnutie spájajú so senilitou a rôznymi postihnutiami. Cituje aj štúdiu profesorky Beccy Levy z Yale, ktorá zistila, že ľudia s pozitívnym vnímaním starnutia žili o 7,5 roka dlhšie ako tí s negatívnym vnímaním.
Veru, žiadna mágia. Iba vlastné očakávania. Treba teda už len silno veriť v pokojnú nečakanú smrť v spánku, v zdraví a v čo možno najvyššom veku. A pre istotu mať nad dverami nejaký šamanský meč. Môže byť aj valaška. Podkova. Kríž. Veď každý vie najlepšie, čo mu funguje.
KOMENTÁR
Unilabs Slovensko 57






Náhle úmrtia
Akútne respiračné zlyhanie
Trombocyt pod drobnohľadom špecialistu
Akútne brucho ako príčina smrti pri náhlych úmrtiach
TÉMA ČÍSLA 94
82
60
Akútne respiračné zlyhanie









zlyhanie

TÉMA ČÍSLA 60 inVitro
MUDr. Ivana Gondová, PhD. Pediater, pediatrický pneumológ a izeológ II. Detská klinika SZU, pneumologická ambulancia, Banská Bystrica
Medzi najčastejšie urgentné stavy v detskom veku patrí rozvoj akútnej respiračnej insuficiencie (ARI). Znamená to, že telo ako také nie je schopné udržať adekvátnu výmenu dýchacích plynov na úrovni nevyhnutnej pre organizmus. Vyvolávajúca príčina, ako aj stav pacienta následne rozhodujú o ďalšom vývoji. Nezriedka vedie k liečbe oxygenoterapiou alebo vysokotlakovou neinvazívnou ventiláciou. Pri progresii treba zabezpečiť dýchanie pomocou umelej pľúcnej ventilácie. ARI patrí medzi stavy, ktoré môžu viesť ku kardiopulmonálnej resuscitácii a k náhlemu úmrtiu v detskom veku.
Úvod
Príčiny úmrtia v detskom veku sú rôznorodé, avšak popredné priečky patria úrazom, malígnym ochoreniam, srdcovým ochoreniam, kongenitálnym malformáciám, infekčným ochoreniam a perinatálnym komplikáciám. Svoje miesto v tomto rebríčku má aj akútna respiračná insuficiencia. Hoci presné štatistické údaje o incidencii nie sú v Slovenskej republike známe, vieme, že patria k najčastejším dôvodom príjmu na JIS, kde významne ovplyvňujú mortalitu pacientov. Akútne respiračné infekcie predstavujú 20 % príčin smrti u detí do 5 rokov života (1). Prevalencia ARDS (syndróm akútnej respiračnej tiesne) sa v Európe, USA a v Austrálii pohybuje od 2 – 12,8 prípadov/100 000 obyvateľov ročne = 0,02 – 0,13 ‰, v Južnej Amerike okolo 1 – 4 % (2). Definícia ARDS spočíva v poznaní, že je narušená výmena krvných plynov, keď organizmus nevie zabezpečiť dostatočný prívod kyslíka pre telo a vylučovanie nadbytočného oxidu uhličitého. Akútne respiračné zlyhanie môže byť podľa času vzniku rozdelené na akútne a chronické. Podľa prevládajúcej zložky na hypoxemické (parciálne) a hyperkapnické (globálne) (3).
Etiológia
Vo všeobecnosti by sa etiológia respiračného zlyhania dala rozdeliť do nasledujúcich kategórií:
1. Ochorenia postihujúce primárne respiračný trakt:
• obštrukcie HDC (aspirácia cudzieho telesa, epiglotitída, tonzilárna hypertrofia, stenóza DC, laryngomalácia, kraniofaciálne abnormality…)
• obštrukcia DDC (bronchiolitída, bronchopulmonálna dysplázia (BPD), status astmaticus)
• ochorenia pľúc (pneumónia, ARDS, edém pľúc)
2. Ochorenia spôsobujúce zhoršenie ventilácie:
• neuromuskulárne ochorenie, myasthenia gravis, Guillainov-Barrého syndróm (GBS)
• traumy a malformácie hrudnej steny, skolióza
• pleurálna efúzia a pneumothorax
3. Zlyhanie CNS a predĺženej miechy:
• status epilepticus, infekcie CNS, intoxikácie, traumy, apnoe z prematurity
4. Zlyhanie oxygenácie:
• hypovolémia, septický šok
• kardiálne zlyhanie
• metabolické ochorenia, intoxikácie
Dôvody, ktoré vedú k tomu, že detskí pacienti častejšie podliehajú respiračnému zlyhaniu než dospelí pacienti, sú: menšie anatomické pomery, nezrelosť riadiaceho centra pre dýchanie u nezrelých novorodencov, vyšší bazálny metabolizmus, inkompletné zväčšovanie počtu alveolov, horizontálne postavenie rebier a i. (3).
Náhle úmrtia Unilabs Slovensko 61
20 %
Akútne respiračné infekcie predstavujú 20 % príčin smrti u detí do 5 rokov života.
Klinický obraz
Pre lekára je pri vyšetrení pacienta najdôležitejšie zhodnotiť závažnosť respiračného zlyhania, na čo treba určitú klinickú skúsenosť. Medzi podstatné kroky v tomto procese patrí zhodnotenie vitálnych funkcií, celkového vzhľadu, auskultačné vyšetrenie pľúc a posúdenie mentálneho stavu, ktoré sa pri progresii dokáže rýchlo zhoršiť. Všetky uvedené postupy majú za cieľ vyhnúť sa zástave dýchania.
Medzi najčastejšie príznaky sprevádzajúce respiračné zlyhania patria:
• Dyspnoe: subjektívny pocit nedostatku vzduchu spojený so zvýšenou prácou dychových svalov. U detí ho voľným okom môžeme pozorovať ako alárne súhyby, vpadávanie jugula a zaťahovanie medzirebrových priestorov.
• Grunting: patrí medzi zvuky počuteľné voľným uchom (distenčne), vzniká zatvorením hlasovej štrbiny pri výdychu v snahe zabrániť kolapsu pľúc, a to zadržaním vzduchu v pľúcach a zvýšením reziduálnej funkčnej kapacity.
• Stridor: distenčný zvuk, ktorý vzniká prechodom vzduchu cez patologicky zúžený vzduchový stĺpec, pri obštrukcii v intratorakálnej oblasti rozlišujeme expiračný stridor, pri obštrukcii v extratorakálnych DC inspiračný stridor.
• Tachypnoe: zrýchlené dýchanie, menej často spomalené (bradypnoe).
• Tachykardia: zrýchlenie pulzovej frekvencie.
• Cyanóza: modrasté sfarbenie kože a slizníc spôsobené zvýšenou koncentráciou redukovaného hemoglobínu.
• Hypoxia: môže sa prejaviť ako telesný a duševný nepokoj, zmätenosť, agresivita, hypotenzia, tachykardia až bezvedomie.

• Hyperkapnia: bolesti hlavy, hypertenzia, potenia, spavosť, zmätenosť.

• Nešpecifické príznaky: slabé pitie, sťažené rozprávanie, slabosť, iritabilita, letargia.
• Ortopnoe, sni ng dog: namáhavé dýchanie.
Každý lekár by si mal dať pozor pri objavení sa tzv. varovných príznakov svedčiacich pre závažný stav dieťaťa (strach, nepokoj, dojem unaveného dieťaťa, viditeľné zaťahovanie svalov na hrudníku, zvyšujúca sa tachykardia a kývanie hlavou) (3).

TÉMA ČÍSLA 62 inVitro
Obrázok č. 1: Pneumothorax (Zdroj: archív autorky, 2023)
Diagnostika
Každé pediatrické vyšetrenie sa začína (ak to dovoľujú podmienky) zberom zdravotnej dokumentácie a anamnestických dát od rodiča alebo od samotného dieťaťa. V anamnéze sa zameriavame na prítomnosť premorbídnych ochorení, závažné pneumologické či neurologické ochorenia a epidemiologickú anamnézu. Nasleduje klinické vyšetrenie, ktoré by sa malo vykonávať rýchlo a zároveň dôsledne. Jeho súčasťou by malo byť aj zhodnotenie saturácie krvi kyslíkom, zmeranie arteriálneho tlaku, určenie pulzovej frekvencie, zhodnotenie kapilárneho návratu. Hlavným cieľom je určenie stavu závažnosti pacienta, ktoré vedie k hospitalizácii na štandardné alebo intenzívne detské oddelenie. Krvný obraz a markery zápalu pomáhajú rozlíšiť bakteriálny pôvod ťažkostí od vírusového. Mineralogram dáva informáciu o potrebe korekcie vnútorného
prostredia. Vyšetrenie parametrov acidobázickej rovnováhy priamo nadväzuje na druh liečby, ktorú u pacienta zvolíme (oxygenoterapia, NIV). Preferujeme odber arteriálnej krvi pred venóznou. Mikrobiologické odbery, ktoré zahŕňajú výtery z HCD, spúta, sérológiu (atypické agens), antigény z moču (pneumokok, legionella) či nazofaryngeálne stery (chrípka, Covid-19, RSV, adenovírus…), sú zamerané na určenie patogénu. V prípade podozrenia na intoxikáciu je nevyhnutný odber materiálu na toxikologický skríning.
Následne prechádzame k zobrazovacím vyšetreniam. Zlatým štandardom pri akútnom respiračnom zlyhaní je realizácia RTG hrudníka. Pomerne rýchlo a jednoducho môžeme získať diagnózu (pneumónia, edém, pneumothorax, tumor, iné…). Stále viac sa do popredia na

Náhle úmrtia Unilabs Slovensko 63
Obrázok č. 2: Zápal pľúc s abscesom (Zdroj: archív autorky, 2023)
oddeleniach JIS dostáva ultrasonografia pľúc, a to pre svoju neinvazívnosť, vyhnutie sa radiačnej záťaži a pre ľahkú realizáciu pri lôžku pacienta. Ak to stav pacienta dovoľuje, je vhodné CT pľúc na spresnenie patologického procesu v DC. Pri podozrení na aspiráciu cudzieho telesa pristupujeme k bronchoskopickému vyšetreniu v celkovej anestézii. Bronchoskopia môže byť zároveň nápomocná z terapeutického hľadiska pri odstraňovaní hlienových zátok pri atelektatických formách pneumónie. Dôležitým úkonom je aj realizácia bronchoalveolárnej laváže na odber mikrobiologických, cytologických a imunologických vyšetrení. Podľa vyvolávajúcej príčiny môžeme doplniť zobrazovacie vyšetrenie CNS, odber likvoru, neurologické vyšetrenie, USG brucha, chirurgické a traumatologické vyšetrenie, kardiologické vyšetrenie a iné (4).

Stanovanie diagnózy akútneho respiračného zlyhania je skladačkou zloženou zo všetkých uvedených vyšetrení, pričom najväčší dôraz prikladáme klinickému stavu, vyšetreniu krvných plynov a zobrazovacím vyšetreniam.















Na oddeleniach JIS sa do popredia dostáva ultrasonografia pľúc, a to pre svoju neinvazívnosť, vyhnutie sa radiačnej záťaži a ľahkú realizáciu pri lôžku pacienta.




TÉMA ČÍSLA 64 inVitro
Obrázok č. 3: Pravostranná atelektáza (Zdroj: archív autorky, 2023)
Diferenciálna diagnostika
V rámci diferenciálnej diagnostiky je nevyhnutné myslieť na stavy, ktoré sa prejavujú ťažkosťami s dýchaním, ale ich pôvod nemusí byť respiračný. Do tejto kategórie spadá napríklad neonatálna sepsa, kongenitálna diafragmatická hernia, kongenitálny centrálny hypoventilačný syndróm, Jeuneov syndróm a i. (5).
Záver
Ak lekár alebo iný zdravotnícky pracovník rozpozná diagnózu akútneho respiračného zlyhania, treba postupovať rýchlo a dôsledne, s cieľom stabilizovať klinický stav pacienta. Pri zlyhaní respirácie v teréne treba poznať zásady prvej pomoci. Každá sanitka má vybavenie, ktoré môže viesť k záchrane života (airway, ambuvak, odsávačka…).
So zlepšujúcimi sa možnosťami neinvazívnej ventilácie pri respiračnom zlyhaní u detí, ktorá sa v súvislosti s pandémiou Covid-19 stala dostupnejšou aj na štandardných pediatrických oddeleniach, sa liečba akútneho respiračného zlyhania čiastočne znížila o potrebu invazívnej ventilácie a s ňou spojenými komplikáciami.
Pre oddelenie intenzívnej starostlivosti je respiračné zlyhanie denným chlebíkom, keďže patrí k najčastejším pohotovostným stavom v detskom veku. Každopádne, liečba patrí do rúk erudovaných špecialistov so skúsenosťami v daných situáciách, čo následne zlepšuje šance pacienta na prežitie.
Prognóza ochorenia je rôznorodá a závisí od vyvolávajúcej príčiny a klinického stavu pacienta. U časti pacientov prechádza stav do chronického respiračného zlyhania vyžadujúceho zavedenie tracheostómie či dlhodobej domácej oxygenoterapie alebo ventilácie.
Nezastupiteľné miesto má aj rehabilitácia zameraná na obnovu respiračných funkcií pacienta, ale aj opätovnú mobilizáciu.
U časti pacientov prechádza stav do chronického respiračného zlyhania vyžadujúceho zavedenie tracheostómie či dlhodobej domácej oxygenoterapie alebo ventilácie.
Literatúra
1. Hammer J.: Acute respiratory failure in children, Pediatric Respiratory Rewiews, 2013, 64-69.
2. Bergmann P .J.: Acute respiratory failure in children- not just an acute problem, Critical care medicine, 2020.
3. Dobiáš V.: Akútna respiračná insuficiencia , Via practiva, 2007, roč. 4(2): 94 – 96.
4. Friedman M., Nitu. E. M.: Acute respiratory failure in children, Pediatric Annals, Vol 47, No.7, 2018.

5. Springer C. S.: Pediatric respiratory failure, Medscape, 2022.

Náhle úmrtia Unilabs Slovensko 65
Hemoragický šok



Hemoragický šok je závažnou komplikáciou sprevádzanou masívnym krvácaním. Vyvíja sa pomerne rýchlo a je spojený s vysokou mortalitou a morbiditou. Príznaky sa nemusia prejaviť okamžite. Na šok je dôležité myslieť pri úrazoch, poraneniach a stavoch vedúcich k dehydratácii a hypovolémii. Včasná diagnostika a adekvátna liečba môžu byť v mnohých prípadoch život zachraňujúce.



TÉMA ČÍSLA 66 inVitro
doc. MUDr. Mária Hulíková, PhD. Hematológ, transfuziológ Ambulancia hematológie a transfuziológie Centrum hemostázy a trombózy, Košice Unilabs Slovensko
Úvod
Hemoragický šok je závažný medicínsky problém aj v súčasnosti. Po kardiálnom a respiračnom zlyhaní, krvácaní a bezvedomí je šok piatym najčastejším stavom ohrozujúcim život. Podľa Národného traumatologického ústavu je hemoragický šok druhou najčastejšou príčinou smrti u ľudí s traumatickými zraneniami a v pôrodníctve dokonca na prvom mieste. Celosvetovo je úmrtnosť v dôsledku krvácania značná. Ročne príde o život v dôsledku krvácania a jeho následkov celosvetovo 1,9 milióna ľudí. Z toho 1,5 milióna hlavne mladých ľudí zomiera na fyzické traumy. (1) Aj keď sa v patofyziológii a diagnostike život ohrozujúceho krvácania dosiahli významné pokroky,
dosiahli úspech v liečbe je limitovaný. spôsobí
Hemoragický šok je klinický syndróm spôsobený náhlou stratou krvi, ku ktorej dochádza najčastejšie po úrazoch, poraneniach, počas operácie, pôrodu atď. a ktorá spôsobí obehové zlyhanie s neadekvátnou distribúciou kyslíka a perfúziou vo vzťahu k metabolickým požiadavkám tkanív vedúce ku generalizovanej hypoxii. Rovnováha medzi potrebou a dodáv-
kou kyslíka do tkanív je narušená.
Tabuľka č. 1: Definícia ťažkého krvácania, upravené podľa (1)
Závažné krvácanie
Život ohrozujúce krvácanie
sa zníži objem krvi v krvnom riečisku a krvná strata je taká rýchla a závažná, že bezprostredne ohrozuje život jedinca a bez insmrti.
je č.
Závažnosť
mu organizmu, rýchlosť a/alebo veľkosť krvnej straty, počet podaných jednotiek transfúznych
peň tkanivovej hypoperfúzie a/alebo poruchy orgánových funkcií. Autoregulačné mecha-
merané na udržanie zásobovania dôležitých (mozog, vyčerpajú
júcej krvi a Ak
Pri ťažkom, život ohrozujúcom krvácaní (ŽOK) sa zníži objem krvi v krvnom riečisku a krvná strata je taká rýchla a závažná, že bezprostredne ohrozuje život jedinca a bez intenzívnej liečby vedie k jeho smrti. Definícia ťažkého krvácania je uvedená v Tabuľke č. 1. Závažnosť krvácania determinuje viacero faktorov, napríklad primárna príčina/zdroj krvácania, aktuálny stav hemokoagulačného systému organizmu, rýchlosť a/alebo veľkosť krvnej straty, počet podaných jednotiek transfúznych prípravkov alebo krvných derivátov a tiež stupeň tkanivovej hypoperfúzie a/alebo poruchy orgánových funkcií. Autoregulačné mechanizmy reakcie organizmu na krvnú stratu, zamerané na udržanie zásobovania dôležitých orgánov kyslíkom (mozog, srdce…), sa pri masívnom krvácaní vyčerpajú a nepomer medzi kapacitou a náplňou krvného riečiska vyústi v hypoperfúziu tkanív alebo samotné krvácanie poškodí životne dôležitý orgán. Dodávka kyslíka tkanivám je obmedzená. Pri pokračujúcej strate krvi zlyhajú autoregulačné mechanizmy, prietok krvi je narušený a dochádza k šokovému stavu a poškodeniu tkanív. Ak sa cirkulácia krvi neobnoví, stav sa stáva
• symptomatické krvácanie do kritickej oblasti/orgánu, kompartment syndróm (intrakraniálne, intraspinálne, retroperitoneálne, intraartikulárne, perikrdiálne)
• pokles Hb o ≥ 20 g/l, vyžadujúce podanie
≥ 2 jednotiek plnej krvi/erytrocytov
symptomatické (intrakraniálne, intraartikulárne, pokles ≥
• veľkosť krvnej straty:
○ strata celého cirkulujúceho objemu za 24 hodín = cca 10 transfúznych jednotiek erytrocytov alebo
○ strata 50 % cirkulujúceho objemu krvi v priebehu 3 hodín alebo
veľkosť ○


○ strata 1,5 ml/kg/min. počas 20 a viac minút alebo
○ pokračujúce straty presahujúce objem 150 ml/min.
• strata vedúca k ohrozeniu základných životných funkcií (napríklad krvácanie do CNS)
• prítomnosť klinických/laboratórnych známok tkanivovej hypoperfúzie v priebehu krvácania
viac alebo strata do CNS) prítomnosť v
ŽOK
stavom a zlyhaním štandardných postupov zastavenia krvácania (chirurgická kontrola koncentrátov
Nezastaviteľné krvácanie • ŽOK s klinickými a laboratórnymi známkami hypoperfúzie, hypokoagulačným stavom a zlyhaním štandardných postupov zastavenia krvácania (chirurgická kontrola zastavenia krvácania, podanie erytrocytov, plazmy, fibrinogénu, koncentrátov trombocytov)
Hb – hemoglobín CNS – centrálny nervový systém ŽOK – život ohrozujúce krvácanie
CNS – centrálny nervový systém
Náhle úmrtia Unilabs Slovensko 67
nezvratným. Šokový stav to nie je len strata objemu a erytrocytov ako prenášačov kyslíka, ale súčasne dochádza k rôznym patofyziologickým zmenám. Najvýznamnejšie sú poruchy koagulácie. Koagulopatia sa vyvíja ako kombinácia niekoľkých procesov – strata koagulačných faktorov krvácaním, hemodilúcia infúznymi roztokmi a dysfunkcia koagulačnej kaskády ako sekundárna odozva na acidózu a hypotermiu. (2, 3)
Tabuľka č. 2 (4) uvádza zmeny v hemostáze navodené acidózou, hypotermiou a hypokalcémiou. Porucha zrážania krvi prehĺbi krvácanie, to vedie k vyčerpaniu koagulačných faktorov, k strate krvných doštičiek a krvácanie progreduje. V prípade významného tkanivového poškodenia vstupuje do hry poškodenie endotelu. Endotelová dysfunkcia vedie k aktivácii fibrinolýzy, zmene permeability cievnej výstelky a k antikoagulácii navodenej heparínom, alebo jemu podobnými látkami (degradáciou glykokalyxu), ktorý za normálnych okolností udržuje netrombotické vlastnosti endotelu. Pochody, ktoré prebiehajú pri masívnej hemorágii a ktoré vyústia v kogulopatiu
Podľa Národného traumatologického ústavu je hemoragický šok druhou najčastejšou príčinou smrti u ľudí s traumatickými zraneniami a v pôrodníctve dokonca na prvom mieste.
Tabuľka č. 2: Zmeny v hemostáze navodené acidózou, hypotermiou a hypokalcémiou, upravené podľa (4) Acidóza Hypotermia Hypokalcémia
tvorba trombínu inhibícia propagačnej fázy inhibícia iniciačnej fázy inhibícia pri Ca2+ ≤ 0,25 mmol/l
fibrinogén zvýšená degradácia znížená syntéza N/A
počet trombocytov znížený bez ovplyvnenia N/A
funkcia trombocytov znížená agregácia
≤ 31 °C: znížená agregácia
> 31 °C: zvýšená agregácia N/A
efekt normalizácie teploty porucha koagulácie pretrváva úprava koagulácie N/A
efekt podania rFVIIa účinnosť je znížená účinnosť nie je znížená N/A
efekt podania PCC N/A N/A N/A
efekt kyseliny tranexámovej účinnosť nie je ovplyvnená účinnosť nie je ovplyvnená N/A
N/A – údaje nie sú dostupné
rFVII – rekombinantný aktivovaný faktor VII
PCC – koncentráty protrombínového komplexu
TÉMA ČÍSLA 68 inVitro
hypoperfúzia/šok
masívna krvná strata
poškodenie tkaniva
acidóza
hypotermia
hypokalcémia
znížená koncentrácia fibrinogénu
inhibícia generácie trombínu
dysfunkcia trombocytov
koagulopatia pri masívnom krvácaní
zahŕňajú okrem hypoperfúzie a tkanivového poškodenia aj iatrogénne faktory (masívne krvné náhrady). To vedie k acidóze, hypotermii a k hypokalcémii, následne k zníženej koncentrácii fibrinogénu, k inhibícii tvorby trombínu, k dysfunkcii trombocytov (Schéma č. 1).
(4, 5, 6, 7)
Etiológia
Príčiny masívneho krvácania a hemoragického šoku sú rôznorodé. Pri hemoragickom šoku strata krvi presahuje schopnosť tela kompenzovať a zabezpečiť adekvátnu perfúziu a okysličenie tkaniva. Toto je spôsobené vonkajším a vnútorným krvácaním pri traume po úrazoch, po tupých a prenikajúcich poraneniach, ale môže byť spôsobené aj perioperačným krvácaním, krvácaním spojeným
s tehotenstvom (mimomaternicové tehotenstvo, placenta praevia, abrupcia placenty, popôrodné krvácanie) alebo spontánnym krvácaním z tráviaceho traktu (prasknutý vred žalúdka, dvanástnika, ezofageálne varixy, intestinálne krvácanie). Masívne krvácanie môže mať aj vaskulárne príčiny (ruptura aneuryzmy brušnej aorty, disekcia, AV malformácie), tiež iatrogénne príčiny (biopsia pečene, obličiek a pod.), potom je to následok chorobných príčin (komplexná porucha hemostázy), hepatopatie, urologického krvácania, antikoagulačnej a antitrombotickej liečby. Príčiny hemoragického šoku sú odlišné, ale patofyziologický mechanizmus a výsledný
kritický stav vykazujú spoločné rysy. Následky šoku sú rovnaké – zlyhanie funkcie buniek životne dôležitých orgánov. (7, 8, 9)
Náhle úmrtia Unilabs Slovensko 69
Schéma č. 1: Patofyziológia poruchy krvného zrážania pri masívnej hemorágii, upravené podľa (4)
latrogenné faktory masívne krvné náhrady
Klinický obraz – symptómy hemoragického šoku
Šok prebieha vo fázach:
1. Štádium kompenzovaného šoku. Alternatívny názov je kompenzovaná alebo ischemická fáza hypoxie. Charakterizuje ho aktivácia sympatikového nervového systému (tachykardia, tachypnoe, zvýšenie kontraktility myokardu a minútového objemu, kontrakcia veľkých kapacitných ciev). Systolický krvný tlak je normálny, diastolický tlak je zvýšený, pulz sa zvýši na 80 – 90 úderov/min., hladina hemoglobínu je > 90 g/l. Ďalšími príznakmi sú bledosť kože, studené akra, kapilárny návrat spomalený, stav vedomia je nezmenený, v niektorých prípadoch mierna úzkosť.
2. Štádium dekompenzovaného šoku. Toto štádium charakterizuje zníženie minútového objemu srdca následkom zníženia venózneho návratu, porušenie cievnych reflexov, presakovanie krvi a plazmy do okolitých tkanív, zvýšenie krvných strát, spomalenie prietoku, zhoršenie perfúzie, mikrotrombotizácia, paralýza cievneho systému, zastavenie mikrocirkulácie. V klinickom obraze sa pozoruje lividné sfarbenie koncových častí končatín, studený pot, zmeny vedomia, znížený až nemerateľný krvný tlak, oligúria, difúzne krvácanie z telesných otvorov. (10)
30 %
U väčšiny pacientov kompenzačné mechanizmy spôsobujú, že hypotenzia je necitlivý indikátor šoku až do straty 30 % z celkového objemu krvi.
Je ťažké identifikovať príznaky a symptómy hemoragického šoku, ak pochádza krvácanie z okultného zdroja. U väčšiny pacientov kompenzačné mechanizmy spôsobujú, že hypotenzia je necitlivý indikátor šoku až do straty 30 % z celkového objemu krvi. Prínosom pre diagnózu šoku sú známky tkanivovej hypoperfúzie: zmena stavu vedomia, tachypnoe, tachykardia, oslabenie periférneho pulzu, škvrnité, bledé, studené končatiny, pokles diurézy, pomalý kapilárny návrat. Je dôležité rozpoznanie stupňa straty krvi prostredníctvom vitálnych funkcií a abnormalít duševného stavu. Klasifikácia závažnosti hemoragického šoku sa opiera o množstvo straty krvi s očakávanými fyziologickými reakciami.
Hemoragický šok triedy I je strata objemu krvi až do 15 % z celkového objemu krvi. Srdcová frekvencia je minimálne zvýšená (100 úderov/min.) alebo normálna. Krvný tlak a pulzový tlak sú stabilné, ale môžu byť mierne zvýšené pri úzkosti. Dýchacia frekvencia je stabilná pri 14 – 20 dychov/min. Výdaj moču zostáva vyšší ako 30 ml/h. Často môže byť jediným klinickým príznakom mierna forma úzkosti.
Hemoragický šok triedy II zahŕňa stratu 15 – 30 % z celkového objemu krvi. Pacienti so strednou formou úzkosti majú zvýšenú srdcovú frekvenciu a frekvenciu dýchania (100 – 120 úderov/min. a 20 – 24 dychov/min.). Výdaj moču môže mierne klesnúť (20 – 30 ml/h). Pulzný tlak začína klesať, ale systolický krvný
TÉMA ČÍSLA 70 inVitro
tlak môže byť nezmenený alebo mierne znížený, čo môže byť príznakom, že organizmus nedokáže kompenzovať náhlu stratu krvi. Výdaj moču sa javí ako jediný najdôležitejší ukazovateľ na monitorovanie stavu tekutín u pacienta. Na začiatku šoku krvný tlak nie je spoľahlivý indikátor, pretože kompenzačné mechanizmy tela udržia krvný tlak zvyčajne v normálnych medziach, až kým strata krvi nedosiahne 30 % z celkového objemu krvi.
Hemoragický šok triedy III je strata objemu 30 – 40 % z celkového objemu krvi. Pacient má tachykardiu (120 – 140 úderov/ min), výrazný pokles krvného tlaku. Dychová frekvencia (30 – 40 dychov/min.) je výrazne zvýšená. Výdaj moču klesá (5 – 15 ml/h). Dopĺňanie kapilár je oneskorené. U pacienta dochádza k zmenám psychického stavu. Pacient má vážny úzkostný stav. Môže dôjsť aj k strate vedomia.
Hemoragický šok triedy IV je najzávažnejší. Pacienti sú letargickí, s ťažkou hypotenziou a tachykardiou s nehmatateľným alebo nitkovitým periférnym pulzom. Frekvencia dýchania je > 35 dychov/min. Výdaj moču je minimálny alebo chýba. Dopĺňanie kapilár je oneskorené. Uvedená charakteristika hemoragického šoku sa vzťahuje na 70 kg vážiaceho zdravého jedinca. Pri hodnotení pacientov sa musia brať do úvahy klinické faktory. Napríklad starší pacienti užívajúci betablokátory môžu meniť pacientovu fyziologickú odpoveď na znížený objem krvi inhibíciou mechanizmu na zvýšenie srdcovej frekvencie. Alebo pacienti s východiskovou hypertenziou môžu byť funkčne hypotenzní, so systolickým krvným tlakom 110 mmHg. (10, 11,12) Tabuľka č. 3 uvádza základné príznaky šoku podľa straty krvi. (10)
Všeobecné symptómy hemoragického šoku
Pri hemoragickom šoku dochádza k poklesu krvného tlaku, tepová frekvencia stúpa, tep je nitkovitý, pacient má stenokardie, arytmie, zrýchľuje sa frekvencia dýchania, prítomné je dyspnoe, pacient je bledý, nekľudný, oblieva ho studený pot, má studenú, vlhkú, mramorovú kožu, má oligúriu až anúriu, pozorované je zhoršenie stavu vedomia (apatia, excitácia, agresivita, somnolencia, sopor), spomalený kapilárny návrat, pacient má nauzea,
Prítomnosť normálnych laboratórnych
hodnôt krvného zrážania nevylučuje rozvoj život ohrozujúceho krvácania.
vracanie, pozorovaná je tvorba mikrotrombov v kapilárach s poruchou mikrocirkulácie. Najcitlivejším ukazovateľom šoku je kapilárny návrat, nie hypotenzia.
Diagnóza hemoragického šoku
Diagnóza hemoragického šoku je väčšinou založená na včasnom rozpoznaní šoku (založený najmä na nálezoch fyzikálneho vyšetrenia) a identifikácii zdroja závažnej straty krvi. V ideálnom prípade by k rozpoznaniu malo dôjsť pred rozvojom hypotenzie. Veľká pozornosť by sa mala venovať reakciám organizmu na nízky objem krvi a fyzikálnemu vyšetreniu, ktoré môže odhaliť príznaky šoku. Šok možno diagnostikovať na základe dôkazov o zmene perfúznych parametrov: stav vedomia, srdcová frekvencia, farba slizníc, čas naplnenia kapilár, teplota, kvalita pulzu. Počiatočnými príznakmi môžu byť tachykardia, tachypnoe a pokles tlaku. Hypotenzia je známkou dekompenzovaného šoku. Chladné končatiny a oneskorené naplnenie kapilár sú príznakmi periférnej vazokonstrikcie. Oligúria a/alebo porucha vedomia upozorňujú na zníženú perfúziu orgánov (obličky, mozog).
Zatiaľ čo silné vonkajšie krvácanie je okamžite rozpoznateľné, vnútorné krvácanie sa niekedy neodhalí, kým pacient nevykazuje príznaky hemoragického šoku. Ak príčina šoku nie je zrejmá alebo je krvácanie vnútorné,
Náhle úmrtia Unilabs Slovensko 71
Na posúdenie rozsahu krvácania závažnosti šoku sa odporúča priebežne sledovať hladinu laktátu a deficit báz v krvi.
na diagnostiku príčiny krvácania sú vhodným nástrojom zobrazovacie metódy a laboratórne testy: röntgenové vyšetrenie (rtg), ultrasonografia (USG), skenovanie pomocou počítačovej tomografie (CT), zobrazovanie magnetickou rezonanciou (MRI), krvné testy. Ultrazvuk sa používa na odhalenie intrakavitárneho zdroja krvácania (hrudník, brucho, panva), na identifickáciu okultných zdrojov krvácania, ako sú prasknutá aneuryzma brušnej aorty, mimomaternicové tehotenstvo, krvácanie z maternice, ktoré môžu zostať skryté ako krvácajúce ložiská, ďalej na detekciu intraperitoneálnej tekutiny, na hodnotenie hemoperitonea a hemoperikardu a pod. CT sa má okamžite vykonať u kritických pacientov, u ktorých po ustálení klinického obrazu nemožno identifikovať pôvod krvácania. CT je zlatým štandardom diagnostiky vnútrobrušných poranení. Fyzikálne vyšetrenia a rádiologické vyšetrenia môžu pomôcť lokalizovať zdroje krvácania, ale je dôležité si uvedomiť, že negatívny ultrazvuk nevylučuje napríklad intraabdominálnu patológiu. USG indikované pri intraperitoneálnom krvácaní neodhalí krvácanie do retroperitonea.
Laboratórne vyšetrenia nemusia ukázať akútny hemoragický šok. Hemoglobín (Hb) a hematokrit (HTK) môžu byť na začiatku rozvoja šoku v norme (redistribúcia intersticiálnej tekutiny do plazmy trvá 8 – 12 h). Často sú ovplyvnené objemovou resuscitáciou. Je dôležité hodnotiť nízku iniciálnu koncentráciu Hb ako
Stupeň % objemu Príznaky
1. 0 – 15 tachykardia minimálne zvýšená, zvyčajne nedochádza k žiadnej zmene krvného tlaku, pulzného tlaku alebo frekvencie dýchania, kapilárny návrat trvá > 3 s, ale často jediný klinický príznak je mierna forma úzkosti
2. 15 – 30 tachykardia > 100/min., zníženie tlakovej amplitúdy, tachypnoe, studená koža, úzkosť
3. 30 – 40 tachypnoe, tachykardia, zníženie TK, zmätenosť, oligúria
4. > 40 tachykardia, nemerateľný diastolický TK, depresia CNS, studená koža, anúria
TK – krvný tlak CNS – centrálny nervový systém

TÉMA ČÍSLA 72 inVitro
Tabuľka č. 3: Príznaky šoku podľa straty krvi, upravené podľa (10)
ukazovateľ ťažkého krvácania spojeného s koagulopatiou. Na posúdenie závažnosti a dynamiky krvácania treba opakovane kontrolovať hodnoty Hb.
Koagulácia je na začiatku krvácania zväčša v norme. Pri rozvoji šoku, ktorý je sprevádzaný acidózou, hypotermiou a hypokalciémiou, prebiehajú zmeny v hemostáze, vzniká koagulopatia. Odporúča sa rutinne a včas vykonávať opakované vyšetrenia hemokoagulačných parametrov PT (protrombínový test), aPTT (aktivovaný parciálny tromboplastínový test), koncentrácie fibrinogénu a počet trombocytov. Na identifikáciu koagulačnej poruchy sú odporúčané viskoelastometrické metódy, ak sú dostupné, sú to testy typu POCT.
Na zhodnotenie závažnosti krvácania a poruchy krvnej zrážanlivosti sa odporúča uprednostniť klinický stav pred výsledkami laboratórnych vyšetrení. Prítomnosť normálnych laboratórnych hodnôt krvného zrážania nevylučuje rozvoj ŽOK.
Biochemické parametre sú ovplyvnené objemovou resuscitáciou – hyperchloremická acidóza, transfúziou – hyperkaliémia, urea a kreatinín sú zväčša v norme. Na posúdenie rozsahu krvácania závažnosti šoku sa odporúča priebežne sledovať hladinu laktátu a deficit báz v krvi. Acidobáza je dobrým skorým markerom, ktorý pomôže odhadnúť závažnosť stavu a signalizuje potrebu intenzívnejšej resuscitácie. (13, 14)
Záver
Hemoragický šok spôsobený ťažkou stratou krvi vedie k nedostatočnému dodávaniu kyslíka na bunkovej úrovni. Ak krvácanie pokračuje nekontrolovane, rýchlo nasleduje smrť. Príznaky šoku sa nemusia prejaviť okamžite. Na šok treba myslieť pri úrazoch, poraneniach a stavoch vedúcich k dehydratácii a hypovolémii. Priemerný čas od nástupu šoku do smrti je 2 hodiny, preto je veľmi dôležité hemoragický šok včas rozpoznať a zabezpečiť rýchle, adekvátne opatrenia na zastavenie krvácania zachraňujúce život pacienta.
Literatúra
1. Törker FS. Hemorrhagic shock. In book: Clinical Management of Shock - The Science and Art of Physiological Restoration, 2020
2. Rossaint R, Bouillon B, Cerny V et al. The European guideline on management of major bleeding and coagulopathy following trauma.Critical care 2016; 20: 100. Dostupné z DOI: ˂http://dx.doi.org/10.1186/s13054-0161265-x>.
3. Kozek-Langenecker SA et al. Management of severe perioperative bleeding:guideline from the European Society of Anaesthesiology: First update 2016.Eur J Anaesthesiol 2017; 34(6): 332-395.
4. De Robertis E, Kozek-Langenecker SA, Tufano R et al. Coagulopathy induced by acidosis, hypothermia and hypocalceaemia in severe bleeding. Minerva Anestesiol 2015; 81(1): 65-75
5. Kornblith LZ, MooreHB, Cohen MJ. Trauma-induced coagulopathy: The
past,present, and future. J Thromb Haemost.2019 Jun; 17(6):852-862.
6. Martini WZ. Coagulopathy by hypothermia and acidosis: Mechanisms of thrombin generation and fibrinogen availability. J Trauma 2009; 67:202-208.
7. Cannon JW. Hemorrhagic shock. N Engl J Med 2018; 378:370-9
8. Gutierrez G, Reines HD, Wulf-Gutierrez ME. Clinical review: Hemorrhagic shock. Critical Care 2004, 8:373381(DOI 10.1 186/cc2851)
9. Hulíková M. Peripartálne krvácanie z pohľadu hematológa. Interná med. 2012; 12 (7-8):277-284
10. Dobiáš V. Hypovolemický hemoragický šok. Via Practica 3/2004; 172-174
11. Hooper N, Armstrong TJ. Hemorrhagic shock. In: StatPearls [Internet]. Treasure Island (FL): StatPearls Publishing; 2019 Jan. Dostupné: https:/ /www.ncbi.nlm. nih.gov/books/NBK470382
12. Cocchi MN, Kimlin E, Walsh M, Donnino MW. Identification and resuscitation of the trauma patient in shock. Emerg Med Clin North Am. 2007 Aug.25(3): 623-42, vii.
13. Hemorrhagic shock. https://emedicine. medscape.com/article/432650overview
14. Wilson M, Davis DP, Cimbra R. Diagnosis and monitoring of hemorrhagic shock during the initial resuscitation of multiple trauma patients: a review. J Emerg Med. 2003 May;24(4):413-22.
Náhle úmrtia Unilabs Slovensko 73
Kardiálne príčiny náhlych úmrtí










TÉMA ČÍSLA 74 inVitro
MUDr. Natália Vaňová, PhD., MBA Prednosta Interná klinika, Nemonica AGEL Košice-Šaca a LF UPJŠ
MUDr. Pavol Fülöp Interná klinika, Nemonica AGEL Košice-Šaca a LF UPJŠ
Etiológia
90 %
Odhadovaná úmrtnosť na SCA je približne 90 % a u tých, ktorí prežili, často pretrvávajú významné funkčné a/alebo kognitívne poruchy.
Úvod
Náhla srdcová smrť (sudden cardiac death – SCD) je definovaná ako náhle a neočakávané zastavenie kardiovaskulárnej funkcie (sudden cardiac arrest – SCA) vedúce k obehovému kolapsu. Výskyt SCD je u jednotlivcov v bežnej populácii relatívne zriedkavý, v rozmedzí 0,03 – 0,10 % ročne (1, 2). Napriek tomu sa na základe konzervatívnych odhadov na celom svete ročne vyskytujú najmenej 2 milióny prípadov SCA. Odhadovaná úmrtnosť na SCA je približne 90 % a u tých, ktorí prežili, často pretrvávajú významné funkčné a/alebo kognitívne poruchy (3). Identifikácia rizikových faktorov je dôležitým cieľom z klinického hľadiska, ako aj z hľadiska verejného zdravia. Tento prehľad poskytne informácie o známych či skúmaných prediktívnych faktoroch pre SCA/SCD vo všeobecnej populácii so zameraním na kardiálne príčiny.
Príčiny SCA/SCD sa líšia v závislosti od veku. Je dôležité si uvedomiť, že takmer 50 % prípadov SCA je z nekardiálnych príčin (4). Súhrnné zistenia z publikovanej literatúry naznačujú, že koronárna choroba srdca (CAD) predstavuje približne 80 % kardiálnych prípadov SCD (5). Najohrozenejšiu skupinu SCA tvoria pacienti, ktorí prežili SCA a dokonca aj pacienti s „reverzibilnou príčinou“ – čelia úmrtnosti 18 % po 2 rokoch (6). Druhú najrizikovejšiu skupinu tvoria pacienti so zníženou systolickou funkciou ľavej komory (LVEF). Faktory, ako sú vyššia funkčná trieda New York Heart Association (NYHA), nižšia LVEF, fibrilácia predsiení (FP) a trvalá komorová tachykardia (VT) prinášajú vyššie riziko arytmií (7) a zároveň zvyšujú podiel úmrtí z iných príčin. Tabuľka č. 1 sumarizuje ďalšie definované populácie SCA.
U mladších pacientov (do 35 rokov) je však ischemická choroba srdca menej častou príčinou SCA/SCD. Údaje z viacerých kohort ukázali, že arytmická príčina môže predstavovať približne 20 – 30 % náhlych nevysvetliteľných úmrtí (8). U mladších ľudí genetická mutácia srdca prispieva k značnému podielu náhlej nevysvetliteľnej smrti z arytmickej príčiny.
Náhle úmrtia Unilabs Slovensko 75
Ročne sa na celom svete vyskytujú najmenej 2 milióny prípadov náhlej srdcovej smrti (SCD), pričom kardiálna príčina má na svedomí približne polovicu. Identifikácia osôb so zvýšeným kardiálnym rizikom SCD je teda veľmi dôležitá z hľadiska verejného zdravia, čomu môže dopomôcť aj strojové učenie, ktoré využíva algoritmy na empirické „učenie“ vzorov z údajov.
Kardiovaskulárne príčiny SCD
Ischemická choroba srdca
• akútna ischémia (napr. akútny infarkt myokardu)
• prekonaný infarkt myokardu s prítomnosťou jazvy myokardu
• akútna ischémia vyskytujúca sa pri už preexistujúcej KCHS alebo jazvy myokardu
• kardiomyopatia spôsobená ischemickou chorobou srdca
• neischemická kardiomyopatia
• myokarditída (akútna a/alebo chronická)
• dilatačná kardiomyopatia
• hypertrofická kardiomyopatia
• kardiomyopatia spôsobená tachykardiou
• sarkoidóza
• srdcová amyloidóza
• Chagasova choroba
• kardiomyopatia vyvolaná stresom (Takotsubo kardiomyopatia)
• v súvislosti s prolapsom mitrálnej chlopne
• sekundárne pri systémových ochoreniach (napr. reumatoidná artritída, lupus, systémová skleróza, cukrovka)
• mitochondriálne ochorenie
• arytmogénna kardiomyopatia pravej/ľavej komory
• alkoholová kardiomyopatia
• peripartálna kardiomyopatia
• kardiomyopatia vyvolaná liekmi (napr. chemoterapia)
• nekompaktná ľavá komora
• reštriktívna kardiomyopatia (napr. eozinofilná endomyokardiálna fibróza, idiopatická endomyokardiálna fibróza, karcinoid, indukovaná žiarením, sklerodermia)
• infiltratívna kardiomyopatia (napr. morbus Fabry, Pompe, Danon, hemochromatóza)
• reumatické ochorenie srdca
• sekundárne pri svalovej dystrofii
• lymská karditída
• chlopňové ochorenie srdca
• ťažká aortálna stenóza (získaná)
• akútna ťažká aortálna alebo mitrálna regurgitácia
Primárne arytmické ochorenie bez sprievodného významného štrukturálneho ochorenia srdca
• syndróm dlhého QT (vrodený a získaný)
• Wol ov-Parkinsonov-Whiteov syndróm
• vrodená srdcová blokáda
• Brugadov syndróm
• katecholaminergná polymorfná komorová tachykardia
• syndróm krátkeho QT
• idiopatická komorová fibrilácia
• syndróm včasnej repolarizácie
• degeneratívne zmeny systému srdcového vedenia (sínusový uzol, atrioventrikulárny uzol, infranodoálne vedenie)
Vrodené srdcové choroby
• Fallotova tetralógia
• vrodene korigovaná transpozícia veľkých tepien
• Fontanov obeh
• chlopňové ochorenie (napr. ťažká aortálna stenóza)
• fyziológia jednej komory
• aortálna koarktácia
• dvojitý vývod pravej komory
• hypoplastický syndróm ľavého srdca
• prerušený aortálny oblúk
• pľúcna atrézia
• trikuspidálna atrézia
• celkový anomálny pľúcny venózny návrat
• truncus arteriosus
• Ebsteinova anomália
• Eisenmengerov syndróm
• septálny defekt
• ľavostranné odtokové lézie
Nonatherosklerotická
ischemická choroba srdca
• spontánna disekcia koronárnej artérie
• Kawasakiho choroba
• vaskulitída/arteritída
• fibromuskulárna dysplázia
• infarkt myokardu bez obštrukčných koronárnych artérií
• koronárna embólia
• koronárny vazospazmus
• premostenie myokardu
Iné
• srdcová tamponáda
• srdcová ruptúra
• disekcia aorty
• ruptúra/krvácanie intrakraniálnej aneuryzmy
• intrakraniálne krvácanie
• pľúcna embólia
• ľavý predsieňový myxóm
TÉMA ČÍSLA 76 inVitro
Tabuľka č. 1: Potenciálne kardiovaskulárne príčiny SCD
Štúdie zo Spojených štátov amerických a zo Škandinávie ukázali, že výskyt SCD je dvakrát až trikrát vyšší u mužov než u žien (9).
Najvýraznejší rozdiel vo výskyte SCD súvisiaci s pohlavím sa vyskytuje v premenopauzálnych a skorých postmenopauzálnych rokoch v strednom veku.
Podľa epidemiologických štúdií sa riziko SCA líši v závislosti od rasy. Výskum ukazuje, že výskyt SCD v USA je približne dvojnásobne vyšší medzi afroameričanmi než medzi bielymi Američanmi, 3,5-krát vyšší ako u aziatov a približne päťkrát vyšší než u hispáncov (10).
Viaceré dôkazy naznačujú súvislosť medzi obezitou a/alebo diabetom a rizikom SCD. V analýze 5 209 účastníkov vo Framinghamskej kohorte bola miera SCD vyššia medzi jednotlivcami, ak ich BMI bolo > 28,6 kg/m2 (11). V multietnickej štúdii ARIC bol vyšší pomer pásu k bokom (ukazovateľ centrálnej adipozity) silnejším asociatívnym faktorom pre SCD než BMI alebo obvod pása (11).
Spánkové apnoe je bežná porucha spánku a jeho prítomnosť je spojená so zvýšeným rizikom náhlej smrti. V metaanalýze 22 pozorovacích štúdií Heilbrunn a kol. (13) pozorovali, že ľudia so spánkovým apnoe mali dvojnásobne vyššie riziko náhlej smrti ako ľudia bez.
Súvislosť medzi socioekonomickým stavom (SES) a rizikom SCD bola zaznamenaná vo viacerých štúdiách. V systematickom prehľade
32 štúdií van Nieuwenhuizen et al. (14) uviedli, že ľudia s bydliskom v oblastiach s nízkym SES mali vyšší výskyt SCD a horšie prežívanie. Ako marker SES sa skúmali rôzne aspekty vrátane príjmu, vzdelania alebo kombinácie oboch. Pretože CAD je najčastejšou príčinou mimonemocničného SCA/SCD, predpokladá sa, že ľudia s nižším SES môžu byť vo väčšom riziku z dôvodu vyššej prevalencie rizikových faktorov aterosklerózy. Okrem toho sa predpokladá, že ľudia žijúci v prostrediach s nižším SES môžu byť vystavení sympatikovej hyperaktivite z dôvodu vyššieho stresu, čo potenciálne zvyšuje ich riziko SCA/SCD.
Náhle úmrtia Unilabs Slovensko 77
SES EKG sérové biomarkery jazva/fibróza myokardu rasa LVEF pohlavie vek RASTÚCERIZIKO
Obrázok č. 1: Komplexný model predikcie rizika SCD
Výskyt SCD je dvakrát až trikrát vyšší u mužov než u žien.
Javí sa, že genetické testovanie a rodinný skríning môžu byť užitočné na identifikáciu osôb s vyšším rizikom SCD v dôsledku arytmickej príčiny.
SCA u profesionálnych športovcov je veľmi medializovaná, no nie častá, s incidenciou 0,11 až 33,3 na 100 000. Športovci môžu mať zvýšené riziko SCA, najmä pri neodhalených štrukturálnych a genetických chybách srdca. Arytmogénna dysplázia pravej komory je jedinečná jednotka, pri ktorej môže byť cvičenie patogénne a akútne spustiť arytmiu (15).
Medzi ďalšie významné ohrozené populácie patria rekreační užívatelia drog, od kokaínu (16) po látky ako protihnačkový loperamid (17). Mechanizmy pre medikamentózne navodenú SCA zahŕňajú predávkovanie, predĺženie QT intervalu a torsades de pointes, koronárny vazospazmus a disekciu, akcelerovanú aterosklerózu, infarkt myokardu, myokarditídu a kŕče.
Predikcia SCD
Existuje veľký záujem o používanie biomarkerov na predpovedanie rizika SCA/SCD na individuálnej úrovni. Vo všeobecnej populácii existujú 3 široké triedy biomarkerov, ktoré boli študované ako prediktory SCA/SCD: 1. EKG, 2. sérové markery a 3. zobrazovacie parametre.
EKG
EKG markery odrážajú 3 hlavné koncepty patogenézy SCA/SCD: 1. srdcová autonómna abnormalita (napríklad srdcová frekvencia), 2. abnormálna ventrikulárna repolarizácia (napríklad QTc, analýza T-vlny) a 3. abnormálny substrát myokardu (napríklad fibróza alebo jazva), ktorý môže predisponovať k ventrikulárnym arytmiám (napríklad k hypertrofii ľavej komory alebo fragmentácii QRS).
Aro et al. (18) kombináciou známych EKG markerov spojených so SCD vyvinuli nové rizikové skóre zo štúdie Oregon Sudden Death Study určené na použitie u pacientov s neznámou LVEF alebo LVEF > 35 %. Identifikovali šesť abnormálnych EKG markerov: 1. srdcová frekvencia > 75 úderov za minútu, 2. hypertrofia ľavej komory (Sokolowove-Lyonove alebo Cornellove kritériá), 3. zóna oneskoreného prechodu QRS (≥ zvod V5), 4. široký predný uhol QRS-T (> 90 °), 5. predĺžený QTc (> 450 ms u mužov a > 460 ms u žien) a 6. predĺžený vrchol T-vlny do konca intervalu T-vlny (> 89 ms). Za každý marker bol priradený jeden bod. Po multivariabilnej úprave znamenalo vyššie skóre vyššie riziko SCD
Tabuľka č. 2: EKG parametre asociované so zvýšeným rizikom SCA/SCD
Srdcová frekvencia > 75/min.

Elektrická os srdca QRS-T (> 90 °)
Hypertrofia ľavej komory (Sokolowove-Lyonove alebo Cornellove kritériá)
Predĺžený QTc (> 450 ms u mužov a > 460 ms u žien)
Predĺžený vrchol T-vlny do konca intervalu T-vlny (> 89 ms)
Zóna prechodu QRS (≥ zvod V5)
TÉMA ČÍSLA 78 inVitro
Figure1. Epidemiology,causes,andpredictorsofsuddencardiacarrest(SCA)/suddencardiacdeath(SCD).AlthoughtheincidenceofSCA/SCDis infrequentforindividualsinthegeneralpopulation,theaggregateglobalburdenofSCA/SCDissubstantialbecauseofthesizeofthepopulationat risk(A).(B)TraditionalandemergingriskfactorsassociatedwithSCA/SCDinthegeneralpopulation.Ingeneral,approximately50%ofSCA/SCD casesareattributabletoacardiaccause(B).(C)ThemajorpathophysiologicmechanismsandmanifestationsofSCA/SCD.Olderageisstrongly associatedwithahigherincidenceofSCA/SCD.1 Amongyoungerindividuals(youngerthan35years),suddenunexpecteddeathpresumedtobe relatedtoaprimaryarrhythmiccauseaccountedforapproximately20%-30%ofSCD(D).13-18 ApotentialoptimalapproachforSCA/SCDrisk predictioninthegeneralpopulationisproposed(E).SES,socioeconomicstatus.
(1 bod: OR, 2,2 [95 % IS, 1,2 – 4,1]; 2 body: OR, 4,0 [95 % IS, 2,2 – 7,5]; 3 body: OR, 8,3 [95 % CI, 4,3 – 16,1], 4 body: OR, 21,2 [95 % CI, 9,4 – 47,7]). Pri testovaní na klinickom modeli (t. j. LVEF, vek, pohlavie, hypertenzia, diabetes), dodatočné použitie skóre rizika EKG výrazne zvýšilo diskrimináciu modelu (z 0,63 na 0,75; P < 0,001) a zlepšilo celkovú čistú reklasifikáciu o 31,1 %.

Sérové biomarkery
Sérové biomarkery spojené s vyšším rizikom SCD možno rozdeliť do 5 patofyziologických dráh: 1. zvýšený vaskulárny a/alebo systémový zápal (napríklad zvýšené hladiny C-reaktívneho proteínu, interleukínu-6, fibrinogénu, počtu bielych krviniek), 2. subklinické poškodenie myokardu (vysokocitlivý srdcový troponín T/I), 3. napínanie myokardu (natriuretický peptid typu B), 4. abnormálne lipidové profily (napríklad cirkulujúca neesterifikovaná mastná kyselina – NEFA, lipoproteínové častice podobné remnantom, lipoproteínový cholesterol s nízkou hustotou) a 5. markery hyperglykémie (napríklad postprandiálna glykémia, hemoglobín A1c).
Genetika
Maregalli et al. (19) v roku 2009 zistili, že mutácia v géne SCN5A vedie k vytvoreniu predčasného stop kodónu alebo k bodovej mutácii vedúcej k strate funkcie Na+ kanálov a má za následok rozvoj závažnejšej formy Brugadovho syndrómu. Ak sa vysoká voltáž na EKG spája so skráteným intervalom PQ (pod 120 ms), treba myslieť na Fabryho chorobu, ktorú vieme geneticky verifikovať. Syndróm náhlej arytmickej smrti môže odrážať dedičné arytmie, ako sú syndróm dlhého QT intervalu, katecholaminergná polymorfná VT a spomínaný Brugadov syndróm. To podčiarkuje potenciálnu užitočnosť genetického
testovania a rodinného skríningu na identifikáciu osôb s vyšším rizikom SCD v dôsledku arytmickej príčiny.
Zobrazovacie markery
Oblasti myokardiálnej fibrózy/jazvy môžu slúžiť ako substrát pre reentry, čo je dôležitá zložka v patofyziológii ventrikulárnych arytmií (20). Typicky sa tieto oblasti detegujú podľa prítomnosti neskorého gadolíniového zosilnenia (LGE) pomocou srdcovej magnetickej rezonancie (CMR) alebo pomocou echokardiografie (ECHO) (21, 22). Existuje množstvo klinických údajov, ktoré podporujú asociáciu fibrózy myokardu/jazvy a rizika VT/KF a/alebo SCD. Za zmienku stojí, že tieto štúdie sa zamerali na pacientov so zníženou
Náhle úmrtia Unilabs Slovensko 79
Obrázok č. 2: Optimálny prístup k predikcii rizika SCD
Viaceré dôkazy naznačujú súvislosť medzi obezitou a/alebo diabetom a rizikom SCD.
LVEF (< 35 %), s predchádzajúcim infarktom myokardu alebo so štrukturálnym ochorením srdca, ako je hypertrofická kardiomyopatia. To, či je prítomnosť myokardiálnej fibrózy/jazvy prediktorom SCA/SCD vo všeobecnej populácii, si vyžaduje ďalšie štúdie. V sérii 749 pacientov so zachovanou LVEF (v priemere 66 %), ktorí podstúpili CMR v referenčnom centre v rámci diferenciácie kardiologických symptómov, prítomnosť LGE nebola spojená (u 54 % pacientov) s VT/VF alebo SCA/ SCD (23). Keďže v bežnej populácii nie je kapacitne možné vykonávať zobrazovanie srdca ako skríningový nástroj na SCA/SCD, detekciu jazvy/fibrózy myokardu možno dosiahnuť pomocou 12-zvodového EKG. Prítomnosť repolarizačných zmien (horizontálna/zostupná depresia ST ≥ 0,05 mV s negatívnou T-vlnou v ktoromkoľvek zo zvodov I, II, aVL alebo V3-V6), vlna Q vo zvodoch V1 alebo V2 a ľavá zadná fascikulárna blokáda koreluje s LGE na CMR (24).
Nové možnosti diagnostiky
Strojové učenie (ML) je technika, ktorá využíva algoritmy na empirické „učenie“ vzorov z údajov. ML môže zvýšiť presnosť rozpoznávania vizuálnych vzorov. Keďže ML má schopnosť odhaliť vzorce na predpovedanie ochorenia, ktoré by inak ľudia nemuseli ľahko rozpoznať, môže sa stať užitočným nástrojom pre analýzu EKG. Attia et al. (25) pomocou konvolučných neurónových sietí (formy hlbokého učenia v ML) úspešne identifikovali osoby, u ktorých sa následne rozvinula FP na základe ich 12-zvodového EKG pri sínusovom rytme. Táto štúdia naznačila, že rozvoju FP môžu predchádzať jemné srdcové – elektrické a/alebo štrukturálne – zmeny. Okrem toho výsledky štúdií naznačujú, že techniky hlbokého učenia môžu identifikovať rôzne stavy z EKG ako napríklad abnormálnu srdcovú kontraktilitu (napríklad LVEF), abnormálnu srdcovú relaxáciu (diastolická dysfunkcia), amyloidózu či dilatačnú kardiomyopatiu (26, 27, 28).
1 hodinu
V štúdii analyzujúcej zmeny srdcovej a respiračnej frekvencie pomocou strojového učenia, Lee a kol. vyvinuli model, ktorý dokázal predpovedať VT 1 hodinu pred začiatkom.
V štúdii analyzujúcej zmeny srdcovej a respiračnej frekvencie pomocou ML, Lee a kol. (29) vyvinuli model, ktorý dokázal predpovedať VT 1 hodinu pred začiatkom so senzitivitou 0,88, špecificitou 0,82 a plochou pod krivkou 0,93. V inej štúdii Taye et al. (30) rôznymi algoritmami ML dokázali – na základe variability srdcovej frekvencie – predpovedať budúci výskyt ventrikulárnych arytmií s presnosťou 66 – 85 %. Kľúčovým obmedzením týchto štúdií je, že pozitívny výsledok (pretrvávajúca alebo nepretrvávajúca KT/KF) nemusí nevyhnutne viesť k SCA/SCD.
Záver
SCD je dôležitým problémom verejného zdravia kvôli značnému počtu ohrozených jedincov. Existuje mnoho overených a vznikajúcich rizikových faktorov, ktoré sú spojené s vyšším rizikom SCA/SCD. Spomedzi všetkých má EKG najväčší potenciál na prognózu rizika SCA/SCD u jednotlivca. Vďaka neinvazívnej povahe získavania údajov je ľahko a rýchlo dostupné. Údaje získané pomocou EKG spolu s biologickými a laboratórnymi markermi môžu zlepšiť predikciu rizika SCA/SCD v bežnej populácii. Integrácia ML na ďalšie zlepšenie predikcie rizika SCA/SCD je síce atraktívnou, ale stále neoverenou oblasťou, ktorá si však zaslúži ďalšie štúdium.
TÉMA ČÍSLA 80 inVitro
Literatúra
1. Straus SM, Bleumink GS, Dieleman JP, et al. The incidence of sudden cardiac death in the general population. J Clin Epidemiol 2004;57: 98-102.
2. Martens E, Sinner MF, Siebermair J, et al. Incidence of sudden cardiac death in Germany: results from an emergency medical service registry in Lower Saxony. Europace 2014;16:1752-8.
3. Narayan SM, Wang PJ, Daubert JP. New concepts in sudden cardiac arrest to address an intractable epidemic: JACC state of-the-art review. J Am Coll Cardiol 2019;73:70-88.
4. Myat A, Song KJ, Rea T. Out-of-hospital cardiac arrest: current concepts. Lancet 2018;391:970-9.
5. Myerburg RJ, Interian A Jr, Mitrani RM, Kessler KM, Castellanos A. Frequency of sudden cardiac death and profiles of risk.Am J Cardiol 1997;80. 10F-9F.
6. Wyse DG, Friedman PL, Brodsky MA, et al. Life-threatening ventricular arrhythmias due to transient or correctable causes: high risk for death in follow-up. J Am Coll Cardiol 2001;38:1718-24.
7. Zeitler EP, Al-Khatib SM, Friedman DJ, et al. Predicting appropriate shocks in patients with heart failure: patient level meta-analysis from SCD-HeFT and MADIT II. J Cardiovasc Electro- physiol 2017;28:1345-51.
8. Jayaraman R, Reinier K, Nair S, et al. Risk factors of sudden cardiac death in the young: multiple-year communitywide assessment. Circu- lation 2018;137:1561-70.
9. Haukilahti MAE, Holmström L, Vähätalo J, et al. Sudden cardiac death in women. Circulation 2019;139:1012-21.
10. Tseng ZH, Olgin JE, Vittinghoff E, et al. Prospective countywide surveillance and autopsy characterization of sudden cardiac death: POST SCD study. Circulation 2018;137:2689-700.
11. Hubert HB, Feinleib M, McNamara PM, Castelli WP. Obesity as an independent risk factor for cardiovascular disease: a 26-year follow-up of participants in the Framingham Heart Study. Circulation 1983;67: 968-77.
12. Adabag S, Huxley RR, Lopez FL, et al. Obesity related risk of sudden cardiac death in the atherosclerosis risk in communities study. Heart 2015;101:215-21.
13. Heilbrunn ES, Ssentongo P, Chinchilli VM, et al. Sudden death in individuals
with obstructive sleep apnoea: a systematic review and meta- analysis. BMJ Open Respir Res 2021;8:e000656.
14. van Nieuwenhuizen BP, Oving I, Kunst AE, et al. Socio-economic differences in incidence, bystander cardiopulmonary resuscitation and survival from out-of-hospital cardiac arrest: a systematic review. Resuscitation 2019;141:44-62.
15. James CA, Bhonsale A, Tichnell C, et al. Exercise increases age-related penetrance and arrhythmic risk in arrhythmogenic right ventricular dysplasia/cardiomyopathy-associated desmo- somal mutation carriers. J Am Coll Cardiol 2013; 62:1290-7.
16. Havakuk O, Rezkalla SH, Kloner RA. The cardiovascular effects of cocaine. J Am Coll Cardiol 2017;70:101–13.
17. Nattel S. An emerging malignant arrhythmia epidemic due to loperamide abuse underlying mechanisms and clinical relevance. J Am Coll Cardiol EP 2016;2:790–2.
18. AroAL,ReinierK,RusinaruC,etal. Electricalrisk Scorebeyond The Left ventricular ejection fraction: prediction of sudden cardiac death in the Oregon Sudden Unexpected Death Study and the Atherosclerosis Risk in Communities Study. Eur Heart J 2017;38:3017-25.
19. Meregalli PG, Tan HL, Probst V, Koopmann TT, Tanck MW, Bhuiyan ZA, Sacher F, Kyndt F, Schott JJ, Albuisson J, Mabo P, Bezzina CR, Le Marec H, Wilde AA. Type of SCN5A mutation determines clinical severity and degree of conduction slowing in lossof-function sodium channelopathies. Heart Rhythm. 2009 Mar;6(3):341-8. doi: 10.1016/j.hrthm.2008.11.009. Epub 2008 Nov 11. PMID: 19251209.
20. Mandoli GE, D’Ascenzi F, Vinco G, et al. Novel approaches in cardiac imaging for non-invasive assessment of left heart myocardial fibrosis. Front Cardiovasc Med 2021;8:614235.
21. Disertori M, Rigoni M, Pace N, et al. Myocardial fibrosis assessment by LGE is a powerful predictor of ventricular tachyarrhythmias in ischemic and nonischemic LV dysfunction: a metaanalysis. JACC Cardiovasc Imaging 2016;9:1046-55.
22. Li X, Fan X, Li S, et al. A novel risk stratification score for sudden cardiac death prediction in middle-aged, nonischemic dilated cardio- myopathy
patients: the ESTIMATED score. Can J Cardiol 2020;36: 1121-9.
23. Lota AS, Tsao A, Owen R, et al. Prognostic significance of nonischemic myocardial fibrosis in patients with normal LV volumes and ejection- fraction. JACC Cardiovasc Imaging 2021;14:2353-65.
24. Inoue YY, Soliman EZ, Yoneyama K, et al. Electrocardiographic strain pattern is associated with left ventricular concentric remodeling, scar, and mortality over 10 years: the MultiEthnic Study of Atherosclerosis. J Am Heart Assoc 2017;6:e006624.
25. Attia ZI, Noseworthy PA, LopezJimenez F, et al. An artificial intelligence-enabled ECG algorithm for the identification of patients with atrial fibrillation during sinus rhythm: a retrospective analysis of outcome prediction. Lancet 2019;394:861-7.
26. Goto S, Mahara K, Beussink-Nelson L, et al. Artificial intelligence- enabled fully automated detection of cardiac amyloidosis using electrocardiograms and echocardiograms. Nat Commun 2021;12:2726.
27. Sengupta PP, Kulkarni H, Narula J. Prediction of abnormal myocardial relaxation from signal processed surface ECG. J Am Coll Cardiol 2018;71:1650-60.
28. Shrivastava S, Cohen-Shelly M, Attia ZI, et al. Artificial intelligence- enabled electrocardiography to screen patients with dilated cardiomyopathy. Am J Cardiol 2021;155:121-7.
29. Lee H, Shin SY, Seo M, Nam GB, Joo S. Prediction of ventricular tachycardia one hour before occurrence using artificial neural networks. Sci Rep 2016;6:32390.
30. Taye GT, Hwang HJ, Lim KM. Application of a convolutional neural network for predicting the occurrence of ventricular tachyarrhythmia using heart rate variability features. Sci Rep 2020;10:6769.
Náhle úmrtia Unilabs Slovensko 81
Trombocyt pod drobnohľadom špecialistu
 MUDr. Zuzana Jedináková, PhD. Hematológ Ambulancia hematológie a transfuziológie Centrum hemostázy a trombózy, Martin Unilabs Slovensko
MUDr. Zuzana Jedináková, PhD. Hematológ Ambulancia hematológie a transfuziológie Centrum hemostázy a trombózy, Martin Unilabs Slovensko









TÉMA ČÍSLA 82 inVitro
Infarkt myokardu, ischemická cievna mozgová príhoda či závažné ataky venózneho tromboembolizmu patria medzi časté príčiny úmrtí, respektíve prekonanie takejto trombotickej komplikácie často dramatickým spôsobom mení kvalitu života pacienta. Trombocyt zohráva v procese zrážania krvi dôležitú úlohu. Poznanie jeho štruktúry, funkcie, ako aj možností ovplyvnenia jednotlivých procesov, do ktorých sa aktívne, či pasívne zapája, sa v tomto svetle javí ako mimoriadne potrebné. V súčasnosti sa mnohé výskumy zameriavajú nielen na možnosti účinnej liečby, ale najmä na identifikáciu možných laboratórnych parametrov s prediktívnou hodnotou.
Trombocyt
Trombocyty, nazývané aj krvné doštičky, sú najmenšími bunkami v ľudskom tele. Sú dôležitou súčasťou krvi a ich hlavnou úlohou je (spolu s koagulačnými faktormi) reagovať na krvácanie po poškodení cievy zhlukovaním sa a iniciovaním procesu zrážania krvi. (1) Krvné doštičky sú bezjadrové bunky, predstavujú úlomky cytoplazmy megakaryocytov v kostnej dreni, ktoré sa vyplavujú do cirkulácie. Cirkulujúce neaktívne krvné doštičky majú bikonkávny diskoidný (šošovkovitý) tvar. V tomto neaktívnom stave veľkosťou nepresahujú v najväčšom rozmere 2 – 3 µm. (1) Neaktivovaný trombocyt má na svojom povrchu množstvo plytkých záhybov. Po aktivácii za účelom zväčšenia celkového povrchu trombocytu, a tým aj odhalenia potrebných receptorov, dochádza k tvorbe mnohých výbežkov – pseudopódií, ktoré sú nevyhnutné pri vytváraní primárnej zátky.
Trombocyt má v aktivovanom stave tvar chobotnice. (Obrázok č. 1)
do 30 minút
Pri rýchlej analýze vzorky pacienta s podozrením na pseudotrombocytopéniu maximálne do 30 minút od odberu nedetegujeme významne znížené počty trombocytov.
Napriek malým rozmerom má trombocyt veľmi dobre zadefinovanú štruktúru a morfológiu, ktorá je nevyhnutná pre jeho úlohu v hemostáze, ako aj v udržiavaní cievnej integrity.
Trombocyty preto obsahujú mnohé intracelulárne štruktúry, medzi ktoré patria najmä rôzne druhy granúl – denzné granuly, α-granuly, λ- a γ-granuly. Aktivované doštičky uvoľňujú obsah týchto granúl pomocou kanálikového systému do extracelulárneho priestoru. Jednoducho povedané, naviazané a aktivované trombocyty uvoľňujú chemotaktické látky za účelom pritiahnutia ďalších trombocytov na miesto endotelového poškodenia.
α-granuly (alfa) obsahujú P-selektín, doštičkový faktor 4 (platelet factor 4 – PF4), transformujúci rastový faktor β1 (transforming growth factor β1 – TGFβ1), od doštičiek odvodený rastový faktor (platelet-derived growth factor – PDGF), fibronektín, β-trombomodulín, von Willebrandov faktor (vWF), fibrinogén a koagulačné faktory V a XIII. (2)
δ-granuly (delta/denzné) obsahujú ADP alebo ATP, vápnikové ióny a serotonín. (2)
γ-granuly (gamma) sú podobné lyzozómom a obsahujú niekoľko typov hydrolytických enzýmov. (2)
λ-granuly (lambda) obsahujú peroxizómy. (2)
Náhle úmrtia Unilabs Slovensko 83
Funkcia trombocytov
Ako už bolo vyššie spomínané, hlavnou úlohou krvných doštičiek je zúčastňovať sa na hemostáze – procese zastavenia krvácania v mieste porušeného endotelu. V prvom kroku sa trombocyty viažu na odhalené subendotelové štruktúry. Tento jav sa nazýva adhézia. Následne dochádza k zmene tvaru krvnej doštičky, čo vedie k expozícii receptorov na jej povrchu a k sekrécii chemických zlúčenín – k aktivácii. Agregácia trombocytov v treťom kroku je charakterizovaná vytváraním spojení medzi doštičkami navzájom. Formovanie tejto doštičkovej zátky (primárna hemostáza) je spojené s aktiváciou koagulačnej kaskády, ktorej konečným produktom je vytvorenie fibrínu a pevnej fibrínovej zátky. (3)
Vyšetrenia trombocytov
Medzi základné vyšetrenia trombocytov patrí v prvom kroku vyšetrenie krvného obrazu pomocou automatického hematologického analyzátora, ďalej len krvinkový analyzátor. Medzi sledované doštičkové parametre patrí počet trombocytov (PLT), ich veľkosť (stredný objem trombocytov – MPV – medium platelet volume) a distribučná šírka trombocytov (PDW – platelet distribution width).


Počet trombocytov
Fyziologický počet trombocytov sa v kaukazskej populácii pohybuje v rozmedzí 150 – 450 × 109/l. (1) Počet trombocytov je o čosi vyšší u žien než u mužov a s určitými cyklickými zmenami – s miernym poklesom počas
menštruácie. (4) Nižší počet krvných doštičiek sa fyziologicky vyskytuje v zdravej afro-karibskej populácii a u africkej rasy je celkovo nižší v porovnaní s kaukazskou rasou. (4) Znížený počet trombocytov v periférnej krvi sa nazýva trombocytopénia, zvýšený počet trombocytóza.
Zvýšený počet trombocytov môže byť reaktívneho charakteru. Trombocytózu detegujeme často v prípade akútnych stavov – pri infekčných ochoreniach, po operáciách, pri hojení rán. Miernu, no chronickú trombocytózu typicky nachádzame v teréne chronických anémií, najmä v prípade zvýšených chronických krvných strát. Po úprave anémie dochádza aj k úprave trombocytózy. Pretrvávajúca až progredujúca trombocytóza je charakteristickým znakom myeloproliferatívnych ochorení a je nevyhnutné zrealizovať diagnostické kroky za účelom ich vylúčenia.
Pri zníženom počte trombocytov rozlišujeme ľahkú, stredne ťažkú a ťažkú trombocytopéniu. V klinickej praxi sa používa viacero klasifikácií, no vo všeobecnosti možno za stredne ťažkú trombocytopéniu považovať počet trombocytov v rozmedzí 30 – 70 × 109/l, za ťažkú trombocytopéniu počet trombocytov pod 30 × 109/l. (3) Stredne ťažké až ťažké trombocytopénie vyžadujú urgentnú diferenciálnu diagnostiku, najmä za účelom rozlíšenia možnej primárnej imúnnej trombocytopénie od trombocytopénie sprevádzajúcej závažné ochorenia krvotvorby.
TÉMA ČÍSLA 84 inVitro
Obrázok č. 1: Vyšetrenie trombocytu v elektrónovom mikroskope A – trombocyt v neaktívnom stave B – trombocyt po aktivácii (17)
V klinickej praxi sa nezriedkavo stretávame aj s fenoménom pseudotrombocytopénie. Ide o stav, pri ktorom počas vyšetrenia krvného obrazu pomocou krvinkového analyzátora zachytávame falošne nízky počet trombocytov rôzne závažného stupňa. U časti populácie dochádza po odobratí periférnej krvi do skúmavky s obsahom protizrážavého roztoku kyseliny etyléndiamíntetraoctovej (EDTA) k zhlukovaniu trombocytov spolu s leukocytmi do roziet. Tento jav je výsledkom väzby prirodzene sa vyskytujúcej protilátky (aglutinínu) na glykoproteín IIb/IIIa, ktorý sa exponuje po odštiepení iónov vápnika v prítomnosti EDTA.
(3) Z vlastných klinických skúseností vyplynulo, že pri rýchlej analýze vzorky pacienta s podozrením na pseudotrombocytopéniu maximálne do 30 minút od odberu nedetegujeme významne znížené počty trombocytov. Po prekročení tohto limitu zvyčajne pozorujeme signifikantný pokles trombocytov až na úroveň ťažkej trombocytopénie v priamej závislosti od dĺžky časového intervalu. Táto skutočnosť vysvetľuje prípady, keď sme u toho istého pacienta v priebehu len niekoľkých dní zaznamenali diametrálne odlišné počty krvných doštičiek. Preto sa v situáciách, keď nie je možné zabezpečiť okamžitú analýzu, odporúča odber vzorky do skúmavky s obsahom protizrážavého roztoku citrátu sodného – fyziologický počet trombocytov potvrdí podozrenie na pseudotrombocytopéniu.
Stredný objem trombocytov (MPV)
Na stanovenie veľkosti trombocytov sa využívajú rovnaké techniky ako pri analýze červených krviniek. MPV sa odvodzuje z impedančnej distribučnej krivky. Za fyziologický sa považuje objem trombocytov v rozmedzí od 6,5 – 12 fl. Parameter je veľmi závislý od spôsobu analýzy a od času a spôsobu uskladnenia vzorky periférnej krvi pred samotným vyšetrením. Ak sa na vyšetrenie použije impedančná technika, MPV nepriamo úmerne koreluje s počtom trombocytov u zdravých jedincov. MPV je naopak nižší, ak je trombocytopénia dôsledkom megaloblastovej anémie alebo zlyhania kostnej drene. (4) Veľké trombocyty sú viac hemostaticky aktívne ako trombocyty menšie. Po funkčnej stránke je teda prítomnosť väčších trombocytov významnejšia ako znížený MPV. Vzostup MPV bol pozorovaný v prípade pacientov s vyšším rizikom infarktu myokardu a ischemických cievnych mozgových príhod. (4) Vysoký MPV je typickým nálezom pri vrodených makrotrombocytopéniách. Medzi najznámejšie vrodené trombocytopénie s veľkými trombocytmi patrí aj Bernardov-Soulierov syndróm (spojený aj s trombocytopatiou) či Mayova-Hegglinova anomália, Epsteinov syndróm, Fechtnerov a Sebastianov syndróm, pri ktorých je makrotrombocytopénia jedným z typických nálezov pri komplexných syndrómoch. (3) Vo všeobecnosti býva MPV zvýšený aj v teréne myeloproliferatívnych ochorení, no na odlíšenie esenciálnej trombocytémie od reaktívnych foriem je tento parameter nedostatočný. (4)
PDW
Distribučná šírka trombocytov (PDW) informuje o „miere uniformnosti“ krvných doštičiek, poukazuje na prípadnú anizocytózu v populácii trombocytov.
Distribučná šírka trombocytov a iné doštičkové parametre Z ostatných parametrov, ktoré bývajú automaticky počítané a uvádzané, je vhodné spomenúť ešte distribučnú šírku trombocytov (platelet distribution width – PDW), ktorá informuje o „miere uniformnosti“ krvných doštičiek. Poukazuje na prípadnú anizocytózu v populácii trombocytov. PCT – „platokrit“ je analógiou hematokritu. Vypočítava sa na základe MPV a celkového počtu trombocytov a zodpovedá objemu cirkulujúcich trombocytov v určitom objeme krvi (1) (s fyziologickými hodnotami 1,08 – 2,82 ml/l). Niektoré analyzátory udávajú aj pomerné zastúpenie veľkých trombocytov (platelet large cell ratio – P-LCR), ktoré sú väčšie ako stanovená horná hranici 12 fl. (1) V našich podmienkach sa za fyziologické hodnoty považuje prítomnosť týchto buniek v rozmedzí 11 – 45 %.

Náhle úmrtia Unilabs Slovensko 85
Vysoký P-LCR alebo PDW môžu signalizovať aj periférnu deštrukciu doštičiek na imunitnom podklade. (1) PCT je parameter vypočítaný a nemá význam pre klinickú prax. (1) Všetky sledované doštičkové parametre sú špecifické pre použitý typ analyzátora, preto je nevyhnutné riadiť sa referenčnými hodnotami udávanými v danom laboratóriu. (1)
Morfologické vyšetrenie trombocytov
V krvnom nátere pri použití klasickej optickej mikroskopie sa trombocyty javia ako purpurové bodkovité útvary, ktorých priemer predstavuje približne 20 % priemeru červenej krvinky. V krvnom nátere sa hodnotí počet, tvar, veľkosť, ako aj tvorba prípadných zhlukov trombocytov (Obrázok č. 2).
Elektrónová mikroskopia sa v bežnej klinickej praxi v rutinnom vyšetrení nepoužíva, ale jej zavedenie pred viac ako 70 rokmi prinieslo zásadné poznatky o ultraštruktúre trombocytov v neaktívnom aj aktivovanom stave, čo viedlo k porozumeniu ich funkcie v procese hemostázy.
Funkčné vyšetrenie trombocytov
V poslednom období vzrástla klinická požiadavka na vyhodnotenie funkcie trombocytov.
Zhodnotiť ich funkčný stav je veľmi dôležité v rámci diagnostiky krvácavých ochorení, pri hodnotení odpovede na podávanú protidoštičkovú liečbu, pri perioperačnom vyhodnocovaní hemostázy. (2) Existuje množstvo testov, no často sú založené na rôznom princípe – vyhodnocovanie agregability, aktivácie trombocytov, fyzikálnych vlastností krvnej zrazeniny, správania sa trombocytov v podmienkach rôzneho šmykového napätia... Veľkou nevýhodou pri hodnotení funkčného stavu trombocytu je
Vyšetrenie trombofilného stavu (vrodeného aj získaného) sa často realizuje aj v rámci diferenciálnej diagnostiky tehotenských komplikácií.
skutočnosť, že krvné doštičky sú bunky, ktoré sa veľmi ľahko aktivujú počas predanalytickej fázy vyšetrenia, čím môže dochádzať aj k výraznému skresleniu získaných údajov. Prehľad najčastejšie využívaných testov funkcie trombocytov rozdelených na základe princípu vyšetrenia uvádza Tabuľka č. 1. Poruchu funkcie trombocytov označujeme termínom trombocytopatia.
Základným princípom testovania funkcie trombocytov (no aj celkového vyšetrenia trombofilného stavu) by mala byť kladná odpoveď na otázku, či bude mať výsledok testovania vplyv na ďalší manažment liečby pacienta. (5)
A B C
Obrázok č. 2: Vyšetrenie trombocytov v krvnom nátere (18)
A: Esenciálna trombocytémia – zhluky trombocytov pri trombocytóze
B: Pseudotrombocytopénia ako následok tvorby zhlukov trombocytov
C: Trombocytopénia pri primárnej imúnnej trombocytopénii



TÉMA ČÍSLA 86 inVitro
Tabuľka č. 1: Metódy vyšetrovania funkcie trombocytov (4) Čas krvácania Natívna plná krv Skríningový test
Testy založené na princípe agregácie doštičiek
Svetelná agregometria citrátová PRP skríningový test pre krvácavé ochorenia, diagnostická metóda pre defekty trombocytov, monitoring protidoštičkovej liečby
Impedančná agregometria citrátová plná krv skríningový test pre krvácavé ochorenia, diagnostická metóda pre defekty trombocytov, monitoring protidoštičkovej liečby
Lumiagregometria citrátová plná krv vyšetrenie sekrečných schopností doštičiek
Plateletworks citrátová plná krv monitoring doštičkovej odpovede na protidoštičkovú liečbu
Testy založené na princípe adhézie v podmienkach šmykového napätia
PFA-100, inovácia PFA-200 citrátová plná krv zhodnotenie rizika krvácania a efektu liekov, vyhľadávanie závažnej dysfunkcie trombocytov odhaľujúcej vWD
Global Thrombosis Test (GTT) natívna plná krv vyhodnotenie funkcie doštičiek a trombolýzy
Metódy hodnotiace funkciu trombocytov kombinované s viskoelastickými testami
Tromboelastografia (TEG)
Rotačná tromboelastometria (ROTEM)
citrátová plná krv zhodnotenie globálnej hemostázy a monitoring efektu protidoštičkovej liečby
citrátová plná krv zhodnotenie globálnej hemostázy a monitoring efektu protidoštičkovej liečby, diagnostika defektov trombocytov
Analýza trombocytov pomocou prietokovej cytometrie
Prietoková cytometria citrátová plná krv, PRP, preprané trombocyty
Testy hodnotiace metabolity tromboxánu
Rádio- alebo enzýmovo značené imunologické testy (ELISA)
Vysvetlivky:
beta-TG – beta-tromboglobulín
sérum, moč, citrátová plazma
ELISA – enzyme-linked immunosorbent assay
GTT – global thrombosis test (globálny test trombózy)
PFA – platelet function assay (test funkcie trombocytov)
PF-4 – platelet factor 4 (doštičkový faktor 4)
PRP – platelet rich plasma (plazma bohatá na doštičky)
V prípade hlbokej venóznej trombózy (HVT) sa najčastejšie odporúča testovanie pacientov po jej prekonaní najmä v mladšom veku (do 45. roku života), bez jasného vyvolávajúceho faktora, v prípade výskytu trombózy v atypickej lokalite (v. lienalis, mezenteriálne vény…) a tiež v prípade pozitívnej rodinnej anamnézy na výskyt HVT. Mnohé realizované štúdie skúmajúce
zhodnotenie počtu trombocytov, detekcia aktivácie trombocytov na základe zvýšenej expresie povrchových/cytoplazmatických markerov
meranie metabolitov TXA2 (beta-TG, PF-4, solubilný P-selektín)
ROTEM – rotational thromboelastometry (rotačná tromboelastometria)
TEG – tromboelastografia
TXA2 – tromboxán A2
vWD – von Willebrand disease (von Willebrandova choroba)
vzťah medzi vrodenou trombofíliou a artériovými trombotickými komplikáciami neviedli k jednoznačným záverom. (6) Neexistujú jasné dôkazy, že by prítomnosť vrodenej trombofílie mala viesť k inej forme sekundárnej prevencie. (5, 7) Vyšetrenie trombofilného stavu (vrodeného aj získaného) sa často realizuje aj v rámci diferenciálnej diagnostiky tehotenských komplikácií.
Náhle úmrtia Unilabs Slovensko 87
Medzi najčastejšie patria opakujúce sa straty plodu, pôrod mŕtveho plodu, preeklampsia, intrauterinná rastová retardácia plodu. V poslednom čase býva trombofilný stav vylučovaný aj po neúspešných cykloch asistovanej reprodukcie a v prípadoch primárnej alebo sekundárnej sterility pacientky, aj keď indikácia vyšetrenia za týchto okolností nie je celkom jasná. Zhodnotiť vplyv trombofílie alebo zmien iných hemostazeologických laboratórnych parametrov na výskyt vyššie uvedených tehotenských komplikácií je veľmi náročné. Potvrdenie kauzality pri prítomnosti iných, mnohokrát významnejších nehematologických faktorov je takmer nemožné. (6) Bola potvrdená najmä súvislosť s intrauterinnou rastovou retardáciou a preeklampsiou. (9) V týchto dvoch prípadoch bol potvrdený aj benefit z podávanej prevencie pomocou kyseliny acetylsalicylovej (ASA) alebo nízkomolekulových heparínov (LMWH – low molecular weight heparins). (10)
K vyšetreniu funkčného stavu trombocytov pristupujeme pri klinických ťažkostiach pacienta/ pacientky a pri negatívnom výsledku základného skríningu trombofilného stavu (neprítomnosť vrodenej trombofílie, negatívne vyšetrenie na antifosfolipidový syndróm, ako aj pri fyziologickom náleze parametrov špeciálnej hemostázy). Po odobratí vzorky periférnej krvi je nevyhnutné zrealizovať vyšetrenie v čo najkratšom čase. Pri vyhodnocovaní analýzy treba mať na pamäti, že výsledok môže byť ovplyvnený
viacerými nezávislými faktormi pôsobiacimi počas predanalytickej aj analytickej fázy vyšetrenia. Základným princípom je zabezpečiť odber a spracovanie vzoriek pacientov za rovnakých podmienok, aby boli výsledky vyšetrenia interpretovateľné a navzájom porovnateľné.
(2) Medzi faktory, ktoré môžu zohrávať úlohu v diagnostickom procese, patria:
a) na strane pacienta – akútne zápalové ochorenie, dekompenzácia chronického ochorenia, ťažké aterosklerotické poškodenie ciev, hojenie poranení, pooperačné stavy, nadmerná fyzická záťaž, hormonálne zmeny… Otázny je vplyv dlhodobého fajčenia, ako aj prípadnej nadmernej psychickej záťaže.
b) na strane samotného vyšetrenia – spôsob odberu vzorky, ako aj čas jej vyšetrenia od odberu, parametre centrifugácie, počet trombocytov vo vyšetrovanej vzorke.
Z vlastných skúseností možno taktiež poznamenať, že aktivačný status trombocytov je do značnej miery ovplyvnený aj užívaním antitrombotickej terapie.
Medzi najčastejšie používané laboratórne metódy hodnotiace funkciu trombocytov patrí vyšetrenie pomocou agregometrie, či už na optickom, alebo impedančnom princípe. V našom laboratóriu používame za účelom zhodnotenia aktivačného stavu trombocytov aj vyšetrenie expresie aktivačných markerov pomocou prietokovej cytometrie.
Tabuľka č. 2: Diferenciálna diagnostika trombocytopatií na základe agregácie trombocytov (13)
Agregácia
Deficit PY2 receptora
adenozíndifosfát epinefrín kolagén ristocetín znížená zachovaná zachovaná zachovaná
Deficit adrenergných receptorov zachovaná znížená zachovaná zachovaná
Deficit kolagénového receptora zachovaná zachovaná znížená až absentujúca zachovaná
vWD, BS syndróm zachovaná zachovaná zachovaná znížená až absentujúca
Glanzmannova trombasténia znížená znížená znížená normálna alebo mierne znížená
Vysvetlivky:
BS syndróm – Bernardov-Soulierov syndróm vWD – von Willebrandova choroba (von Willebrand disease)
TÉMA ČÍSLA 88 inVitro
60 000 receptorov







Jedna krvná doštička má na svojom povrchu približne 60 000 receptorov glykoproteínového komplexu GPIIb/IIIa.
Agregometrické vyšetrenie Je zamerané na zhodnotenie prípadných odchýlok v procese agregácie trombocytov, či už v zmysle zvýšenej (hyperagregabilita trombocytov), alebo zníženej (hypoagregabilita trombocytov) agregačnej odpovede po ich stimulácii rôznymi typmi induktorov v presne stanovených koncentráciách.
Proces agregácie začína niekoľko minút po aktivácii a je výsledkom aktivácie receptora glykoproteínového komplexu GPIIb/IIIa, čo umožní väzbu s vWF alebo s fibrinogénom. (11) Jedna krvná doštička má na svojom povrchu približne 60 000 receptorov tohto typu. (12) Molekuly fibrinogénu a vWF slúžia ako mosty viažuce susedné trombocyty. Aktivovaný receptor GPIIb/ IIIa po väzbe fibrinogénu dokáže intracelulárnou signalizáciou aktivovať ďalšie receptory GPIIb/IIIa. GPIIa/IIIb dokáže taktiež ukotviť trombocyt k subendotelovému vWF za účelom vyššej stability. Vzhľadom na jasné a kľúčové postavenie GPIIb/IIIa v procese agregácie trombocytov predstavuje ovplyvnenie jeho aktivity mechanizmus účinku mnohých antiagregačných liekov.
V klinickej praxi sa najčastejšie používa optická agregometria, ktorej princípom je meranie vzostupu transmisie svetla vo vyšetrovanej
suspenzii trombocytov (v plazme bohatej na trombocyty) po pridaní exogénneho doštičkového induktora v závislosti od % agregovaných trombocytov. (14) Medzi najčastejšie používané induktory patria adenozíndifosfát, epinefrín, kolagén, kyselina arachidónová, trombín a ristocetín v presne stanovených koncentráciách.
Hypoagregabilita trombocytov sprevádza rôzne získané alebo vrodené stavy. Je spojená s krvácavými prejavmi, respektíve so zvýšeným rizikom krvácania. V prípade vrodených trombocytopatií, ktoré sú ale pomerne raritným nálezom, napríklad pri Bernardovom-Soulierovom (BS) syndróme s prevalenciou 1 prípad na 1 milión obyvateľov (13), je hypoagregabilita trombocytov trvalým nálezom a trombocyty vykazujú zníženú agregáciu v závislosti od konkrétneho vrodeného syndrómu – pre BS syndróm s deficitom glykoproteínového komplexu GPIb/V/IX je typická znížená až absentujúca agregácia po ristocetíne, pri Glanzmannovej trombasténii s deficitom glykoproteínového komplexu GPIIb/IIIa je signifikantne znížená agregácia po kolagéne, epinefríne aj po adenozíndifosfáte so zachovanou agregáciou po ristocetíne. Diferenciálna diagnostika vrodených trombocytopatií na základe výsledku agregometrického vyšetrenia je uvedená v Tabuľke č. 2.
Pri získanej trombocytopatii s hypoagregabilitou ide o dočasný nález a po odstránení vyvolávajúcej príčiny dochádza k úprave agregačnej odpovede. V klinickej praxi sa s hypoagregabilitou trombocytov stretávame najmä v teréne užívanej protidoštičkovej liečby, kde je žiadúcim fenoménom, ale vyskytuje sa aj ako následok užívanej analgetickej a protizápalovej liečby, pri myeloproliferatívnych ochoreniach, pri hepatopatii, monoklonálnych gamapatiách i pri systémových ochoreniach. (3)
Hyperagregabilita trombocytov je naopak charakterizovaná ako stav zvýšenej reaktivity trombocytov po ich stimulácii induktormi. Považuje sa za predispozíciu, rizikový faktor trombotických, najmä artériových komplikácií. Táto vlastnosť trombocytov, označovaná aj ako syndróm lepivých trombocytov/doštičiek (SPS), môže byť buď získaná (pri zápalových ochoreniach, po operáciách, pri hojení rán, pri hormonálnej nerovnováhe, v tehotenstve…), alebo sa môže vyskytovať na vrodenom podklade. Aj keď v súčasnosti ešte nepoznáme konkrétny gén alebo súbor génov, ktoré sú jednoznačne zodpovedné za vrodenú hyperagregabilitu trombocytov,
Náhle úmrtia Unilabs Slovensko 89
hereditárny pôvod je vysoko suspektný najmä v rodinách s podobným a pretrvávajúcim agregometrickým obrazom u viacerých jej členov pri súčasne zvýšenom výskyte trombotických komplikácií v týchto rodinách.
Vyšetrenie agregácie trombocytov je súčasťou skríningu trombofilného stavu realizovaného v hematologických ambulanciách. Hyperagregabilita je laboratórne definovaná ako zvýšená agregabilita krvných doštičiek in vitro v reakcii po stimulácii nízkymi koncentráciami ADP a/alebo epinefrínu. Agregácia po ostatných typoch induktorov ostáva fyziologická. (14) Pri diagnostike hyperagregability sa využíva ADP vo finálnych koncentráciách
2,34 µM, 1,17 µM a 0,58 µM. Epinefrín v koncetráciách 11 µM, 1,1 µM a 0,55 µM. Na základe výsledného percenta agregovaných trombocytov po jednotlivých typoch induktorov rozoznávame konkrétne podtypy syndrómu lepivých trombocytov.
Z hľadiska klinickej praxe má veľký význam monitoring účinnosti protidoštičkovej liečby. Vyšetrenie je indikované najmä u pacientov po recidivujúcich trombotických komplikáciách napriek antiagregačnej terapii – pacienti s recidivujúcimi tranzitórnymi ischemickými atakmi, ischemickými cievnymi mozgovými príhodami, s infarktmi myokardu či po trombotickom uzávere cievnych stentov v rôznych lokalizáciách. Najčastejšie sa v rámci sekundárnej prevencie artériových trombotických komplikácií používa ASA. Pri podozrení na tzv. aspirínovú rezistenciu sa agregometria po stimulácii kyselinou arachidónovou javí ako najvhodnejšia metóda stanovenia protidoštičkového účinku ASA. Za účinnú sa liečba považuje, ak dochádza k útlmu agregácie pod 25 %. (14) Pri liečbe pomocou tienopyridínov (klopidogrel, prasugrel, ticagrelor…) sa môže tiež vyskytnúť fenomén rezistencie. Pri podozrení na rezistenciu sa v tomto prípade vyšetruje stimulácia po ADP s prostaglandínom E1 v koncentrácii 10 mol/l. Za účinnú sa považuje inhibícia agregácie pod 45 %. (14)
Aktivácia trombocytov sa vyskytuje počas vývoja aterosklerózy, ako aj v čase formovania trombu pri akútnej manifestácii aterosklerotickej choroby.
Využitie imunofenotypového vyšetrenia na posúdenie aktivačného stavu trombocytov Na posúdenie imunofenotypových charakteristík buniek sa využíva prietoková cytometria (PC). Ide o techniku rýchlej analýzy špecifických charakteristík rôznych buniek pomocou merania ich veľkosti a granularity. Ponúka informácie o funkčnom stave trombocytov in vivo a vypovedá aj
TÉMA ČÍSLA 90 inVitro
Tabuľka č. 3: Veková charakteristika vyšetrovaných súborov
Vysvetlivky: N – počet členov v súbore SD – smerodajná odchýlka
o aktivačnom stave trombocytov, o trombopoéze, pomáha diagnostikovať špecifické ochorenia a taktiež monitorovať protidoštičkovú terapiu. (5, 15) Využíva optické a fluorescenčné fyzikálne princípy za účelom detekcie povrchových receptorov typických pre aktiváciu trombocytov, sekrečných molekúl a trombocytových, ako aj leukocyto-trombocytových agregátov. Základným princípom vyšetrenia je väzba fluorescenčne značenej protilátky na špecifický proteín na povrchu vyšetrovanej bunky alebo v jej cytoplazme. Laserový lúč prechádza pretekajúcou vzorkou a excituje na vyššiu energetickú úroveň na bunkách naviazané molekuly fluorescenčných farbív (fluorochrómov), ktoré pri spätnom prechode do neexcitovaného stavu emitujú svetelnú energiu rôznej vlnovej dĺžky. Použitie viacerých fluorochrómov, ktoré absorbujú svetlo podobnej vlnovej dĺžky, ale emitujú svetlo rozličnej vlnovej dĺžky, umožňuje simultánnu detekciu viacerých vyšetrovaných znakov. (5) Prietoková cytometria môže byť užitočná aj pri diagnostike už vyššie spomínaných vrodených (napríklad Bernardov-Soulierov syndróm, Glanzmannova trombasténia) alebo získaných dysfunkcií trombocytov (napríklad heparínom indukovaná trombocytopénia – HIT) a porúch sekrécie. Umožňuje analýzu aj v prípade nízkeho počtu doštičiek. (5) Taktiež umožňuje rozpoznať prokoagulačnú kapacitu a aktivačný stav trombocytov (pacienti s akútnym koronárnym syndrómom alebo extratelovým obehom). V rámci monitorovania účinnosti protidoštičkovej liečby tienopyridínmi sa najčastejšie hodnotí fosforylácia VASP (Vasodilator-stimulated protein). (5) V transfuziológii sa používa na zhodnotenie aktivovaného stavu trombocytov, ako aj na identifikáciu prípadnej kontaminácie trombocytových koncentrátov leukocytmi. (16)
CD antigény – Clusters of di erentiation Ide o rôzne povrchové alebo cytoplazmatické molekuly s rôznou funkciou, ktoré sú typické pre skúmanú bunku v určitom vývojovom
období, prípadne v určitom funkčnom stave. CD antigény môžu patriť medzi receptory alebo ligandy. Niektoré CD antigény nie sú zapojené do signalizačných dráh, môžu mať mnohé iné funkcie – napríklad sú dôležité pri adhézii buniek. Mnohé CD antigény sú predmetom výskumu, lebo predstavujú potenciálny terapeutický cieľ za účelom ovplyvnenia signalizačných dráh a správania bunky.
CD antigény typické pre trombocyty Expresia povrchových CD antigénov trombocytov sa líši v závislosti od stavu vyšetrovaného trombocytu. Povrchové CD antigény, ktoré sú prítomné na trombocytoch pred ich aktiváciou, sa považujú za špecifické doštičkové znaky a slúžia na identifikáciu populácie trombocytov vo vyšetrovanej vzorke. Za takéto diferenciačné znaky možno považovať antigény CD41, CD42, CD61, CD36.
Ako bolo uvedené vyššie, v procese aktivácie trombocytov dochádza na povrchu trombocytu k expresii mnohých špecifických CD antigénov, ktorá je často výsledkom uvoľnenia obsahu α-granúl trombocytov. Tieto znaky sa nenachádzajú na neaktivovaných trombocytoch, preto môžu slúžiť ako špecifický marker ich aktivácie. V našom laboratóriu využívame najmä detekciu antigénov CD63 (vyšetrovaný v koexpresii CD36/CD63), CD62P – P-selektínu, CD49b, CD31 a CD51. (19)
VASP
V rámci monitorovania účinnosti protidoštičkovej liečby tienopyridínmi sa najčastejšie hodnotí fosforylácia VASP (Vasodilator-stimulated protein).
Náhle úmrtia Unilabs Slovensko 91
N priemerný vek SD min. vek max. vek Kontrolný súbor 33 40,45 13,09 21 69 Pacientky s tehotenskými komplikáciami 50 33,4 7,63 22 58 Pacientky s trombotickými komplikáciami 50 46,76 11,95 19 71
Aktivácia trombocytov sa vyskytuje počas vývoja aterosklerózy, ako aj v čase formovania trombu pri akútnej manifestácii aterosklerotickej choroby. (20) Optimálne zhodnotenie aktivačného stavu trombocytov predstavuje výzvu, no znamená jednoznačný prínos z hľadiska identifikácie pacientov, ktorí sa nachádzajú v riziku ďalších kardiovaskulárnych príhod v budúcnosti. (20) Prietoková cytometria sledujúca expresiu molekúl typických pre aktiváciu trombocytov (P-selektín, CD63) alebo zmenu konformácie (GPIIb-IIIa) patrí medzi priame metódy sledujúce funkčné vlastnosti trombocytov. Nepriame vyšetrovacie metódy merajú ex vivo funkciu trombocytov s predpokladom rovnakého správania trombocytov in vivo (agregácia a adhézia a sekrečná odpoveď po aktivácii). Vykazujú však pomerne slabú koreláciu s priamymi vyšetrovacími metódami. (20) In vitro bola dokázaná asociácia medzi sekrečnou reakciou a uvoľnením mikropartikúl (MPs) z trombocytov (platelet-derived MPs – PMPs). (22) Počet cirkulujúcich PMPs odráža aktivačný status doštičiek in vivo, napríklad v prípade pacientov s chorobou periférnych artérií (21), s nestabilnou anginou pectoris, s infarktom myokardu, po cerebrovaskulárnych príhodách a s diabetom. (20) Ukazuje sa, že subpopulácie PMPs (exprimujúce P-selektín alebo CD63) môžu byť novým markerom aktivácie trombocytov in vivo. Funkčné poruchy trombocytov sa v dominantnej miere spájajú so vznikom artériovej trombózy. V prípade venózneho tromboembolizmu (VTE) a jeho patofyziológie zohráva úlohu najmä poškodenie endotelu, stáza krvi a navodený hyperkoagulačný stav.
Vyšetrenie agregácie trombocytov má, ako už bolo uvedené, jasne definované referenčné hodnoty a v prípade potvrdenia hyperagregability trombocytov následne (podľa klinických ťažkostí) pristupujeme k zahájeniu adekvátnej liečby, prípadne prevencie. Pri negatívnom výsledku agregometrie a pretrvávajúcich klinických ťažkostiach sme sa rozhodli pristúpiť k hodnoteniu aktivačného stavu trombocytov našich pacientov pomocou prietokovej cytometrie. Viedli nás k tomu výsledky analýzy parametrov získaných v populácii pacientov v našej hematologickej ambulancii. Keďže neexistuje jasne definované referenčné rozmedzie fyziologickej expresie antigénov, za kontrolný súbor sme si zvolili skupinu 33 žien bez klinických ťažkostí, ktoré boli v našej ambulancii vyšetrované len z dôvodu pozitívnej rodinnej anamnézy na výskyt trombotickej alebo tehotenskej komplikácie. Kontrolný súbor sme porovnávali s dvoma vyšetrovanými súbormi. Prvý tvorilo 50 pacientok
VTE – 17
tromboflebitídy – 32
CMP – 17
TIA – 2
migrény – 7
vask. encefalopatia, pokročilá ATS
trombóza VCR – 2
Graf č. 1: Spektrum pozorovaných trombotických komplikácií. ATS – ateroskleróza, CMP – cievna mozgová príhoda, TIA – tranzitórny ischemický atak, vask. – vaskulárna, VCR – vena centralis retinae, VTE – venózny tromboembolizmus
s tehotenskými komplikáciami, druhý 50 žien so suspektnými alebo evidentnými trombotickými komplikáciami. Charakteristiku jednotlivých súborov zobrazuje Tabuľka č. 3, spektrum trombotických komplikácií Graf č. 1.
Z vyššie uvedených vyšetrovaných a sledovaných trombocytových znakov sme sa zamerali na analýzu expresie CD62P (P-selektínu), ktorý sa uvoľňuje z α-granúl po aktivácii trombocytov a následnej degranulácii. Ako druhý parameter bola vyhodnocovaná koexpresia znakov CD36/ CD63 – CD36 ako konštitučný znak krvných doštičiek, znak CD63 ako prejav ich aktivácie. (2)
Výsledky štatistickej analýzy rozdielov v expresii CD62P medzi pacientkami s trombotickými a pacientkami s tehotenskými komplikáciami nedokázali štatisticky významné rozdiely (p = 0,124619).
Pozorujeme však štatisticky významné rozdiely v expresii CD62P medzi pacientkami s tehotenskými komplikáciami a kontrolným súborom (p < 0,001), ako aj medzi pacientkami s trombotickými komplikáciami a kontrolami (p < 0,001). (2)
TÉMA ČÍSLA 92 inVitro
Literatúra
Podobná situácia bola zaznamenaná aj pri analýze koexpresie CD36/CD63. Medzi dvoma sledovanými súbormi symptomatických pacientok nebol zachytený štatisticky významný rozdiel v sledovanom parametri (p = 0,202745). Naopak, rozdiely v koexpresii CD36/CD63 medzi asymtomatickými kontrolami a pacientkami s tehotenskými, ako aj s trombotickými komplikáciami boli štatisticky významné (p < 0,001). (2)
Vyššie uvedené vyšetrenia neboli realizované v čase akútnych trombotických komplikácií, ale až po ich preliečení. Takisto v prípade výskytu tehotenských komplikácií sa pristúpilo k analýze minimálne 3 mesiace po ich prekonaní. Prejavy pretrvávajúcej a signifikantne zvýšenej aktivácie trombocytov aj po tehotenstve/preliečení trombózy by mohli znamenať pretrvávajúce zvýšené riziko recidívy ťažkostí. Či by mohla zvýšená expresia TRAMS slúžiť ako prediktívny faktor ďalších následných tehotenských komplikácií u pacientok s pozitívnou gynekologickou anamnézou, alebo byť indikátorom tromboprofylaxie pri inak negatívnom výsledku
1. Michelson AD. et al. Platelets. Academic, 2013, 3rd Edition, s. 1398, ISBN: 9780123878380.
2. Jedináková Z. Expresia aktivačných markerov trombocytov pacientiek s tehotenskými a/alebo trombotickými komplikáciami. Špecializačná práca. Martin: Univerzita Komenského, 2020, s. 55
3. Sakalová A., Bátorová A., Mistrík M. et al. Klinická hematológia, Martin: Osveta, 2010, s. 295, ISBN 978-80-8063-324-0.
4. Briggs C, Bain BJ et al. Basic Haematological Techniques, Dacie and Lewis Practical Haematology (Twelfth Edition), 2017.
5. Paniccia R., Priora R., Liotta AA. Et al. Platelet function tests: a comparative review, Vasc Health Risk Manag. 2015; 11: 133-148.
6. Middeldorp S. Evidence-based approach to thrombophilia testing. J Thromb Thrombolysis 211; 31(3): 275-281.
7. Boekholdt SM, Kramer MH. Arterial thrombosis and the role of thrombophilia. Semin Thromb Hemost. 2007;33(6):588–596. doi: 10.1055/s-2007985755.
8. Bezemer ID, Meer FJ, Eikenboom JC, Rosendaal FR, Doggen CJ. The value of family history as a risk indicator for
skríningu trombofilného stavu, je zatiaľ v rovine špekulácií. (2) Môže byť ale nápomocnou informáciou pri zvažovaní predĺženej liečby HVT u rizikových pacientov, prípadne u antitrombotickej profylaxie v nasledujúcom tehotenstve.
Záver
Spomenuté laboratórne metódy predstavujú základné spektrum vyšetrovacích metód so zameraním na trombocyt, ktoré sú momentálne dostupné v rámci bežnej diagnostiky možných porúch hemostázy. Zmeny v niektorých parametroch odhaľujú závažnú funkčnú poruchu, niektoré zmeny sa považujú za predispozíciu, respektíve možný rizikový faktor trombotických komplikácií. V súčasnej dobe však pribúda veľa informácií o ďalších možných parametroch, ktoré by mohli zohrávať úlohu vo včasnej diagnostike, ako aj v prevencii trombotických komplikácií, preto možno očakávať, že sa toto spektrum vyšetrení bude stále viac a viac rozširovať s cieľom čo najadresnejšej liečby pre každého pacienta.
venous thrombosis. Arch Intern Med. 2008; 169(6): 610-615. doi: 10.1001/ archinternmed.2008.589.
9. Robertson L., Wu O., Langhorne P. et al. Thrombophilia in pregnancy: a systematic review. Br J Haematol. 2006; 132(2): 171-196. doi: 10.1111/j.13652141.2005.05847.
10. Kaandorp SP., Di Nisio M., Goddijn M. et al. Aspirin or anticoagulants for treating recurrent miscarriage in women without antiphospholipid syndrome. Cochrane Database Syst Rev 2009 (1): CD004734.
11. Yip J., Shen Y., Berndt MC., Andrews RK. et al. Primary platelet adhesion receptors. Life. 2005, 57 (2): 103-8. doi:10.1080/15216540500078962.
12. O'Halloran AM., Curtin R., O'Connor F. et al. The impact of genetic variation in the region of the GPIIIa gene, on Pl expression bias and GPIIb/IIIa receptor density in platelets. British Journal of Haematology 2006; 132 (4): 494-502. doi:10.1111/j.1365-2141.2005.05897.x.
13. https://en.wikipedia.org/wiki/Bernard–Soulier_syndrome
14. Škorňová I., S lavík L. et al. Hemostáza, P+M, 2020, s. 285, ISBN 978-80-8969478-5.
15. Michelson AD, Newburger PE et al. Platelets and leukocytes: aggregate knowledge. Blood, 2007; 110: 794-795.
16. Middelburg RA., Roest M., Ham J. et al. Flow cytometric assessment of agonist-induced P-selectin expression as a measure of platelet quality in stored platelet concentrates. Transfusion, 2013; 53: 1780-1787.
17. https://www.researchgate.net/figure/ Scanning-electron-micrographs-ofA-resting-37-C-and-B-temperatureactivated-20_fig7_6923881
18. https://imagebank.hematology.org
19. https://sinobiological.com
20. Van der Zee PM., Biró E., Ko Y. et al: P-selectin- and CD63-exposing platelet microparticles reflect platelet activation in peripheral arterial diseaseand myocardial infarction. Clinical Chemistry 2006; 52: 657-664.
21. Zeiger f., Stephan S., Hoheisel G. et al. P-selectin expression, platelet aggregates and platelet-derived microparticle formation are increased in peripheral arterial disease. Blood Coagul Fibrinolysis 2000; 11: 723-8.
22. Michielson AD., Barnard MR., Hechtman HB. et. al. In vivo tracking of platelets: circulating degranulated platelets rapidly lose surface P-selectin but continue to circulate and function. Proc Natl Acad Sci USA 1996; 93: 11877-82.
Náhle úmrtia Unilabs Slovensko 93
Akútne brucho ako príčina smrti pri náhlych








TÉMA ČÍSLA 94 inVitro
úmrtiach
MUDr. Arpád Panyko, PhD., MPH IV. Chirurgická klinika UNB a LF UK
Náhle brušné príhody (NPB) sú akútne, život ohrozujúce stavy. Po kardiovaskulárnych a respiračných ochoreniach sú jednou z najčastejších príčin náhlej, neočakávanej smrti. Včasné rozpoznanie náhlych brušných príhod
významne ovplyvňuje ďalší osud chorého. Príčiny bolesti brucha zahŕňajú široké klinické spektrum, môžu byť buď úrazové, alebo zápalové. Našim článkom chceme poukázať na diagnostické úskalia potenciálne fatálnych ochorení.
V anglosaskej literatúre sa pri špecifikácii bolesti často používa mnemotechnická pomôcka PQRST: P = Pain (lokalizácia), Q = Quality (kvalita), R = Radiation (propagácia), S = Severity (intenzita), T = Time (časové okolnosti).
môžu byť podobné ochoreniam iných orgánov nachádzajúcich sa v brušnej dutine, ale aj orgánov nachádzajúcich sa v hrudníku alebo retroperitoneu. Preto treba pri prvom podozrení na NPB postupovať tak, ako keby išlo skutočne o NPB. Lekár by mal pacienta s podozrením na NPB opakovane vyšetrovať a sledovať dynamiku ochorenia, aby sa predišlo nesprávnej diagnóze. Včasné rozpoznanie závažnosti bolesti brucha je pre chirurga kľúčovou úlohou a zvyčajne potrebné na to, aby sa predišlo fatálnym následkom. (3)
Úvod

Bolesti brucha patria k častým diagnózam v klinickej praxi a zaraďujeme sem široké spektrum klinických stavov. Náhle príhody brušné (NPB) sú akútne ochorenia brucha, ktoré sú charakteristické náhlym začiatkom, rýchlou progresiou a spravidla si vyžadujú neodkladný operačný výkon. Výskyt náhlych brušných príhod je asi 500 – 800 na 100 000 obyvateľov. (1) Na našej ambulancii urgentného príjmu sa v rokoch 1999 až 2008 zvýšil počet prípadov s bolesťami brucha o 30 %. Vyše 25 % z týchto pacientov následne potrebuje urgentnú chirurgickú intervenciu. (2) Určiť, či je NPB prítomná pomocou jediného vyšetrenia, môže byť v počiatočných štádiách ochorenia ťažké, pretože príznaky
Etiológia
NPB sa podľa spôsobu vzniku delí na traumatickú a netraumatickú. Medzi netraumatické
NPB patria zápalové, ileózne, krvácanie z gastrointestinálneho traktu (GIT), gynekologické a perioperačné. Traumatické NPB sa delia na perforáciu, krvácanie do brušnej dutiny a zmiešanú formu. (4) Hoci sú tieto ochorenia v porovnaní s inými stavmi menej častou príčinou náhlej smrti, v skutočnosti sú rovnako dôležité. Najčastejšou príčinou náhleho úmrtia je masívne krvácanie do brušnej dutiny alebo do gastrointestinálneho traktu, ako komplikácia vredovej choroby gastroduodena, ulceróznej kolitídy, divertikulitídy alebo ektopickej gravidity. Ďalšie príčiny sú uvedené v Tabuľke č. 2.

Náhle úmrtia Unilabs Slovensko 95
PQRST
Tabuľka č. 1: Rozdelenie operačných výkonov podľa urgentnosti (2)
Urgentnosť výkonu
Diagnózy


okamžitá operácia krvácanie do dutiny brušnej, brušná trauma, disekcia brušnej aneuryzmy
urgentná operácia – do 2 hodín perforácia dutého orgánu, difúzna peritonitída
včasná operácia – do 8 hodín mechanický ileus, akútna apendicitída
skorá operácia – do 48 hodín akútna cholecystitída, intraabdominálny absces
Klinický obraz
Klinický obraz náhlych brušných príhod závisí hlavne od príčiny ťažkostí. Dominujú nasledujúce príznaky: bolesť brucha, nauzea, vracanie, zástava vetrov a stolice. Príznaky sú spravidla veľmi príznačné, môžu však byť aj úplne diskrétne alebo niektoré môžu chýbať. Okrem bežných anamnestických údajov (osobná, lieková, alergická anamnéza, abúzy) nás vždy zaujíma špecifikácia subjektívnych ťažkostí. Zameriavame sa na bolesť, zvracanie, poruchu pasáže, ťažkosti s močením, gynekologické problémy a okolnosti vzniku problémov (synkopa, stravovacie návyky). V anglosaskej literatúre sa pri špecifikácii bolesti často používa mnemotechnická pomôcka PQRST: P = Pain (lokalizácia), Q = Quality (kvalita), R = Radiation (propagácia), S = Severity (intenzita), T = Time (časové okolnosti). (5) Zisťujeme lokalizáciu, charakter, nástup a intenzitu bolesti, prípadné úľavové alebo zhoršujúce faktory, atď.
Náhle brušné príhody sú najčastejšie charakterizované úpornými, silnými, náhle vzniknutými bolesťami, keď si pacient častokrát nevie nájsť úľavovú polohu. Povaha bolestí môže byť pri jednotlivých diagnózach rozdielna. Lokalizácia bolesti súvisí s jej etiológiou. Pokiaľ ide o bolesť viscerálnu, nie je pacient schopný ju presne lokalizovať. Viscerálna bolesť býva popisovaná ako tupá, neostro ohraničená. Bolesť somatická vychádza z postihnutého orgánu. Býva popisovaná ako ostrá a ohraničená a pacient býva schopný ju presne lokalizovať. Je spôsobená priamym dráždením peritonea zapáleným orgánom či patologickým obsahom v dutine brušnej (žalúdočná šťava, krv, stolica a pod.). Ďalej rozlišujeme bolesť prenesenú (typicky v ľavom ramene pri afekcii sleziny či pod pravou lopatkou pri akútnom zápale žlčníka). Náhle vzniknutá bolesť brucha z plného zdravia býva alarmujúcim príznakom. Mala by
nás upozorniť na závažnejší stav. Býva spojená s perforačnou alebo ischemickou etiológiou. S postupne nastupujúcou bolesťou sa stretávame u pacientov so zápalovými príhodami. Nie je výnimočné, že pacienti, ktorí majú zmenené vnímanie bolesti (napr. ovplyvnené chronickou analgetickou medikáciou), nie sú u perforačných príhod schopní špecifikovať náhle vzniknutú bolesť. Vnímanie intenzity bolesti je individuálne a nemusí mať súvislosť so závažnosťou stavu. V časovej osi je bolesť udávaná ako zhoršujúca sa, ustupujúca a kolikovitá. Niekedy môžeme pacienta so závažným stavom zastihnúť v období ustupujúcej bolesti, s následným výrazným zhoršením (typicky pri perforačných príhodách). Zatiaľ čo pri perforácii dominuje u pacienta perzistujúca bolesť, tak u pacientov s ischémiou steny čreva dochádza po
Zvýšená hladina sérovej amylázy alebo presnejšej lipázy potvrdzuje klinickú diagnózu akútnej pankreatitídy.
TÉMA ČÍSLA 96 inVitro
počiatočnej prudkej bolesti k rozvoju takmer „asymptomatického okna“, keď sa má pacient relatívne dobre a až následne nastupuje opätovný atak bolesti po rozvoji peritonitídy. Medzi ďalšie formy bolesti, ktorú pacienti opisujú, patrí postupne sa zhoršujúca bolesť. Tento stav je pozorovaný najmä pri zápalových ochoreniach – apendicitída, cholecystitída, divertikulitída, pankreatitída. Kolikovité bolesti je možné vidieť v počiatočných štádiách mechanického ilea, čo je podmienené peristaltikou. Táto forma bolesti je však charakteristická aj pre renálnu či biliárnu koliku.
Pri diagnostike je veľmi dôležité poznať celú anamnézu charakteru bolesti, od miesta vzniku, jej migrácie až po určenie kvality bolesti. Migrujúca bolesť je charakteristická pre zápalové ochorenia, keď po počiatočnej tupej viscerálnej bolesti dochádza postupne k progresii ochorenia a prestupu na peritoneum, čím vzniká parietálna bolesť. V tomto momente už vie pacient bolestivosť jasne lokalizovať a môže tak dôjsť k jej presunu z pôvodného miesta. (6)
Diagnostika
Náhle príhody brušné sú závažné stavy, ktoré majú veľmi rýchly priebeh a môžu pacienta ohroziť na živote, aj preto je kľúčové správne určenie diagnózy a včasná liečba. V diagnostickom algoritme je snaha postupovať tak, aby bola diagnostika čo najrýchlejšia, najjednoduchšia, ale zároveň kvalitná. Z diferenciálno-diagnostického hľadiska je vždy dôležité odlíšiť, či ide o organickú, alebo o funkčnú bolesť brucha. Počiatočné štádiá ochorenia je možné diagnostikovať oveľa skôr a ľahšie.
Pri diagnostike náhlej brušnej príhody sa opierame predovšetkým o anamnézu, ako aj o klinické vyšetrenie pacienta. Organickú príčinu bolesti by mohli napomôcť odhaliť niektoré varovné príznaky, ktoré môžeme nájsť už pri
U pacientov s ischémiou steny čreva dochádza po počiatočnej prudkej bolesti k rozvoju takmer „asymptomatického okna“, keď sa má pacient relatívne dobre a až následne nastupuje opätovný atak bolesti.
zisťovaní anamnézy, iné až pri fyzikálnom vyšetrení a hodnotení výsledkov laboratórnych vyšetrení. Už prvý kontakt s pacientom rozhoduje o vyhodnotení závažnosti stavu, ako aj o nastavení optimálneho manažmentu pacienta. (7) Cielená a podrobná anamnéza terajšieho ochorenia tvorí základ správne stanovenej diagnózy. Pri vyšetrení pacienta sa realizuje: pohľad, pohmat, poklop, posluch a vyšetrenie cez konečník. Pri pohľade sa môžu u pacienta už na prvý pohľad rozpoznať viaceré patologické stavy – bledý kolorit kože, ikterus, cyanóza, dyspnoe, schvátenosť atď. Pozornosť sa venuje jazvám, kožným prejavom, nafúknutiu brucha, šíreniu dýchacej vlny. Vyšetrovaním brucha pohmatom zisťujeme napätie brušnej steny, bolestivosť, rezistencie. Palpačné vyšetrenie sa začína na najvzdialenejšom mieste od miesta, ktoré určí pacient ako najviac bolestivé. Nesmie sa zabudnúť ani na predilekčné
Vrodené Získané
• obštrukcia duodéna
• defekt mezentéria
• Meckelov divertikul
• heterotopia žalúdka
• masívne gastrointestinálne krvácanie
• inkarcerované vnútorné hernie
• volvulus/zauzlenie čriev
• disekcia alebo ruptúra aneuryzmy abdominálnej aorty
• inkarcerovaná inguinálna hernia
• akútna dilatácia žalúdka
• trombóza AMS (arteria mesenterica superior)
• perforácia gastroduodenálnych vredov
Náhle úmrtia Unilabs Slovensko 97
Tabuľka č. 2: Najčastejšie príčiny náhlych úmrtí zo spektra chirurgických diagnóz (11)
miesta možných herniácií – tzv. herniové body. Vyšetrenie brucha poklopom je pri fyziologickom stave diferenciálne bubienkové (tympanické). Pri patologických procesoch sa rozlišujú akcentované tóny pri nahromadení vzduchu, alebo naopak pritlmené tóny nad výpotkom alebo solídnou hmotou. Bolesť pri poklope (Pléniesov znak) je jedna zo známok peritoneálneho dráždenia. Posluch musí byť vykonaný vo všetkých štyroch kvadrantoch brucha. Za normálnych okolností počujeme fyziologické zvuky črevnej peristaltiky. Pri usilovnej peristaltike sú tieto zvuky zosilnené, na druhej strane, v neskoršej fáze mechanického ilea pri unavenom čreve alebo pri peritonitíde dominuje v bruchu mŕtve ticho. Pri vyšetrení cez konečník sa hodnotí inšpekcia análnej oblasti, tonus zvierača, stena ampuly rekta, vyklenovanie Douglasovho priestoru. Taktiež sa môže nahmatať rezistencia do asi 8 cm, ako aj prostata u mužov. Obsah ampuly hodnotíme podľa stôp stolice na rukavici po ukončení vyšetrenia. Samotná anamnéza a fyzikálne vyšetrenie stačia na stanovenie diagnózy v dvoch tretinách prípadov.
Doplňujúce laboratórne a zobrazovacie vyšetrenia sú nevyhnutné na presnú diagnostiku a racionálne rozhodnutie o manažmente liečby. Dostupnosť a spoľahlivosť niektorých vyšetrovacích metód sa v rôznych nemocniciach líši. Pri ich výbere by sa mala zvážiť invazívnosť, riziko vyšetrenia a nákladová efektívnosť. Výsledky následne musíme interpretovať v klinickom kontexte každého prípadu. Liberálnejšie použitie diagnostických metód je opodstatnené u starších pacientov alebo u pacientov zo špeciálnej skupiny (napríklad imunodeficientní pacienti), u ktorých môžu byť anamnéza a fyzikálny nález menej spoľahlivé. (6)
Laboratórne vyšetrenia
Biochemické a hematologické vyšetrenie sú doplnkom dôkladného odberu anamnestických údajov a kompletného objektívneho vyšetrenia. Výsledky aj pri patologických hodnotách musia korelovať v kontexte s klinickým obrazom ochorenia. Súbežne s klinickým vyšetrením vykonávame hematologické a biochemické vyšetrenie krvi (KO, základné hemokoagulačné vyšetrenie, určenie krvnej skupiny, kreatinín, Na, K, Cl), chemické vyšetrenie moču. V prípade diferenciálnej diagnostiky ťažkostí doplníme základnú škálu laboratórnych vyšetrení stanovením „hepatálneho súboru“ v krvi, ABR alebo vyšetrením močového sedimentu. (8)
a) Hematologické vyšetrenia. Hemoglobín, hematokrit, počet bielych krviniek a diferenciálny krvný obraz odobratý pri prvotnom vyšetrení majú vysokú výpovednú hodnotu. Anémia svedčí pre možné krvné straty, taktiež pre chronickú anemizáciu pri nezistených malígnych tumoroch. Leukocytóza (> 13 000/µl) s posunom vľavo v diferenciálnom krvnom obraze, ako aj leukopénia (< 5 000/µl) sú príznakmi závažnej infekcie. Za predpokladu, že až 90 % všetkých náhlych brušných príhod je spôsobených zápalovými ochoreniami, ich senzitivita a špecificita sú pomerne nízke. Pri miernej leukocytóze bez progresie sledujeme dynamiku objektívneho nálezu, ale opatrnosť v hodnotení vyžadujú anergickí pacienti. Pri predpoklade chirurgickej intervencia vyšetrujeme krvnú skupinu a základné hemokoagulačné parametre (trombocyty, protrombínový čas, aPTT, fibrinogén). Platí to aj pre pacientov s antikoagulačnou liečbou. (8)
b) Biochemické vyšetrenie zohráva úlohu v hodnotení závažnosti a možnej lokalizácie chorobného stavu. Hladiny elektrolytov, ABR a kreatinínu sú dôležité pri rozvrate vnútorného prostredia v pokročilých štádiách ochorení a pri črevnej nepriechodnosti. Dôležité sú sérové elektrolyty, dusík močovina a kreatinín, najmä ak sa očakáva hypovolémia
TÉMA ČÍSLA 98 inVitro
Bolesť pri poklope (Pléniesov znak) je jedna zo známok peritoneálneho dráždenia.
(t. j. v dôsledku šoku, hojného vracania alebo hnačky alebo oneskoreného príchodu). Kreatinín sa považuje za nevyhnutný pred získaním rádiografického zobrazenia s jódovanými kontrastnými látkami kvôli možnému poškodeniu obličiek. Zvýšený laktát v krvi môže indikovať ischémiu čreva vzhľadom na koreláciu s anaeróbnym metabolizmom. Je však nešpecifický a môže byť zvýšený aj pri iných klinických situáciách, ako je napríklad dehydratácia, masívna strata krvi alebo zlyhanie pečene. Netušená metabolická acidóza môže byť prvou indíciou k závažnému ochoreniu. Zvýšená hladina sérovej amylázy alebo presnejšej lipázy potvrdzuje klinickú diagnózu akútnej pankreatitídy. Mierne zvýšené hodnoty amylázy sa musia interpretovať opatrne, pretože abnormálne hladiny často sprevádzajú ischemické črevo, torziu ovariálnej cysty, perforovaný vred alebo zápaly príušnej žľazy. Lipáza je špecifickejšia pre pankreatitídu. (9) U pacientov s podozrením na hepatobiliárne ochorenie sú dôležité funkčné testy pečene (bilirubín, alkalická fosfatáza, aspartátaminotransferáza, alanínaminotransferáza, albumín), ktoré sú užitočné pre diferenciálnu diagnostiku porúch pečene a na posúdenie závažnosti základného ochorenia.

c) Vyšetrenie moču sa vykonáva ľahko a môže odhaliť užitočné informácie. Orientačné vyšetrenie kvantitatívnej diurézy, mernej hmotnosti moču a orientačné semikvantitatívne chemické vyšetrenie zhodnotí stav dehydratácie a možnosti nechirurgickej príčiny abdominálnych bolestí. Tmavý moč alebo zvýšená špecifická hmotnosť odrážajú miernu dehydratáciu u pacientov s normálnou funkciou obličiek. Hyperbilirubinémia môže spôsobiť tmavo sfarbený moč. Mikroskopická hematúria alebo pyúria môžu potvrdiť renálnu koliku alebo infekciu močových ciest.
d) Vyšetrenie stolice má svoj význam pri makroskopickej prítomnosti krvi formou melény a hematochézie, pri profúznych hnačkách je vhodné mikrobiologické vyšetrenie na vylúčenie infekčného pôvodu ťažkostí. Podľa niektorých odporúčaných postupov by sa malo rutinne vykonávať aj vyšetrenie stolice na okultné krvácanie. Pozitívny test poukazuje na slizničnú léziu, ktorá môže byť zodpovedná za obštrukciu hrubého čreva alebo chronickú anémiu pri nádorovom ochorení.
e) Krvácanie z tráviaceho traktu nie je bežným znakom akútneho brucha. Metóda rotačnej tromboelastometrie (ROTEM) je v súčasnosti čoraz viac a s obľubou používaná v manažmente krvácania. Ako ,,bed-side“ test v určitom zmysle nahrádza bežné koagulačné testy v tejto situácii s tým, že umožňuje poskytovať cielenú liečbu koagulopatie, vedie k zníženiu podávania transfúznych prípravkov a k zníženiu krvácania.
f) Zápalová NPB je charakterizovaná zvýšenými hladinami zápalových markerov (C-reaktívny proteín, prokalcitonín, interleukín-6). Viaceré štúdie potvrdili aj prognostický význam neutrofil-lymfocytového pomeru (NLR) alebo delta-neutrofilového indexu (DNI). (10)
g) Genetické faktory – existujú dôkazy o dedičnosti polygénnych znakov, ktoré predisponujú k náhlemu úmrtiu. Dedičné arteriopatie, ako sú Marfanov syndróm, Loeysov-Dietzov syndróm a Ehlersov-Danlosov syndróm, predisponujú k náhlemu úmrtiu prostredníctvom katastrofickej ruptúry veľkých ciev. (11)
Náhle úmrtia Unilabs Slovensko 99
Obrázok č. 1: Natívna snímka brucha u pacienta s pneumoperitoneom pri perforovanej divertikulitíde (archív autora)
Zobrazovacie vyšetrenia
Výpovedná hodnota anamnézy, fyzikálneho a laboratórneho vyšetrenia nie je na určenie správnej diagnózy vždy dostačujúca. Zobrazovacie vyšetrenia sú doplnkom pri určení diagnózy a sú indikované podľa individuálneho zváženia. Ich správna indikácia minimalizuje časovú stratu v manažmente pacienta. V rámci diagnostiky pacienta sa začína jednoduchšími a dostupnými vyšetreniami, za predpokladu zmysluplnosti ich vykonania. V závislosti od klinického stavu a predchádzajúcich vyšetrení sa najčastejšie používa: RTG vyšetrenie brucha, abdominálna ultrasonografia alebo počítačová tomografia. Dôležitým faktorom je však aj skúsenosť posudzujúceho rádiológa. (7)
RTG vyšetrenie brucha patrí medzi štandardné vyšetrenia, ktoré je vykonávané v stoji alebo v ľahu horizontálnym lúčom. Voľný vzduch pod bránicovými klenbami je príznakom perforácie dutého orgánu. Sledujeme taktiež prítomnosť hladiniek črevných kľučiek, na základe ktorých môžeme bližšie určiť miesto predpokladanej mechanickej prekážky alebo zistiť prejavy poruchy črevnej pasáže. Často treba doplniť aj RTG hrudníka, napríklad na vylúčenie bazálnej pneumónie imitujúcej akútnu cholecystitídu. Pri nejasnom náleze je možné vykonať vyšetrenie pomocou kontrastnej látky, keď je únik do voľnej dutiny prejavom perforácie dutého orgánu. (6)
Sonografické vyšetrenie dutiny brušnej patrí medzi rutinné vyšetrenia pri bolestiach dutiny brušnej. Pomocou tejto zobrazovacej modality je možné identifikovať priame známky zápalového ochorenia dutiny brušnej, alebo sa môže nepriamo poukázať na prebiehajúci patologický proces, a to poukázaním na voľnú tekutinu. Výhodou vyšetrenia je vysoká senzitivita (90 %), ľahká dostupnosť, vyšetrenie je pritom ekonomicky a radiačne nezaťažujúce. (12)
Počítačová tomografia (CT) sa realizuje pri nejasnom náleze predchádzajúcich vyšetrení. Medzi nevýhody vyšetrenia patrí radiačné zaťaženie pacienta, naopak výhodou je rýchle vyhodnotenie väčšej časti dutiny brušnej bez ohľadu na hmotnosť pacienta. Iné vyšetrovacie postupy – či už zobrazovacie, alebo endoskopické vyšetrenia – sú závislé od ich dostupnosti, ako aj od stavu pacienta. (13) V rámci diagnosticko-terapeutického postupu môžeme využiť RTG pasáž tráviacim traktom (najmä u pacientov s obštrukciou tráviaceho traktu spôsobenou funkčne) alebo rádiointervenčný výkon (angiografia a. mesenterica
sup. so zavedením stentu pri mezenteriálnej ischémii). V rámci diagnostiky akútneho brucha sa využívajú aj ďalšie metódy, ako napríklad endoskopia, laparoskopia a diagnostická peritoneálna laváž. Magnetická rezonancia sa pri diagnostike náhlej brušnej príhody (NPB) nevyužíva. (6)
Diferenciálna diagnostika
V rámci diferenciálnej diagnostiky a nastavenia správnej liečby pacienta treba oddiferencovať iné extraabdominálne príčiny, ktoré môžu byť charakterizované veľmi podobnou symptomatológiou, napríklad: bazálna pneumónia, pleuritída, pneumotorax, infarkt myokardu, disekujúca aneuryzma aorty, pyelonefritída, ureterolitiáza, perinefritický absces, endokrinologické a metabolické ochorenia (urémia, hyperglykémia, addisonská kríza, akútna intermitentná porfýria alebo akútna hypelipoproteinémia), hematologické ochorenia (akútna leukémia, kosáčikovitá anémia) môžu imitovať náhlu bolesť brucha, intoxikácie (otrava olovom a ťažkými kovmi, abstinenčný

TÉMA ČÍSLA 100 inVitro
Obrázok č. 2: Masívna dilatácia žalúdka ako príčina náhlej brušnej príhody (archív autora)
syndróm z narkotík), infekčné a zápalové ochorenia (tabes dorsalis, herpes zoster, akútna reumatická horúčka, Henochova-Schönleinova purpura, systémový lupus erythematosus, polyarteritis nodosa).
Diagnostika je komplikovanejšia u pacientov, ktorí chronicky užívajú kortikosteroidy alebo NSAID, pretože tieto lieky sťažujú klinické vyšetrenie absenciou príznakov peritoneálneho dráždenia. Preto sa u týchto pacientov musíme viac spoliehať na paraklinické metódy. Pacienti užívajúci betablokátory nereagujú tachykardiou ako súčasťou systémovej zápalovej odpovede. Geriatrickí pacienti, obézni pacienti alebo ženy vo fertilnom veku predstavujú špeciálne skupiny pacientov s často atypickou symptomatológiou. Ak klinický nález nekorešponduje so silnou bolesťou, mali by sme myslieť na mezenteriálnu ischémiu, ruptúru aneuryzmy brušnej aorty alebo torziu ovariálnej cysty. Okrem pacientov s akútnou pankreatitídou môžeme nájsť zvýšenú sérovú amylázu u pacientov s akútnou cholecystitídou, perforáciou peptického vredu alebo mezenterickou ischémiou. Hematóm prednej brušnej steny či ťažká gastroenteritída môžu imitovať náhlu brušnú príhodu. (7)
Záver
Akútne bolesti brucha liečime podľa ich vyvolávajúcej príčiny po stanovení diagnózy ochorenia. Morbidita i mortalita závisia nielen od rozsahu základného ochorenia, pridružených ochorení a veku, ale aj od rýchlosti a správnosti ošetrenia. Každý pacient s podozrením na náhlu brušnú príhodu má byť vyšetrený chirurgom. Rýchla diagnostika a včasné rozhodnutie o terapeutických opatreniach sú nevyhnutné pre zníženie morbidity a mortality.
90 %
90 % všetkých náhlych brušných príhod je spôsobených zápalovými ochoreniami.
4. Falch C, Vicente D, Haberle H, Kirschniak A, Muller S, Nissan A, et al. Treatment of acute abdominal pain in the emergency room: a systematic review of the literature. Eur J Pain. 2014;18(7):902-13.
5. Schildberg CW, Skibbe J, Croner R, Schellerer V, Hohenberger W, Horbach T. [Rational diagnostics of acute abdomen]. Chirurg. 2010;81(11):1013-9.
6. Dye T. The acute abdomen: a surgeon's approach to diagnosis and treatment. Clin Tech Small Anim Pract. 2003;18(1):53-65.
7. Noll M, Kim M. [The acute abdomen. From ambulance to the emergency room]. MMW Fortschr Med. 2023;165(2):40-3.
8. Panebianco NL, Jahnes K, Mills AM. Imaging and laboratory testing in acute abdominal pain. Emerg Med Clin North Am. 2011;29(2):175-93, vii.
9. Barbieri JS, Riggio JM, Jaffe R. Amylase testing for abdominal pain and suspected acute pancreatitis. J Hosp Med. 2016;11(5):366-8.
10. Kang HS, Cha YS, Park KH, Hwang SO. Delta neutrophil index as a promising prognostic marker of emergent surgical intervention for acute diverticulitis in the emergency department. PLoS One. 2017;12(11):e0187629.
Literatúra
1. Cervellin G, Mora R, Ticinesi A, Meschi T, Comelli I, Catena F, et al. Epidemiology and outcomes of acute abdominal pain in a large urban Emergency Department: retrospective analysis of 5,340 cases. Ann Transl Med. 2016;4(19):362.
2. de Burlet KJ, Ing AJ, Larsen PD, Dennett ER. Systematic review of diagnostic pathways for patients presenting with acute abdominal pain. Int J Qual Health Care. 2018;30(9):678-83.
3. Minten L, Messiaen P, Van der Hilst J. Acute abdominal pain: a challenging diagnosis. Acta Gastroenterol Belg. 2022;85(4):646-7.
11. Menezes RG, Ahmed S, Pasha SB, Hussain SA, Fatima H, Kharoshah MA, et al. Gastrointestinal causes of sudden unexpected death: A review. Med Sci Law. 2018;58(1):5-15.
12. Eiberg JP, Grantcharov TP, Eriksen JR, Boel T, Buhl C, Jensen D, et al. Ultrasound of the acute abdomen performed by surgeons in training. Minerva Chir. 2008;63(1):17-22.
13. Wybranski C, Pech M, Fischbach K. [What does the visceral surgeon need to know about computed tomography in the diagnostic work-up of the acute abdomen?]. Zentralbl Chir. 2015;140(1):38-46.
Náhle úmrtia Unilabs Slovensko 101
Intoxikácia etylénglykolom




Etylénglykol je obľúbenou zložkou do chladiacich zmesí. Vďaka svojej sladkej chuti je zneužívaný ako aditívum. Relatívne často však dochádza aj k jeho neúmyselnej konzumácii. Otravy sú

pomerne časté, keď deti alebo zvieratá skonzumujú veľké množstvá. Bolo dokázané, že pre človeka aj pre zvieratá sú jeho
metabolity toxické. Pokiaľ sa vykoná včasná liečba, prognóza je vo všeobecnosti dobrá a väčšina pacientov sa úplne zotaví.




TÉMA ČÍSLA 102 inVitro
MUDr. Ivo Topoľský, PhD., MPH Klinika pre deti a dorast A. Getlíka, LF SZU a UN Bratislava
Charakteristika
Etylénglykol alebo etán-1,2-diol (monoetylénglykol, MEG) patrí do skupiny glykolov so sumárnym vzorcom C2H4(OH)2. Je to bezfarebná, takmer neprchavá látka aromatickej vône a trpkosladkej chuti. Kvapalina je rozpustná vo vode a vo väčšine organických rozpúšťadiel. Pri zmiešaní s vodou vzniká exotermická reakcia. Má vynikajúci prenos tepla a ochráni pred mrazom. Najčastejšie sa používa ako nemrznúca zmes do motorových vozidiel, v klimatizačných systémoch, v geotermálnych systémoch vykurovania/chladenia. V plastovom priemysle je etylénglykol dôležitým prekurzorom polyesterových vláken a živíc. Ďalej sa používa do náterov, detergentov, do pracích prostriedkov a v kozmetickom priemysle, na výrobu sklenených vláken, pri výrobe atramentu a rozpúšťadiel na plasty, pri výrobe kondenzátorov.
Čistý etylénglykol zamŕza pri teplote približne −12 °C, ale po zmiešaní s vodou zmes zamŕza pri nižšej teplote, napríklad zmes 60 % etylénglykolu a 40 % vody zamrzne pri −45 °C. Podobne sa správa aj dietylénglykol, ktorý má dve hydroxylové skupiny, a preto má silnejšie redukčné účinky než etanol.
C2H4(OH)2












Etylénglykol alebo etán-1,2-diol patrí do skupiny glykolov so sumárnym vzorcom C2H4(OH)2 Je to bezfarebná, takmer neprchavá aromatická látka s trpkosladkou chuťou.
Toxická dávka, ktorá vyžaduje lekárske ošetrenie, sa líši podľa vnímavosti jedinca, ale všeobecne sa uvádza viac než 0,1 ml/kg čistého etylénglykolu. Pri požití 50 % roztoku je to pre dospelého človeka s hmotnosťou 80 kg približne 16 ml a 4 ml pre dieťa s hmotnosťou 20 kg. Smrteľná dávka sa u ľudí uvádza približne 1,4 ml/kg čistého etylénglykolu. V prepočte 224 ml 50 % etylénglykolu pre 80kg dospelého a 56 ml pre 20kg dieťa. Orientačná dávka, ktorá už vyžaduje posúdenie lekára, je viac než jedno oliznutie alebo ochutnanie u dieťaťa a viac ako jedno sústo v ústach u dospelého.
V roku 2015 Plačková a kol. publikovali 263 dopytov na Národné toxikologické informačné centrum ohľadom intoxikácie etylénglykolom, ktoré zahŕňali 113 hospitalizovaných pacientov počas 10-ročnej periódy, z ktorých 12 (10,6 %) zomrelo. Priemerný vek bol 46 rokov, prevažovali muži (62 %). Podľa PSS (Poison Severity Score) bolo 19 z 21 prípadov s akútnym poškodením obličiek na úrovni závažnej intoxikácie. Terapia etanolom bola použitá v 76 %, hemodialýza v 95 % prípadov. Fomepizol sa použil len v jednom prípade u závažnej intoxikácie 16-ročného chlapca.
Náhle úmrtia Unilabs Slovensko 103
História
Produkcia etylénglykolu začala v roku 1856. Francúzsky chemik Charles Adolphe Wurtz nazval vzniknutú zlúčeninu glykol, pretože mala podobné vlastnosti ako etanol (1 hydroxylová skupina) a glycerol (3 hydroxylové skupiny). Priemyselnú výrobu odštartovala 1. svetová vojna, kde sa glykol používal ako náhrada glycerolu pre výbušniny. Etylénglykol má pri požití pomerne vysokú toxicitu pre cicavce, približne rovnakú ako metanol, s orálnou LDLo = 786 mg/kg pre človeka (100 – 150 ml roztoku, 1 – 2 ml/kg 100% etylénglykolu). Hlavné nebezpečenstvo je spôsobené jeho sladkou chuťou, ktorá môže priťahovať deti a zvieratá.
V 30. rokoch sa postupne objavujú prvé správy (kazuistiky) o intoxikáciách, v 40. rokoch aj skupinové otravy, najmä vo vojenských jednotkách. V 80. rokoch bol publikovaný prípad o 36 pacientoch vo Švédsku, z ktorých 6 zomrelo. V tom čase bola tiež veľmi „známa“ tzv. Fridexová aféra v Rakúsku, kde výrobcovia vína „vylepšovali“ jeho chuť pridávaním Fridexu. Veľa milovníkov vína bolo intoxikovaných a objavili sa aj fatálne prípady. V roku 2022 zomrelo niekoľko stoviek detí v Indonézii a v Gambii, pretože paracetamolový sirup obsahoval etylénglykol a dietylénglykol, teda zložky spojené s akútnym poškodením obličiek. V decembri 2022 ministerstvo zdravotníctva Uzbekistanu informovalo o úmrtiach detí v dôsledku výskytu etylénglykolu v sirupe proti kašľu. Pomerne časté sú náhodné otravy motoristov, ktorí uskladňujú nespotrebovanú nemrznúcu zmes do pivových fliaš v chladničke.
Intoxikácia vzniká najčastejšie požitím. Inhalácia vo všeobecnosti nebýva spojená s toxicitou, ale boli opísané prípady chronickej otravy spojené s nystagmom a záchvatmi dezorientácie u pracujúcich vystavených výparom etylénglykolu a inhalácii zohriatych nemrznúcich zmesí.
viac než 0,1 ml/kg
Toxická dávka, ktorá vyžaduje lekárske ošetrenie, sa všeobecne uvádza viac než 0,1 ml/kg čistého etylénglykolu.
Pomerne časté sú náhodné otravy motoristov, ktorí uskladňujú nespotrebovanú nemrznúcu zmes do pivových fliaš v chladničke.
V rámci prevencie intoxikácií sa vyrábajú nemrznúce zmesi na použitie v automobiloch, ktoré obsahujú propylénglykol namiesto etylénglykolu. Ich používanie sa vo všeobecnosti považuje za bezpečnejšie, pretože propylénglykol nie je taký chutný a v tele sa mení na kyselinu mliečnu, normálny produkt metabolizmu a fyzickej námahy. V niektorých štátoch (Austrália, Spojené kráľovstvo a sedemnásť štátov USA) sa od roku 2012 vyžaduje pridávanie horkej arómy (denatonium benzoát) do nemrznúcich zmesí.
Farmakokinetika
Etylénglykol rýchlo metabolizuje a jeho metabolity, najmä kyselina glykolová a kyselina šťavelová, sú extrémne toxické. Metabolizuje sa predovšetkým v pečeni, ale čiastočne aj v obličkách a jeho metabolizmus nie je úplne objasnený. Po požití sa rýchlo absorbuje (vrcholové koncentrácie v plazme dosahuje po 1 – 4 hodinách). Približne 75 % sa metabolizuje pomocou pečeňovej alkoholdehydrogenázy na glykoaldehyd, ktorý ihneď oxiduje cez glyoxalát a na glykolát (kyselinu glykolovú). Reakcia sa ukazuje ako veľmi pomalá a vedie k hromadeniu glykolátu, čo je čiastočne zodpovedné za metabolickú acidózu. Premena glyoxalátu cez kyselinu glyoxalovú na kyselinu šťavelovú (oxalát) je relatívne rýchla. Kryštály oxalátu vápenatého sa objavujú v moči len 1 – 2 hodiny po požití etylénglykolu. Kyselina glyoxalová sa aj cez glycín premieňa na kyselinu benzóovú a ďalej na kyselinu hippurovú, ktorá môže byť zodpovedná za hippurátové kryštály (Obrázok č. 1).
TÉMA ČÍSLA 104 inVitro
moč
4-metylparyzol
glykoaldehyd
glykolát (kyselina glykolová)
CH2 – C – CH3 OH O
CH2 – CH2
OH OH
alkoholdehydrogenáza (môže byť blokovaná etanolem)
CH2 – CH
OH O
laktát dehydrogenáza
laktát
laktátová acidóza
kyselina mravčia oxalomalát
aldehydoxidáza
glyoxalát (glyoxal)
CH – CH O O
γ-hydroxy-α-ketoglutarát
kyselina glyoxalová
CH – C – OH O O
oxalát (kyselina šťavelová)
HO – C – C – OH O O
kalciumoxalát
hypokalciémia
moč
tkanivové depozity
Obrázok č. 1: Metabolizmus etylénglykolu (podľa Sey art, 1997)
glycín
CH – C – OH
+CO2 + CO2
NH2 O
vysoká aniónová medzera
metabolická acidóza
kyselina benzóová
kyselina hippurová
hippurátové kryštály?
Náhle úmrtia Unilabs Slovensko 105
etylénglykol
Plazmatický polčas rozpadu etylénglykolu je 3 hodiny, neviaže sa na bielkoviny. Približne 25 % etylénglykolu sa objaví v moči v nezmenenom stave a asi 2,3 % ako oxalát. Exkrécia/ vylučovanie oxalátu závisí od obličkových funkcií a redukuje sa v súvislosti so znížením glomerulovej filtrácie, vtedy sa začnú formovať tubulárne depozity kalcium oxalátu.
Metabolity najprv napadnú centrálny nervový systém, potom srdce a napokon obličky.
Diagnóza
Klinické príznaky a symptómy otravy etylénglykolom sú nešpecifické a vyskytujú sa pri mnohých otravách, diagnóza je často zložitá. Intoxikáciu etylénglykolom môžeme predpokladať u osôb, ktoré vyzerajú ako v ebriete, ale nemajú typický alkoholový foetor z úst, respektíve u ktorých sa vyskytne závažná acidóza nejasnej etiológie a poruchy vedomia. Priame vyšetrenie koncentrácie etylénglykolu v plazme často nebýva dostupné. Kalcium oxalátové kryštály môžeme nájsť v moči veľmi skoro po intoxikácii, neskôr prichádza mikroskopická hematúria, oligúria, proteinúria.
Významným nálezom býva závažná metabolická acidóza s pH < 7,0, bikarbonáty < 8 mmol/l a veľká aniónová medzera. Medzi nešpecifické nálezy patrí leukocytóza až do 40 000/mm3 a hypokalciémia zapríčinená cheláciou kalcium oxalátu v mnohých orgánoch, ktorá niekedy môže viesť k tetanii a srdcovej dysfunkcii.
Z extrémnych laboratórnych výsledkov z dopytov na Národné toxikologické informačné
1 – 2 hodiny
Kryštály oxalátu vápenatého sa objavujú v moči len 1 – 2 hodiny po požití etylénglykolu.
centrum: najnižšie pH krvi bolo 6,68, sérový bikarbonát 1,4 mmol/l, kreatinín 1 126 µmol/l, aniónová medzera 45,2 mmol/l a kálium 7,4.
Klasické príznaky intoxikácie etylénglykolom
Príznaky otravy sa prejavujú v troch krokoch, ktoré sa začínajú intoxikáciou a zvracaním, potom spôsobujú metabolickú acidózu, kardiovaskulárnu dysfunkciu a nakoniec akútne zlyhanie obličiek.
Laboratórne nálezy
1. závažná metabolická acidóza s aniónovou medzerou
2. zvýšená osmolálna medzera
3. postihnutie obličiek
4. oxalátová (zriedkavejšie hippurátová) kryštalúria
Tabuľka č. 1: Jednotlivé štádiá intoxikácie etylénglykolom
Fáza Postihnutie orgánu Čas po požití Príznaky
1. neurologická manifestácia (+ acidóza)
2. kardiopulmonálna manifestácia (+ acidóza)
3. obličková manifestácia (+ acidóza)
30 min. – 12 hod. Podobné príznaky ako pri intoxikácii alkoholom. Nauzea, vomitus, ataxia, stupor, hypotermia, kŕče, kóma, nystagmus, o almoplégia, utlmené reflexy a tetanické kontrakcie. Je tu koincidencia s najvyššími koncentráciami aldehydov v krvi.
12 – 24 hod. Dyspnoe, tachypnoe, hyperventilácia, cyanóza, pľúcny edém, tachykardia, mierna hypertenzia, kongestívne zlyhanie srdca. Môže pretrvávať alterácia CNS.
24 – 72 hod. Oligúria, anúria, oxalátová kryštálúria, urémia.
TÉMA ČÍSLA 106 inVitro
Nebezpečnosť etylénglykolu spočíva v rýchlej premene na toxické metabolity (glykolaldehydy), ktoré inhibujú glykolýzu, Krebsov cyklus trikarboxylových kyselín, oxidatívnu fosforyláciu a proteosyntézu. Ovplyvňujú metabolizmus sérotonínu a menia hladinu amínu v mozgu. Aldehydy tiež prispievajú k cerebrálnej dráždivosti. Oxaláty zapríčiňujú zlyhanie obličiek (intersticiálny edém, dilatácia proximálnych aj distálnych tubulov), metabolickú acidózu, hypokalciémiu a aj cerebrálne podráždenie. Laktát, ktorý je produkovaný jednak priamo etylénglykolom a tiež ako výsledok poškodeného metabolizmu pyruvátu (kvôli produkcii aldehydov), prehlbuje acidózu. Hromadí sa tiež pri respiračnom a kardiálnom zlyhaní. Jeho koncentrácia sa môže zvyšovať aj pri podávaní etanolu, ktorý sa metabolizuje cez pyruvát.
Záver
Osud pacienta závisí od rýchlosti podania adekvátnej liečby, ktorá musí byť komplexná. Prvotná je stabilizácia vitálnych funkcií. Odstránenie etylénglykolu zo zažívacieho traktu je možné len veľmi skoro po intoxikácii. Nápomocné je dostatočné zavodnenie organizmu a potlačenie účinku alkoholdehydrogenázy, najčastejšie etanolom, na princípe kompetitívnej inhibície. Podobný účinok má aj antidotum Fomepizol, jeho použitím sa môžeme vyhnúť podávaniu etanolu u detí. Pacient profituje z hemodialýzy, ktorá odstraňuje toxíny vznikajúce pri akútnom poškodení obličiek, ale predovšetkým pomáha korigovať závažnú metabolickú acidózu. Použitie pomocných látok (infúzie s obsahom vápnika, podávanie vitamínov – pyridoxín, tiamín, kyselina listová) urýchľujú premenu kyseliny glyoxalovej na netoxické metabolity. Po zvládnutí akútnej fázy závisí osud pacienta od závažnosti poškodenia obličiek a od ich následného zotavenia, avšak aj u najťažších intoxikácií etylénglykolom dochádza k úprave ich funkcií ad integrum. Predpokladom pre tento priaznivý vývoj je včasné zachytenie a riešenie všetkých komplikácií v priebehu otravy a adekvátna reakcia počas liečebného postupu.
Literatúra
1. Beaulieu, J., Roberts, D. M., Gosselin, S., Hoffman, R. S., Lavergne, V., Hovda, K. E., Megarbane, B., Lung, D., Thanacoody, R., Ghannoum, M. (2022) Treating ethylene glycol poisoning with alcohol dehydrogenase inhibition, but without extracorporeal treatments: a systematic review, Clinical Toxicology, 60:7, 784-797, DOI: 10.1080/15563650.2022.2049810
2. Ghannoum, M., Gosselin, S., Hoffman, R. S. et al. (2023) Extracorporeal treatment for ethylene glycol poisoning: systematic review and recommendations from the EXTRIP workgroup. Crit Care 27, 56 (2023). https://doi.org/10.1186/ s13054-022-04227-2
3. Křenová M., Pelclová D. 2006. Complete Recovery after Repeated Suicidal Ethylene Glycol Ingestion. Prague Medical Report Vol. 107 (2006) No. 1, p. 13-136
4. Krifta, P.: Etylenglykol. 2011. In: Akutní intoxikace a léková poškození v intenzivní medicíně. Grada Publishing, Praha, 2011, 2. vydání. s. 135-138. ISBN 978-80-247-3146-9
5. Mydlík, M., Derzsiová, K., Mizla, P. et al. 2002. Diagnostika a liečba otravy etylénglykolom – rozbor 20 chorých. Vnitř Lék 2002; 48 (11): 1054-1059.
6. Plačková, S., Cagáňová, B., Faltánova, P., Lipták, T., Otrubová, O., Kresánek, J. 2015. XXXV International Congress of the European Association of Poisons Centres and Clinical Toxicologists (EAPCCT) 26-29 May 2015, St Julian's, Malta, Clinical Toxicology, 53:4, 233403, DOI: 10.3109/15563650.2015.1024953 To link to this article: http://dx.doi.org/10.3109/155 63650.2015.1024953
7. Racek J., Petříková V., Rajdl D., Novák I. 2017. Otrava etylenglykolem a falešně vysoká hladina laktátu. Klin. Biochem. Metab., 25 (46), 2017, No. 1, p. 32-35. https://www.cskb.cz/wp-content/ uploads/2019/10/KBM-2017-1-Racek-32.pdf
8. Šagát, T. Etylénglykol. 2019. In: Šagát, T., Šašinka, M., Kovács, L., Bánovčin, P., Kuchta, M. a kol. Pediatria. Herba, Bratislava, 2019. 3. Vydanie. s. 1516. ISBN 978–80–89631–90-2
9. Seyffart, G. 1997. Ethylene glycol. In: Poison index : the treatment of acute intoxication. 4th ed. Pabst Science Publishers, Lengerich, 1997. p. 318-331. ISBN 3-931660-46-X
Náhle úmrtia Unilabs Slovensko 107
Smrtiace plyny







TÉMA ČÍSLA 108 inVitro
MUDr. Marek Brenišin, PhD. Ústav patologickej fyziológie LF UPJŠ, Košice Univerzita Pavla Jozefa Šafárika v Košiciach
Toxické plyny predstavujú významný
zdroj otráv v domácnosti aj v priemyselnej výrobe. V súčasnosti sa už aj na Slovensku zvyšuje povedomie o nebezpečenstve niektorých plynov, napríklad oxidu uhoľnatého v domácnostiach. Keďže mnohé z plynov uvedených v tomto článku sú látky bez farby a zápachu, môžu pri nebadanom úniku veľmi rýchlo spôsobiť ťažkú až smrteľnú otravu.
Úvod
Toxické a smrtiace plyny sa môžu vyskytnúť ako v domácnosti, tak aj pri bežných prácach, napríklad oprava motorky v garáži, ale aj v priemyselnej výrobe. Na Slovensku je pomerne významným zdrojom otráv najmä oxid uhoľnatý, ktorý podľa udávaných štatistík zabije ročne asi 150 ľudí, čo je 2,75/100 000 (Dobiáš, 2007). Pre porovnanie, v Japonsku zodpovedá až za 5 000 úmrtí ročne = 3,98/100 000, čo predstavuje až polovicu všetkých otráv (Kinoshita a kol., 2020). V Európskej únii predstavuje počet úmrtí 2,2/100 000 obyvateľov ročne, čo je veľký problém. Len pre porovnanie, na HIV/AIDS umrie ročne 2,0/100 000 obyvateľov, na rakovinu kože 2,1/100 000 obyvateľov a na následky konzumácie alkoholu 2,6/100 000 obyvateľov (Braubach a kol., 2013).
K ostatným významným intoxikáciám plynmi v domácnostiach dochádza najmä neodborným a svojpomocným spaľovaním odpadov, keď sa pri nízkych teplotách uvoľňujú rôzne škodlivé plyny, najmä z plastov, napríklad propylén (Park a Lee, 2021), styrén a vinylchlorid, čo sú plyny s narkotickým účinkom, pôsobiace negatívne na krvný obeh (nj.gov).
Najnebezpečnejšie je spaľovanie práve PVC, kde pri vysokých teplotách vzniká kyselina chlorovodíková spôsobujúca chemické poleptanie pokožky a dýchacích ciest (Xia a kol., 2021). Presné čísla je ťažké odhadnúť, keďže z obavy postihu zo strany orgánov činných v trestnom konaní sa dotyční túto činnosť snažia utajiť. V prípade oxidu uhličitého sú dostupné najmä staršie štatistiky zo sveta, napríklad v USA sa udáva priemerne 89 úmrtí ročne (Permentier a kol., 2017).
150 ľudí
Na Slovensku je pomerne významným zdrojom otráv najmä oxid uhoľnatý, ktorý podľa štatistík zabije ročne asi 150 ľudí.
V priemysle sú najvýznamnejšie úniky rôznych pomocných látok pri organickej syntéze ako napríklad arzín, chlorid a fluorid boritý, diazometán, diborán, plynný fluór, chlór, kyselina kyanovodíková či fosgén (Poonguzhali a kol., 2022). Mnohé z týchto látok sú bezfarebné, niektoré bez zápachu, iné naopak možno cítiť pri prekročení prahovej koncentrácie (napríklad chlorid boritý či fosgén). Rovnako rizikové sú výroby polovodičov, kde sa tieto zlúčeniny používajú, napríklad arzín, v súčasnosti sú ale úniky a otravy pomerne zriedkavé (Kuivenhoven, Mason, 2022).
Náhle úmrtia Unilabs Slovensko 109
Otrava oxidom uhoľnatým
• zmätenosť +
• bolesti hlavy+
• dezorientácia++
• poruchy vedomia+++
• kóma!
• poruchy zraku++
• svalové kŕče++
• svalová slabosť ++
• višňovočervená venózna krv
• ružové sfarbenie pokožky+
• poruchy rytmu srdca+++
• zhoršenie existujúcichchorÔb+++
• nauzea +
Obrázok č. 1: Porovnanie príznakov otravy oxidom uhličitým a oxidom uhoľnatým. Ako už napovedá schéma, mnohé príznaky sú veľmi podobné pri oboch plynoch, ich manifestácia závisí od koncentrácie CO-Hb v krvi pacienta, respektíve CO2 vo vdychovanom vzduchu. Najmä pri otrave oxidom uhoľnatým je potrebná obozretnosť, keďže príznaky v miernej forme otravy pripomínajú chrípku.
Otravy smrtiacimi plynmi Oxid uhoľnatý
Ide o plyn bez farby a zápachu, vzniká nedokonalým spaľovaním látok obsahujúcich uhlík. Je o niečo ľahší ako vzduch – špecifická hustota 0,97 kg/m3 (Kinoshita a kol., 2021), pričom v domácnostiach sú najnebezpečnejšie najmä rôzne piecky, kotle na ohrev vody (Aoshima a kol., 2021) či práca v uzavretej miestnosti, napríklad v garáži pri zapnutom spaľovacom motore. Štatisticky sa najviac ľudí priotrávi pri práci s otvoreným ohňom (asi 44 %), významnú skupinu ale tvoria aj priemyselné nehody či nesprávne nainštalované piecky a kotle (spolu asi 45 %), pričom otravy výfukovými plynmi sú pomerne zriedkavé (len asi 4 % prípadov) (Reumuth a kol., 2019), keďže obsah CO vo výfukových plynoch dosahuje len asi 0,01 – 0,06 %, avšak až takmer 88 % otráv CO výfukovými plynmi má suicidálny charakter (Kinoshita a kol., 2021).
Otrava oxidom uhličitým
• stav podobný opitosti*
• mierny útlm**
• zmätenosť ***
• bolesti hlavy***
• závraty***
• bezvedomie!
• porucha sluchu**
• výpadky zraku!
• potenie**
• červené sfarbenie pokožky**
• svalový tremor!
• tmavočervená venózna krv
• tachykardia**
• vzostup krvného tlaku**
• dušnosť **
Vysvetlivky: Koncentrácia CO-Hb vo vzduchu: + < 10 %
++ 10 – 30 %
+++ 30 – 50 %
! > 50 %
Koncentrácia CO2 vo vzduchu:
* asi 1 – 3 %
** 3 – 5 %
*** 5 – 8 %
! > 8 %
(upravené podľa viacerých autorov)
Oxid uhoľnatý sa viaže na hemoglobín kovalentnou väzbou, ktorá je asi 240-násobne silnejšia než donorno-akceptórna väzba kyslíka na atóm železa (Reumuth a kol., 2019). Blokovaná krv tak nedokáže prenášať kyslík, pričom charakteristicky je sfarbená do višňovočervenej až hnedočervenej, podľa farby karboxyhemoglobínu (Tabasum a kol., 2022). O niečo menej známy je aj fakt, že CO priamo blokuje cytochróm-c-oxidázu, čo môže mať za následok neskoršie priame poškodenie tkanív a zanecháva chronické následky (Kinoshita a kol., 2021). Najhoršie dopady sú badateľné na myokarde, kde okrem ischémie môžu vznikať arytmie, čo vedie k poklesu krvného tlaku a vzácne aj k vzniku trombov (Reumuth a kol., 2019). Z klinického hľadiska je pomerne zaujímavé aj neurologické poškodenie, ktoré sa akútne prejavuje nešpecificky nauzeou,
TÉMA ČÍSLA 110 inVitro
zvracaním, slabosťou (obsah CO-Hb v krvi menej ako 10 – 30 %), zatiaľ čo špecificky agitáciou, zmenami psychiky a motorickou paralýzou (CO-Hb 30 – 50 %), pričom hodnoty CO-Hb nad 50 % sú už život ohrozujúce a často vedú k opuchu mozgu a strate vedomia, ktorá končí smrťou (Kinoshita a kol., 2021) (Obrázok č. 1).
Vzácne popísané prípady hovoria o neurologických následkoch v podobe paréz a plégií, pričom sa predpokladá kombinácia akútnej a chronickej toxicity CO (Aoshima a kol., 2021). Treba si uvedomiť, že pri obsahu 0,01 % CO vo vzduchu môže poľahky dôjsť k nasýteniu až 44 % všetkého hemoglobínu v priebehu pár minút.
Diagnóza sa stanovuje použitím pulzného oxymetra a priamym meraním z kapilárnej krvi. Keďže CO-Hb absorbuje svetlo podobne ako oxyhemoglobín, vypočítava sa jeho koncentrácia ako rozdiel saturácie krvi nameranej oxymetrom a hodnotami z kapilárnej krvi (Dobiáš, 2007).
Oxid uhličitý Ide o bezfarebný plyn, bez zápachu a jemne kyslastej chuti, jeho špecifická hustota je vyššia než hustota vzduchu (Langford, 2005).
Spontánne vzniká pri dokonalom horení v prírode, pri procese kvasenia – jeho zvýšené koncentrácie nachádzame teda vo vínnych pivniciach, ale aj v jaskyniach a baniach (Dobiáš, 2007). Takisto je využívaný v potravinárstve na výrobu bublinkových nápojov, v priemysle ako chladiarenský plyn (Permentier a kol., 2017),
prípadne môžu intoxikácie vzniknúť aj pri používaní suchého ľadu v uzavretom priestore (Gonzales, Sakhamuri a Teelucksingh, 2017).
Oxid uhličitý pôsobí na telo nielen vyvolaním asfyxie, ale má aj priamy toxický efekt (Langford, 2005). Pri koncentráciách 2 – 5 % CO2 vo vdychovanom vzduchu dochádza k hyperventilácii, avšak v tomto prípade s rozvojom respiračnej acidózy, keďže zvyšujúca sa koncentrácia oxidu uhličitého má stimulačný efekt na dýchanie, po prekročení určitej hranice však naopak činnosť dychového centra utlmuje (predpokladá sa interferencia s rozkladom acetylcholínu vedúca k zvýšenej aktivite parasympatika). Koncentrácie nad 10 % vedú ku konvulziám, kóme a k smrti v priebehu niekoľkých minút. Ak stúpne koncentrácia oxidu uhličitého nad 30 %, obeť umiera v priebehu niekoľkých sekúnd na okamžitú zástavu dýchania (Permentier a kol., 2017) (Obrázok č. 1).
Oxid uhličitý má toxický efekt aj priamo na krvný obeh, kde prostredníctvom generalizovanej vazodilatácie (prejaví sa ružovým až červeným sfarbením pokožky) vedie k rapídnemu poklesu krvného tlaku na periférii a k zvýšenému intrakraniálnemu tlaku, čo vedie k útlmu činnosti CNS. Ako rozhodujúci faktor sa ukazuje priamy efekt oxidu uhličitého na zvýšenie aktivity enzýmu cyklooxygenáza 1 (COX-1) a nadprodukciu prostaglandínu E2 (PGE2), ktorá vedie vedie ku generalizovanej vazodilatácii v mozgovej cirkulácii (Howarth a kol., 2017).
Oxid uhoľnatý sa viaže na hemoglobín kovalentnou väzbou, ktorá je asi 240-násobne silnejšia než donorno-akceptórna väzba kyslíka na atóm železa.
Diagnostika je založená na meraní krvných plynov z arteriálnej krvi, pri neodbornej manipulácii so suchým ľadom sa na pokožke obete nachádzajú popáleniny. Bol zaznamenaný zvláštny prípad použitia suchého ľadu za suicidálnym účelom v uzavretej miestnosti, kde po jeho sublimácii došlo k rýchlemu navýšeniu koncentrácie CO2 v okolitom vzduchu. Je potrebná opatrnosť, keďže mnohé symptómy môžu byť pripisované iným príčinám – napríklad u staršej osoby, ktorá otvorila kontajner so suchým ľadom v aute, by mohli vyvrátené oči nahor imitovať neurologickú príčinu, zatiaľ čo elevácia troponínu akútny kardiálny syndróm (Gonzales, Sakhamuri a Teelucksingh, 2017).
K najvýznamnejšej nehode v našich končinách došlo v roku 1976 pri úniku oxidu uhličitého ako chladiaceho plynu použitého v experimentálnom reaktore KS150 v jadrovej elektrárni v Jaslovských Bohuniciach. Napriek prvotným správam o bezproblémovom incidente boli neskôr potvrdené dve obete (INES).
Náhle úmrtia Unilabs Slovensko 111
Chlór









Chlór je plyn žltozelenej farby, ktorý neskôr na vzduchu bledne. Má štipľavý zápach a je ťažší než vzduch. Hoci bol pôvodne používaný ako bojový plyn (pri meste Ypres v roku 1915 ho použili nemeckí ženisti, asi 5 000 obetí na strane Dohody), v súčasnosti má svoje využitie najmä ako dezinfekčný plyn (Achanta a Jord, 2017).
Expozícia väčšinou nastáva v domácnosti pri zmiešaní chlórového bielidla s iným čistiacim prostriedkom, napríklad na toalety. Štatistiky udávajú 6 300 – 6 500 expozícií hlásených v USA za rok 2017 (Howard a kol., 2007). Z priemyselných havárií stojí za zmienku vykoľajenie vlaku prevážajúceho chlór v roku 2005 v Graniteville, USA, kde po uvoľnení asi 60 ton do okolia bolo usmrtených 9 osôb a vyše 500 muselo vyhľadať lekársku pomoc (Zellner, Eyer, 2020).






Po styku s vodou reaguje chlór s vodíkom za vzniku kyseliny chlorovodíkovej, ktorá rýchlo preniká biologickými membránami (Morim, Guldner, 2022). Plynný chlór je ale asi 33-krát reaktívnejší, nešpecificky oxiduje membrány a môže viesť dokonca k alterácii DNA. Najčastejšie sú zasiahnuté dýchacie cesty – najmä horné, keďže dolné dýchacie cesty absorbujú asi len 5 % plynného chlóru. Dochádza k podráždeniu slizníc, najnebezpečnejšie je akútne poškodenie pľúc a akútny respiračný distress syndróm (ARDS) (Zellner, Eyer, 2020). Účinky sa líšia od koncentrácie, pri koncentrácii 1 – 3 ppm pôsobí chlór dráždivo na oči a sliznice, pri 15 ppm môže dôjsť k poškodeniu pľúc, fatálnym sa stáva pri koncentrácii asi 430 ppm, keď dochádza k smrti do 30 minút od začiatku expozície (Morim, Guldner, 2022).
Fosgén
Fosgén (oxychlorid uhličitý, chlorid karbonylu) (COCl2) je bezfarebný plyn ťažší než vzduch, typicky páchne ako vlhké seno. Prvýkrát bol použitý ako bojová látka v roku 1915 Nemeckým cisárstvom pri obrane Varšavy, neskôr sa ho pokúsili použiť aj na západnom fronte, tam už ale po predošlom útoku chlórom boli britské jednotky opatrnejšie a včas nasadili plynové masky. Napriek tomu ale zodpovedal za väčšinu úmrtí po útokoch bojovými plynmi, keďže fosgén a jeho deriváty (difosgén a trifosgén) mali tendenciu hromadiť sa v nižšie položených miestach, napríklad v zákopoch. V súčasnosti sa používa hojne v priemysle, a to najmä pri výrobe farbív.


Plynný chlór je asi 33-krát reaktívnejší, nešpecificky oxiduje membrány a môže viesť dokonca k alterácii DNA.

Fosgén je lipofilný, čo uľahčuje jeho vstrebávanie v pľúcach (Pauluhn, 2021). Na rozdiel od plynného chlóru je nebezpečná najmä jeho oneskorená toxicita, keďže spôsobuje hromadenie tekutiny a proteínov v interstíciu. Po 1 – 2 dňoch po expozícii sa rozvíja pľúcny edém, ktorý po približne 2 – 3 týždňoch vedie k obštrukčnej bronchiolitíde.
Vystavenie sa účinkom plynu v trvaní asi 30 minút: pri koncentrácii 5 ppm dochádza k poškodeniu pľúc, pri koncentrácii 17 ppm a viac sa stáva smrteľným, pacient umiera na rýchlo sa rozvíjajúci ARDS (Hobson, Richieri a Parseghian, 2021).
Oxidy dusíka
Oxidy dusíka predstavujú plyny – oxid dusný (N2O), oxid dusnatý (NO) a oxid dusičitý (NO2).

Až na posledný sú to bezfarebné plyny, bez chuti a zápachu, oxid dusičitý je hrdzavohnedý plyn štipľavého zápachu. Oxidy dusíka sa rozpúšťajú vo vode, chemickou reakciou vzniká zmes kyselín, ktoré v ľudskom organizme spôsobujú vznik nitrátov a nitridov, ktoré ničia krvné častice. Postihnutý upadne do bezvedomia (mladyzachranar.sk).
Ich najvýznamnejším zdrojom sú výfukové plyny a priemyselné exhaláty, pričom oxid dusný sa rýchlo mení na oxid dusičitý pri prístupe vzdušného kyslíka, takže toxicita oxidov dusíka je vymedzená hlavne pôsobením NO2 (Amaducci, Downs, 2022).
TÉMA ČÍSLA 112 inVitro
Akútne intoxikácie sú pomerne zriedkavé, opäť ide hlavne o suicidálne účely, pričom NO2 priamo zvyšuje toxicitu CO vo výfukových exhalátoch. Jeho pôsobenie je najmä chronického charakteru, keďže je významnou súčasťou skleníkových plynov.
Oxid dusný (N2O), triviálnym názvom rajský plyn, sa používa na krátkodobú anestéziu najmä v zubnom lekárstve, pri miernych otravách má efekt na zmeny psychiky, dlhodobo je nebezpečný z hľadiska poškodenia centrálnej nervovej sústavy (van Amsterdam, Nabben, van den Brink, 2022).
Oxid dusnatý a dusičitý sú pomerne silné oxidačné činidlá. Pôsobia jednak na pľúca, kde dlhodobé pôsobenie subletálnych dávok vedie k obštrukčnej bronchiolitíde a zvyšovaniu rezistencie pľúcnej cirkulácie, pri vyšších koncentráciách až k edému pľúc a smrti udusením. Poškodenie ešte akcentuje premena oxidov dusíka na reaktívne formy dusíka a kyslíka, ktoré zhoršujú prebiehajúce poškodenie (Ciampi a kol., 2022). Druhým významným mechanizmom je pôsobenie NO a NO2 na hemoglobín, ktorý oxidujú na methemoglobín, a to oxidáciou hémového železa z Fe2+ na Fe3+ Táto zmena vedie aj k zvýšenej afinite zvyšných jednotiek hému ku kyslíku, čím sa zhoršuje dodávka kyslíka tkanivám. Najviac ohrozené sú dojčatá, u ktorých enzým methemoglobínreduktáza ešte dozrieva a nedokáže zmenený hemoglobín odbúravať dostatočne efektívne. Otrava sa často prejaví až niekoľko hodín po expozícii, toxická pneumónia a obštrukčná bronchiolitída sa rozvíjajú pri koncentráciách 25 – 100 ppm, pričom letálne sú koncentrácie nad 150 ppm (Amaducci, Downs, 2022).
Oxid dusný (N2O), známy ako rajský plyn, sa používa na krátkodobú anestéziu najmä v zubnom lekárstve, dlhodobo ale poškodzuje centrálnu nervovú sústavu.
Oxid dusný sa dlhodobo považoval za pomerne neškodný plyn, objavili sa ale prípady jeho použitia za suicidálnym účelom zdravotníckymi pracovníkmi, v poslednej dobe navyše narastá jeho zneužívanie mladými ľuďmi za účelom eufórie, pričom sa ukazuje, že dlhodobá expozícia zvýšeným koncentráciám oxidu dusnatého má negatívny dopad na CNS a spôsobuje jej ireverzibilné poškodenie (Chadly a kol., 1989, van Amsterdam, Nabben, van den Brink, 2022).
Diagnostika sa opiera o röntgenový nález (biele opacity) a stanovenie koncentrácie methemoglobínu v krvi.
Amoniak, fenoly, kyanidy, propylén, dioxíny (spaľovanie odpadu)
Pri spaľovaní odpadu v domácnostiach neprebieha – v dôsledku nízkej teploty – rozklad látok správne, a tak môžu vznikať rôzne dráždivé plyny s negatívnym dopadom na ľudské zdravie. Okrem amoniaku, fenolov a kyanidov unikajú aj rôzne dioxíny, najmä tetrachlórdibenzodioxín, ktorý je v súčasnosti považovaný za jeden z najsilnejších syntetických jedov. Ich nebezpečenstvom je najmä chronická toxicita a rozvoj nádorov (Mierzwiński a kol., 2019; Häfner, Hochheim, Bredow, 2020).
Pri spaľovaní plastov sa uvoľňujú monoméry – etylén, propylén a styrén, ktoré majú vo vyšších koncentráciách narkotické účinky a v minulosti boli za týmto účelom používané až do objavu dokonalejších anestetík (Papari, Bamdad, Berruti, 2021). Najnebezpečnejším je ale vinylchlorid, ktorý sa uvoľňuje aj pri spaľovaní pri vysokých teplotách v spaľovniach. Preto je v súčasnosti tlak na upustenie výroby plastov z PVC (Damayanti, 2022). Presné štatistiky nie sú známe, keďže na Slovensku je spaľovanie odpadu v domácnostiach ilegálne.
Náhle úmrtia Unilabs Slovensko 113
N
2O
Plyny použité pri organickej syntéze a výrobe polovodičov
Pomerne veľa plynov sa využíva aj pri organickej syntéze a pri výrobe polovodičov. V tomto prípade však ide o zriedkavé, výsostne industriálne expozície. Zatiaľ čo o niektorých sme už písali vyššie (napríklad chlór, podobné príznaky vykazuje aj plynný fluór či fosgén), nebezpečné sú aj plynné formy halogénov a prvkov V.A skupiny (Periodickej sústavy prvkov – As, N, P, Sb, Bi), najmä arzénu.
Bór – chlorid a fluorid boritý sú plyny bez farby a štipľavého zápachu. Pri styku so vzdušnou vlhkosťou vytvárajú biele pary, pôsobením vody v slizniciach sa uvoľňuje chlorovodík a dochádza k poleptaniu slizníc.
Arzán (AsH3), arzín, zastarale arzenovodík, je bezfarebný plyn, 2,5-násobne ťažší než vzduch, bez zápachu, pri koncentrácii vyššej než 0,5 ppm môže byť cítiť ako cesnak. Predstavuje najťažšiu formu intoxikácie zlúčeninami arzénu, je toxickejší než samotný arzén (Mir, Vaishampayan, Dhawan, 2022). Pri expozícii sa rýchlo vyvíja pneumónia a pľúcny edém, bohato infiltrovaný polymorfonukleármi. Hoci je jeho cesta vstupu do tela hlavne inhalačná, boli popísané prípady otravy aj kontaktom s pokožkou. V krvnom riečisku navyše spôsobuje hemolýzu erytrocytov, čo zhoršuje jeho priebeh. Pri chronickej expozícii preto predstavuje najväčšie nebezpečenstvo obličkové zlyhanie (Obrázok č. 2), v minulosti so stopercentnou mortalitou, dnes sa mnohých pacientov darí zachrániť vďaka hemodialýze (Muza ar a kol., 2022, NRS).
Ide o jeden z najtoxickejších plynov, koncentrácie viac ako 10 ppm sú smrteľné pri dlhodobej expozícii, viac ako 25 ppm spôsobuje smrť
Obrázok č. 2: Hemolýza spôsobená expozíciou arzínu. Naľavo je vak so zmrazenou plazmou od zdravého pacienta, zatiaľ čo napravo je čierno sfarbená plazma pacienta otráveného arzínom. Bez hemodialýzy je tento stav prakticky smrteľný, väčšina pacientov umiera na akútne obličkové zlyhanie (Ibrahim a kol., 2006).
do 30 – 60 minút a pri koncentráciách nad 250 ppm nastáva smrť okamžite v dôsledku náhleho zlyhania srdca (Mir, Vaishampayan, Dhawan, 2022). V priemysle je používaný najmä pri výrobe LED diód.
Záver
Expozície toxickými plynmi sú, boli a bohužiaľ aj budú stálou súčasťou urgentnej medicíny a medicíny katastrof. Popri klasických otravách oxidom uhoľnatým a uhličitým, či neúmyselnej expozícii chlóru pri nesprávnom použití čistiacich prostriedkov, tu ale narastá hrozba expozície toxickými a supertoxickými plynmi, akým je napríklad spomínaný arzín, keďže nároky na výrobu polovodičov a diód budú zrejme narastať. Zmierňovanie následkov tak spočíva najmä v dôslednej prevencii, identifikácii príčiny otravy a vo včasnom terapeutickom zásahu.
NO 2

TÉMA ČÍSLA 114 inVitro
NO2 priamo zvyšuje toxicitu CO vo výfukových exhalátoch.
Literatúra
1. Achanta S, Jordt SE. Toxic effects of chlorine gas and potential treatments: a literature review. Toxicol Mech Methods 2021, 31, 244-256.
2. Amaducci A, Downs JW. Nitrogen Dioxide Toxicity. StatPearls 2022, dostupné online na https://www.ncbi.nlm.nih.gov/books/ NBK554539/
3. Aoshima K, Yamaoka H, Nakamura S et al. Right Hemiplegia Following Acute Carbon Monoxide Poisoning. Cureus 2021, 13, e16738.
4. Braubach M, Algoet A, Beaton M et al. Mortality associated with exposure to carbon monoxide in WHO European Member States, Indoor Air 2013, 23, 115-125.
5. Chadly A, Marc B, Barres D et al. Suicide by nitrous oxide poisoning. Am J Forensic Med Pathol 1989, 10, 330-1.
6. Ciampi Q, Russo A, D’Alise C et al. Nitrogen dioxide component of air pollution increases pulmonary congestion assessed by lung ultrasound in patients with chronic coronary syndromes. Environ Sci Pollut Res Int 2022, 29, 26960-26968.
7. Damayanti D, Saputri DR, Sumanto Marpaung DS et al. Current Prospects for Plastic Waste Treatment. Polymers (Basel) 2022, 14, 3133.
8. Dobiáš V. REPETITÓRIUM URGENTNEJ MEDICÍNY Intoxikácia oxidom uhoľnatým a oxidom uhličitým. Viac Pract 2007, 9, 422-423.
9. Gonzales L, Sakhamuri S, Teelukcsingh S. Dry ice (solid carbon dioxide) exposure with disastrous consequences. QJM 2017, 110, 757-758.
10. Häfner M, Hochheim M, Bredow T. Chemistry with F Centers: Reduction of Organic Molecules on the Defective Potassium Chloride(100) Surface. J Phys Chem C 2020, 124, 12606–12616.
11. Hobson ST, Richieri RA, Parseghian MH. Phosgene: toxicology, animal models, and medical countermeasures. Toxicol Mech Methods 2021, 31, 293-307.
12. Howard C, Ducre B, Burda AM et al. Management of chlorine gas exposure. J Emerg Nurs 2007, 33, 402-404.
13. Howarth C, Sutherland B, Choi HB et al. A Critical Role for Astrocytes in Hypercapnic Vasodilation in Brain. J Neurosci 2017, 37, 2403-2414.
14. http://www.mladyzachranar.sk/Default. aspx?CatID=310
15. Ibrahim D, Froberg B, Wolf A et al. Heavy Metal Poisoning: Clinical Presentations and Pathophysiology. Clin Lab Med 2006, 26, 67-97.
16. Kinoshita H, Türkan H, Vucinic S et al. Carbon monoxide poisoning. Toxicol Rep 2020, 7, 169-173.
17. "The International Nuclear and Radiological Event Scale," International Atomic Energy Agency, 08-26941/E, 2008.
18. Kuivenhoven M, Mason K. Arsenic Toxicity. StatPearls. 2022, 31082169.
19. Langford NJ. Carbon Dioxide Poisoning. Toxicol Rev 2005, 24, 229-235
20. Mierzwiński D, Łach D, Mikuła J et al. Utilization of innovative system for coke oven wastewater treatment as an element of stabilization technology for post-process waste from municipal incineration plants. IOP Conf Ser: Mater Sci Eng 2019, 706, 012018.
21. Mir S, Vaishampayan A, Dhawan N. A Review on Recycling of End-ofLife Light-Emitting Diodes for Metal Recovery. JOM 2022, 74, 599-611.
22. Morim A, Guldner GT. Chlorine Gas Toxicity. [Updated 2022 Jun 27]. StatPearls 2022, dostupné na https://www.ncbi.nlm.nih.gov/books/ NBK537213/
23. Muzaffar S, Khan J, Srivastava R et al. Mechanistic understanding of the toxic effects of arsenic and warfare arsenicals on human health and environment. Cell Biol Toxicol (2022). doi: https://doi. org/10.1007/s10565-022-09710-8.
24. National Research Council (US) Subcommittee on Acute Exposure Guideline Levels. Acute Exposure Guideline Levels for Selected Airborne Chemicals: Volume 1. Washington (DC): National Academies Press (US); 2000. 2, Arsine Acute Exposure Guideline Levels. Dostupné na: https://www.ncbi.nlm.nih. gov/books/NBK222407/ [2023-02-14]
25. New Jersey Department of Health: Hazardous Substance Fact Sheet –Propylene: dostupné online na https:// nj.gov/health/eoh/rtkweb/documents/ fs/1609.pdf [2023-02-13]
26. Papari S, Bamdad H, Berruti F. Pyrolytic Conversion of Plastic Waste to ValueAdded Products and Fuels: A Review. Materials (Basel) 2021, 14, 2586.
27. Park C, Lee J. Pyrolysis of polypropylene for production of fuelrange products: Effect of molecular weight of polypropylene. Int J Energy Res 2021, 45, 13088-13097.
28. Pauluhn J. Phosgene inhalation toxicity: Update on mechanisms and mechanism-based treatment strategies. Toxicology 2021, 450, 152682.
29. Permentier K, Vercammen S, Soetaert S et al. Carbon dioxide poisoning: a literature review of an often forgotten cause of intoxication in the emergency department. Int J Emerg Med 2017, 10, 14.
30. Poonguzhali S, Sivasangari A, Ajitha P et al. Design and performance analysis of smart photonic sensors for industrial applications. Curr Appl Phys 2022, 39, 183-189.
31. Reumuth G, Alharbi Z, Siamak Houschyar K et al. Carbon monoxide intoxication: What we know. Burns 2019, 45, 526-530.
32. Tabasum H, Neelagund SE, Haraha RJ et al. Double deaths due to domestic carbon monoxide poisoning correlated with medicolegal autopsy and laboratory studies. Biomedicine 2022, 42, doi: https://doi.org/10.51248/.v42i2.1305.
33. Van Amsterdam JGC, Nabben T, van den Brink W. Increasing recreational nitrous oxide use: Should we worry? A narrative review. J Psychopharmacol 2022, 36, 943-950.
34. Xia Z, Yang H, Sun J et al. Co-pyrolysis of waste polyvinyl chloride and oil-based drilling cuttings: Pyrolysis process and product characteristics analysis. J Celan Prod 2021, 318, 128521.
35. Zellner T, Eyer F. Choking agents and chlorine gas – History, pathophysiology, clinical effects and treatment. Toxicol Lett 2020, 320, 73-79.
Náhle úmrtia Unilabs Slovensko 115
Akútna choroba z ožiarenia





Člen pracovnej skupiny Národného ohniskového bodu Slovenskej republiky Medzinárodných zdravotných predpisov Svetovej zdravotníckej organizácie Úrad verejného zdravotníctva SR

TÉMA ČÍSLA
žiarenia prakticky vo všetkých oblastiach ľudskej činnosti (veda, výskum, školstvo, medicína, farmácia, hospodárstvo, poľnohospodárstvo, potravinársky priemysel a pod.) viedlo k zavedeniu
ochranných opatrení v oblasti ožiarenia pri práci s ich postupným rozšírením aj na ochranu obyvateľov a životného prostredia pred jeho nepriaznivými účinkami.
Dôvodom sú mimoriadne situácie spôsobené ľudskými aktivitami, či už plánovanými (jadrový priemysel, vojenské skúšky jadrových zbraní), alebo potenciálnymi (možné teroristické aktivity alebo jadrový konflikt).
Vedeckú disciplínu, ktorej náplňou je ochrana zdravia pracovníkov, obyvateľov a životného prostredia pred nepriaznivými účinkami ionizujúceho žiarenia, nazývame radiačná ochrana
Systém ochrany pred ionizujúcim žiarením prešiel dlhým vývojom, je založený na prevencii, na zásadách a princípoch, ktoré platia jednotne na celom svete. V Slovenskej republike je zabezpečenie radiačnej ochrany v celom jej rozsahu v kompetencii úradov verejného zdravotníctva (Úradu verejného zdravotníctva Slovenskej republiky – ÚVZ SR a regionálnych úradov verejného zdravotníctva v Banskej Bystrici, Košiciach, Nitre a v Bratislave).
Množstvom aplikácií zdrojov žiarenia (zdravotníctvo – urýchľovacia, diagnostická technika, rádionuklidové terapeutické procedúry, aplikácie zdrojov žiarenia na vedecké účely, priemysel, jadrová energetika) patrí Slovenská republika (SR) medzi svetovú špičku.
U niektorých aplikácií (jadrová energetika) hrozí možná havária, nehoda alebo udalosť, ktorá môže závažným spôsobom ohroziť zdravie obyvateľov a životné prostredie nielen v SR, ale aj v okolitých krajinách. To, že môže nastať takáto situácia, sme sa za posledných niekoľko desaťročí presvedčili niekoľkokrát. Kontrolovať technicky zložité zariadenia, poskytovať odborné rady pri zabezpečení vysokej úrovne radiačnej ochrany obsluhujúcich pracovníkov, obyvateľov žijúcich v ich okolí a ochrany životného prostredia kladie vysoké odborné nároky na
pracovníkov radiačnej ochrany. Okrem neustáleho odborného vzdelávania potrebujú odborníci z oblasti radiačnej ochrany aj adekvátne prístrojové vybavenie, aby mohli prevádzky takýchto zariadení kontrolovať, a tak minimalizovať respektíve vylúčiť neodôvodnené ožiarenie.
Pri riešení praktických problémov je radiačná ochrana konfrontovaná s otázkami: aké bude alebo môže byť ožiarenie ľudí, čo môže ožiarenie spôsobiť, t. j. aké a koľko problémov na zdraví môže vyvolať a následne ako hodnotiť a usmerňovať dané ožiarenie.
Z hľadiska vzťahu dávky žiarenia a biologického účinku môže ožiarenie spôsobiť deterministické následky, spojené so zánikom buniek a následnou stratou fungovania tkanív a orgánov. Tieto zmeny, ktoré majú jednoznačný klinický prejav a je ich možné dať do súvisu s predchádzajúcim ožiarením, nastávajú až po prekročení určitej dávky – tzv. prahovej dávky – v príslušných tkanivách a orgánoch. Ochrana proti deterministickým účinkom spočíva v zabránení dosiahnutia prahových dávok pre jednotlivé tkanivá a orgány. Iným typom významných biologických zmien v dôsledku ožiarenia sú stochastické účinky zapríčinené zmenami v bunkách, ktoré prežili ožiarenie. Zo zmenených buniek sa môže aj po značnom časovom odstupe vyvinúť nádor. Obranné a reparačné schopnosti organizmu spôsobujú, že tento vývoj je pri malých dávkach veľmi nepravdepodobný, avšak nie sú uvádzané dávky, pri ktorých by nemohlo dôjsť k vzniku nádoru. Karcinogénny účinok žiarenia bol preukázaný
Náhle úmrtia Unilabs Slovensko 117
Využívanie ionizujúceho
v epidemiologických štúdiách u rôznych ožiarených populácií, kde bol pozorovaný zvýšený počet nádorov oproti porovnateľnej kontrolnej populácii. Z hľadiska jednotlivca rastie s dávkou žiarenia pravdepodobnosť vzniku nádoru, nie však intenzita alebo stupeň účinku. Stochastický alebo náhodný charakter, z hľadiska určitého jedinca, majú aj dedičné dôsledky ožiarenia, ktoré sa prejavujú u potomstva ožiarených osôb. Nemôžeme teda vznik týchto poškodení po ožiarení celkom vylúčiť, môžeme iba obmedziť pravdepodobnosť ich vzniku na mieru považovanú za prijateľnú pre jednotlivca a spoločnosť.
Na mieste je otázka, za akých okolnosti, respektíve kedy môže byť pracovník alebo obyvateľ ožiarený dávkou ohrozujúcou život. Vysoké dávky sa môžu vyskytnúť u osôb, ktoré na pracoviskách tieto zdroje obsluhujú. Počet takýchto osôb je obmedzený, preto je pri nehodách postihnutých (ožiarených) obvykle iba málo jednotlivcov.
U jednotlivcov z obyvateľstva môže nastať vyššie uvedený prípad len veľmi vzácne. Mohol by nastať napríklad pri strate zdroja žiarenia s vysokou rádioaktivitou na mieste bežne prístupnom pre obyvateľov, ak by s ním bolo neodborne nakladané.
Lekár, ktorý prijíma k ošetreniu pracovníka ožiareného pri nehode, by mal byť oboznámený s opatreniami prevencie nehôd na pracovisku a s postupmi používanými v prípade, keď taká situácia nastane.
V prvom rade treba, aby stanovil anamnézu, teda druh ožiarenia, miesto na ktorom sa ožiarený nachádzal, v akej pozícii bol vzhľadom na zdroj žiarenia, aké ochranné prostriedky použil a či bol dekontaminovaný pred príchodom do zdravotníckeho zariadenia.
Akútna choroba z ožiarenia môže nastať pri: • lokálnom ožiarení kože, • vonkajšom ožiarení celého tela.
TÉMA ČÍSLA 118 inVitro
Množstvom aplikácií zdrojov žiarenia patrí Slovenská republika medzi svetovú špičku.
Najčastejším prípadom lokálneho ožiarenia je ožiarenie kože. Môže byť spôsobené vonkajším zdrojom žiarenia alebo kontamináciou rádioaktívnymi látkami.
Dôležitým faktorom pre prijatie opatrení na stanovenie liečebného postupu je dozimetrické vyhodnotenie prípadu. Ošetrujúci lekár potrebuje údaje o lokálnej dávke žiarenia, ktorú porovnáva s erytémovou dávkou (ED) pre príslušný druh žiarenia. ED je jednorazová dávka, ktorá do 30 dní vyvolá zreteľný erytém u 80 % ožiarených osôb. Najnižšia ED je okolo 3 Gy.
Pri podozrení na vonkajšiu kontamináciu kože treba merať kontamináciu buď priamo na povrchu tela, alebo na tampónoch, ktorými sa robili otery.
Klinický obraz akútnej radiačnej dermatitídy
Akútna radiačná dermatitída sa vyznačuje niekoľkodňovým obdobím latencie. V prvej fáze sa objavuje tzv. včasný erytém, v prvých 24 – 28 hodinách po ožiarení, ako jemné začervenanie kože. Závažné problémy sa môžu objavovať v období 1 – 2 týždňov po ožiarení. V tomto období treba pacienta pozývať na kontroly a sledovať. Opakovaným meraním teploty kože pomocou termografie je možné posúdiť závažnosť ožiarenia. Po vzniku erytému treba sledovať možný vznik pľuzgierov a nekróz. V prípade, že je lokálna dávka na úrovni biologickej odozvy, sledovanie postihnutej oblasti sa predlžuje na 4 – 6 týždňov.
V týchto prípadoch je možné v tomto období zistiť (nájsť) aj bez predchádzajúceho erytému oneskorenú hyperpigmentáciu, folikulárnu hyperkeratózu, atrofiu a iné.
Z vyššie uvedeného vyplýva, že podozrenie na možné poškodenie kože nevyžaduje okamžitý lekársky zákrok. Ožiarenej osobe musí byť ihneď nariadený zákaz práce so zdrojmi žiarenia, ako aj vylúčenie možnosti kontaktu s chemicky alebo mechanicky dráždiacimi látkami na pracovisku aj mimo neho.
Priama lekárska pomoc sa poskytuje ožiarenej osobe v prípade zreteľnej kožnej reakcie na klinikách popálenín. Indikácie k odoslaniu postihnutých pacientov na kliniku popálenín sú u radiačných poškodení odlišné od tepelných poškodení. Veľmi pozorne treba sledovať ohraničenie sčervenania, pretože u radiačných poškodení nemožno (a priori) odhadnúť
veľkosť plochy a hĺbku postihnutia, ktorá najmä pri gama žiarení býva závažnejšia než pri tepelných popáleninách.
Pri vzniku pľuzgierov a pri hĺbkovom poškodení (defektov) indikuje odborník na popáleniny spôsob lokálneho ošetrenia a využíva podľa potreby vhodné lokálne krytie. Pokiaľ kožné poškodenia nie sú príliš hlboké, táto včasná etapa končí ich epitelizáciou. Priebeh hojenia sa môže skomplikovať, ak je epitelový kryt nedostatočný, čo môže následne viesť k zániku kapilárnej siete v koriu (povrchová vrstva kože). Asi po roku až dvoch sa môže následkom porušenia kontinuity pokožky dostaviť sekundárny defekt. Tu preberá liečbu plastický chirurg. Pred následným liečebným postupom musí byť posúdený aj stav hlbších štruktúr, t. j. ciev a kostí. V tomto prípade sú dôležité aj výsledky dozimetrických meraní. V niektorých prípadoch je možné riešiť stav poškodenia tubulárnou plastikou, v krajnom prípade amputáciou postihnutej časti (končatiny). Z hľadiska prevencie neskorých recidív poškodenia je potrebná dlhodobá ochrana postihnutej časti kože.
Celotelové ožiarenie môže spôsobiť len zdroj žiarenia s vysokou rádioaktivitou. V praxi môže nastať takýto prípad pri nezvládnutí prevádzky jadrového reaktora alebo pri nevhodnej manipulácii so štiepnym materiálom. K významným celotelovým ožiareniam dochádza aj pri strate kontroly nad priemyselnými gama žiaričmi s vysokou rádioaktivitou.
80 %
Erytémová dávka (ED) pre príslušný druh žiarenia je jednorazová dávka, ktorá do 30 dní vyvolá zreteľný erytém u 80 % ožiarených osôb. Najnižšia ED je okolo 3 Gy.
Náhle úmrtia Unilabs Slovensko 119
Klinický obraz pri celotelovom ožiarení Akútna choroba z ožiarenia nastáva po jednorazovom ožiarení celého tela alebo jeho väčšej časti vysokou dávkou žiarenia. V závislosti od dávky žiarenia prevládajú v klinickom obraze príznaky poškodenia krvotvorných orgánov, tráviaceho ústrojenstva alebo centrálneho nervového systému.
Hematologická forma akútnej choroby z ožiarenia so stredne ťažkým priebehom sa prejavuje pri dávkach 3 – 4 Gy. Avšak príznaky sa môžu prejaviť už pri dávkach 1 – 2 Gy. Ich priebeh je možné rozdeliť na niekoľko období. Prvý deň po ožiarení sa objavujú príznaky nešpecifického charakteru, skleslosť a bolesti hlavy a tieto sú takmer vždy spojené so zvracaním. Ďalším obdobím, asi za 1 – 2 týždne, je tzv. doba latencie (bezpríznakové obdobie). Po tomto období dochádza k mikrobiálnemu rozsevu, k rozvoju sepsy a krvácaniu. Ich príčinou je pokles krvotvorby v kostnej dreni. Výraznou zložkou klinického obrazu bývajú aj nazofaryngeálne príznaky vyznačujúce sa poškodením sliznice dutiny ústnej a hltanu. Príčinou tejto formy akútnej choroby z ožiarenia je výpadok významnej frakcie prekurzorov krvotvorby a buniek retikuloendotelového systému.
Pri celotelových dávkach 10 Gy a vyšších sú včasné príznaky výraznejšie a objavujú sa už po štvrtom až šiestom dni po ožiarení. Dochádza k minerálnemu rozvratu, krvavým hnačkám, poruchám črevnej peristaltiky (ileus) a k perforácii čreva. Rozvíja sa črevná forma akútnej choroby z ožiarenia. Patogeneticky ide o nekrózu črevného epitelu s poruchou vodného a minerálneho hospodárstva. Pacienti zomierajú následkom porušenej črevnej mikrobiálnej bariéry s rozvojom septického šoku.
Po dávkach nad 30 Gy sa už po niekoľkých minútach objavujú príznaky ako hypotenzia, dezorientácia, poruchy vedomia. Pri dávkach nad 100 Gy sú typické tonicko-klonické kŕče spojené s bezvedomím a postihnutý umiera na neurovaskulárnu formu akútnej choroby z ožiarenia.
Záver
Dozor v oblasti radiačnej ochrany v SR je zabezpečený Úradom verejného zdravotníctva Slovenskej republiky, Odborom radiačnej ochrany (ORO) a príslušnými regionálnymi úradmi verejného zdravotníctva, a to v zmysle ustanovení Zákona č. 87/2018 Z. z. o radiačnej ochrane a o zmene a doplnení niektorých zákonov. Zákon o radiačnej ochrane pokrýva všetky požiadavky, ktoré sú ustanovené v relevantných dokumentoch Európskej komisie, Medzinárodnej agentúry pre atómovú energiu a ďalších vedeckých inštitúcií. Európska komisia tieto požiadavky navyše pravidelne kontroluje.
Literatúra
1. IAEA, International Basic Safety Standards for Protection against Ionizing Radiation and for the Safety of Radiation Sources, IAEA, Vienna (2014)
2. ICRP, 1990 Recommendations of the International Commission on Radiological Protection, ICRP Publication 60, Pergamon Press, Oxford (1991)
3. ICRP, 2007 Recommendations of the International Commission on Radiological Protection, ICRP Publication 103, Ann. ICRP 37 (2 – 4)
4. Kolektív autorov: Principy a praxe radiační ochrany, Editor Vladislav Klener. 1. vyd. Praha: AZIN CZ, 2000. 619 str. ISBN 80-238-3703-6
5. Herman Cember: Introduction to Health Physics, Third Edition, McGraw-Hill Co., Inc. USA, 1996
6. Remediation Process for Areas Affected by Past Activities and Accidents, Safety Guide No. WS-G3.1,IAEA,Vienna (2007)
Karcinogénny účinok žiarenia bol preukázaný v epidemiologických štúdiách u rôznych ožiarených populácií, kde bol pozorovaný zvýšený počet nádorov oproti porovnateľnej kontrolnej populácii.
TÉMA ČÍSLA 120 inVitro
Kedy došlo k prvej vážnej havárii jadrovej elektrárne na Slovensku?
Prvýkrát 5. januára 1976 na Jadrovej elektrárni (JE) A1. K druhej havárii JE A1 došlo 22. februára 1977. Pri týchto haváriách došlo k významným únikom rádioaktivity do životného prostredia. V ich dôsledku bola prevádzka JE A1 ukončená.
Ako a ako často kontrolujete, či rádioaktívne látky z Jaslovských Bohuníc aj v súčasnosti neprenikajú do vzduchu, zeme a spodných vôd?
ÚVZ SR systematicky monitoruje rádioaktivitu v okolí všetkých JE na Slovensku. Niektoré merania sa vykonávajú v mesačných intervaloch (napríklad aktivita povrchových a pitných vôd, spadov a pod.), niektoré raz ročne (napríklad analýza vzoriek poľnohospodárskych produktov).
V zmysle platných predpisov však za monitorovanie zodpovedá ten, kto kontaminuje životné prostredie. Rozsah meraní, ktoré zabezpečuje prevádzkovateľ, je podstatne širší. ÚVZ SR posudzuje monitorovací plán prevádzkovateľa, kontroluje jeho dodržiavanie a systém kvality monitorovania. Prevádzkovateľ pravidelne predkladá na ÚVZ SR výsledky merania.
Je pravda, že sa zvyšuje počet rakovinových ochorení obyvateľov bývajúcich v okolí jadrových elektrárni?
Dosiaľ žiadna zo štúdií výskytu chorobnosti v okolí JE nič podobné nezistila.
Výpusty z JE na Slovensku sú v porovnaní s inými jadrovými elektrárňami rovnakého typu podpriemerné. Vplyv na ožiarenie obyvateľov je veľmi nízky, dostupnými metódami nie je priamo merateľný. V súlade so súčasnými poznatkami o účinkoch
žiarenia na človeka, pri zohľadnení reálnych dávok obyvateľov v okolí JE, sú možné účinky prevádzky JE v SR na zdravie obyvateľov také malé, že ich nie je možné preukázať ani epidemiologickými štúdiami.
Máme sa báť jadrových elektrárni?
Sú tie naše bezpečné?
Báť sa niečoho, čo nám prináša úžitok, by nebolo správne. Jadrové elektrárne vznikli ako alternatívna technológia na výrobu elektrickej energie. Táto technológia – podobne ako iné, napríklad chemické alebo biologické – prináša určité riziká v podobe nehôd alebo dokonca ťažkých havárií (Černobyľ, Fukušima). Dôležité je, aby tieto riziká boli minimalizované a prevádzka jadrových elektrárni bola dôsledne kontrolovaná. Odpoveď na otázku, či sú naše jadrové elektrárne bezpečné, znie, že naše jadrové elektrárne spĺňajú európsky štandard jadrovej bezpečnosti a radiačnej ochrany, avšak potenciálne riziko mimoriadnej udalosti tu – samozrejme – existuje.
Z tohto dôvodu je veľmi dôležité neustále kontrolovať jej prevádzkovateľa odborne zdatným a nezávislým štátnym dozorným orgánom. Odbor radiačnej ochrany Úradu verejného zdravotníctva Slovenskej republiky ním je, čo potvrdzujú aj pravidelné verifikačné misie Európskej komisie.
Náhle úmrtia Unilabs Slovensko 121
Prehľad významných udalostí na jadrových zariadeniach v SR a otázky, na ktoré ÚVZ SR v súvislosti s ich prevádzkou odpovedá najčastejšie
Neživý, nemŕtvy: účinky rastlín a húb navodzujúce stav podobný smrti






TÉMA ČÍSLA 122 inVitro
PharmDr. Slavomír Kurhajec, PhD. Univerzita veterinárskeho lekárstva a farmácie v Košiciach, Katedra farmaceutickej technológie, farmakognózie a botaniky
prírodného pôvodu.
Fenomén zdanlivej smrti vyvolával strach predovšetkým v Európe v období 17. – 19. storočia. Umierajúci sa obávali, že budú predčasne prehlásení za mŕtvych a následne pochovaní zaživa.
V týchto dobách sa ľudia ďaleko viac než samotnej smrti báli toho, že sa živí zobudia hlboko pod zemou. Kvôli týmto obavám sa zavádzali rozličné „preventívne“ opatrenia. Telo sa tak pochovávalo až na tretí deň po úmrtí, a to výlučne len po dôkladnej prehliadke, súčasťou ktorej boli najbizarnejšie pokusy priviesť nebožtíka k životu. Súčasťou rakiev bývali mechanizmy, ktorým mohol dať údajne mŕtvy najavo, že je ešte stále živý. Z histórie sú známe jednoduché pomôcky ako napríklad zvonček na motúze, ale zámožnejší si mohli dovoliť zložité, technicky prepracované rakvy, ktoré pochovanému umožňovali dostať sa z nich von (1).
Lazarov fenomén je situácia, keď je u človeka s preukázateľnou zástavou obehu popísaná spontánna obnova cirkulácie bez akýchkoľvek resuscitačných zásahov.
vočíšnej ríši sa taktiež môžeme stretnúť s javom s
zdanlivej smrti zvykne spájať s ochoreniami cen-
dy, parkinsonizmus, katatónia, nekonvulzívny status epilepticus, kraniocerebrálne traumy, tumory

Zdanlivá smrť – Vita minima, Vita latens alebo Vita reducta – je stav vyvolaný chorobnými zmenami organizmu alebo externými faktormi, keď sú životné prejavy jedinca výrazne oslabené a utlmené a človek sa pritom javí ako mŕtvy. V živočíšnej ríši sa taktiež môžeme stretnúť s javom podobným zdanlivej smrti a síce s hibernáciou. Dochádza pri nej k dočasnému zníženiu životných funkcií s cieľom prečkať obdobie s nepriaznivými podmienkami. Pri takejto téme je vhodné spomenúť aj Lazarov fenomén, respektíve fenomén autoresuscitácie. Ide o situácie, keď je u človeka s preukázateľnou zástavou obehu popísaná spontánna obnova cirkulácie bez akýchkoľvek resuscitačných zásahov. U ľudí sa stav zdanlivej smrti zvykne spájať s ochoreniami centrálneho nervového systému, ako sú encefalitídy, parkinsonizmus, katatónia, nekonvulzívny status epilepticus, kraniocerebrálne traumy, tumory mozgu či cievne mozgové príhody.
Obraz zdanlivej smrti môžu za určitých okolností vyvolávať aj rôzne somatické ochorenia. Spravidla sa jedná o urémiu, hyperkalcémiu, hypoglykémiu, pelagru, akútnu porfýriu, diabetickú ketoacidózu, najrozličnejšie infekcie, zápaly, ale aj úrazy elektrickým prúdom či bleskom, celkové podchladenie organizmu, anorexiu, prípadne katalepsiu. Stav podobný smrti je možné docieliť aj intoxikáciou, a to spravidla látkami tlmiacimi nervový systém. K týmto látkam bezpochyby patrí alkohol, opioidy, hypnotiká, oxid uhoľnatý a antipsychotiká, avšak výnimkou nie sú ani látky prírodného pôvodu (2). Do tejto skupiny môžeme zaradiť produkty metabolizmu húb a nezriedka aj živočíchov, no najväčšiu skupinu tvoria práve niektoré obsahové látky rastlín.
Náhle úmrtia Unilabs Slovensko 123
Termín zdanlivá smrť sa v medicíne používa na označenie mŕtveho, ktorý po nejakej dobe „ožije“. Táto téma sa objavuje nielen v populárnej literatúre, ale aj z histórie poznáme nejeden prípad, keď sa osoba s nehmatateľným pulzom a teplotou tela nižšou než 22 °C zrazu prebrala. Tento stav môže byť zapríčinený rôznymi ochoreniami, úrazmi alebo intoxikáciou liečivami či látkami prírodného pôvodu.
V
Jednou z nich je napríklad indolový monoterpenický alkaloid yohimbínového typu – rezerpín. Rezerpín sa po perorálnom podaní rýchlo absorbuje a svoju maximálnu plazmatickú koncentráciu dosahuje približne po dvoch hodinách. Jeho mechanizmus účinku spočíva v tom, že blokuje prienik monoamínov do vezikúl presynaptických neurónov, čím následne vyvoláva depléciu neurotransmiterov v synaptickej štrbine a okrem toho pôsobí sympatolyticky (3). Túto látku je pomerne jednoduché získať z rastliny rauvolfia hadovitá (Rauvolfia serpentina, L. Benth.), ktorá patrí do čeľade zimozeleňovité (Apocynaceae). Ide o malé kríky s podlhovastými vajcovitými listami a bielymi alebo červenkastými kvetmi, pre ktoré je charakteristická dlhá korunná rúrka. Ich domovinou je tropická Ázia, obzvlášť India a Thajsko. Na obsah rezerpínu sú bohaté aj iné druhy ako napríklad rauvolfia štvorlistá (Rauvolfia tetraphylla L.) z tropickej Strednej Ameriky alebo rauvolfia dávivá (Rauvolfia vomitoria AFZ), ktorá pochádza z tropickej Afriky. Práve koreň týchto rastlín obsahuje najvyšší podiel účinných látok, ktoré popri rezerpíne tvoria aj iné alkaloidy ako ajmalín a ajmalicín. V malých dávkach sa táto podzemná časť rastliny zvykla používať ako sedatívum a prostriedok na terapiu hypertenzie. Samotný izolovaný alkaloid rezerpín má síce potenciálne využitie v úlohe neuroleptika, no pre vedľajšie účinky, ku ktorým patrí upchatý nos, depresívna nálada, únava či zmenená schopnosť pacienta reagovať na okolité podnety, sa prakticky vôbec nepoužíva (4). Vysoké dávky vyvolávajú výraznú depresiu centrálneho nervového systému,

bradykardiu, hypotenziu, letargiu, kómu a intoxikovaný skutočne môže pôsobiť ako mŕtvy (5).
Lekno modré (Nymphaea caerulea Savigny) je sladkovodná rastlina, ktorá sa prirodzene vyskytuje vo východnej časti Afriky a v južnej časti Arabského polostrova. Starými Egypťanmi bolo toto lekno považované za jednu z najvzácnejších rastlín a aj v súčasnosti je stále klasifikované ako jedno z najkrajších tropických lekien. V staroveku symbolizovalo znovuzrodenie a práve Egypťania verili v jeho omladzujúci a afrodiziakálny účinok. V dnešnej dobe sa mu pripisujú antioxidačné, antiflogistické, antihyperlipidemické, ale hlavne slabé
po 2 hodinách
Rezerpín sa po perorálnom podaní rýchlo absorbuje a svoju maximálnu plazmatickú koncentráciu dosahuje približne po dvoch hodinách.
TÉMA ČÍSLA 124 inVitro
Obrázok č. 1: Rauvolfia serpentina Zdroj: https://www.flickr.com/photos/dinesh_valke/505526733
euforizujúce a sedatívne účinky. Okrem iného obsahuje alkaloid nuciferín, ktorý je štrukturálne podobný apomorfínu. Jeho mechanizmus pôsobenia je podobný s mechanizmom niektorých antipsychotík, obzvlášť aripiprazolom. Účinok je sprostredkovaný najmä prostredníctvom serotonínových a dopamínových receptorov (6, 7). O nuciferíne je známe, že potencuje analgetický účinok morfínu (pôsobí synergicky). Zapríčiňuje sedáciu, ptózu, hypotermiu, inhibuje spontánnu motoriku a vo vyšších dávkach vyvoláva poruchy vedomia a katalepsiu. Tá sa prejavuje strnulosťou končatín, zníženou citlivosťou k bolesti a tzv. voskovou ohybnosťou (Flexibilitas cerea). V ojedinelých prípadoch môžu vysoké dávky nuciferínu vyvolať kómu s mŕtvolným vzhľadom tela (8, 6, 9).
Maoriovia, pôvodní obyvatelia Nového Zélandu, už stáročia používali pečeňovky druhu Radula perrottetii Gottsche ex Steph. a Radula marginata Taylor (patriace medzi machorasty – Bryophyta) na liečenie najrozličnejších ochorení. Tieto rastliny na kameňoch a kmeňoch stromov vo vlhkom prostredí vytvárajú akýsi šupinatý zelený „koberec“. Majú zaoblené prekrývajúce sa listy, ktoré pozostávajú z dvoch nerovnakých lalokov. Práve tie obsahujú kyselinu perotetinovú a jej deriváty označované ako perotetinény (perrottetinene). Najznámejší a najpreskúmanejší je práve (−)-cis-perotetinén. Tieto látky sa chemickou štruktúrou nápadne podobajú dobre známym metabolitom rastlín rodu konope (r. Canabis) – kanabinoidom. Perotetinény disponujú imunomodulačným a antiflogistickým účinkom, ale pripisujú sa im aj psychoaktívne vlastnosti podobné tetrahydrokanabinolu (THC).
Možno aj preto sa zozbieraná a usušená stielka pečeňovky druhu Radula marginata Taylor zvykne zneužívať ako nová rekreačná droga. Treba však poznamenať, že perotetinény v porovnaní s THC pôsobia o niečo menej psychoaktívne. Experimenty vykonané v in vitro aj in vivo podmienkach naznačujú, že ich mechanizmus pôsobenia je taktiež sprostredkovaný parciálnym agonistickým účinkom na kanabinoidných receptoroch CB1 a CB2. Okrem toho, že perotetinén znižuje uvoľňovanie histamínu z mastocytov a disponuje tak antialergickými a protizápalovými vlastnosťami, jeho vyššie dávky vyvolávajú analgéziu, halucinácie, hypotermiu, hypolokomóciu, katalepsiu až celkovú paralýzu (10, 11).
Zdroj: https://upload.wikimedia.org/wikipedia/commons/8/80/ Nymphaea_caerulea-20091014-RM-115245.jpg
Už starovekí Gréci poznali toxické účinky rododendronov a tvrdili, že po skonzumovaní rododendronového medu upadnú do stavu blízkeho smrti. Tento stav vo svojich spisoch popisuje aj Sokratov žiak Xenofón. V niektorých oblastiach Nepálu a Turecka dodnes býva takýto med zneužívaný ako rekreačná droga, ktorá si zaslúžila pomenovanie „med bláznov“. Jeho účinky sú zapríčinené bioaktívnymi látkami rastlín rodu rododendron patriace do čeľade vresovité (Ericaceae). Tieto vždyzelené kvitnúce kríky, známe pod ľudovým názvom alpská ruža alebo azalka, sa u nás bežne pestujú kvôli atraktívnym kvetom. Obzvlášť druhy Rhododendron ponticum L., Rhododendron flavum Don. a Rhododendron luteum Sweet produkujú acetylandromedol – grayanotoxín, ktorý ovplyvňuje sodíkové kanály neurónov. Dokonca druhy ako

Náhle úmrtia Unilabs Slovensko 125
Obrázok č. 2: Nymphaea caerulea
Lekno modré, starými Egypťanmi považované za jednu z najvzácnejších rastlín, obsahuje alkaloid nuciferín.
Rhododendron dauricum L. a Rhododendron anthopogonoides Maxim. v rámci svojho metabolizmu syntetizujú aj psychoaktívne fytokanabinoidy, akými sú kyselina antopogocyklolová, kyselina grifolová a konfluentín. Obsahové látky rododendronov vyvolávajú diurézu, hyperhidrózu, parestéziu (tŕpnutie) končatín, svalovú slabosť, výraznú hypotenziu, poruchy srdcového rytmu, bradykardiu a poruchy vedomia (12, 13).
Popínavá liana chondodendron plstnatý (Chondodendron tomentosum Ruiz. & Pav.) z čeľade mesiačikovité (Menispermaceae) pochádzajúca z dažďových lesov Južnej Ameriky. Kôru a drevo týchto rastlín pôvodní obyvatelia používali na výrobu šípových jedov. Obsahuje bisbenzylizochinolínové alkaloidy na čele s tubokurarínom. Táto látka nesie pomenovanie odvodené od tubusu, bambusovej nádoby, v ktorej ho Indiáni uchovávali a od súhrnného názvu pre šípové jedy, t. j. kurare. Tubokurarín sa cez intaktnú sliznicu gastrointestinálneho traktu vôbec neresorbuje.
Pri intravenóznom podaní však bráni prenosu vzruchu medzi nervom a svalom, čím vyvoláva úplnú paralýzu priečne pruhovaných svalov.
Obeť zasiahnutá takýmto otráveným šípom je síce pri plnom vedomí, ale nedokáže vykonať ani najmenší pohyb. Jej dýchanie je pomalé a plytké a v ťažších prípadoch intoxikácie môže dôjsť až k uduseniu. Práve neschopnosť pohybu u takto otráveného zvieraťa alebo človeka môže vyvolať dojem že je už po smrti (4, 14).
Opium crudum je na vzduchu zaschnutá šťava, respektíve latex, ktorý sa získava narezaním nezrelých makovíc maku siateho (Papaver somniferum L.) z čeľade makovité (Papaveraceae). Obsahuje veľké množstvo ópiových alkaloidov, z ktorých je najznámejší morfín, kodeín, tebaín, papaverín či noskapín. Táto droga v súčasnosti predstavuje surovinu, z ktorej sa jednotlivé alkaloidy izolujú a následne používajú pre svoje charakteristické účinky. V súčasnosti je zaobchádzanie s ópiom a jeho vybranými obsahovými látkami prísne regulované a riadi sa striktne zákonom. Avšak až do 20. storočia sa v lekárňach bežne predávala ópiová tinktúra tzv. Laudanum, s obsahom 1 % morfínu, a to bez akéhokoľvek lekárskeho predpisu. Tinktúra predstavovala lacné a dostupné analgetikum, antitusikum a antidiarhoikum. Pri požití väčšieho množstva morfínu sa u pacientov nezriedka objavili príznaky akútnej otravy. Treba poznamenať, že letálna dávka morfínu pre dospelého (nezávislého) človeka sa pohybuje len okolo 20 – 40 mg. Okrem hlbokého bezvedomia, pomalého a povrchného dychu,
Obrázok
Zdroj: https://upload.wikimedia.org/wikipedia/ commons/1/1a/Papaver_somniferum_2021_G4.jpg

Zdroj: https://cs.wikipedia.org/wiki/Byrsonima_ crassifolia#/media/Soubor:Byrsonima_crassifolia_2.jpg

Obrázok
Zdroj: https://thesoulvine.com/products/banisteriopsis-caapi-1oz?selling_plan=1232502895&variant=20390051184694

TÉMA ČÍSLA 126 inVitro
č. 3: Papaver somniferum
Obrázok č. 4: Byrsonima crassifolia
č. 5: Banisteriopsis caapi
miotických zreníc, cyanózy a nízkeho krvného tlaku sa intoxikovaný vyznačoval nízkou telesnou teplotou a studenou pokožkou, čo obhliadajúceho lekára mohlo falošne ubezpečiť, že je už pacient mŕtvy (4, 14, 15).
Za zmienku stojí spomenúť aj rastlinu Byrsonima crassifolia (L.) Kunth, z čeľade malpígiovité (Malpighiaceae). Je to tropický strom široko rozšírený v Mexiku a v niektorých regiónoch Strednej a Južnej Ameriky. Rastlina je známa pre svoje chutné plody, známe ako „nanche“ a uplatnenie v ľudovej medicíne pri liečbe hnačkových ochorení, nervozite a hypertenzie. Nedávno sa ukázalo, že intraperitoneálne podanie alkoholových extraktov z kôry a listov u pokusných zvierat pôsobilo analgeticky a zároveň znižovalo svalový tonus, vyvolávalo hypotermiu a katalepsiu. Pokusné zviera sa prestalo hýbať a na prvý pohľad vyzeralo ako mŕtve. Rastlina obsahuje veľké množstvo flavonoidov (rutín, kvercetín, hesperidín) a zatiaľ nie je zrejmé, ktoré účinné látky spôsobovali sledované prejavy (16).
Existujú rastliny, ktoré po požití síce fyzicky nevyvolávajú stav podobný smrti, ale pôsobia ako psychodysleptiká vyvolávajúce halucinácie a ich konzumenti môžu popisovať posmrtné zážitky. K takýmto rastlinám bezpochyby patrí tzv. liana smrti alebo liana duší (Banisteriopsis caapi Spruce ex Griseb.) z čeľade malpígiovité (Malpighiaceae), domorodcami označovaná názvom ayahuasca. Táto liana slúži na prípravu nápoja amazonských šamanov. Obsahuje harmalové alkaloidy ako harmín, harmalín a tetrahydroharmín, ktoré pôsobia ako inhibítory monoaminooxidázy. Okrem toho rastlina produkuje halucinogénne pôsobiaci dimetyltryptamín (DMT). Podobne ako iné psychedeliká, aj táto látka ovplyvňuje serotonínový systém v mozgu. DMT pôsobí ako agonista serotonínových receptorov a navodzuje extrémne silné mimotelové zážitky. Intoxikovaný má pocity
Liana smrti alebo liana duší, domorodcami označovaná názvom ayahuasca, obsahuje harmalové alkaloidy ako harmín, harmalín a tetrahydroharmín. Okrem toho produkuje halucinogénne pôsobiaci dimetyltryptamín (DMT).

Perotetinény sa chemickou štruktúrou nápadne podobajú dobre známym metabolitom rastlín rodu konope – kanabinoidom.
návštevy iných svetov, komunikácie s bytosťami iných dimenzií, pričom pociťuje silný vnútorný mier. Zážitky po požití ayahuascy sú podozrivo podobné tým, ktoré popisujú ľudia ocitajúci sa na prahu smrti. V našich zemepisných šírkach nájdeme DMT v niektorých rastlinách rodu chrastnica (r. Phalaris) z čeľade lipnicovité (Poaceae). Najznámejšia je chrastnica trsteníkovitá (Phalaris arundinacea L.), ktorá sa taktiež zvykne zneužívať pre svoje halucinogénne vlastnosti. Užíva sa fajčením, jej účinky nastupujú veľmi rýchlo a trvajú spravidla 30 minút. Rastliny s obsahom DMT sa nepoužívajú len pri šamanských rituáloch. Siahajú po nich ľudia túžiaci po silných psychedelických zážitkoch, ktorí chcú vyskúšať niečo iné než LSD či lysohlávky. Treba poznamenať, že u pravidelných konzumentov rastlín s obsahom DMT sa často pozoruje tzv. rozštiepenie ega a vážne psychické poruchy. DMT terapeutické využitie nemá, no diskutuje sa o ňom ako o modelovej látke s potenciálnym využitím pri štúdiu psychológie umierania (15, 17, 18, 19).
Náhle úmrtia Unilabs Slovensko 127
V Strednej a Južnej Amerike sú ako halucinogén často zneužívané huby s miestnym označením – teonanácatl. Nám sú tieto huby známe skôr ako lysohlávky. V Európe sú najrozšírenejšie druhy holohlavec končistý (Psilocybe semilanceata (Fr.) P. Kumm.) a holohlavec modrejúci (Psilocybe cyanescens Wakef.). V týchto hubách sa množstvo psychoaktívneho indolového derivátu psilocybínu pohybuje priemerne okolo 1 %. Účinnú dávku tak predstavuje 6 až 12 plodníc, pričom ich účinok nastupuje po 30 až 60 minútach. Štrukturálne je psilocybínu veľmi podobná zlúčenina N,N-dimetyl-5-hydroxytryptamín, ktorý nájdeme v muchotrávke citrónovožltej (Amanita citrina Pers.), muchotrávke porfýrovosivej (Amanita porphyria Alb., Schwein.) alebo v sekrétoch ropuchy bradavičnatej (Bufo bufo L.). Pri náboženských obradoch boli Aztékmi používané semená rastliny ololiuqui, ktorú poznáme pod slovenským názvom povojník purpurový (Ipomoea violacea L.) z čeľade pupencovité (Convolvulaceae). Jeho hlavnou účinnou látkou je amid kyseliny lysergovej, štrukturálne podobný derivát dobre známej halucinogénnej drogy LSD. Peyotl je termín, ktorým sa niekedy označuje druh kaktusu s názvom lofofora williamsova (Echinocactus Wiliamsi J. M. Coult.). Ukrýva v sebe halucinogénny derivát fenyletylamínu – meskalín
Účinok všetkých týchto látok, t. j. psylocibínu, N,N-dimetyl-5-hydroxytryptamínu, amidu kyseliny lysergovej či meskalínu, je podobný účinku, akým sa vyznačuje spomínaný DMT a s najväčšou pravdepodobnosťou rovnako súvisí so serotonínovými receptormi, a to najmä s 5-HT2A. Tieto zlúčeniny vyvolávajú transcendentálne zážitky, zmenu vo vnímaní reality, priestoru a času, spôsobujú odlišnosti v myslení, zapríčiňujú poruchy vo videní, makropsiu, halucinácie či depersonalizáciu (15, 17, 18).
Záver
Za určitých okolností môže byť zdanlivá smrť, ktorú chápeme ako útlm fyziologických funkcií, chybne interpretovaná ako „skutočná“ smrť, t. j. Exitus letalis – prirodzený odchod. Človek môže zdanlivo pôsobiť ako mŕtvy z viacerých príčin. Spravidla ide o rôzne ochorenia centrálneho nervového systému, somatické ochorenia, úrazy alebo rôzne intoxikácie. Na zabránenie chybného konštatovania smrti preto treba dôkladne posúdiť prítomnosť nielen tzv. neistých posmrtných znakov (bledosť kože, pokles telesnej teploty, areflexia, depresia dýchania, nehmatateľný pulz, nepočuteľná srdcová činnosť), ale je neodmysliteľné zamerať sa aj na tzv. isté posmrtné znaky (posmrtné škvrny, posmrtná stuhnutosť, hnilobné zmeny) a overiť prítomnosť elektrickej srdcovej aktivity monitorovaním EKG, elektrickej aktivity mozgu vykonaním EEG, respektíve určiť mozgovú smrť pomocou angiografie mozgových tepien. Len skutočne dôkladným vyšetrením tela je možné overiť, či ide reálne o smrť, alebo len o patologický stav organizmu vyznačujúci sa zdanlivou smrťou (20).
Až do 20. storočia sa v lekárňach bežne predávala ópiová tinktúra tzv. Laudanum s obsahom 1 % morfínu, a to bez akéhokoľvek lekárskeho predpisu.
TÉMA ČÍSLA 128 inVitro
https://en.wikipedia.org/wiki/Psilocybe_semilanceata#/ media/File:Psilocybe.semilanceata.Alan.jpg

Literatúra
1. Grubhoffer, V., et al. Zdánlivá smrt jako kulturotvorný fenomén. Historie–Otázky–Problémy, 2019, 11.1: 177-189.
2. Bobrov, N. et al. Tanatológia a humánna tafonómia – etické a právne aspekty, 1 vyd., 2016, Lekárska fakulta UPJŠ: Košice, 84 s.
3. Higuo C. Cell Therapy for Parkinson’s Disease. In RAM, J. L. et al. Conn's Handbook of Models for Human Aging (Second Edition). London : Academic Press, 2018, p. 659-672. Schonfelder
4. Schönfelder I. et al. Liečivé rastliny: Ottov sprievodca prírodou, 2010, Ottovo nakladatelství: Praha, 496 s.
5. Cheung, M. et al. Reserpine In National library of medicine. National centre for biotechnology information: Treasure Island (FL) StatPearls Publishing. 2020.
6. Farrell MS, et al. In Vitro and In Vivo Characterization of the Alkaloid Nuciferine. PLoS One, 2016, 11.3: 1-27.
7. Chan, J. D. et al. Pharmacological profiling an abundantly expressed schistosome serotonergic GPCR identifies nuciferine as a potent antagonist. International Journal for Parasitology: Drugs and Drug Resistance, 2016, 6.3: 364-370.
8. Bhattacharya S. K. et al. Psychopharmacological studies on (-)-nuciferine and its Hofmann degradation product atherosperminine. Psychopharmacology, 1978, 59.1: 29-33.
9. Mukherjee, P. K., et al. The sacred lotus (Nelumbo nucifera)–phytochemical and therapeutic profile. Journal of Pharmacy and Pharmacology, 2009, 61.4: 407-422.
10. Asai, H. et al. Potential Anti-allergic Effects of Bibenzyl Derivatives from Liverworts, Radula perrottetii. Planta Medica, 2022, 88.12: 1069-1077.
11. Chicca, A. et al. Uncovering the psychoactivity of a cannabinoid from liverworts associated with a legal high. Science advances, 2018, 4.10: 1-10.
12. Gülck, T. et al. Phytocannabinoids: origins and biosynthesis. Trends in plant science, 2020, 25.10: 985-1004.
13. Jansen, S. A. et al. Grayanotoxin poisoning: „mad honey disease“ and beyond. Cardiovascular toxicology, 2012, 12: 208-215.
14. Mirossay, L. et al. Základná farmakológia a farmakoterapia, 2009, Equilibria: Košice, 533 s.
15. Tumová, I. et al. Toxikológia pre farmaceutov, 2016, Herba: Bratislava, 192 s.
16. De La Cabeza, M. et al. Neuropharmacological Effects in Animal Models and HPLC-Phytochemical Profiling of Byrsonima crassifolia (L.) Kunth Bark Extracts. Molecules, 2023, 28.2: 764.
17. Valenca, M. M. et al. The use of hallucinogenic plants in the history of Homo sapiens: prehistory and ancient peoples. In CARVALHO, C. A et. al Neuronitri Nutrition, Brain and Behavior Recife : UFPE, 2019, p. 215-220.
18. Mandal, S.C. et al. Herbal biomolecules in Healthcare applications, 2021, Academic Press: London, p. 722.
19. Sonego, A. B. et al. Cannabidiol attenuates haloperidol-induced catalepsy and c-Fos protein expression in the dorsolateral striatum via 5-HT1A receptors in mice. Behavioural brain research, 2016, 309: 22-28.
20. Škulec, R. et al. „Zdánlivá smrt“ je z pohledu fyziologie možná?. Anesteziologie a intenzivní medicína, 2018, 29.3: 168-170.
Náhle úmrtia Unilabs Slovensko 129
Obrázok č. 6: Psilocybe semilanceata Zdroj:
Právne a medicínske aspekty darcovstva orgánov na Slovensku
Odber orgánov na transplantačné účely je nepochybne jednou z najdôležitejších súčastí multidisciplinárneho liečebného postupu. Uvedené multidisciplinárne liečebné postupy sú spojené s požiadavkou na efektívne vyhľadávanie darcov, diagnostiku a odber orgánov, tkanív a buniek za účelom ekonomicky efektívneho a legislatívne nespochybniteľného použitia u príjemcov.




TÉMA ČÍSLA 130 inVitro
MUDr. Igor Gaľa, PhD., MPH
Primár
Transplantačné oddelenie, Univerzitná nemocnica L. Pasteura Košice
„Bez darcov niet transplantácií.“ Toto známe a všeobecne akceptované tvrdenie je dôkazom toho, že darca predstavuje východiskový bod pre každý transplantačný program. Bez ohľadu na to, ako dobre je transplantačný program pripravený a finančne zabezpečený, jeho vyhliadky na úspech závisia od počtu darcov orgánov. Dôležitým míľnikom v histórii transplantácií bolo vytvorenie odberových koordinátorov v jednotlivých transplantačných centrách. Tým bol zabezpečený hladký priebeh celého procesu, ktorý začína nahlásením potenciálneho darcu orgánov.



Bez ohľadu na to, ako dobre je transplantačtenciálneho darcu orgánov.
V modernej medicíne je dobre známe, že transplantácia orgánov významne predlžuje život a zlepšuje jeho kvalitu. Dokonca sa ukázalo, že je nákladovo efektívna. Keďže sú odbery orgánov od zomrelých darcov na transplantačné



účely v súčasnosti bežným lekárskym výkonom, existuje všeobecná zhoda v tom, že by darcovstvo malo byť upravené samostatnou právnou normou. Právne úpravy týkajúce sa darcovstva orgánov sa v jednotlivých krajinách líšia, čo súvisí s kultúrnymi, sociálnymi a náboženský-
orgánov sa v jednotlivých krajinách líšia, čo súmi tradíciami.
a existuje mnoho právnych a spoločenských etických otázok, ktoré treba ďalej skúmať a roz-
zo strany lekárskych spoločností a darcovských spoločností a predovšetkým zo strany prísluš-
Už v roku 1991 pápež Ján Pavol II. na 1. medzinárodnom kongrese spoločnosti pre výmenu orgánov povedal: „Na základe výskumu a klinických skúseností sa treba ešte veľa naučiť a existuje mnoho právnych a spoločenských etických otázok, ktoré treba ďalej skúmať a rozširovať. Vyskytujú sa dokonca hanebné prípady zneužívania, ktoré si vyžadujú rozhodné kroky zo strany lekárskych spoločností a darcovských spoločností a predovšetkým zo strany príslušných legislatívnych orgánov.“ (1)
Náhle úmrtia Unilabs Slovensko 131
Odbery orgánov sú zahrnuté v etických a právnych normách a podobných medicínskych kritériách. Môžu ich vykonávať pracovníci vyškolení na túto činnosť. Odbery a transplantácie sa vykonávajú v zdravotníckych zariadeniach určených Ministerstvom zdravotníctva Slovenskej republiky, ktoré udeľuje povolenie k týmto činnostiam.
Problematika darcovstva orgánov je rozsiahla a okrem medicínskeho pohľadu zahŕňa napríklad aj právny, historický, etický, náboženský princíp a iné aspekty. Základné pravidlá sú zakotvené v slovenskej legislatíve a upravujú ich právne predpisy rôznej právnej sily, ako sú zákony, nariadenia vlády a odborné usmernenia.
Transplantácie orgánov a tkanív majú dlhú históriu. Ľudia v minulosti premýšľali a skúmali, ako nahradiť poškodené alebo chýbajúce časti ľudského tela. Prvá experimentálna autotransplantácia obličky bola uskutočnená na psovi v roku 1902, ktorú vykonal Emmerich Ullmann. Až o 52 rokov neskôr, konkrétne 23. 12. 1954 bola v Bostone vykonaná prvá úspešná transplantácia obličky medzi jednovaječnými dvojčatami. Tento operačný zákrok uskutočnil chirurg Joseph Murray. Prvú nepríbuznú transplantáciu obličky zrealizoval ten istý chirurg v roku 1961 u pacienta s imunosupresívnou liečbou. Transplantát fungoval dobre, ale pacient zomrel na toxicitu lieku. V tom istom roku urobili v bývalom Československu prvú transplantáciu obličky lekári v Hradci Králové. Iba 16-ročnej pacientke z východného Slovenska transplantovali obličku od jej matky. Pacientka však 2 týždne po transplantácii zomrela na infekčnú komplikáciu – otravu krvi. Systematický program transplantácie obličiek sa začal v Prahe a prvú úspešnú transplantáciu obličky vykonali 21. marca 1966 v Ústave klinickej a experimentálnej medicíny – IKEM. (2)
Na Slovensku bola zrealizovaná prvá transplantácia obličky 16. júna 1972 v Nemocnici s poliklinikou akademika Ladislava Dérera na bratislavských Kramároch a vykonal ju transplantačný tím Urologickej kliniky Lekárskej fakulty Univerzity Komenského v Bratislave pod vedením profesora Zvaru. (3)
Legislatíva odberov a tkanív na Slovensku Ako už bolo spomínané, transplantácia orgánov, tkanív a buniek má multidisciplinárny charakter a zaoberá sa prenosom z tela živého alebo mŕtveho darcu do tela príjemcu za účelom záchrany života alebo významného zlepšenia jeho kvality. V Slovenskej republike sa vykonávajú
Právne úpravy týkajúce sa darcovstva orgánov sa v jednotlivých krajinách líšia, čo súvisí s kultúrnymi, sociálnymi a náboženskými tradíciami.
transplantácie orgánov, tkanív a buniek od mŕtvych a živých darcov v štyroch transplantačných centrách v Košiciach, Banskej Bystrici, Martine a v Bratislave. V Košiciach a Martine je rozvinutý transplantačný program obličiek. V Banskej Bystrici sa okrem obličiek transplantuje aj pečeň a v Bratislave sa realizuje aj program transplantácie srdca.
Jeden mŕtvy darca môže zachrániť 7 životov. Z orgánov sa transplantujú obličky, pankreas, pečeň, srdce, pľúca a tenké črevo. Z tkanív sa môže transplantovať koža, cievy, spojivové tkanivá, srdcové chlopne, očné tkanivá a konduity a tkanivá embryonálneho pôvodu.
Koncepcia smrti mozgu v Slovenskej republike – legislatívne aspekty
Až do polovice minulého storočia bola smrť jedinca vnímaná ako zástava činnosti srdca a dýchania. S rozvojom resuscitačných techník a objavením umelej ventilácie pľúc sa koncept mozgovej smrti zmenil a za mŕtveho darcu je považovaný pacient so všetkými vyhasnutými funkciami mozgu, vrátane mozgového kmeňa, v dôsledku ireverzibilného poškodenia mozgu z rôznych príčin. Stanovenie mozgovej smrti nie je celosvetovo rovnaké a medzi vyspelými krajinami varíruje. Prvá európska krajina, ktorá zadefinovala mozgovú smrť zákonom, bolo Francúzsko, a to v roku 1968. (4)
TÉMA ČÍSLA 132 inVitro
Prvý postup pri stanovení smrti mozgu v Slovenskej republike bol uzákonený v polovici sedemdesiatych rokov. Slovenská republika upravila postup pri stanovení mozgovej smrti v dvoch právnych úpravách:
• Odborné usmernenie Ministerstva zdravotníctva SR o darcovstve, odbere ľudských orgánov z tiel živých a mŕtvych darcov, o testovaní darcov a o prenose ľudských orgánov na príjemcu. Ide o predpis č. 28610/2006 – OZSO, ďalej len „odborné usmernenie MZ SR“. (5)
• Zákon o zdravotnej starostlivosti, službách súvisiacich s poskytovaním zdravotnej starostlivosti a o zmene a doplnení niektorých zákonov č. 576/2004 Z. z., ďalej len „zákon o zdravotnej starostlivosti“. (6)
Podľa §43 ods. 8 písm. c) zákona o zdravotnej starostlivosti, po určení smrti lekárom alebo konzíliom možno na mŕtvom tele vykonať len zdravotné výkony potrebné na účely odberu ľudských orgánov, ľudských tkanív a ľudských buniek.
Podľa §43 ods. 4 zákona o zdravotnej starostlivosti, ak sa dýchacie funkcie a obehové funkcie osoby udržiavajú pomocou prístrojov, smrť mozgu musí jednomyseľne potvrdiť konzílium, pričom § 2 ods. 5 tohto zákona ustanovuje, z ktorých pracovníkov je poradný orgán zložený. (7)
Vyššie uvedeným odborným usmernením MZ SR bolo zrušené odborné usmernenie MZ SR č. SZS4391/1996-Po o odberoch orgánov z tiel mŕtvych darcov. (8)
Zároveň bolo Úradom pre dohľad nad zdravotnou starostlivosťou vydané Metodické usmernenie č. 01/01/2015 o odbere tkanív a buniek z mŕtvych darcov na pracoviskách úradu za účelom stanovenia podmienok spolupráce pri výkone podmienok spolupráce a jednotného postupu pri výkone odberu tkanív a buniek z tiel mŕtvych darcov tkanivovými zariadeniami na súdnolekárskych a patologicko-anatomických pracoviskách úradu. (9) Podstatná zmena, ktorú zaviedlo účinné odborné usmernenie MZ SR, je tá, že predmetom jeho úpravy sú nielen odbery z tiel mŕtvych, ale aj živých darcov. § 43 ods. 1 zákona o zdravotnej starostlivosti upravuje, že „lekár je povinný zisťovať smrť v súlade so súčasnými poznatkami vedy.“ Uvedené riešenie je považované za veľmi výhodné z toho hľadiska, že ak by sa v budúcnosti prípadne zmenili podmienky pre určenie smrti, samotné transplantácie by sa realizovali podľa poznatkov medicínskej vedy aktuálnych v danom období. Ak by v zákone bolo len ustanovenie, ktoré by explicitne/jednoznačne vymedzilo, kedy sa osoba považuje za mŕtvu a neobsahovalo by formuláciu, že „lekár je povinný zisťovať smrť v súlade so súčasnými poznatkami lekárskej vedy“, brzdilo by to uskutočňovanie transplantácií. Muselo by sa vyčkať na zmenu chápania a následne zákonnej úpravy zisťovania smrti, teda pokiaľ by sa znenie zákona neprispôsobilo potrebám a poznatkom praxe, inak by bolo vykonávanie transplantácií protiprávne. (10)
Z tohto dôvodu je zákon o zdravotnej starostlivosti právny predpis, ktorý dôsledne upravuje právne vzťahy a postupy v danej oblasti, a to nie len čo sa týka určovania momentu smrti, ale aj z hľadiska transplantácií ex morturo. (11)
1972
Na Slovensku bola zrealizovaná prvá transplantácia obličky v roku 1972 v Nemocnici s poliklinikou akademika Ladislava Dérera na bratislavských Kramároch.
Náhle úmrtia Unilabs Slovensko 133
Správnosť zákonnej formulácie sa nedávno potvrdila, nakoľko v odbornom usmernení sa zdôrazňuje klinická diagnostika mozgovej smrti bez nevyhnutnosti jej potvrdenia konfirmačným testom, tzv. mozgovou panangiografiou.
Klinické vyšetrenie mozgovej smrti musí byť vykonané dvakrát s časovým odstupom – v závislosti od toho, či ide o dieťa (tu sa rozlišuje aj jeho vek), alebo o dospelého. Len v prípade nejednoznačného klinického vyšetrenia alebo v prípade nemožnosti vylúčiť prítomnosť kontraindikácií odberu treba potvrdiť diagnózu mozgovej smrti konfirmačným testom. Ide o jedenkrát vykonanú sériografickú cerebrálnu panagiografiu alebo mozgovú perfúznu scintigrafiu ako dôkaz zastavenia mozgovej cirkulácie a EEG vyšetrenie alebo vyšetrenie sluchových kmeňových evokovaných potenciálov. Napriek tomu sa u detí do jedného roku veku musí jeden z týchto testov vykonať povinne. (12)
Všetky vyššie uvedené kritériá sú v súlade s legislatívou Európskej únie a so smernicami Európskej dialyzačnej a transplantačnej spoločnosti a Európskej spoločnosti pre orgánové transplantácie. Cieľom zmeny je možnosť klinicky diagnostikovať mozgovú smrť aj u potenciálnych darcov, u ktorých aj pri ťažkom mozgovom poranení, nezlučiteľným so životom, nedochádza ku kompletnej zástave mozgovej cirkulácie. (13)
Právna úprava darcovstva orgánov Odoberaním, darovaním a transplantáciou orgánov, tkanív a buniek sa zaoberá právna úprava darcovstva orgánov predstavujúca komplex pravidiel, ktorý zabezpečuje ochranu práv nielen darcov, ale aj príjemcov a usmerňuje celý proces. Slovenská legislatíva darcovstva vychádza z právnych úprav Európskej únie – zo smerníc Európskeho parlamentu a Rady EÚ. Smernice predstavujú špecifický druh právneho aktu a sú záväzné pre každý členský štát. Medzi rozhodujúce európske smernice, ktoré upravujú predmetnú problematiku, môžeme zaradiť Smernicu Európskeho parlamentu a Rady 2004/23/ES z 31. marca 2004 a Smernicu Európskeho parlamentu a Rady 2010/45/EÚ zo 7. júla 2010. Citovať spomínané právne normy by ďaleko presiahlo možnosti tohto článku. Všetky právne normy
Jeden mŕtvy darca môže zachrániť 7 životov.
TÉMA ČÍSLA 134 inVitro
7 životov
o odberoch orgánov a tkanív komplexne dopĺňa Zákon č. 317/2016 Z. z. o požiadavkách a postupoch pri odbere a transplantácií ľudského orgánu, ľudského tkaniva a buniek (transplantačný zákon). Darcovstvo orgánov je špecifická právna oblasť, ktorú v slovenskom právnom poriadku zaraďujeme do medicínskeho práva.
Detekcia orgánového darcu
Detekcia potenciálneho orgánového darcu (POD) je najdôležitejším krokom v darcovsko-transplantačnom programe, ktorý sa začína identifikáciou POD a končí sa odberom orgánov a tkanív a následnou transplantáciou príjemcovi. Takýmto darcom je každý pacient v kóme s nezvratným poškodením funkcie mozgu, u ktorého sa predpokladá, že dospeje do mozgovej smrti. Vek darcu nie je ohraničený. Darcov orgánov a tkanív rozdeľujeme do dvoch veľkých skupín – žijúci darcovia a mŕtvi darcovia.
Mŕtveho darcu orgánov môžeme rozdeliť do dvoch skupín:
1. darca s bijúcim srdcom – DBD (donor a er brain death)
2. darca s nebijúcim srdcom – DCD (donor a er circulatory death)
Väčšina potenciálnych orgánových darcov je hospitalizovaná na jednotkách anestéziológie a intenzívnej medicíny. Určitý počet darcov s bijúcim srdcom sa môže vyskytovať aj na jednotkách intenzívnej starostlivosti, ktoré disponujú umelou pľúcnou ventiláciou ako napríklad neurochirurgická, kardiologická, neurologická či traumatologická JIS. Práve tieto spomínané jednotky intenzívnej starostlivosti môžu byť zdrojom neidentifikovaných POD. Ako vhodné riešenie považujeme funkciu nemocničného koordinátora s kompetenciou prístupu na tieto oddelenia, ktorý identifikuje POD. (14, 15)
Manažment multiorgánového darcu
Súčasné princípy starostlivosti o darcu orgánov sú zamerané na monitoring základných funkcií jednotlivých orgánov a na aplikáciu infúzií, respektíve – v prípade potreby – na podávanie vazopresorickej podpory.
Čas, ktorý darca strávi na oddeleniach anestéziológie a intenzívnej medicíny (OAIM), je nevyhnutné využiť na optimalizáciu multiorgánových funkcií za účelom zlepšenia transplantačných výsledkov. Reverzibilné poruchy funkcie jednotlivých orgánov môžu byť korigované medikamentóznou resuscitáciou. Ošetrovací čas by mal byť sprevádzaný opakovaným
Za mŕtveho darcu je považovaný pacient so všetkými vyhasnutými funkciami mozgu, vrátane mozgového kmeňa, v dôsledku ireverzibilného poškodenia mozgu z rôznych príčin.
prehodnocovaním aktuálneho stavu so snahou o zlepšenie orgánových funkcií smerom k predefinovaným cieľom. Ak sú orgánové funkcie optimalizované, odber orgánov by mal byť uskutočnený čo najskôr.
Kontraindikácie darcovstva orgánov rozdeľujeme na absolútne a relatívne.
Absolútne kontraindikácie darovania orgánov sú: HIV pozitivita, akútna hepatitída, anamnéza alebo riziko priónovej choroby, tuberkulóza, nezvládnutá sepsa, anamnéza malígneho nádorového ochorenia (s výnimkou kožného bazaliómu, karcinómu krčka maternice in situ a nemetastázujúcich primárnych mozgových nádorov).
Relatívne kontraindikácie darovania konkrétneho orgánu sú: závažné poškodenie funkcie potenciálneho štepu, ktoré má trvalý charakter a predstavuje neakceptovateľné riziko pre recipienta, anamnéza chronického poškodenia orgánu, sérologická pozitivita na vírusovú hepatitídu B alebo C – orgány od takýchto darcov je možné odobrať a ponúknuť príjemcom s infekciou vírusom HBV, respektíve HCV (po ich detailnom informovaní). Pri odmietnutí jedného orgánu z dôvodu jeho nedostatočnej kvality je stále možné uvažovať o darcovstve iného orgánu. (14, 15)
Náhle úmrtia Unilabs Slovensko 135
Stanovenie mozgovej smrti a starostlivosť o darcu
Nevyhnutnými predpokladmi stanovenia smrti mozgu sú:
1. známa a nevyliečiteľná príčina poškodenia mozgu,
2. bezvedomie (Glasgow Coma Scale = 3 b),
3. 6 – 12 hodín bez liekov ovplyvňujúcich neuromuskulárny prenos a tlmiacich CNS,
4. neprítomnosť spontánnej ventilácie.
Na stanovenie smrti mozgu je povinné klinické vyšetrenie pacienta (konfirmačný test nie je povinný, komisia ho indikuje podľa uváženia). (16)
Ak sa funkcie dýchania a cirkulácie udržiavajú pomocou prístrojov, smrť mozgu musí jednomyseľne potvrdiť konzílium zložené z:
• ošetrujúceho lekára,
• lekára so špecializáciou v špecializačnom odbore neurológia,
• lekára so špecializáciou v špecializačnom odbore anestéziológia a intenzívna medicína alebo lekára so špecializáciou v špecializačnom odbore anestéziológia a resuscitácia.
Konzílium ihneď po určení smrti mozgu spíše zápisnicu o určení smrti mozgu mŕtveho darcu s bijúcim srdcom. Členom konzília nesmie byť lekár z transplantačného centra. Klinické určenie smrti mozgu treba vykonať dvakrát, a to:
• u detí do jedného roka života s odstupom minimálne 24 hodín
• u detí od jedného roka života do 18 rokov s odstupom minimálne 12 hodín,
• u dospelých nad 18 rokov (docplayer.net) s odstupom minimálne 2 hodín. (17)
Nevyhnutnými kritériami na stanovenie smrti mozgu sú: hlboké bezvedomie, stanovenie mozgovej areflexie, neprítomnosť spontánneho dýchania, neprítomnosť dočasných alebo trvalých kontraindikácií pri akútnej intoxikácii, neprítomnosť kombinácie miechovej lézie a intoxikácie, primárnej hypotermie, metabolického a endokrinného rozvratu.
V prípade nejednoznačného klinického vyšetrenia alebo v prípade, keď nemožno vylúčiť prítomnosť dočasných alebo trvalých kontraindikácii pri akútnej intoxikácii, sa klinická diagnóza smrti mozgu potvrdí konfirmačným testom, a to: jedenkrát vykonanou sériografickou cerebrálnou panangiografiou alebo mozgovou perfúznou scintigrafiou alebo EEG vyšetrením alebo vyšetrením sluchových kmeňových
4 centrá
V SR sa vykonávajú transplantácie orgánov, tkanív a buniek od mŕtvych a živých darcov v 4 transplantačných centrách: v Košiciach, Banskej Bystrici, Martine a v Bratislave.
evokovaných potenciálov. Tieto konfirmačné testy sú alternatívami, stačí vykonať jeden z nich. (18)
Príčiny smrti mozgu rozdeľujeme na intracerebrálne a extracerebrálne:
• Primárne štruktúrne poškodenie mozgu (intracerebrálne príčiny):
○ krvácanie do mozgu,
○ ischemické poškodenie,
○ embólia,
○ kraniocerebrálne poranenia,
○ nádory,
○ abscesy,
○ subdurálne empyémy,
○ fokálne encefalitídy,
○ Wernickeho encefalopatia,
○ centrálna pontínna myelinolýza.
• Zlyhanie cerebrálnej cirkulácie (extracerebrálne príčiny):
○ intoxikácia,
○ ťažká systémová infekcia,
○ metabolické poruchy,
○ hypertenzná encefalopatia,
○ eklampsia,
○ hypertermia a hypotermia. (14)
Mozgová smrť je však spravidla spojená so závažnou instabilitou rôzných systémov fyziologických funkcií, najmä však kardiovaskulárneho systému, respiračného systému, regulácie sympatika a parasympatika, telesnej teploty a mnohých ďalších. Intenzívna medicína má preto za úlohu ovplyvňovať tieto patofyziologické procesy takým spôsobom, aby bolo možné odobrať čo najviac orgánov so zachovanou funkciou pre
TÉMA ČÍSLA 136 inVitro
potreby transplantácie. Kritické zvýšenie krvného tlaku vedie k typickej kardiovaskulárnej odozve. Primárne dochádza k bradykardii, artériovej hypotenzii a neskôr ako následok excesívneho vyplavenia katecholamínov k závažným tachykardiám a hypertenznej kríze. V tomto období dochádza k centralizácii obehu, zvýšenému a erloadu a viscerálnej hypoperfúzii. Táto katecholamínova búrka je posledným kompenzačným mechanizmom, ktorým sa mozog snaží zvýšiť svoju perfúziu. Neskôr dochádza k zastaveniu mozgovej cirkulácie, ktorú pozorujeme klinicky náhlym poklesom tlaku, vymiznutím spontánnej dychovej aktivity, rozvojom diabetes insipidus a progresívnou stratou telesnej teploty. Obdobie rozvoja mozgovej smrti je z hľadiska manažmentu pacienta kľúčové. V jeho priebehu sa priority liečby zásadne menia.
Pri rozvoji klinických známok mozgovej smrti treba aktívne riešiť vzniknutú hypotenziu a hypoperfúziu (nedostatočné prekrvenie tkaniva), sústrediť sa na uchovanie orgánovej funkcie a vytvoriť podmienky na diagnostiku mozgovej smrti podľa zákona. Nestabilita životných funkcií u darcu je dlhodobo známy problém. Metabolická acidóza spolu s hypotermiou a generalizovanou zápalovou odpoveďou sa podieľajú na koagulačných. abnormalitách. Poruchy neuroendokrinného systému vedú k diabetes insipidus, strate hypotonických tekutín a k dysfunkcii myokardu, ďalej k hypotenzii, hypoperfúzii orgánov a k hypernatriémii. Neopatrná tekutinová liečba – spolu so zmenou tenzie v pľúcnych kapilárach – môže viesť k rozvoju pľúcneho edému.
V snahe o štandardizáciu procesov boli konsenzom určené tieto cieľové hodnoty: pravidlo 4 × 100: systola minimálne 100 torr, diuréza minimálne 100 ml/hod., pO2 v ABR minimálne 100 mmHg, Hb minimálne 100 g/l. (19)
Asi najpraktickejším a jednoduchým odporúčaním je snažiť sa vo všetkých parametroch priblížiť k normálnym hodnotám. (2, 14)
Záver
Je nesporné, že darovanie orgánov pre účely záchrany ľudského života predstavuje pre spoločnosť i jednotlivca vysokú morálnu hodnotu.
Transplantácie orgánov predstavujú jeden z najväčších úspechov lekárskych vied 20. storočia. Pozoruhodná úspešnosť transplantácií orgánov je výsledkom pokroku v medicínskom a farmaceutickom výskume a v medicínskej technike, ako aj v rozvoji transplantačnej imunológie a účinnej imunosupresívnej liečby.
Literatúra
1. Zdroj z internetu :https://www.vatican.va/content/ john-paul-ii/it/speeches/1991/june/documents/ hf_jp-ii_spe_19910620_trapianti.html
2. BREZA, J. – ŽILINSKÁ, Z. a kol. Transplantácia obličky. Bratislava: Cofin, 2020. 289s
3. BREZA, J. 40. Výročie prvej transplantácie obličky na Slovensku. Lek. Obzor. 2012, 61(6): 187 – 189
4. MATINKOVÁ, J. a kol. Mozgová smrť – medicínske aspekty, legislatívne normy v Slovenskej republike. In Neurologie pro praxi. 2015, roč. 16, č. 3, s. 140 – 143.
5. Zdroj z internetu ( https://www.epi.sk/vestnikmzsr/2007-1
6. Zdroj z internetu: https://www.zakonypreludi.sk/ zz/2004-576
7. Pozri § 43 zákona č. 576/2004 Z. z. o zdravotníckej starostlivosti v znení neskorších predpisov
8. Uverejnené vo Vestníku MZ SR, čiastka 1-2/1997
9. Zdroj z internetu: https://www.udzs-sk.sk/ documents/14214/82174/MU+%C4%8D.+01-012015+o+odbere+tkan%C3%ADv+a+buniek+z+m %C5%95tvych+darcov+na+pracovisk%C3%A1ch +%C3%BAradu.pdf
10. DRGONEC, J.-HOLLÄNDER, P. Moderná medicína a právo. Bratislava: OBZOR, 1998. 125s.
11. CEHLÁROVÁ, Ľ.: Darcovstvo ľudských orgánov a transplantácie z pohľadu noriem správneho práva, Košice, UPJŠ, 2008, s. 547 – 558.
12. Pozri Článok 7 ods. 2 odborného usmerenia MZ SR č. 2861/2006
13. LACA, Ľ.: Súčasná legislatíva transplantácií orgánov, tkanív a buniek. In: Orgánové transplantácie: multidisciplinárny časopis pre transplantačnú problematiku. 2005, č. 2, s. 1 – 5.
14. Beňa, Ľ. a kol. Manuál transplantačného koordinátora. Martin: Osveta, 2010. 88s
15. DEDINSKÁ, I. – MIKLUŠICA, J. Základy pre odber orgánov a transplantácie obličiek. Vysokoškolské skriptá, 2014.
16. Zdroj z internetu: https://www. transplant.sk/sites/default/files/field_ downloads/2020-05-21/Manu%C3%A1l_ transplanta%C4%8Dn%C3%A9ho_ koordin%C3%A1tora.pdf
17. Zdroj z internetu : Odborné usmernenie Ministerstva zdravotníctva Slovenskej republiky o darcovstve, odberoch ľudských orgánov z tiel živých a mŕtvych darcov, o testovaní darcov a o prenose ľudských orgánov na príjemcu. Číslo: 28610/2006 – OZSO zo dňa 3. 1. 2007
18. Zdroj z internetu : Odborné usmernenie Ministerstva zdravotníctva Slovenskej republiky o darcovstve, odberoch ľudských orgánov z tiel živých a mŕtvych darcov, o testovaní darcov a o prenose ľudských orgánov na príjemcu. Číslo: 28610/2006 – OZSO zo dňa 3. 1. 2007
19. Zdroj z internetu: https://www.wikiskripta.eu/w/ Transplantologie/S%C5%A0_(sestra)
Náhle úmrtia Unilabs Slovensko 137
LBC metódou BD SurePath
Pokrok nastáva aj v LBC cytológii – LBC vyšetrenie metódou BD SurePath nahradilo predošlú metódu ThinPrep! Čo všetko táto metóda pre včasné zachytenie prekanceróznych stavov krčka maternice znamená? Prináša niekoľko nesporných výhod aj pre vaše pacientky.
Jednoznačné výhody
metódy BD SurePath:
• Skorší a vyšší záchyt rakoviny krčka maternice ako konvenčná cytológia či LBC založená na Thin-Prep technológii – preukázané štúdiami!
• Štatisticky významný nárast detekcie prekanceróznych lézií krčka maternice všetkých stupňov – v porovnaní s konvenčnou cytológiou, ako aj s metódou ThinPrep.
• Reprezentatívna a diagnosticky ľahšie čitatelná vzorka buniek patológovi umožňuje jednoduchšie a presnejšie rozlíšiť cytologické abnormality.

• Stačí nízky podiel atypických skvamóznych buniek neznámeho pôvodu vyselektovaných vo vzorke – v porovnaní s klasickou i ThinPrep technológiou.
• Metóda BD SurePath má nízky podiel vzoriek vyradených zo spracovania kvôli nedostatočnej kvalite vzorky v porovnaní s inými technológiami – nižšia pravdepodobnosť opakovaného odberu.
• U pacientok s negatívnym cytologickým nálezom sa dá touto metódou získať aj biologicky cenný materiál na stanovenie prítomnosti vírusu HPV.
Pre poistenky ZP Union a ZP Dôvera je LBC vyšetrenie plne hradené zdravotnou poisťovňou, a to nielen v rámci preventívnych prehliadok, ale aj pri zápalových a chorobných procesoch.
V prípade akýchkoľvek otázok sa obráťte na vášho medicínskeho reprezentanta.
www.unilabs.sk
Unilabs Slovensko je zatiaľ jediná spoločnosť na Slovensku, ktorá realizuje LBC touto technológiou!
Laboratórna diagnostika


















PRAKTICKÁ PRÍRUČKA/ TECHNICKÁ PRÍRUČKA 2 Unilabs Slovensko – partner č. 1 v laboratórnej diagnostike 3 Procesná mapa 4 1. Žiadanka a objednanie vyšetrení 5 Vyplnenie žiadanky 6 Výber vyšetrení 6 Značenie vzoriek 9 Telefonické doobjednanie 10 Biochémia a hematológia 19 Imunológia a alergológia 26 Mikrobiológia 38 Genetika 42 Patológia 45 2. Odber 46 Žiadanka na odberový materiál 47 3. Transport 48 Mapa pokrytia zvozovými trasami 50 4. Registrácia a príprava vzorky 52 5. Komplexná diagnostika 54 6. Kvalita a akreditácia 56 7. Analýza 62 8. Validácia a distribúcia výsledkov 63 Výsledkový list 64 9. Kontakty 65 Manažment 68 Sieť laboratórií a pracovísk
Unilabs Slovensko – partner č. 1 v laboratórnej diagnostike
Unilabs Slovensko predstavuje komplexnú modernú laboratórnu diagnostiku s vysokou kvalitou a širokou dostupnosťou. Naše služby poskytujeme prostredníctvom siete viac než 70 laboratórií na území celého Slovenska. V súčasnosti ponúkame viac než 2 200 vyšetrení v odboroch klinická biochémia, hematológia a transfúziológia, klinická imunológia a alergológia, klinická mikrobiológia, lekárska genetika a patologická anatómia, pričom výsledky rutinných vyšetrení dodávame lekárom do 24 hodín.
nej a externej kontroly kvality postupne prechádza akreditáciou jednotlivých laboratórií, ktorá je zárukou spoľahlivosti výsledkov laboratórnych vyšetrení. Na odber biologického materiálu poskytujeme bezplatne potrebný odberový materiál a transport vzoriek realizujeme vlastnou dopravnou službou. Zabezpečujeme tak dohľad nad dodržaním podmienok predanalytickej fázy po odbere vzorky v súlade so správnou laboratórnou praxou.
Vďaka tomuto prístupu vieme pacienta odbremeniť od zbytočnej traumatizácie z nutnosti viacnásobného odberu vzorky, znížiť čas potrebný na vyšetrenie a v konečnom dôsledku napomáhame efektívne realizovať zdravotnú starostlivosť.










Máme záujem aj o vzdelávanie budúceho personálu laboratórií. V spolupráci so Slovenskou zdravotníckou univerzitou sa tak naše pracovisko – centrálne laboratórium v Bratislave – stalo spoločnou výučbovou základňou. Zdravotnícki pracovníci, ktorí si zvyšujú svoju kvalifi káciu, tak získavajú odborné vedomosti a zručnosti v laboratórnych disciplínach pod kvalifi kovaným a odborným vedením našich špecialistov.
Kontinuálne rozširujeme paletu vyšetrení, zavádzame moderné metódy diagnostiky v súlade so svetovými trendmi. Vyvíjame maximálne úsilie na to, aby naša diagnostika bola účinným a efektívnym nástrojom v rukách klinických lekárov. Využívame pritom poslednú generáciu prístrojovej techniky od svetovo renomovaných výrobcov a aplikujeme výlučne technológie certifikované Európskou úniou.






Denne v našich laboratóriách vyšetríme vzorky od 12 500 pacientov, ktorým zrealizujeme vyše 90 000 vyšetrení. Takýto výkon je možné dosiahnuť iba dokonalým zvládnutím všetkých potrebných procesov od odberu vzorky až po doručenie výsledku s permanentným monitorovaním kvality a výkonu každej etapy tohto procesu. Unilabs Slovensko okrem inter-









Spolupracujeme s odborníkmi vo všetkých medicínskych odboroch doma i v zahraničí. Naši zamestnanci sa aktívne vzdelávajú a sledujú trendy a inovácie v oblasti laboratórnej diagnostiky. Spolupracujeme s nemocnicami či svetovo renomovanými výrobcami liekov na odborných klinických štúdiách, naši zástupcovia prednášajú doma i v zahraničí na odborných fórach.
Kontinuálny rast spoločností združených v Unilabs Slovensko nám umožňuje širokú interdisciplinárnu spoluprácu naprieč jednotlivými pracoviskami, ako aj veľmi rýchle zavádzanie nových diagnostických postupov do klinickej praxe. Samozrejmosťou je poskytovanie odborných konzílií či konzultačných služieb.
Spoločnosť Unilabs Slovensko je zmluvným partnerom všetkých zdravotných poisťovní na Slovensku. Naše služby poskytujeme 80 nemocniciam a poliklinikám a viac než 7 tisíckam lekárov.
Laboratórna diagnostika 2
Procesná mapa
Predanalytická fáza
Vysvetlivky NIS – nemocničný informačný systém AIS – ambulantný informačný systém TAT – turn around time, čas odozvy, čas od objednania vyšetrenia po doručenie výsledku lekárovi
Analytická fáza






















1. Žiadanka a objednanie vyšetrení Priamo z NIS a AIS
2. Odber Kompletný odberový materiál zdarma: uzatvorený, transportné pôdy, ostatné odberové médiá
3. Transport Bezplatný zvoz niekoľkokrát denne
4. Registrácia a príprava vzorky Unikátny čiarový kód
5. Komplexná diagnostika Vyšetrenia v širokej palete odborov LD vrátane možnosti doordinovania vyšetrení
9. Kontakty Medicínski reprezentanti Sieť laboratórií a pracovísk
8. Validácia a distribúcia výsledkov Dvojstupňová kontrola výsledkov a ich odoslanie
Postanalytická fáza
7. Analýza Veľkokapacitné analyzátory, vysoký stupeň automatizácie, krátke TAT
6. Kvalita a akreditácia EN: ISO 15189:2012






Laboratórna diagnostika 3
Vyplnenie žiadanky – zoznam základných informácií o pacientovi
Hlavička
– hlavička žiadanky je miesto na zadanie základných informácií o pacientovi; dôležité je, aby boli tieto údaje čitateľne vyplnené, pretože sú potrebné na identifikáciu pacienta, pridelenie správneho intervalu referenčných hodnôt, ktoré sú rozlíšené podľa veku, pohlavia a pod.
Priezvisko a meno pacienta
Platiteľ
– číselný kód poisťovne v prípade, že sú vyšetrenia hradené zo ZP
– samoplatca, ak sú vyšetrenia hradené na priamu platbu; v tomto prípade treba uviesť, komu výkony fakturovať (pacientovi alebo lekárovi) a fakturačnú adresu uviesť v kolónke „dôležité poznámky“
– uviesť názov pracovnej zdravotnej služby v prípade, že sú vyšetrenia hradené cez PZS
Nie je oslobodené od DPH – začiarkne sa v prípade samoplatcu, ktorého vyšetrenia nie sú realizované v rámci zdravotnej starostlivosti – vyšetrenia na plastické operácie, ktoré nie sú robené zo zdravotných dôvodov, potvrdenia na zbrojný preukaz, vodičský preukaz, laboratórne vyšetrenia potrebné na prácu do zahraničia a pod.; od DPH nie sú oslobodené ani vyšetrenia pre veterinárnych lekárov
ŽIADANKA O VYŠETRENIE − KLINICKÁ BIOCHÉMIA A HEMATOLÓGIA
Rodné číslo pacienta
Platiteľ
Rodné číslo kód ZP, samoplatca,PZS
Priezvisko
Ulica, číslo domu*
PSČ*
IČ EÚ
Oslob. od DPH áno nie
Fakturovať lekár pacient
Meno Samoplatca – e-mail
Mesto/obec*
priložiť kópiu preukazu poistenca
Dátum narodenia Dátum a čas odberu
Dg. (MKCH)
Pečiatka a podpis ordinujúceho lekára – v prípade úhrady vyšetrenia cez ZP je tento údaj povinný
Užívané lieky
Dôležitá poznámka
Diuréza
Hebd. ml/ hod.
Výška
Hmotnosť
MC t.
cm
kg
Kód krajiny
Pohlavie muž žena
Dátum vystavenia žiadanky
Kód hospit. prípadu
Podpis a pečiatka ordinujúceho lekára
Odporúčajúci lekár Meno a priezvisko A kód P kód
n Nepovoliť sprístupnenie výsledku v EZKO
* adresu pacienta žiadame vyplniť v prípade samoplatcu alebo vyšetrení hlásených v zmysle zákona č. 355/2007 Z. z.
Hormóny štítnej žlazy
n S − TSH (TSH)
01
Krv na sérum
Krv na sérum 2 (záťažové testy)
1E
ZÁKLADNÁ BIOCHÉMIA (SÉRUM)
Metabolity
n S − Glukóza (GLU)
n S − Glukóza po jedle (GLUPJ)
n S − Močovina (UREA)

n S − Kreatinín (KREATE)
n S − Cystatín C (CYSC)
n S − Kyselina močová (KM)
n S − Celkové bielkoviny (TP)
n S − Albumín (ALB)
Štandardne budú výsledky laboratórnych vyšetrení nahrané do NZIS. Ak lekár požaduje, aby neboli okamžite sprístupnené na nahliadnutie pacientovi cez elektronickú zdravotnú kartu občana, vyznačí tento fakt prostredníctvom doplneného poľa (štandardne sa predpokladá, že nezávisle od vôle indikujúceho lekára sa tak stane po 10 kalendárnych dňoch).
n S − Bilirubín celkový (TBIL)
n S − Bilirubín konjugovaný (DBIL)
n S − Fruktózamín (FZA)
Krv s EDTA (BNP, HCY, REN)
E2,M2
Krv na renín a homocysteín je potrebné po odbere transportovať na ľade.
n S − T3 voľný (FT3)
Dátum a čas odberu vzorky – dôležitý údaj z hľadiska zabezpečenia predanalytickej fázy
n S − T4 voľný (FT4)
n S − T3 celkový (CT3)
n S − T4 celkový (CT4)
n S − Tyreoglobulín (TG)
n S − aTG / Tyreoglobulín
– autoprotilátky (ATG)
n S − aTPO / Tyreoperoxidáza – autoprotilátky (ATPO)
Krv s EDTA 02
n Saturácia transferínu (STRF)
n S − Solubilný transferínový receptor (STR)
n S − Feritín (FER)
n S − Haptoglobín (HAPT)
IMUNOLÓGIA
Základná imunológia
n S − IgA (IGA)
n S − IgM (IGM)
n S − IgG (IGG)
n S − IgE (IGE)
n S − C3 komplement (C3)
n S − C4 komplement (C4)
n S − TSI / Tyreoideu stimulujúci imunoglobulín (TSI)
Fertilita
n S − Anti Műllerian hormón (AMH)
n S − Luteinizačný hormón (LH)
n S − FSH (FSH)
n S − Estradiol (EST)
n S − Progesterón (PROG)
n S − Prolaktín (PRL)
n S − Testosterón (TTE)
n S − SHBG (SHBG)
n Voľný estradiol (FEST)
n Biologicky dostupný estradiol (BAEST)
n S − Žlčové kyseliny (ZLK)
Odhad GF
n GF podľa Cockroft & Gaulta (COC)
n GF podľa Schwartza (do 18 rokov) (SCHWARZ)
n GF podľa CKD EPi (CKDEPI)
n GF z cystatínu C (GFCYSC)
Elektroforéza bielkovín
Dátum narodenia a pohlavie – vypĺňa sa v prípade, ak z rodného čísla, resp. IČ poistenca nie je možné určiť dátum narodenia, resp. pohlavie pacienta
n S − Elektroforéza bielkovín (ELFO)
n S − Imunoelektroforéza (IELFO)
Enzýmy
n S − AST (AST)
Adresa pacienta
n S − ALT (ALT)
n S − GGT (GMT)
n S − Cirkulujúce imunokomplexy (CIK)
Zápalové markery
Diagnózy – treba uviesť všetky relevantné diagnózy, najmä v prípade, ak sú ordinované špeciálne vyšetrenia, ktoré poisťovňa hradí len pri konkrétnych diagnózach
n S − CRP (CRP)
n S − CRP hs (CRPHS)
n S − Reumatoidný faktor (RF)
n Androgénny index (FTAI)
n Voľný testosterón (FTTE)
n Biologicky dostupný testosterón (BATTE)
n S − 17-OH-progesterón (17OH)
n S − DHEA-sulfát (DHEA)
IČ EÚ a kód krajiny
n S − Prokalcitonín (PCT)



n S − Interleukín 6 (IL6)
n S − Prealbumín (PREALB)
n S − Beta-2-mikroglobulín (B2M)
Markery streptokokovej infekcie
n S − ASLO (ASLO)
n S − ADNáza B (ADNS)
Špecifické bielkoviny
n S − Androstendión (ANDD)
Iné hormóny
n S − Pregnenolón (PREG)
n S − Aldosterón v ľahu (ALDL)
n S − Aldosterón v stoji (ALDS)
n P − Renín v ľahu (odber do EDTA) (RENL)
n P − Renín v stoji (odber do EDTA) (RENS)
n Pomer aldosterón-renín (ARR)
HEMATOLÓGIA n B − Krvný obraz (KO) n B − Krvný obraz s diferenciálom (KO5) n B − Retikulocyty (RTC)
GLYKOVANÝ HEMOGLOBÍN n B − HbA1c (HBA1C)
n S − ALP (ALP)
n S − ALP izoenzýmy (ALPIZO)
n S − Amyláza (AMS)
n S − Pankreatická amyláza (PAMS)
n S − Lipáza (LIPA)
n S − Cholínesteráza (CHE)
n S − Laktátdehydrogenáza (LD)
– treba vyplniť u všetkých pacientov, aby sme v prípade pozitivít na prenosné ochorenia predišli zdržaniu v procese včasného nahlásenia na RÚVZ
n S − CK (CK)
n S − CK-MB (CKMBI)
n S − Angiotenzín konvertujúci enzým (ACE)
n S − HBDH (HBDH)
Lipidy
n S − Cholesterol (CHOL)
n S − HDL cholesterol (HDL)
n S − LDL cholesterol (LDL)
n S − Alfa-1-antitrypsín (A1AT)
n S − Alfa-2-makroglobulín (A2M)
– vyplniť v prípade, že ide o poistenca, ktorý má preukaz európskeho poistenca, resp. nemá poistenie v SR (k žiadanke treba priložiť kópiu preukazu poistenia)
n S − Alfa-1-kyslý glykoproteín (AAG)
n S − Ceruloplazmín (CER)
n P − Homocysteín (odber do EDTA) (HCYP)
Kardiálne markery
n S − Troponín I hs (TNIHS)
n S − Troponín T hs (TNTHS)
n S − Myoglobín (MYO)
n S − NT-proBNP (NTBNP)
n P − BNP (odber do EDTA) (BBNP)
ŠPECIÁLNE VYŠETRENIA Vitamíny
n S − Vitamín B12 (B12)
n S − Vitamín B12 aktívny (B12A)
n S − C-peptid (CPEP)
n S − C-peptid po záťaži (CPEPZ)
n S − Inzulín (IRI)
n S − Inzulín po záťaži (IRIZ)
n HOMA – IR (inzulínová rezistencia) (IR)
n S − Kortizol ranný odber (KORR)
n S − Kortizol poobedný odber (KORP)
n S − Somatotropín (STH)















n S − IGF-1 (IGF1)
n S − IGFBP-3 (IGFBP3)
n S − Kalcitonín (KALC) n S − Parathormón (intaktný) (PTH) n S − Erytropoetín (EPO) n S − Gastrín (GASTR) n S − Serotonín € (SER)
Klinické informácie – diuréza, výška, váha, fáza menštruačného cyklu, týždeň tehotenstva, užívané lieky, ktoré môžu mať vplyv na výsledok vyšetrenia; každá položka je označená piktogramom, ktorý je zobrazený pri vyšetrení, ktoré túto informáciu vyžaduje; ak je ordinované vyšetrenie označené niektorým piktogramom, treba vyplniť požadovanú klinickú informáciu
Krv s NaF/NA2EDTA 14
METABOLITY n P − Glukóza (PGLU) n P − Glukóza po jedle (PGLUPJ) n P − Laktát (LAC)
Dôležitá poznámka – pobyt v zahraničí, rizikové sexuálne správanie, HCV pozitivita a podobne
Krv s citrátom 03
HEMOKOAGULÁCIA n P – PT-ratio (PTR)
n P − INR (liečení pacienti) (INR)
n P − APTT-ratio (APTR)
n P − Fibrinogén (FIB) n P − Trombínový čas-ratio (TTR)
Laboratórna diagnostika 5
www.unilabs.sk, info@unilabs.sk
Platná od 1. 2. 2021
n
n
P − Antitrombín III (AT3)
V závere každej žiadanky sme pridali text súvisiaci s ochranou osobných údajov (GDPR) a miesto na podpis pacienta.
1
Hlavička niektorých žiadaniek môže obsahovať aj ďalšie povinné údaje, napr. telefónne číslo, e-mailovú adresu, dátum očkovania a podobne.
Výber vyšetrení
Podrobnosti o odberovom materiáli, o spôsobe a podmienkach odberu nájdete na našich webových stránkach alebo sa môžete informovať v call centre či u medicínskych reprezentantov.
Výber požadovaných vyšetrení na Žiadanke o vyšetrenie – preventívna prehliadka, základné vyšetrenia
4. Ak sa rozhodnete u pacienta realizovať preventívnu prehliadku a zároveň žiadate vyšetriť parametre, ktoré nie sú jej súčasťou, odber potrebnej vzorky realizujete iba jedenkrát. Čiarové kódy, prosíme, nalepte na 1. stranu Žiadanky o vyšetrenie – preventívna prehliadka, základné vyšetrenia a:
• doplňte kód diagnózy podľa platného zákona č. 160/2013 Z. z.,
















• vyznačte navyše požadované vyšetrenie. Ak žiadate vyšetriť parameter, ktorý sa stanovuje z iného druhu vzorky, ako je obsiahnutý v preventívnej prehliadke, zrealizujte potrebný odber biologického materiálu a nalepte čiarový kód na príslušné miesto žiadanky.
1. Na realizáciu laboratórnych vyšetrení patriacich do príslušnej preventívnej prehliadky treba vyznačiť krížikom požiadavku na prehliadku, odobrať vždy materiál vyznačený podľa príslušnej špecializácie indikujúceho lekára a nalepiť čiarové kódy na 1. stranu Žiadanky o vyšetrenie – preventívna prehliadka, základné vyšetrenia.
pacient Ulica, číslo domu* Dg. (MKCH) Kód hospit. prípadu
Značenie vzoriek
kg Podpis pečiatka ordinujúceho lekára
adresu pacienta žiadame vyplniť prípade samoplatcu alebo vyšetrení hlásených zmysle zákona 355/2007 Z. z. n
musí byť
n

Moč ranný ERYTROCYTOV n n n
V RANNOM MOČI n U − Amyláza
ZÁKLADNÁ BIOCHÉMIA Metabolity n Glukóza n n Cystatín Kyselina močová (KM) n Celkové bielkoviny n n Výpočtové parametre n GF podľa Cockroft Gaulta n n Enzýmy n AST n n Amyláza Pankreatická amyláza (PAMS) VYŠETRENIA STOLICE n Lipidy (AI1)
n n Preeklampsia n n €
(ASLO) n Reumatoidný faktor HORMÓNY Celkový hCG (HCG) n Voľný beta-hCG n n –Hormóny štítnej žľay n TSH n Onkomarkery n AFP n Celkový hCG n INFEKČNÁ SÉROLÓGIA n Anti HCV IgG (HCV) n HBsAg n RRR, anti Treponema pallidum n n n n n Triacylglyceroly Index LDL/HDL Index CHOL/HDL n n Minerály stopové prvky (NA) n Draslík n n Metabolizmus železa hemoglobínu n Železo n (STRF) IMUNOLÓGIA IgA IgM (IGM) n IgG SPOLU VYŠ. Viac informácií spracovaní vašich osobných údajov právach nájdete https://www.unilabs.sk/ochrana-udajov
2. Ak žiadate o jednotlivé vyšetrenia, môžete použiť ktorúkoľvek z našich žiadaniek, pričom ak ide o základné vyšetrenia, odporúčame vám využiť 2. časť Žiadanky o vyšetrenie – preventívna prehliadka, základné vyšetrenia. Pri odbere, prosíme:
• doplňte diagnózu pacienta,

• vyznačte požiadavku na vyšetrenie krížikom v žiadanke,
• nalepte – tak ako je obvyklé – čiarový kód na príslušné miesto žiadanky a na skúmavku so vzorkou.
3. V zmysle platnej legislatívy by mal lekár pacientovi zrealizovať preventívne vyšetrenie v stave, keď nejaví objektívne ani subjektívne žiadne znaky choroby či zdravotných problémov. To znamená, že v prípade realizácie preventívnej prehliadky by ste v čase odberu nemali vyžadovať iné laboratórne vyšetrenia.
Označovanie vzoriek prešlo do predanalytickej fázy, čím sa znížilo riziko zámeny vzorky na minimum. Čo je však oveľa dôležitejšie, značenie vzoriek klasickými papierovými štítkami sme vo väčšine odberov nahradili čiarovými kódmi (tzv. barcode). Tento spôsob identifikácie eliminuje možnosť zámeny vzorky, je manuálne menej náročný a vďaka bezplatnému dodávaniu čiarových kódov predstavuje aj úsporu nákladov na strane odosielateľa.
Písomné žiadanky
Pri písomných žiadankách sa využíva tzv. dvojitý barcoding. Lekár od nás získava pás samolepiacich čiarových kódov, kde je každý kód dodávaný v páre – menší a väčší.


Jedinečné čiarové dvojkódy na papierovú žiadanku
Dvojkódy štandardné
Dvojkódy malé
Laboratórna diagnostika 6
ŽIADANKA O VYŠETRENIE – PREVENTÍVNA PREHLIADKA, ZÁKLADNÉ VYŠETRENIA PREVENTÍVNA PREHLIADKA Náplň preventívnych prehliadok uhrádzaných verejného zdravotného poistenia podľa prílohy zákona č. 577/2004 Z. rozsah požadovanej diagnostik ZÁKLADNÉ VYŠETRENIA (0 15 r.), diagnóza Z00.1 špecializácii gynekológia pôrodníctvo 009, diagnóza Z01.4 V špecializácii všeobecné lekárstvo 020 (od 18 r.), pediatria 007 vš. starostlivosť dorast 008 (od 17 r.), diagnózy Z00.0, Z00.1, Z52.0 reg. značka: ŽoV/03/2023/09 Platná od 15.3.2023 01 Krv na sérum Krv na sérum 04 Moč ranný Moč ranný 07 10 Sedimentácia 02 n n n n Fibrinogén (FIB) n Trombínový
Po vyplnení záhlavia žiadanky s identifi káciou pacienta a žiadateľa:
Jednotlivé skúmavky s odobratým materiálom sa označia po dĺžke skúmavky dlhšou časťou čiarového kódu s doplneným menom pacienta. Druhá, menšia časť kódu sa nalepí na žiadanku do farebného obdĺžnika, ktorý je umiestnený vždy nad blokom vyšetrení, ktoré možno vyšetriť z 1 odberu (z 1 skúmavky, z 1 tampónu, v 1 médiu…).




Aplikácia čiarových dvojkódov




NESPRÁVNE označená skúmavka





















SPRÁVNE označená skúmavka

Laboratórna diagnostika 7
Vypíšte meno pacienta a odlepte nálepku z podkladového pásu.
Časť s menom nalepte na skúmavku.
Oddeľte jednotlivé diely nálepky v mieste perforácie.
1 3 2 4
Druhú časť nalepte na žiadanku do políčka požadovaného vyšetrenia.
1
KEDY POUŽIŤ MALÉ ČIAROVÉ KÓDY
Malé čiarové kódy sa používajú na označenie vzoriek, z ktorých sa realizujú nasledujúce vyšetrenia do tzv. malých odberových súprav:
• glukóza z kapilárnej krvi
(813805 – Skúmavka s KF + Na2 250 l),
• CRP z kapilárnej krvi – odberový materiál je k dispozícii priamo v nemocničných laboratóriách,
• sedimentácia
(14250 – Skúmavka NC 1,6 ml),




















• pediatrická biochémia
(810176 – Skúmavka s gélom 800 µl – ped.),
• pediatrický krvný obraz (813510 – Skúmavka K2EDTA 500 µl – ped.).

Požadované vyšetrenia sa vyznačia krížikom vo štvorčeku pred príslušným vyšetrením. Farba obdĺžnika zodpovedá farbe uzáveru odberovej skúmavky (skúmavky Vacutest, skúmavky s transportným médiom, sterilnej skúmavky), do ktorej treba materiál odobrať. Vo farebných rámikoch môžu byť uvedené ďalšie dôležité údaje – množstvo vzorky, ktoré treba odobrať, typ antikoagulačného činidla alebo transportného média, respektíve teplota, pri ktorej treba uchovať vzorku po odbere.
Elektronické žiadanky
Sme prvá a zatiaľ jediná spoločnosť na Slovensku, ktorá ambulantnýn lekárom ponúka možnosť využívať elektronické žiadanky prostredníctvom modulu v ambulantnom informačnom systéme (AIS). Táto jedinečná výhoda umožňuje ambulancii efektívny manažment pacientov v čase odberov, znižuje chybovosť, šetrí čas a v konečnom dôsledku skracuje proces diagnostiky. Modul elektronickej žiadanky zároveň obsahuje systém indikačných pravidiel, ktorý je aktualizovaný našou spoločnosťou, a tak lekárovi zjednodušuje orientáciu v pravidlách 3 zdravotných poisťovní. Funkcionalitu elektronickej žiadanky možno využívať až po doplnení technického vybavenia (kúpa SW modulu v AIS a čítačky čiarových kódov). Unilabs Slovensko prepláca tieto náklady na základe dohody u tých lekárov, ktorí odosielajú vzorky vo vyššom počte. V prípade záujmu nás kontaktujte na SK-obchod@unilabs.com.

Aktuálny stav AIS a NIS umožňujúcich takéto prepojenie s naším laboratórnym systémom (LIS) nájdete na www.unilabs.sk/elektronicke-sluzby.
V prípade elektronických žiadaniek stačí jeden dlhší čiarový kód doplnený o meno pacienta, ktorý je po nalepení na vzorku ihneď po odbere v ambulancii nasnímaný čítačkou čiarových kódov.
Jedinečné čiarové dvojkódy na elektronickú žiadanku
STATIM značenie
Zatiaľ čo bežné vzorky sa označujú bielym čiarovým kódom, prioritné vzorky STATIM sa označujú červeným kódom a sú používané výlučne v elektronickej žiadanke ako jednokód.
Indikácie na tieto vyšetrenia musia byť zo strany žiadateľa opodstatnené. Čas dodania výsledku sa pohybuje v závislosti od typu požadovaného parametra od 15 do 60 minút.
V prípade záujmu o prihlásenie do laboratórneho systému (výsledky aj žiadanky) používajte, prosíme, AlphaLAB (aktuálne spúšťame unilabs.pro – novšiu a vylepšenú verziu systému AlphaLAB).
V prípade akýchkoľvek otázok sa, prosíme, obráťte na vášho medicínskeho reprezentanta alebo na call centrum 0850 150 000.
Laboratórna diagnostika 8
EDI Jednokódy červené – STATIM
EDI Jednokódy biele – RUTINA
EDI Jednokódy malé
DÔLEŽITÉ UPOZORNENIE
Biologický materiál a žiadanky od HBsAg, HCV alebo HIV pozitívnych pacientov musia byť výrazne označené, najlepšie červenými písmenami (napríklad HBsAg pozit.), pričom materiál musí byť uložený do transportného vrecúška samostatne.
Skúmavka na vyšetrenie krvnej skupiny + RhD faktora a antierytrocytárnych protilátok musí byť pri čiarovom kóde vždy doplnená aj menom, priezviskom a rodným číslom pacienta.
Prípadné užívanie liekov treba napísať na žiadanku. Ak je odber robený deň dopredu, treba tento fakt uviesť na žiadanke. Niektoré parametre môžu byť v takom prípade vyradené z procesu analýzy, a tak vyšetrenia nebudú realizované.
Legenda a iné údaje
Vyšetrenia s červeným podfarbením je možné objednať len na základe predchádzajúcej individuálnej dohody s kontaktným laboratóriom.
Vyšetrenia nie sú hradené zo zdravotného poistenia. Je možné ich objednať len na priamu platbu.
Kontrolný súčet ordinovaných vyšetrení
Podľa najnovších pokynov zdravotných poisťovní treba uvádzať aj kontrolný súčet ordinovaných vyšetrení.
Telefonické doobjednanie
















Ošetrujúci lekár, prípadne ním poverená zdravotná sestra, môže dodatočne telefonicky doordinovať vyšetrenie niektorých parametrov z už odobratej krvi, ktorá bola dodaná do nášho laboratória. Telefonické doordinovanie možno veľmi pohodlne realizovať prostredníctvom call centra (0850 150 000), ale iba z telefónneho čísla nahláseného lekárom ako súčasť verifi kačných údajov, ktoré umožňujú identifi kovať volajúceho.
Pri doordinovaní vyšetrenia treba zohľadniť stabilitu požadovaného parametra pri skladovaní za daných podmienok, pôvodný dátum odberu vzorky, ako aj dobu skladovania vyšetrených vzoriek v laboratóriu. Záznam o doordinovaní bude uvedený aj na výsledkovom liste v rámci komentára k žiadanke.
Vyšetrenia koagulačných parametrov a vyšetrenia krvného obrazu je možné doordinovať pri dodržaní špecifických podmienok stability vzorky. Vyšetrenia zo séra a zbieraného moču sa môžu dodatočne objednať najneskôr do dvoch pracovných dní (48 hodín) od doručenia vzorky do laboratória. Je to doba, počas ktorej sa vyšetrené vzorky séra a moču skladujú.
Takmer všetky vyšetrované parametre stanovované zo séra sú stabilné pri chladničkovej teplote 2 – 8 °C, a to najmenej 2 dni (s výnimkou niektorých mimoriadne citlivých parametrov, ktoré sú nestabilné).



Naše laboratóriá majú vypracované pracovné postupy pre možnosť doordinovania jednotlivých parametrov. V prípade nesplnenia týchto podmienok nemôžeme doordinovanie akceptovať, o čom bude ošetrujúci lekár ako objednávateľ vyšetrení telefonicky informovaný.
Ordinovanie vyšetrení, ktoré nie sú v ponuke Unilabs Slovensko
V prípade, že vyšetrenie na žiadanke nie je uvedené, klient napíše svoju požiadavku do kolónky „Iné vyšetrenia“. Zároveň sa telefonicky informuje v laboratóriu o možnostiach transportu do iného laboratória mimo siete Unilabs Slovensko. Spoločnosť Unilabs Slovensko zabezpečuje odvoz biologického materiálu potrebného na tieto vyšetrenia len na pracoviská, ktoré sa nachádzajú v rámci existujúcich zvozových trás Unilabs Slovensko. Za kvalitu a doručenie výsledkov z iných ako vlastných pracovísk reťazec Unilabs Slovensko nepreberá zodpovednosť.
Laboratórna diagnostika 9
€ 1
Biochémia a hematológia
Spoločnosť Unilabs Slovensko má najviac skúseností práve v odbore klinickej biochémie, kde dnes ponúka viac než 900 vyšetrení.
S výnimkou niektorých špeciálnych vyšetrení sú výsledky lekárom k dispozícii do 24 hodín a samozrejmosťou je poskytovanie urgentnej diagnostiky vo všetkých laboratóriách spoločnosti.
Rutinné vyšetrenia a testy pokrývajú:
• pečeňové testy,
• obličkové testy,
• hormonálne testy,





• posúdenie metabolizmu minerálov a sacharidov,
• poruchy lipidového spektra,
• markery zápalu a sepsy,


• onkomarkery,
• kostné markery,
• stanovenie vitamínov.
Naše laboratóriá lekárom rutinne ponúkajú kompletnú paletu základných vyšetrení potrebnú na diagnostiku ochorení:
– dýchacej sústavy,

– kardiovaskulárnej sústavy,
– tráviacej sústavy,




– močovej sústavy,
– žliaz s vnútorným vylučovaním,
– pohlavnej sústavy.
Naša ponuka vyšetrení pokrýva aj vysoko špecifické potreby lekárov – špecialistov, ako sú napríklad:
– diagnostika v oblasti porúch fertility (vyšetrenia hormonálnych profilov a vitamínov, protilátky proti ováriám a spermiám, anti Müllerian hormón (AMH) – komentovaný prenatálny skríning pre tehotné samostatne v I. a II. trimestri, ako aj integrovaný prenatálny skríning s odporúčaním
klinického genetika,
– parametre poškodenia myokardu,
– katecholamíny a ich metabolity,



viac
ako
– testy na diagnostiku a sledovanie diabetes mellitus, – vyšetrenia na diagnostiku a kontrolu úspešnosti liečby osteoporózy.
Vďaka najmodernejšiemu vybaveniu ako jedni z mála na Slovensku stanovujeme močové sedimenty prietokovou cytometriou. Pri patologickej hodnote erytrocytov vo vzorke je výhodou takéhoto stanovenia okamžité určenie pôvodu erytrocytov, ktoré výrazne zrýchľuje diagnostiku a následnú liečbu pacienta. Ponúkame tiež stanovenie stopových prvkov, žlčových kyselín či hladín vybraných liečiv.
Naše CL – Z ÁPAD v Bratislave ponúka na Slovensku najnovšie a najmodernejšie vyšetrenia, akými sú napríklad:
– p2PSA – proenzymová forma prostatického špecifického antigénu, ktorá je frakciou v plazme cirkulujúceho voľného PSA; vyšetrenie PSA v kombinácii s PHI (Prostate Health Index) má v súčasnosti najvyššiu špecificitu pri diagnostike karcinómu prostaty,
– sd-LDL cholesterol,



– vyšetrenie kalprotektínu v stolici,
– vyšetrenie DAO – histamínovej intolerancie,
– stanovenie vitamínu A, E, aktívnej formy vitamínu B12,
– vyšetrenie ťažkých kovov – chróm, nikel a olovo,
– vyšetrenie stopových prvkov – meď, zinok, selén.
Laboratórna diagnostika 10
900
PREVENTÍVNA PREHLIADKA
Krv na sérum
Krv s EDTA
Moč ranný
Sedimentácia Stolica
Výpočtové parametre
GF podľa Cockroft & Gaulta
GF podľa Schwartza (do 18 rokov)
GF podľa CKD EPi
GF z cystatínu C
Enzýmy
S − AST
S − ALT
S − GGT
S − ALP
ZÁKLADNÉ VYŠETRENIA
02 Krv s EDTA
HEMATOLÓGIA
B − Krvý obraz
B − Krvý obraz s diferenciálom
HEMOKOAGULÁGIA
P − PT-ratio
P − INR (INR) - liečení pacienti
P − APTT – ratio
P − Fibrinogén
P − Trombínový čas – ratio
P − Antitrombín III



P − D-dimér
ZÁKLADNÉ VYŠETRENIA
V RANNOM MOČI
U − Moč chemicky
U − Močový sediment
U − Amyláza
SEDIMENTÁCIA ERYTROCYTOV
P− Sedimentácia erytrocytov
IMUNOHEMATOLÓGIA
Krvná skupina + RhD
Antierytrocyt. protilátky (NAT)
01 Krv na sérum
ZÁKLADNÁ BIOCHÉMIA
Metabolity
S − Glukóza
S − Glukóza po jedle
S − Močovina
S − Kreatinín
S − Cystatín C








S − Kyselina močová
S − Celkové bielkoviny
S − Albumín
S − Bilirubín celkový
S − Bilirubín konjugovaný
S − Amyláza
S − Pankreatická amyláza
S − Lipáza
S − Cholínesteráza
S − Laktátdehydrogenáza
S − CK
Lipidy
S − Cholesterol
S − HDL cholesterol
S − LDL cholesterol
S − Triacylglyceroly
Index LDL/HDL
Index CHOL/HDL
Non - HDL - cholesterol
Aterogénny index plazmy
Minerály a stopové prvky
S − Sodík
S − Draslík
S − Chloridy
S − Vápnik
S − Fosfor
S − Horčík
Metabolizmus železa a hemoglobínu
S − Železo
S − Celková väzbová kapacita Fe
Voľná väzbová kapacita Fe
S − Transferín Saturácia transferínu
IMUNOLÓGIA
Základná imunológia
S − IgA
S − IgM
S − IgG
Zápalové markery
S − CRP
S − ASLO
S − Reumatoidný faktor
HORMÓNY
Gravidita
S − Celkový hCG
S − Voľný beta-hCG
S − TSH v gravidite
S – aTPO / Tyreoperoxidáza
– autoprotilátky
Hormóny štítnej žlazy
S − TSH
S − T4 voľný
Preeklampsia
Index sFlt-1/PIGF €
sFlt-1 €
PIGF €
Onkomarkery
S − AFP
S − Celkový hCG
S − CA 125
ROMA index (CA125; HE4)
S − PSA
INFEKČNÁ SÉROLÓGIA
– Anti Rubeola IgM, IgG

– Anti Toxoplasma gondii IgM, IgG (skríning)
– Anti CMV IgM, IgG (skríning)
– Anti HCV IgG
– HBsAg





– RRR, anti Treponema pallidum
– Anti HIV 1/2, p24 HIV antigén

07 Stolica
VYŠETRENIE STOLICE
F − Stolica na OK
14 Krv s NaF/Na2EDTA
METABOLITY
P − Glukóza
P − Glukóza po jedle
Laboratórna diagnostika 12
ŽIADANKA O VYŠETRENIE – PREVENTÍVNA PREHLIADKA, ZÁKLADNÉ VYŠETRENIA
ŽIADANKA KLINICKÁ BIOCHÉMIA A HEMATOLÓGIA
01 Krv na sérum ZÁKLADNÁ BIOCHÉMIA (SÉRUM)
Metabolity
S − Glukóza
S − Glukóza po jedle
S − Močovina
S − Kreatinín
S − Cystatín C

S − Kyselina močová
S − Celkové bielkoviny
S − Albumín
S − Bilirubín celkový
S − Bilirubín konjugovaný
S − Fruktozamín
S − Žlčové kyseliny
Odhad GF
GF podľa Cockroft & Gaulta
GF podľa Schwartza (do 18 rokov)
GF podľa CKD EPi
GF z cystatínu C
Elektroforéza bielkovín
S − Elektroforéza bielkovín
S − Imunoelektroforéza
Enzýmy
S − AST
S − ALT
S − GGT
S − ALP
S − ALP izoenzýmy
S − Amyláza
S − Pankreatická amyláza
S − Lipáza
S − Cholínesteráza
S − Laktátdehydrogenáza
S − CK
S − CK-MB
S − Angiotenzín konvertujúci enzým
S − HBDH
Lipidy
S − Cholesterol
S − HDL cholesterol
S − LDL cholesterol
S − Triacylglyceroly
S − sd-LDL cholesterol €
S − Lipoproteín (a)
S − Apolipoproteín A1
S − Apolipoproteín B
– Index LDL/HDL









– Index CHOL/HDL


– Aterogénny index
plazmy
Minerály a stopové prvky
S − Sodík
S − Draslík
S − Chloridy
S − Vápnik
– Vápnik ionizovaný výpočtom
– Vápnik s korekciou na albumín
S − Fosfor
S − Horčík
S − Zinok
S − Meď
S − Selén
Osmolalita séra výpočtom
Metabolizmus železa a hemoglobínu

S − Železo
S − Celková väzbová kapacita Fe
– Voľná väzbová kapacita Fe
S − Transferín
– Saturácia transferínu
S − Solubilný transferínový
receptor
S − Feritín
S − Haptoglobín
IMUNOLÓGIA
Základná imunológia
S − IgA
S − IgM
S − IgG
S − IgE
S − C3 komplement
S − C4 komplement
S − Cirkulujúce imunokomplexy
Zápalové markery
S − CRP
S − CRP hs
S − Reumatoidný faktor
S − Prokalcitonín
S − Anti CCP
S − Prokalcitonín
S − Interleukín 6
S − Prealbumín
S − Beta-2-mikroglobulín
Markery streptokokovej infekcie
S − ASLO
S − ADNáza B
Špecifické bielkoviny
S − Alfa-1-antitrypsín
S − Alfa-2-makroglobulín

S − Alfa-1-kyslý glykoproteín
S − Ceruloplazmín
S − Homocysteín (odber do EDTA)
Kardiálne markery
S − Troponín I hs
S − Troponín T hs
S − Myoglobín
S − NT-proBNP
B − BNP (odber do EDTA)
ŠPECIÁLNE VYŠETRENIA
Vitamíny
S − Vitamín B12
S − Vitamín B12 aktívny
S − Kyselina listová
S − Vitamín D
S − Vitamín A
S − Vitamín C
S − Vitamín E
Iné vyšetrenia
S – Koenzým Q10 €
S – Profil mastných kyselín €
Liečivá
S − Digoxín
S − Lítium
S − Kyselina valproová
S – Karbamazepín
S − Fenobarbital
S − Teofylín
S − Gentamycín






S − Vankomycín
HORMÓNY
Gravidita
S − Celkový hCG
S − Voľný beta-hCG
S − TSH v gravidite
S – aTPO/Tyreoperoxidáza – autoprotilátky
Hormóny štítnej žlazy
S − TSH
S − T3 voľný
S − T4 voľný
S − T3 celkový
S − T4 celkový
S − Tyreoglobulín
S − aTG/Tyreoglobulín – autoprotilátky
S − aTPO/Tyreoperoxidáza – autoprotilátky
S − TSI/Tyreoideu stimulujúci imunoglobulín
Fertilita
S − Anti Műllerian hormón
S − Luteinizačný hormón
Laboratórna diagnostika 13
Biochémia hematológia
€ Vyšetrenia označené týmto symbolom nie sú hradené zdravotnou poisťovňou a je možné ich objednať len na priamu úhradu.
S − FSH
S − Estradiol
S − Progesterón
S − Prolaktín
S − Testosterón
S − SHBG
Voľný estradiol
Biologicky dostupný estradiol Androgénny index
Voľný testosterón
Biologicky dostupný testosterón
S − 17-OH-progesterón
S − DHEA-sulfát
S − Androstendión
Iné hormóny
S − Pregnenolón
S − Aldosterón v ľahu
S − Aldosterón v stoji
P − Renín v ľahu (odber do EDTA)
P − Renín v stoji (odber do EDTA)
Pomer aldosterón-renín
S − C-peptid
S − C-peptid po záťaži
S − Inzulín
S − Inzulín po záťaži
HOMA – IR (inzulínová rezistencia)
S − Kortizol ranný odber
S − Kortizol poobedný odber
S − Somatotropín
S − IGF-1
S − IGFBP-3
S − Kalcitonín
S − Parathormón (intaktný)
S − Erytropoetín
S − Gastrín
S − Serotonín €
ONKOMARKERY
S − AFP
S − Celkový hCG
S − Voľný beta-hCG
S − CEA
S − CA 19-9
S − CA 125
ROMA index (CA125/HE4)
S − CA 15-3
S − CA 72-4
S − CYFRA 21-1
S − NSE
S − Tkanivový polypeptidový antigén
S − SCCA
S − PSA
S − Voľný PSA
PSA ratio (fPSA/PSA) Index zdravej prostaty € (PSA/fPSA/p2PSA)
S − Tymidínkináza
S − Proteín S100
S − Chromogranín A
KOSTNÉ MARKERY
S − Osteokalcín
S − Beta-CrossLaps
S − P1NP
02 Krv s EDTA HEMATOLÓGIA
B − Krvný obraz
B − Krvný obraz s diferenciálom
B − Retikulocyty
GLYKOVANÝ HEMOGLOBÍN
B − HbA1c
14 Krv s NaF/NA2EDTA
METABOLITY
P − Glukóza
P − Glukóza po jedle
P − Laktát
03 Krv s citrátom HEMOKOAGULÁCIA
P – PT-ratio
P − INR (liečení pacienti)
P − APTT-ratio
P − Fibrinogén
P − Trombínový čas-ratio
P − Antitrombín III
P − D-dimér
ŠPECIÁLNE KOAGUL. VYŠETRENIA
P − Dabigatran
P − Anti Xa aktivita
P − Faktor II
P − Faktor V
P − Faktor VII
P − Faktor VIII
P − Faktor IX
P − Faktor X
P − Faktor XI
P − Faktor XII
10 Sedimentácia SEDIMENTÁCIA ERYTROCYTOV
P − Sedimentácia erytrocytov
12 Krv s EDTA 6 ml, deti – 3 ml Na skúmavke musí byť meno a rodné číslo pacienta
IMUNOHEMATOLÓGIA
– Krvná skupina + RhD
– Antierytrocyt. protilátky (NAT)


















– Skúška kompatibility
– Priamy antiglobul. test (PAT)
06 Kapilárna krv
VYŠETRENIA KAPILÁRNEJ
KRVI
B − Glukóza
B − Glukóza po jedle
B − CRP
ED Krv s EDTA INÉ VYŠETRENIA Z PLAZMY
P − Amoniak
P − ACTH
P − Metanefrín, Normetanefrín
A6,C6,D6,25 Kapilára/ Striekačka na ABR
Miesto odberu: – artéria – véna – kapilára – pupočník
VNÚTORNÉ PROSTREDIE
A METABOLITY
B − Acidobázická rovnováha
B – Aniónová medzera – mikroionty
B − Vápnik ionizovaný
B − Karbonylhemoglobín
B − Methemoglobín
B − Bilirubín
B − Laktát
07 Stolica
7B Stolica
VYŠETRENIA STOLICE
F − Stolica na OK
F − Pankreatická elastáza
F − Kalprotektín
04 Moč ranný
ZÁKLADNÉ VYŠ. V RANNO M MOČI
U − Moč chemicky
U − Močový sediment
METABOLITY V RANNOM MOČI
U − Glukóza
U − Močovina
Frakčná exkrécia močoviny
U − Kreatinín
U − Kyselina močová
Frakčná exkrécia kys. močovej
U − Celkové bielkoviny
U − Mikroalbuminúria
Index albumín/kreatinín
Osmolalita ranného moču (výpočet)
ELEKTROFORÉZA BIELKOVÍN MOČU
U − Elektroforéza bielkovín
U − Imunoelektroforéza
ENZÝMY V RANNOM MOČI
U − Amyláza
Frakčná exkrécia amylázy
U − Pankreatická amyláza
MINERÁLY V RANNOM MOČI
U − Sodík
Frakčná exkrécia Na
U − Draslík
Frakčná exkrécia K
U − Chloridy
Frakčná exkrécia CI
U − Vápnik
Index vápnik/kreatinín
Frakčná exkrécia Ca
Laboratórna diagnostika 14
U − Fosfor
Index fosfor/kreatinín
Frakčná exkrécia P
U − Horčík
Frakčná exkrécia Mg
INÉ VYŠETRENIA V RANNOM MOČI
U − Beta-2-mikroglobulín
U − Kortizol
Index kortizol/kreatinín
U − Melanín
U − Porfyríny
U − Pyrilinks
5A, 05 Moč zbieraný
– 12 hod.
– 24 hod.
METABOLITY V ZBIERANOM MOČI
dU − Glukóza
dU − Močovina
Frakčná exkrécia močoviny
dU − Kreatinín
Kreatinín klírens
dU − Kyselina močová
Frakčná exkrécia kys. močovej
dU − Celkové bielkoviny
dU − Mikroalbuminúria
Index albumín/kreatinín
Osmolalita zbieraného moču (výpočet)
MINERÁLY V ZBIERANOM MOČI
dU − Sodík
Frakčná exkrécia Na
dU − Draslík
Frakčná exkrécia K
dU − Chloridy
Frakčná exkrécia CI
dU − Vápnik
Index vápnik/kreatinín
Frakčná exkrécia Ca
dU − Fosfor
Frakčná exkrécia P
dU − Horčík
Frakčná exkrécia Mg
dU – Meď
INÉ VYŠ. V ZBIERANOM MOČI
dU − Addisov sedimen (len 12 hod.)
dU − Beta-2-mikroglobulín
dU − Kortizol
Index kortizol/kreatinín
dU − Aldosterón
dU − Serotonín €
5B Moč zbieraný
DO 6M HCl
dU − Katecholamíny
dU − Kyselina 5-OH-3-indoloctová
dU − Kys. homovanilová
POT
POT − Chloridy
EJAKULÁT
– Spermiogram
MOČOVÝ KAMEŇ
– Rozbor močového kameňa
DIALYZÁT
DI − Glukóza
DI − Kyselina močová
DI − Sodík
DI − Draslík
DI − Chloridy
DI − CRP
DI − Laktát
PUNKTÁT
PU − pH
PU − Glukóza
PU − Celkové bielkoviny
PU − Albumín
PU − Bilirubín celkový
PU − AST
PU − ALT
PU − Amyláza
PU − Laktátdehydrogenáza
PU − CRP
PU − Laktát
PU − Reumatoidný faktor
SLINY 17 SLINY
SA − Kortizol ranný odber (odber medzi 7:00 – 9:00)
B7 SLINY
SA − Kortizol poob. odber (odber medzi 16:00 – 19:00)
C7 SLINY
SA – Kortizol nočný odber (odber o 24:00)
TOXIKOLÓGIA
1G Krv na sérum
S – Karbohydrátdeficientný transferín
S – Chróm €
S – Nikel €

U4 Moč ranný
U − Multidrogový test
W4 Moč ranný
U – Etylglukuronid
U − Metabolity organických rozpúšťadiel €


1F Krv na sérum
S – Alkohol
ŽIADANKA
VYŠETRENIE Z PLODOVEJ VODY
PV − AFP
ET Krv s EDTA
B – Olovo €
I. TRIMESTER
– PAPP-A, voľný beta-hCG


– USG
II. TRIMESTER
– Double test: celkový hCG + AFP
– Triple test: celkový hCG + AFP + voľný estriol
– USG







PREEKLAMPSIA
– Index sFlt-1/PIGF €
– sFlt-1 €







– PIGF €

Laboratórna diagnostika 15 Biochémia hematológia
XX
O VYŠETRENIE – BIOCHÉMIA – PRENATÁLNY SKRÍNING
ŽIADANKA DIABETOLÓGIA
O-GTT (OGTT, OGTTS, OGTTP)
Krv na OGTT
– odber na lačno
– 1 hod. po záťaži glukózou
– 2 hod. po záťaži glukózou
U-GTT (UOGTT)
Moč
– odber na lačno



– 1 hod. po záťaži glukózou
– 2 hod. po záťaži glukózou
GLYKEMICKÝ PROFIL
Kapilárna krv
02 Krv s EDTA
GLYKOVANÝ HEMOGLOBÍN
B − HbA1c
01 Krv na sérum
1E Krv na sérum 2 (záťažové testy)
VYŠETRENIA ZO SÉRA
S − Glukóza
S − Glukóza po jedle
S − Kreatinín
S − AST
S − ALT
S − GGT
S − CK
S − Cholesterol
S − HDL cholesterol
S − LDL cholesterol
S − Triacylglyceroly
– Index LDL/HDL











– Index CHOL/HDL

– Aterogénny index plazmy
S − C-peptid
S − C-peptid po záťaži
S − Inzulín
S − Inzulín po po záťaži
– HOMA – IR (inzulínová rezistencia)
– anti-GAD/Dekarboxyláza
kyseliny glutámovej
– autoprotilátky IgG
– IAA/Inzulín – autoprotilátky IgG
– anti-IA2/Tyrozínfosfatáza – autoprotilátky IgG
04 Moč ranný
METABOLITY V RANNOM MOČI
U − Glukóza
U − Kreatinín
U − Celkové bielkoviny
U − Mikroalbuminúria
– Index albumín /kreatinín
04 Moč zbieraný
METABOLITY V ZBIERANOM MOČI
dU − Glukóza
dU − Kreatinín
– Kreatinín klírens
dU − Celkové bielkoviny
dU − Mikroalbuminúria
– Index albumín /kreatinín
ŽIADANKA ŠPECIÁLNA HEMATOLÓGIA
02 Krv s EDTA HEMATOLÓGIA
B − Krvný obraz
B − Krvný obraz s diferenciálom
B − Retikulocyty
03 Krv s citrátom
KOAGULAČNÉ FAKTORY
P − Faktor II
P − Faktor V
P − Faktor VII
P − Faktor VIII
P − Faktor VIII chromogénny
P − Faktor IX
P − Faktor X
P − Faktor XI
P − Faktor XII
P − Faktor XIII
03 Krv s citrátom
TROMBOFILNÝ STAV – SKRÍNING
P − ProC global
P − ProC global/faktor V
P − Proteín C
P − Proteín S
P − Voľný proteín S Ag
03 Krv s citrátom
ZÁKLADNÁ KOAGULÁCIA
P − PT-ratio
P − INR (liečení pacienti)
P − APTT-ratio
P − Fibrinogén
P − Trombínový čas-ratio
P − Antitrombín III



P − D-dimér
HEMATOLÓGIA
P − Trombocyty v citráte
03 Krv s citrátom
ANTIKOAGULAČNÁ LIEČBA
P − Dabigatran
P − Anti Xa aktivita
P − Rivaroxaban
P − Apixaban
P − Edoxaban
03 Krv s citrátom
FIBRINOLÝZA
P − PAI-1
P − Plazminogén
P − Alfa-2-antiplazmín
VON WILLEBRANDOV SYNDRÓM
P − vWF: Aktivita
P − vWF: Antigén
Laboratórna diagnostika 16
02 Krv s EDTA
HEMATOLÓGIA
B − Krvný obraz
B − Krvný obraz s diferenciálom
B − Retikulocyty
03 Krv s citrátom
KOAGULAČNÉ FAKTORY
P − Faktor II
P − Faktor V
P − Faktor VII
P − Faktor VIII
P − Faktor VIII chromogénny
P − Faktor IX
P − Faktor X
P − Faktor XI
P − Faktor XII
P − Faktor XIII
03 Krv s citrátom
TROMBOFILNÝ STAV
– SKRÍNING
P − ProC global
P − ProC global/faktor V
P − Proteín C
P − Proteín S
P − Voľný proteín S Ag
03 Krv s citrátom
ZÁKLADNÁ KOAGULÁCIA
P − PT-ratio
P − INR (liečení pacienti)
P − APTT-ratio
P − Fibrinogén
P − Trombínový čas-ratio
P − Antitrombín III















P − D-dimér
HEMATOLÓGIA
P − Trombocyty v citráte
03 Krv s citrátom
ANTIKOAGULAČNÁ LIEČBA
P − Dabigatran
P − Anti Xa aktivita
P − Rivaroxaban
P − Apixaban
P − Edoxaban
03 Krv s citrátom
FIBRINOLÝZA
P − PAI-1
P − Plazminogén
P − Alfa-2-antiplazmín
VON WILLEBRANDOV SYNDRÓM
P − vWF: Aktivita
P − vWF: Antigén
03 Krv s citrátom
ANTIFOSFOLIPIDOVÝ
SYNDRÓM
P − Lupus antikoagulans
skríning
P − Lupus antikoagulans
konfirmácia
P − Kaolínový čas – ratio
01 Krv na sérum ANTIFOSFOLIPIDOVÝ
SYNDRÓM
– Fosfolipidy – autoprotilátky IgG skríning
– Fosfolipidy – autoprotilátky IgM skríning
– Kardiolipín – autoprotilátky IgG
– Kardiolipín – autoprotilátky IgM
– β -2-glykoproteín 1
– autoprotilátky skríning
– Anexín V – autoprotilátky IgG
– Anexín V – autoprotilátky IgM
– Fosfatidylserín – autoprotilátky
IgG
– Fosfatidylserín – autoprotilátky IgM
– Kyselina fosfatidylová
– autoprotilátky IgG
– Kyselina fosfatidylová
– autoprotilátky IgM
– Fosfatidylinozitol
– autoprotilátky IgG
– Fosfatidylinozitol
– autoprotilátky IgM
– Fosfatidyletanolamín
– autoprotilátky IgG



– Fosfatidyletanolamín
– autoprotilátky IgM
– Protrombín
– autoprotilátky skríning
03 Krv s citrátom
AGREGÁCIA TROMBOCYTOV
P − Agregácia – ADP
P − Agregácia – EPI
P − Agregácia – kolagén
P − Agregácia – kyselina arachidónová
P − Agregácia – RIPA
P − Agregácia – spontánna
SYNDRÓM LEPIVÝCH DOŠTIČIEK (len ako súčasť AGR)
02 Krv s EDTA IMUNOFENOTYPIZÁCIA
LEUKOCYTOV
B − Základná imunofenotypizácia
hematologického ochorenia
B − Akútna leukémia
B − Lymfoproliferatívne ochorenie (LPO)
B − Vlasatobunková leukémia (HCL)
B − Mnohopočetný myelóm (MM) /Monokl. gamapatia nej. významu (MGUS)
B − Myeloproliferatívne neoplázie (MPN) /Myelodysplast. syndróm (MDS)
15 Kostná dreň Li Heparinát IMUNOFENOTYPIZÁCIA
LEUKOCYTOV
– KD − Základná imunofenotypizácia
hematologického ochorenia
– KD − Akútna leukémia
– KD − Lymfoproliferatívne ochorenie (LPO)
– KD − Vlasatobunková leukémia (HCL)

– KD − Mnohopočetný myelóm (MM)/Monokl. gamapatia nej. významu (MGUS)
– KD − Myeloproliferatívne neoplázie (MPN) /Myelodysplast. syndróm (MDS)
15 Iný materiál
Špecifikujte materiál
– Biopsia zo žalúdka, čreva – prietoková cytometria
– BAL, likvor – prietoková cytometria
– T-LPO, biopsia z kože, MF – prietoková cytometria
–
–
–
–
nočná hemoglobinúria

Laboratórna diagnostika 17 Biochémia hematológia
PRIETOKOVÁ CYTOMETRIA 01 Krv na sérum 02 Krv s EDTA
Protilátky proti leukocytom
Protilátky proti trombocytom
HIT – Heparínom indukovaná trombocytopénia 02 Krv s EDTA
–
Aktivačné markery trombocytov
PNH – Paroxyzmálna
ŽIADANKA LIKVOR
09 Likvor BIOCHEMICKÉ VYŠETRENIA (LBIO)
L − Vzhľad
L − Elementy
L − Glukóza
L − Chloridy
L − Celkové bielkoviny
L − Laktát
L − Laktátdehydrogenáza
L − Albumín
L − IgM v likvore
L − IgG v likvore
VÝPOČTY:


– Koeficient energetickej bilancie
51 Likvor MIKROBIOLOGICKÉ VYŠETRENIE (LMIKRO)
– Aeróbna kultivácia
– Anaeróbna kultivácia
– Kultivácia po pomnožení
– Mikroskopia
– Mykológia

– Voľný antigén v likvore
LD Likvor PRIAMY DÔKAZ MIKROORGANIZMOV
– DNA Borrelia burgdorferi s. l. kvalitatívne
– DNA HSV 1 kvantitatívne
– DNA HSV 2 kvantitatívne
– DNA VZV kvantitatívne
– DNA CMV kvantitatívne
– DNA EBV kvantitatívne
– DNA Chlamydia pneumoniae kvalitatívne
– DNA Mycoplasma pneumoniae kvalitatívne
– RNA TBEV (kliešťová encefalitída) kvalitatívne
TL Likvor LIKVOR NA TBC
– Kultivácia, mikroskopia
– DNA Mycobacterium tuberculosis kvalitatívne
9B Likvor 01 Krv na sérum MIKROBIOLOGICKÉ VYŠETRENIE / PROTILÁTKY
– Anti Borrelia spp. IgM, IgG (CSF/sérum) AI Index, Anti Borrelia spp. IgM, IgG (Line Blot)


– Anti HSV IgG (CSF/sérum)
AI Index
– Anti VZV IgG (CSF/sérum)





AI Index
– Anti Parotitis IgG (CSF/sérum)
AI Index
– Anti CMV IgG (CSF/sérum)






AI Index
– Anti EBV, EBNA-1 IgG (CSF/sérum) AI Index


– Anti Kliešťová encefalitída IgM, IgG (CSF/sérum) AI Index
– Cryptococcus neoformans antigén (aglutinácia) (nevyžaduje sa sérum)
Žiadanka na stiahnutie: www.unilabs.sk/ziadanky-tlaciva
Laboratórna diagnostika 18
ŽIADANKA IMUNOLÓGIA A ALERGOLÓGIA
BUNKOVÁ IMUNITA
02 Krv s EDTA
B – Krvný obraz s diferenciálom
IMUNOFENOTYPIZÁCIA
B − Imunofenotypizácia lymfocytov
T-lymfocyty: CD3+
T-lymfocyty pomocné:
CD3+CD4+
T-lymfocyty cytotoxické:
CD3+CD8+
Imunoregulačný index (IRI):


CD4+/CD8+
NK bunky: CD16+56+
B-lymfocyty: CD19+
B − Aktivované T-lymfocyty (CD3+HLA-DR+) len ako súčasť
IFELY
B – Regulačné T-lymfocyty
CD4+CD25highCD127 low
20 Krv s heparinátom
NEŠPECIFICKÁ BUNKOVÁ IMUNITA
P − Fagocytárna aktivita
E2 Krv s EDTA
INÉ VYŠETRENIA
B − HLA-B27
HUMORÁLNA IMUNITA
01 Krv na sérum
04 Moč
IMUNOGLOBULÍNY A KOMPLEMENT
S − IgA
S − IgM
S − IgG
S – Podtriedy IgG (IgG1-4)
S − IgE
S − C3 komplement
S − C4 komplement
S − Cirkulujúce imunokomplexy
ELEKTROFORÉZA BIELKOVÍN
S − Elektroforéza bielkovín
S − Imunoelektroforéza
U − Elektroforéza bielkovín
n U − Imunoelektroforéza
GAMAPATIE
S − Voľné reťazce kappa
S − Voľné reťazce lambda
S − Celkové reťazce kappa
S − Celkové reťazce lambda
U − Voľné reťazce kappa
U − Voľné reťazce lambda
U − Bence Jonesova bielkovina
ZÁPALOVÉ MARKERY
S − CRP
S − Reumatoidný faktor
S − Prokalcitonín
S − Interleukín 6
S − Prealbumín
ŠPECIFICKÉ BIELKOVINY
S − Alfa-1-antitrypsín
S − Alfa-2-makroglobulín
S − Alfa-1-kyslý glykoproteín
S − Ceruloplazmín
H ISTAMÍNOVÁ INTOLERANCIA
S − Diaminooxidáza
PROTILÁTKY PROTI MIKROBIÁLNYM
ANTIGÉNOM
S − ASLO
S − ADNáza B
Candida mannan – protilátky IgG, IgA, IgM
Aspergillus – protilátky IgG
PROTILÁTKY PROTI ĎALŠÍM
ANTIGÉNOM
Potravinová intolerancia
Bielkoviny kravského mlieka – protilátky IgM, IgA, IgG
Laktóza – protilátky IgA, IgG
Sója – protilátky IgA, IgG
Ovalbumín – protilátky IgA, IgG
α – laktalbumín – protilátky IgA, IgG
β – laktoglobulín – protilátky IgA, IgG
Kazeín – protilátky IgA, IgG
Sacharomyces cerevisiae – protilátky IgA
Sacharomyces cerevisiae – protilátky IgG
Celiakia
Deaminovaný gliadín – protilátky IgA, IgG

Tkanivová transglutamináza – protilátky IgA, IgG
AUTOPROTILÁTKY
Reumatológia

ANA/Bunkové jadro – autoprotilátky
IgG skríning (ANAGS)













ENA/Extrahovateľné nukleárne antigény – autoprotilátky IgG skríning
dsDNA/Dvojšpirálová DNA
– autoprotilátky IgG, IgA, IgM
ACCP/Cyklické citrulínované peptidy – autoprotilátky IgG
Diabetes mellitus
anti-GAD/Dekarboxyláza kyseliny glutámovej – autoprotilátky IgG
IAA/Inzulín – autoprotilátky IgG
anti-IA2/Tyrozínfosfatáza – autoprotilátky IgG
Autoimunitná hepatitída
AMA/Mitochondrie – autoprotilátky IgG
LKM/Mikrozómy pečene
a obličky – autoprotilátky IgG
SLA/Solubilný pečeňový
antigén – autoprotilátky IgG
Antifosfolipidový syndróm
Fosfolipidy – autoprotilátky IgG
skríning
Fosfolipidy – autoprotilátky IgM
skríning
Kardiolipín – autoprotilátky IgG
Kardiolipín – autoprotilátky IgM
β-2-glykoproteín 1
– autoprotilátky skríning
Anexín V – autoprotilátky IgG
Anexín V – autoprotilátky IgM
Fosfatidylserín
– autoprotilátky IgG
Fosfatidylserín
– autoprotilátky IgM
Kyselina fosfatidylová
– autoprotilátky IgG
Kyselina fosfatidylová
– autoprotilátky IgM
Fosfatidylinozitol
– autoprotilátky IgG
Fosfatidylinozitol
– autoprotilátky IgM
Fosfatidyletanolamín
– autoprotilátky IgG
Fosfatidyletanolamín
– autoprotilátky IgM
Fosfatidylcholín
– autoprotilátky skríning
Trombín – autoprotilátky skríning
Protrombín – autoprotilátky skríning
Vaskulitída a renálne ochorenia
c-ANCA/Proteináza 3
– autoprotilátky IgG
p-ANCA/Myeloperoxidáza
– autoprotilátky IgG
anti-GBM/Bazálna
membrána glomerulov
– autoprotilátky IgG

Laboratórna diagnostika 20
Štítna žľaza aTG/Tyreoglobulín – autoprotilátky aTPO/Tyreoperoxidáza – autoprotilátky
TSI/Tyreoideu stimulujúci
imunoglobulín
Reprodukčný systém
Zona pellucida
– autoprotilátky IgG
Ováriá – autoprotilátky IgG
Spermatozoa
– autoprotilátky IgG

Iné
APCA/Parietálne bunky – autoprotilátky IgG
Systémová skleróza
– protilátky proti špecifickým



antigénom
7B STOLICA
VYŠETRENIA STOLICE
Pankreatická elastáza
Kalprotektín
ŠPECIFICKÉ
IgE
01 Krv na sérum
ALERGÉNY − SKRÍNING
Atopický profil − deti, dospelí (g6, g12, t3, w6, d1, e1, e2, e3, m2, m6, f1, f2, f3, f4, f9, f14, f17, f31, f35, f49)
Inhalačný profil − deti (g1, g3, g6, g12, t2, t3, t4, t7, w1, w6, w9, d1, d2, e1, e2, e3, m1, m2, m3, m6)
Inhalačný profil − deti, dospelí (g6, g12, t2, t3, t4, w6, w8, w9, d1, d2, e1, e2, e3, e6, e82, e84, m1, m2, m3, m6)
Inhalačný profil − stredozemný (g2, g6, t3, t4, t9, t11, t23, t210, w1, w6, w9, w19, d1, d2, d70, e1, e2, e3, m3, m6)
Pediatrický profil (gx, t3, w6, d1, d2, e1, e2, e3, e204, m2, m3, m6, f1, f2, f3, f4, f9, f13, f14, f17, f31, f35, f49, f75, f76, f78)
Potravinový profil − deti, dospelí (f1, f2, f3, f4, f5, f9, f13, f14, f17, f20, f23, f25, f31, f35, f45, f49, f75, f84, f85, f237)
Profil jedov hmyzu (i1, i3)
ŠPECIFICKÉ I g G














Vyšetrenie oneskorenej potravinovej intolerancie IgG € (f247, f79, f113, f89, f74, f73, fs903, f281, f239, fs900, f260, f216, f66, f48, f47, f235, f132, f15, f31, f35, f25, f256, f20, f17, f13,fs902, f328, f92, f84, f49, f33, f83, f64, f27, f953, f41, f40, f3, f45, f292, f14, f11, f9, f7, f6, f5, f4, f218, f929, f78)
PRÍLOHA K ŽIADANKE IMUNOLÓGIA A ALERGOLÓGIA – ŠPECIFICKÉ IgE – ZOZNAM ALERGÉNOV
ZVIERACIE
e78 – Andulka perie
e215 – Holub perie
e7 – Holub trus
e70 – Hus perie
e86 – Kačica perie
e201 – Kanárik perie
e80 – Koza epitel
e3 – Kôň kožné šupiny
e4 – Krava kožné šupiny
e82 – Králik epitel
e85 – Kura perie
e219 – Kura sérový proteín
e1 – Mačka kožné šupiny
e6 – Morča epitel
e89 – Morka perie
e71 – Myš epitel
e88 – Myš epitel, sérové a močové bielkoviny
e72 – Myš močové bielkoviny
e76 – Myš sérové bielkoviny
e81 – Ovca epitel
e91 – Papagáj perie
e2 – Pes epitel
e5 – Pes kožné šupiny
e209 – Pieskomil epitel
e73 – Potkan epitel
e87 – Potkan epitel, sérové a močové bielkoviny
e74 – Potkan močové bielkoviny
e75 – Potkan sérové bielkoviny
e83 – Prasa epitel
e222 – Prasa sérové bielkoviny
e84 – Škrečok epitel
PLESNE
m6 – Alternaria tenuis
m312 – Aspergillus clavatus
311 – Aspergillus flavus
m3 – Aspergillus fumigatus
m310 – Aspergillus nidulans
m207 – Aspergillus niger
m304 – Aspergillus oryzae
m309 – Aspergillus terreus
m12 – Aureobasidium pullulans
m7 – Botrytis cinerea
m5 – Candida albicans
m202 – Cephalosporium
acremonium
m2 – Cladosporium herbarum
m16 – Curvularia lunata
m14 – Epicoccum purpurascens
m300 – Eurotium herbariorum
(Aspergillus glaucus)
m9 – Fusarium moniliforme
m8 – Helminthosporum halodes
m45 – Hormodendrum hordei
m208 – Chaetomium globosum
m212 – Micropolyspora faeni
m4 – Mucor racemosus
m305 – Penicillium brevicompactum
m1 – Penicillium notatum
m13 – Phoma betae
m70 – Pityrosporum orbiculare
m11 – Rhizopus nigricans
m10 – Stemphylim botryosum
m88 – Stemphyllium solani
m15 – Tricoderma viride
m203 – Trichosporon pullulans
m204 – Ulocladium chartarum
PRACHOVÉ
h1 – Domáci prach – Greer
h6 – Domáci prach – Japan
HMYZ
i71 – Komár jarný ( Aedes communis)
i8 – Moľa (Bombyx mori)
i70 – Mravec čierny (Monomorium minimum)
i5 – Osa (Dolichovespula arenaria)
i2 – Osa (Dolichovespula maculata)
i3 – Osa (Vespula spp.)
i4 – 0sík (Polistes spp.)
i204 – 0vad (Tabanus spp.)
i75 – Sršeň obyčajný (Vespa crabro)
i6 – Rus domový (Blattella germanica)
i1 – Včela medonosná ( Apis mellifera)
i203 – Vijačka múčna (Ephestia kuehniella)
RÔZNE
o1 – Bavlna – vlákno
o72 – S aureus enterotoxín A
o73 – S aureus enterotoxín B

o201 – Tabak (Nicotiana tabacum)
ROZTOČE
d70 – Acarus siro
d201 – Blomia tropicalis
d2 – Dermatophagoides farinae
d3 – Dermatophagoides microceras
Laboratórna diagnostika 21
Imunológia a alergológia
d1 – Dermatophagoides pteronyssinus
d74 – Euroglyphus maynei
d73 – Glycyphagus domesticus
d71 – Lepidoglyphus destructor
d72 – Tyrophagus putrescentiae
PROFESNÉ

k87 – Amyláza (Fungal)
k210 – Anhydrid kyseliny maleínovej (MA)
k213 – Anhydrid tetrachlorftalátu (TCPA)

k226 – Askorbát oxidáza
k202 – Bromelín
k81 – Fikus (Ficus spp.)
k80 – Formaldehyd (E240)
k77 – Hexametylén-1,6diizokyanát (HDI)
k74 – Hodváb prírodný (Bombyx)
k8 – Chmeľ (Humulus lupus)
k225 – Chrenová peroxidáza
k70 – Kávové zrná – zelené (Co ea arabica)
k82 – Latex
k301 – Múčny prach
k20 – Ovčia vlna spracovaná
k72 – Psyllium (Ispaghula laxative)
k71 – Ricín obyčajný (Ricinus communis)
k84 – Slnečnica (Helianthus annuus)
k75 – Toluyléndiizokyanát (TDI)
LIEKOVÉ
Analgetiká, antipyteriká
C281 – Diklofenak
C419 – Fenylbutazón
C286 – Ibuprofén
C388 – Ketoprofén
C217 – Kyselina acetylsalicylová
C209 – Paracetamol
Antibiotiká
C288 – Aminoglykozidy
c204 – Amoxicilín
c203 – Ampicilín
C309 – Cefalexín
C201 – Cefalosporíny mix
C308 – Cefuroxím
C307 – Ciprofloxacín
C216 – Doxycyklín
C212 – Erytromycín
C213 – Gentamycín
C305 – Kyselina klavulánová
C222 – Makrolidy
C398 – Metronidazol
C1 – Penicilín G
C2 – Penicilín V
C295 – Streptomycín
C223 – Sulfametoxazol
C211 – Tetracyklín
C242 – Trimetroprim
Antiepileptiká













C338 – Karbamazepín
Antiflogistiká

C282 – Indometacín
C296 – Propyfenazón
Antiseptiká
C616 – Jodid sodný
Barbituráty
C243 – Tiopental
Bronchodilatanciá, antiastmatiká
C257 – Teophylline
Hormóny

c71 – Inzulín (hovädzí)
c73 – Inzulín (ľudský)
c70 – Inzulín (prasací)
Imunosupresíva
c254 – Prednisolon
Lokálne anestetiká
C232 – Lidokaín
C811 – Mezokaín
Mukolytiká
C202 – Sukcinylcholín
Potravinárske aditíva
C711 – Dusitan sodný (E250)
C704 – Chinolínová žltá (E104)
C703 – Kyselina benzoová (E210)
C707 – Kyselina glutámová (E620)
C726 – Kyselina karmínová (E120)
C312 – Laktóza
C713 – Metylparabén (E218)
C604 – Peroxodisíran amónny (E923)
C636 – Sacharín (E954)
C638 – Talk (mastenec) (E553b)
C717 – Tartrazín (E102)
Rozpúšťadlá
C643 – Toluén
Soli kovov
C649 – Chlorid cínatý E512

C637 – Chlorid strieborný
C645 – Chlorid titaničitý
Vakcíny
C801 – Haemophilus influenzae
Vitamíny
C721 – Vitamín B12 (Kyanokobalamín)
PARAZITY
p4 – Anisakis simplex (sleďový červ)
p1 – Škrkavka detská (Ascaris sp)
p5 – Škrkavka psia (Toxocara canis)
PELE BYLÍN
w69 – Allenrolfea occidentalis
w36 – Ambrózia ( Ambrosia deltoidea)
w4 – Ambrózia nepravá (Franseria acanthicarpa)
w1 – Ambrózia palinolistá ( Ambrosia artemisifolia)
w3 – Ambrózia trojzárezová (Ambrosia trifida)
w2 – Ambrózia trvalka (Ambrosia psylostachya)
w67 – Baccharis halimifolia
w17 – Basia metlovitá (Kochia scoparia)
w90 – Chmeľ japonský popínavý (Humulus japonicus)
w16 – Iva (Iva ciliata)
w14 – Láskavec ohnutý ( Amaranthus retroflexus)
w82 – Láskavec Palmerov ( Amaranthus palmeri)
w24 – Láskavec tŕnistý ( Amaranthus spinosus)
w15 – Loboda (Atriplex lentiformis)
w37 – Loboda (Atriplex wrightii)
w7 – Margaréta biela (Chrysanhmum leucanthemum)
w10 – Mrlík biely (Chenopodium album)
w19 – Múrovník lekársky (Parietaria o cinalis)
w21 – Múrovník palestínský (Parietaria judaica)
w6 – Palina obyčajná ( Arthemisia vulgaris)
w5 – Palina pravá ( Arthemisia absinthium)
w43 – Palina stepná (Artemisia tridentata)
w20 – Pŕhľava dvojdomá (Urtica dioica)
w8 – Púpava lekárská (Taraxacum vulgare)
w203 – Repka olejná (Brasicca napus)
w46 – Ruman smradľavý (Anthemis cotula)
w9 – Skorocel kopijovitý (Plantago lanceolata)
w11 – Slanobyľ drasnomilná (Salsola kali)
w23 – Štiavec kučeravý (Rumex crispus)
w18 – Štiavička obyčajná (Rumex acetosella)
w13 – Voškovník obecný ( Xanthium commune)
w12 – Zlatobyľ obyčajný (Solidago virgaurea)
ALERGÉNY TRÁV A BURÍN
g17 – Bahijská tráva (Paspalum notatum)
g10 – Cirok alpský (Sorghum halepense)
g71 – Chrastnica trsťovitá (Phalaris arundinacea)
g70 – Jačmenica (Elymus triticoides)
g4 – Kostrava lúčna (Festuca elatior)
Laboratórna diagnostika 22
g202 – Kukurica siata (Zea mays)
g8 – Lipnica lúčna (Poa pratensis)
g5 – Mätonoh trváci ( Lolium perenne)
g13 – Medúnok vlnatý (Holcus lanatus)
g14 – Ovos siaty (Avena sativa)
g2 – Prstnatec obyčajný (Cynodon dactylon)
g16 – Psinček lúčna ( Alocepurus pratensis)
g9 – Psinček výbežkatý ( Agrostis stolonifera)
g15 – Pšenica siata (klíčky) (Triticum sativum)
g12 – Raž siata (Secale cereale)
g3 – Reznačka laločnatá (Dactylis glomerata)
g203 – Slanomilná tráva (Distichlis spicata)
g11 – Stoklas bezosťový (Bromus inermis)
g6 – Timotejka lúčna (Phleum pratense)
g1 – Tomka voňavá ( Anthoxanthium odoratum)
g7 – Trstina obyčajná (Phragmites communis)
PELE STROMOV
t280 – Agát biely (Robinia pseudoacacia)
t19 – Akácia (Acacia longifolia)
t211 − Ambrovník styraxový (Liquidambar styraciflua)
t16 − Borovica hladká (Pinus strobus)
t43 − Borovica kadidlová (Pinus taeda)
t6 − Borievka netatová (Juniperus sabinoides)
t60 – Borievka západná (Juniperus occidentalis)
t8 − Brest (Ulmus spp)
t44 − Brestovec západný (Celtis occidentalis)
t3 − Breza previsnutá (Betula alba)
t5 − Buk lesný (Fagus silvatica)
t219 – Céder červený (Juniperus virginiana)
t23 − Cyprus vždyzelený (Cupressus sempervirens)
t80 – Cypruštek japonský (Chamaecyparis obtusa)
t21 − Čajovník (Melaleuca leucadendron)
t7 − Dub biely (Quercus alba)
t42 − Dub červený (Quercus rubra)
t103 – Dub kalifornský (Quercus agrifolia)
t77 − Dub mix (červený, biely, čierny) (Quercus)
t406 – Ďatľovník pravý (Phoenix dactylifera)
t18 − Eukalyptus (Eucalyptus spp)
t209 – Hrab obyčajný (Carpinus betulus)
t15 – Jaseň americký (Fraxinus americana)
t33 – Jaseň (Fraxinus velutina)
t1 – Javor (Acer spp)
t27 – Javor červený (Acer rubrum)
t81 – Jelša japonská (Alnus japonica)
t2 – Jelša sivá (Alnus incana)
t17 – Kryptoméria japonská (Cryptomeria japonica)
t4 – Lieska obyčajná (Corylus avellana)
t208 – Lipa malolistá (Tilia cordata)
t83 – Mangovník indický (Mangifera indica)
t70 – Moruša biela (Morus alba)
t71 – Moruša červená (Morus rubra)
t9 – Olivovník európsky (Olea europaea)
t10 – Orech (Juglans california)
t41 – Orechovec (Carya tomentosa)
t22 – Orechovec pekanový (Carya illinoinensis)
t404 – Pajaseň žliazkatý (Ailanthus altissima)
t72 – Palma kokosová (Syagrus romanzo anum)
t401 – Pieprovník peruánsky (Schinus molle)
t402 – Pistácia mastixová (Pistacia lentiscus)
t11 – Platan javorolistý (Platanus acerifolia)
t73 – Prasličník (Casuarina equisetifolia)
t20 – Prosopis (Prosopis juliflora)
t201 – Smrek obyčajný (Picea excelsa)
t37 – Tisovec dvojradový (Taxodium distichum)
t96 – Topoľ biely (Populus alba)
t14 – Topoľ (Populus spp)
t218 – Vresna (Myrica spp)
t12 – Vŕba biela (Salix alba)
t210 – Vtáčí zob obyčajný (Ligustrum vulgare)
POTRAVINOVÉ ALERGÉNY
Koreniny
f271 − Aníz (Pimpinella anisum)
f269 − Bazalka (Ocimum basillicum)
f278 − Bobkový list (Laurus nobilis)
f280 − Čierne korenie (Piper nigrum)
f279 − Čili (Capsicum frutescens)
f272 − Estragón (Artemisia dracunculus)
f219 − Fenikel (Foeniculum vulgare)
f89 − Horčica (Sinapis spp)
f19 − Kajenské korenie (Pepper cayenne)
f281 − Kari korenie
f268 − Klinček (Syzygium aromaticum)
f317 − Koriander (Coriandrum sativum)









f277 − Kôpor (Anethum graveolens)
f274 − Majoránka (Origanum majorana)
f405 − Mäta (Mentha piperita)
f282 − Muškátový oriešok (Myristica fragrans)
f283 − Oregano (Origanum vulgare)
f218 − Paprika (Capsicum annuum)
f265 − Rasca (Carum carvi)
f344 − Šalvia lekárska (Salvia o cinalis)
f220 − Škorica (Cinnamomum spp.)
f273 − Tymián (Thymus vulgaris)
f234 − Vanilka (Vanilla planifolia)
F270 – Zázvor (Zingiber o cinale)
Mäso




f26 − Mäso bravčové
f27 − Mäso hovädzie
f88 − Mäso jahňacie
f213 − Mäso králičie (Oryctolagus cuniculus)
f83 − Mäso kuracie
f284 − Mäso morčacie
Mlieko
f76 − Alfa-laktalbumín
f77 − Beta-laktoglobulín



f79 − Glutén



Laboratórna diagnostika 23
Imunológia a alergológia
f360 − Jogurt
f78 − Kazeín
f409 − Mlieko kozie
f2 − Mlieko kravské
f231 − Mlieko kravské prevarené
f236 − Srvátka
Obilniny
f6 − Jačmeň (Hordeum vulgare)
f8 − Kukurica
f7 – Ovsená múka
f56 − Pohánka (Fagopyrum esculentum)
f56 – Proso lúpané (pšeno)
f55 – Proso (Panicum miliaceum)
f4 – Pšenica múka
f5 – Raž múka (Secale cereale)
f9 – Ryža (Oryza sativa)

Orechy a jadrá
f299 − Gaštan jedlý (Castanea sativa)
f20 − Mandľa (Amygdalus communis)
f13 – Orech arašidový (Arachis hypogaea)
f202 − Orech kešu (Anacardium occidentale)
f17 − Orech lieskový (Corylus avellana)
f345 − Orech makadamský (Macadamia spp)
f18 – Orech para (Bertholletia excelsa)
f201 − Orech pekanový (Carya illinoensis)
t253 – Orech píniový (Pinus edulis)
f256 – Orech vlašský (Juglans regia)
f203 – Pistácie (Pistacia vera)
Ostatné
f358 − Artičoky (Cynara scolymus)
f21 − Cukrová trstina (Saccharum o cinarum)
f222 − Čaj čierny (Camellia sinensis)
f105 − Čokoláda (Theobroma cacao)
f90 – Jačmenný/pivný slad
f93 − Kakao (Theobroma cacao)
f221 − Káva (Co ea spp.)
f224 − Mak (Papaver somniferum)
f247 − Med
f223 – Oliva zelená (Olea europea)
f212 – Pečiarka záhradná –Šampiňón (Agaricus hortensis)
f403 – Saccharomyces carlsbergensis (Pivovarské kvasinky)
f45 – Saccharomyces cerevisiae (Pekárenské kvasinky)
f10 – Sézam (Sesamum indicum)
Ovocie
f210 − Ananás (Ananas comosus)
f96 − Avokádo (Persea americana)
f92 − Banán (Musa spp.)
f95 − Broskyňa (Prunus persica)
f341 − Brusnica (Vaccinicum vitis-idaea)
f208 − Citrón (Citrus limon)













f242 − Čerešňa (Prunus avium)
f288 − Čučoriedka (Vaccinium myrtilleus)
f289 − Datle (Phoenix dactylifera)

f402 − Figa (Ficus carica)
f209 − Grapefruit (Citrus paradisi)
f259 − Hrozno (Vitis vinifera)
f94 − Hruška (Pyrus communis)
f301 − Hurmikaki (Diospyros kaki)
f49 − Jablko (Malus sylvestris)
f44 − Jahoda (Fragaria vesca)
f102 − Kantalup (Cucumis melo L. var. Cantalupensis)
f84 − Kivi (Actinidia deliciosa)
f36 – Kokos (Cocos nucifera)
f306 − Limetka (Citrus aurantifolia)
f343 − Malina (Rubus idaeus)
f302 − Mandarínka (Citrus reticulata)
f91 − Mango (Mangifera indica)
f294 − Marakuja (Passiflora edulis)
f237 − Marhuľa (Prunus armeniaca)
f329 − Melón vodový (Citrullus lanatus)
f87 − Melón žltý (Cucumis melo)
f401 – Mišpula (Eriobotrya japonica)
f293 − Papája (Carica papaya)
f25 − Paradajka (Solanum lycopersicum)
f33 − Pomaranč (Citrus sinensis)
f255 − Slivka (Prunus domestica)
Ryby a iné vodné živočíchy

f313 − Ančovičky
f408 − Belička
f24 − Garnát
f303 − Halibut
f80 − Homár
f381 − Chňapal červený
f59 − Chobotnica
f258 − Kalmár
f23 − Krab
f338 − Lastúra
f41 − Losos
f349 – Losos keta ikry (Oncorhynchus keta)
f50 − Makrela japonská (Scomber japonicus)
f206 − Makrela obyčajná (Scomber scombrus)
f312 − Mečúň obyčajný (Xiphias gladius)
f3 37 − Morský jazyk (Solea solea)
f207 – Mušľa (Ruditapes spp.)
f65 − Ostriež (Perca spp)
f147 − Platesa (Pleuronectes platessa)
f254 − Platesovité ryby
f204 − Pstruh (Oncorhynchus mykiss/ Salmo gairdnieri)
f320 − Rak riečny (Astacus astacus)
f61 − Sardinka (Sardinops melanosticta)
f37 − Slávka jedlá (Mytilus edulis)
f205 − Sleď (Clupea harengus)
f314 − Slimák (Helix pomatia)
f350 – Treska aljašská ikry (Gadus chalcogrammus)
f3 – Treska obyčajná (Gadus morhua)
f42 – Treska škvrnitá (Melanogrammus aeglefinus)
f40 − Tuniak (Thunnus albacares)
f290 − Ustrica (Ostrea edulis)
Strukoviny
f309 − Cícer (Cicer arietinum)
f15 − Fazuľa biela (Phaseolus vulgaris)
f287 − Fazuľa červená (Phaseolus vulgaris)
f182 − Fazuľa mesiacovitá (Phaseolus lunatus)
f300 – Fazuľa Pinto (Phaseolus vulgaris)
f315 – Fazuľa zelená (Phaseolus vulgaris)
f12 – Hrach (Pisum sativum)
f14 – Sója (Glycine max)
f265 – Šošovica (Lens esculenta)
Syr

f81 − Syr čedar
f67 − Syr parmezán
f82 − Syr s plesňou
f170 − Syr švajčiarsky
Vajce
f245 − Vajce slepačie
f1 − Vaječný bielok
f75 − Vaječný žĺtok
f232 − Ovalbumín
f233 − Ovomukoid

Zelenina
f262 − Baklažán
f260 − Brokolica
f47 − Cesnak
f48 − Cibuľa
f216 − Kapusta biela (Brassica oleracea)
f291 − Karfiol (Brassica oleracea var. botrytis)
f217 – Kel ružičkový (Brassica oleracea var. gemmifera)
Laboratórna diagnostika 24
f31 − Mrkva (Daucus carota)
f263 − Paprika (Capsicum annuum)
f86 − Petržlen (Petrosilenum crispum)
f119 − Reďkev siata (Raphanus sativus)
f406 − Rukola (Eruca vesicaria ssp. sativa)
f54 − Sladký zemiak (Ipomoea batatas)
f215 – Šalát hlávkový (Lactuca sativa)
f261 − Špargľa (Asparagus o cinalis)
f214 − Špenát (Spinachia oleracea)
f225 − Tekvica (Cucurbita pepo)
f244 − Uhorka (Cucumis sativus)
f85 − Zeler (Apium graveolens)
f35 − Zemiak (Solanum tuberosum)
ALERGÉNY – PANEL
– Mix byliny 1
(W1, W6, W9, W10, W11)
– Mix byliny 2

(W2, W6, W9, W10, W15)
– Mix byliny 3
(W6, W9, W10, W12, W20)
– Mix byliny 5
(W1, W6, W7, W8, W12)
– Mix byliny 6
(W9, W10, W11, W18)
– Mix byliny 7
(W7, W8, W9, W10, W12)
– Mix inhalačné 1 (G3, G6, T17, W1, W6)
– Mix inhalačné 2
(G6, M6, T3, W6)
– Mix inhalačné 3
(D1, E1, E2, E3)
– Mix inhalačné 4
(D1, E1, E3, E5, I6, M2)
– Mix inhalačné 5 (G12, G15, M3, M6)
– Mix inhalačné 6 (G6, M2, M6, T3, W6)
– Mix inhalačné 7 (D1, E1, E3, E5, E82)
– Mix inhalačné 8
(D1, E1, E5, G6, G12, M2, T3, W6)
– Mix inhalačné 9

(E1, E5, G4, M6, W9)
– Mix inhalačné 10
(T9, T11, T23, W9, W21)
– Mix plesne 1
(M1, M2, M3, M5, M6)
– Mix potraviny 1
(F13, F17, F18, F20, F36)
– Mix potraviny 2
(F3, F24, F37, F40, F41)
– Mix potraviny 3
(F4, F7, F8, F10, F11)
– Mix potraviny 4 (F4, F8, F9, F10, F11)
– Mix potraviny 5
(F1, F2, F3, F4, F13, F14)
– Mix potraviny 6
(F4, F9, F10, F11, F14)
– Mix potraviny 7
(F1, F2, F4, F9, F13, F14)
– Mix potraviny 8
(F8, F10, F11, F23, F24)
– Mix potraviny 13 (F12, F15, F31, F35
– Mix potraviny 15
(F33, F49, F92, F95)
– Mix potraviny 24
(F17, F24, F84, F92)
– Mix potraviny 25
(F10, F45, F47, F85)
– Mix potraviny 26
(F1, F2, F13, F89)
– Mix potraviny 27
(F3, F4, F14, F17)
– Mix potraviny 28
(F10, F24, F27, F84)
– Mix potraviny 50
(F84, F91, F92, F210)
– Mix potraviny 51
(F25, F31, F35, F47, F89)
– Mix potraviny 73
(F26, F27, F83, F88)
– Mix prach a roztoče 1
(D1, D2, H1, I6)
– Mix profesné 1










(E3, E4, E70, E85)
– Mix roztoče 1
(D1, D2, D3, D71, D72, D73, D74, D201)
– Mix stromy 1
(T1, T3, T7, T8, T10)
– Mix stromy 2
(T1, T7, T8, T14, T22)
– Mix stromy 3
(T6, T7, T8, T14, T20)
– Mix stromy 4
(T7, T8, T11, T12, T14)
– Mix stromy 5
(T2, T4, T8, T12, T14)
– Mix stromy 6
(T1, T3, T5, T7, T10)
– Mix stromy 7
(T9, T12, T16, T18, T19, T21)
– Mix stromy 8
(T1, T3, T4, T7, T11)
– Mix stromy 9
(T2, T3, T4, T7, T12)
– Mix trávy 1
(G3, G4, G5, G6, G8)
– Mix trávy 2
(G2, G5, G6, G8, G10, G17)
– Mix trávy 3
(G1, G5, G6, G12, G13)
– Mix trávy 4
(G1, G5, G7, G12, G13)
– Mix trávy 5
(G1, G2, G3, G6, G7)
– Mix zvieratá 1
(E1, E3, E4, E5)
– Mix zvieratá 2
(E1, E5, E6, E87, E88)
– Mix zvieratá 70
(E6, E82, E84, E87, E88)
– Mix zvieratá 71 (E70, E85, E86, E89)
– Mix zvieratá 72 (E78, E91, E201)
MOLEKULÁRNA ALERGOLÓGIA
HMYZ
– Osa (Vespula vulgaris) rVes v 5
– Včela (Apis mellifera) rApi m 1
– Včela (Apis mellifera) rApi m 2
PLESNE –Aspergillus restrictus nAsp r 1
PRACHOVÉ
– Dermatophagoides farinae nDer f 1
– Dermatophagoides farinae nDer f 2
– Dermatophagoides pteronyssinus nDer p 1







– Dermatophagoides pteronyssinus nDer p 2
ZVIERACIE
– Mačka (Felis domesticus) nFel d 1 (A345)
– Pes (Canis familiaris) nCan f 1
Žiadanka na stiahnutie: www.unilabs.sk/ziadanky-tlaciva
Laboratórna diagnostika 25
Imunológia a alergológia
Mikrobiológia



Laboratóriá klinickej mikrobiológie poskytujú laboratórnu diagnostiku bakteriálnych, vírusových, mykotických a parazitárnych infekcií a laboratórnu diagnostiku infekcií vyvolaných mykobaktériami. Vykonávame aj laboratórnu diagnostiku na úrovni molekulárnej biológie a tiež nepriamy dôkaz infekčného agensa na základe tvorby protilátok.
Na oddeleniach infekčnej sérológie vykonávame diagnostiku na úrovni molekulárnej biológie ako priamy dôkaz DNA mikroorganizmov a ako nepriamy dôkaz mikroorganizmov na základe tvorby protilátok z krvi. Poskytujeme bakteriologické a mykologické kultivačné vyšetrenia klinického materiálu – výtery, punktáty, exudáty, laváže, spútum, sekréty, krv, stolica, moč, likvor, ako aj kanýl, katétrov, drénov a pod. Vyšetrenia poskytované v odbore klinickej mikrobiológie tak komplexne pokrývajú potreby lekárov pri diagnostike a kontrole liečby infekcií v rôznych miestach ľudského organizmu.
Mikrobiologické (bakteriologické, sérologické a PCR) laboratóriá poskytujú:















– kultiváciu a následnú identifikáciu vysokonáročných mikroorganizmov – anaeróbne baktérie, Gardnerella vaginalis, Campylobacter, Mycoplasma, Ureaplasma,
– dôkaz protilátok a antigénov bakteriálnych, vírusových a parazitárnych pôvodcov infekcií imunochemickými metódami; dôkaz DNA mikroorganizmov realizujeme hybridizačnými metódami a real time PCR,
– dôkaz protilátok a antigénov aglutinačnými metódami, – špecifické testy, ktoré môžu zistiť príčinu hepatitídy; medzi špecifické testy patrí detekcia zložiek vírusových častíc a protilátkovej odpovede v sére pacienta na vírusy HAV, HBV, HCV, EBV, HSV, CMV, VZV, – dôkaz antigénu vírusov, baktérií a parazitov zo stolice a respiračného traktu: rotavírusy, adenovírusy, norovírusy, RSV – respiračný syncyciálny vírus, vírus chrípky A, B, toxín Clostridium difficile A a B, antigén Gardia intestinalis, antigén Chlamydia trachomatis z výterov z urogenitálneho traktu imunochromatograficky,
– parazitologické vyšetrenie stolice na mikroskopický dôkaz vajíčok helmintov, cýst protozoí alebo dospelých parazitov, prípadne ich častí koncentračnou metódou sedimentačného typu a mikroskopicky, – diagnostiku tuberkulózy a iných mykobakterióz.
V prípade rezistencie mikroorganizmov alebo na požiadanie lekára okrem bežného antibiogramu ponúkame rozšírenie citlivosti o rezervné antibiotiká. Čas dodania výsledku vyšetrení je úzko závislý od typu vyšetrenia. Naše laboratóriá disponujú najmodernejšou technikou.
Na rutinnú identifikáciu mikroorganizmov využívame štandardné postupy a tiež hmotnostnú spektrometriu proteínov a peptidov pomocou laserovej desorpcie, vďaka ktorej sme schopní identifikovať baktérie a kvasinky počas niekoľkých minút. V mikrobiologickej diagnostike sa môžeme oprieť o moderné plnoautomatické analyzátory VITEK 2 na určenie minimálnych inhibičných koncentrácií antibiotík (výsledky od 8 do 18 hodín). Hoci sú tieto analyzátory na Slovensku stále unikátom, disponujeme nimi na všetkých mikrobiologických pracoviskách. Výsledky testov citlivosti sú interpretované a každoročne aktualizované podľa medzinárodnej antibiotickej smernice EUCAST. Vďaka VITEK-om sú výsledky našich vyšetrení rýchlejšie, presnejšie a kvalitnejšie. Za zmienku stojí aj ultramoderný systém na mikrobiologickú identifikáciu MALDI Biotyper. Tento hmotnostný spektrometer umožňuje presnú druhovú identifikáciu mikroorganizmov v priebehu niekoľkých minút.
V oblasti enzýmových imunochemických stanovení využívame jeden z najmodernejších automatických pipetorov EVO Clinical v spojení so systémom BEPIII analyzátorov, ktoré zvyšujú kvalitu, bezpečnosť a výkon klinického diagnostického procesu.
Aj vďaka progresívnej technike vieme poskytnúť výsledky parazitologických vyšetrení stolice a imunochromatografických vyšetrení do 24 hodín . Moderné technické a prístrojové vybavenie a nepretržitá centrálna ELISA prevádzka infekčnej sérológie ELISA je schopná poskytnúť prevažnú časť výsledkov sérologických vyšetrení do 48 hodín . V prípade pozi-
Laboratórna diagnostika 26
Rezistencia na antibiotiká
Infekcie horných a dolných dýchacích ciest
Vysvetlivky:


















Rezistencia 100 % znamená prirodzenú rezistenciu alebo klinickú neúčinnosť antibiotika pre daný bakteriálny druh
Rezistencia 0 – 10 % znamená, že antibiotikum možno použiť na empirickú liečbu
* kmeň citlivý pri vyššej expozícii daného antibiotika
Laboratórna diagnostika 28
G + koky (% R) G - paličky (% R) Staphylococcus aureus Streptococcus pyogenes Streptococcus pneumoniae Haemophilus influenzae Moraxella catharralis Amoxicilín + klavulanát 4 % 0 % 13 % 2 %* 0 % Amoxicilín 0 % 13 % 19 % 100 % Azitromycín 31 % 29 % 45 % 0 % 0 % Cefixím 0 % 0 % Cefuroxím 4 % 0 % 13 % 1 %* 0 %* Ciprofoxacín 2 %* 3 % 0 % Doxycyklín 2 % 25 % 26 % 0 % Erytromycín 31 % 29 % 45 % 100 % 0 % Klaritromycín 31 % 29 % 45 % 3 % 0 % Klindamycín 22 % 22 % 31 % 100 % Levofloxacín 3 % 1 %* 0 %* Moxifloxacín 0 % 0 % Oxacilín 4 % Penicilín 0 % 13 % 100 % Trimetoprím + sulfónamid 0 % 100 % 28 % 37 % 14 %



















Laboratórna diagnostika 29 Mikrobiológia Rezistencia na antibiotiká Klinický materiál G + koky (% R) Gpaličky (% R) Enterococcus faecalis Staphylococcus aureus Streptococcus agalactiae Streptococcus pyogenes Acinetobacter baumanii Citrobacter freundii Enterobacter cloacea Escherichia coli Klebsiella pneumoniae Proteus mirabilis Pseudomonas aeruginosa Amoxicilín + klavulanát 0 % 11 % 0 % 0 % 100 % 100 % 28 % 29 % 23 % 100 % Amoxicilín 0 % 0 % 0 % 100 % 100 % 100 % 51 % 100 % 65 % 100 % Ampicilín + sulbaktám 0 % 11 % 0 % 0 % 21 % 100 % 100 % 100 % Azitromycín 30 % 49 % 18 % Cefuroxím 100 % 11 % 0 % 0 % 100 % 100 % 100 % 16 % 31 % 30 % 100 % Ciprofl oxacín 15 % 9 %* 66 % 12 % 9 % 24 % 28 % 44 % 24 % Doxycyklín 4 % 73 % 65 % Erytromycín 30 % 49 % 18 % Gentamicín 52 % 6 % 4 % 8 % 19 % 30 % 16 % Klindamycín 100 % 23 % 46 % 10 % Klaritomycín 30 % 49 % 18 % Levofl oxacín 11 % 2 %* 1 %* 12 % 4 % 22 % 22 % Linezolid 0 % 0 % 0 % 0 % Mupirocín 3 % Moxifl oxacín 6 % 3 % 0 % 67 % 0 % Oxacilín 11 % Penicilín 0 % 0 % Tetracyklín 75 % 4 % 73 % 65 % 100 % 100 % Trimetoprím + sulfónamid 100 % 1 % 100 % 100 % 51 % 9 % 10 % 27 % 27 % 58 % 100 % Vankomycín 0 % 0 % Vysvetlivky: Rezistencia 100 % znamená prirodzenú rezistenciu alebo klinickú neúčinnosť antibiotika pre daný bakteriálny druh Rezistencia 0 –10 % znamená, že antibiotikum možno použiť na empirickú liečbu * kmeň citlivý pri vyššej expozícii daného antibiotika


















Laboratórna diagnostika 30 G + koky (% R) Gpaličky (% R) Enterococcus faecalis Enterococcus faecium Staphylococcus sp. koaguláza negat. Staphylococcus aureus Streptococcus agalactiae Citrobacter freundii Enterobacter cloacea Escherichia coli Klebsiella pneumoniae Proteus mirabilis Pseudomonas aeruginosa Amoxicilín 0 % 100 % 20 % 13 % 0 % 100 % 100 % 42 % 100 % 46 % 100 % Amoxicilín + klavulanát 0 % 100 % 20 % 13 % 0 % 100 % 100 % 34 % 34 % 32 % 100 % Azitromycín 58 % 33 % 53 % Cefuroxím 100 % 100 % 20 % 13 % 0 % 100 % 100 % 20 % 32 % 31 % 100 % Ciprofl oxacín 14 % 77 % 13 %* 16 %* 6 % 10 % 20 % 31 % 45 % 25 %* Doxycyklín 16 % 1 % 80 % Erytromycín 58 % 33 % 53 % Fosfomycín 33 % 1 % Gentamicín 11% 42 % 2 % 6 % 4 % 16 % 31 % 21 % Klaritromycín 58 % 0 53 % Klindamycín 21 % 23 % 48 % Levofl oxacín 19 % 75 % 2 %* Linezolid 0 % 0 % 0 % 0 % 0 % Nitrofurantoín 0 % 70 % 3 % 3 % 1 % 9 % 1 % 25 % 100 % 100 % Moxifl oxacín 5 % Oxacilín 20 % 13 % Tetracyklín 79 % 100 % 16 % 1 % 80 % 100 % 100 % Trimetoprím + sulfónamid 100 % 100 % 9 % 2 % 100 % 7 % 10 % 24 % 30 % 50 % 100 % Vankomycín 0 % 13 % 2 % 0 % Vysvetlivky: Rezistencia 100 % znamená prirodzenú rezistenciu alebo klinickú neúčinnosť antibiotika pre daný bakteriálny druh Rezistencia 0 –10 % znamená, že antibiotikum možno použiť na empirickú liečbu * kmeň citlivý pri vyššej expozícii daného antibiotika Rezistencia na antibiotiká Infekcie močových ciest
Rezistencia na antibiotiká



















Laboratórna diagnostika 31 Mikrobiológia G + koky (% R) Gpaličky (% R) Kvasinky (% R) Mykoplazmy (% R) Enterococcus faecalis Staphylococcus aureus Streptococcus agalactiae Escherichia coli Klebsiella pneumoniae Proteus mirabilis Candida albicans Candida non-albicans Mycoplasma hominis Ureaplasma species Amoxicilín 0 % 0 % 37 % 100 % 30 % Amoxicilín + klavulanát 0 % 6 % 0 % 27 % 17 % 12 % Azitromycín 32 % 54 % 100 % 1 % Cefuroxím 100 % 6 % 0 % 8 % 12 % 11 % Ciprofl oxacín 4 % 4 %* 9 % 9 % 19 % Doxycyklín 4 % 78 % 0 % 2 % Erytromycín 32 % 54 % 100 % 1 % Flukonazol 0 % 10 % Gentamicín 7 % 3 % 2 % 21 % Itrakonazol 0 % 7 % Klaritromycín 32 % 54 % 100 % 1 % Klindamycín 22 % 49 % 5 % 100 % Levofl oxacín 4 % 2 %* 0 % 3 % Moxifl oxacín 3 % 0 % 0 % Oxacilín 6 % Penicilín 0 % Tetracyklín 84 % 100 % 0 % 2 % Trimetoprím + sulfónamid 100 % 2 % 100 % 16 % 13 % 34 % Vysvetlivky: Rezistencia 100 % znamená prirodzenú rezistenciu alebo klinickú neúčinnosť antibiotika pre daný bakteriálny druh Rezistencia 0 –10 % znamená, že antibiotikum možno použiť na empirickú liečbu * kmeň citlivý pri vyššej expozícii daného antibiotika
Gynekologické infekcie
ŽIADANKA KLINICKÁ MIKROBIOLÓGIA – BAKTERIOLÓGIA A PARAZITOLÓGIA
INFEKCIE RESPIRAČNÉHO TRAKTU
26 Výter z tonzíl / hrdla
Amiesovo médium
– Kultivácia
– Kultivácia (preventíva)
– MRSA skríning
27 Výter z nosa
Amiesovo médium – Kultivácia
– Kultivácia (preventíva)
– MRSA skríning

28 Výter z laryngu Amiesovo médium – Kultivácia
29 Výter z nazofaryngu
Amiesovo médium – Kultivácia
30 Výter z dutiny ústnej
Amiesovo médium – Kultivácia
33 Ster z jazyka
Amiesovo médium – Kultivácia
31 Spútum
Sterilný kontajner/skúmavka – Kultivácia
32 Aspirát/sekrét
Sterilný kontajner/skúmavka – Kultivácia
BL Bronchoalveolárna laváž
Sterilný kontajner/skúmavka – Kultivácia
2F Výter z nosa na antigén chrípky
Tampón bez transportného média
– Dôkaz antigénu chrípky
2S Výter z nazofaryngu na RSV
Tampón bez transportného média
– Dôkaz antigénu RSV
INFEKCIA UROGENITÁLNEHO TRAKTU
38 Moč
Sterilná skúmavka
– Kultivácia (semikvantitatívne stanovenie)
– Mykológia
39 Výter z uretry
Tampón pre uretru s Amiesovým médiom
– Kultivácia
– Kultivácia na Neisseria gonorrhoeae
– Anaeróbna kultivácia
– Mikroskopia
40 Výter z pošvy
Amiesovo médium
– Kultivácia
– Skríning Streptococcus agalactiae v gravidite
– Anaeróbna kultivácia
– Mikroskopia
41 Výter z cervixu
Amiesovo médium
– Kultivácia
– Kultivácia na Neisseria gonorrhoeae
– Anaeróbna kultivácia
42 Ejakulát
Sterilný kontajner/skúmavka
– Kultivácia
– Kultivácia na Neisseria gonorrhoeae
– Anaeróbna kultivácia
XY Urogenitálny materiál
Odberová súprava na Trichomonas vaginalis
Kultivácia na Trichomonas vaginalis
– uretra
– pošva


XY Urogenitálny materiál
Dakronový tampón vytrepať do média na urogenitálne mykoplazmy Kultivácia na mykoplazmy a ureaplazmy + citlivosť
– uretra
– cervix
– moč (prvý ranný moč)
XY Urogenitálny materiál
Suchý tampón bez média na dôkaz antigénu Chlamydia trachomatis Chlamydia trachomatis antigén
– uretra
– cervix















– moč (prvý ranný moč – len muži)
INFEKCIA GASTROINTESTINÁLNEHO TRAKTU
35 Výter z rekta
Amiesovo médium
– Kultivácia
– Kultivácia (preventíva)
– Mykológia
35 Výter z rekta
Amiesovo médium
– Karbapenemáza skríning
36 Stolica
Nádobka
– Kultivácia
– Mykológia
– Clostridium di cile toxín
– Adenovírus a Rotavírus antigén
– Norovírus antigén
– Giardia intestinalis antigén
– Helicobacter pylori antigén
55 Tkanivo z biopsie
Sterilná nádoba
– Helicobacter pylori mikroskopia a ureázový test
37 Perianálny zlep 1.
Zlep na podložnom sklíčku – Mikroskopia
2P Perianálny zlep 2.
Zlep na podložnom sklíčku – Mikroskopia
3P Perianálny zlep 3.
Zlep na podložnom sklíčku – Mikroskopia
36 Stolica 1.
Nádobka
– Protozoá a helminty
2A Stolica 2.
Nádobka – Protozoá a helminty
3A Stolica 3.
Nádobka – Protozoá a helminty
Laboratórna diagnostika 32
OSTATNÉ INFEKCIE – KLINICKÝ MATERIÁL
43 Ľavé oko (spojivkový vak)
Amiesovo médium – Kultivácia
44 Pravé oko (spojivkový vak)
Amiesovo médium – Kultivácia
57 Výter z ľavého vonkajšieho zvukovodu
Amiesovo médium – Kultivácia
45 Výter z pravého vonkajšieho zvukovodu
Amiesovo médium – Kultivácia
UT Uterus – Kultivácia
54 Materské mlieko
Sterilná nádobka, skúmavka – Kultivácia
46 Ster z kože
Amiesovo médium – Kultivácia
47 Ster z rany
Amiesovo médium – Kultivácia – Kultivácia (aeróbna, anaeróbna)

49 Hnis (lokalizácia)
Sterilný kontajner/striekačka s ihlou zapich. v gume – Kultivácia (aeróbna, anaeróbna)
DK Dekubit – Kultivácia
48 Punktát z abscesu/výpotku
Sterilný kontajner/striekačka s ihlou zapich. v gume – Kultivácia (aeróbna, anaeróbna) – Mikroskopia
53 Plodová voda
Sterilný kontajner/skúmavka – Kultivácia (aeróbna, anaeróbna)
KT Katéter
Sterilná skúmavka – Kultivácia
KN Kanyla
Sterilná skúmavka – Kultivácia
SP Špička
Sterilná skúmavka – Kultivácia
70 Iný klinický materiál – Kultivácia
HEMOKULTÚRA
– 1. odber – 2. odber – 3. odber
H5 Ster z kože z miesta vpichu pred odberom hemokultúry – Kultivácia
H1 Hemokultúra
Bio Hem Bact/Alert FA Plus – aerobic – Aeróbna a mykologická kultivácia
H2 Hemokultúra
Bio Hem Bact/Alert FN Plus – anaerobic – Anaeróbna kultivácia
H4 Hemokultúra
Bio Hem BactAlert PF Plus – pediatric – Aeróbna, anaeróbna a mykologická kultivácia
ŽIADANKA O VYŠETRENIE − DIAGNOSTIKA
KULTIVÁCIA MYKOBAKTÉRIÍ
TS Spútum
Sterilný kontajner – Kultivácia, mikroskopia
TB Bronchoalveolárny výplach
Sterilný kontajner – Kultivácia, mikroskopia
TM Moč
Sterilný kontajner 60 ml – Kultivácia



TP Punktát
Sterilný kontajner, skúmavka – Kultivácia, mikroskopia
TL Likvor
Sterilná skúmavka – Kultivácia, mikroskopia
TR Laryngeálny výter
1. tampón na drôte – Kultivácia
TR Laryngeálny výter
2. tampón na drôte
TR Laryngeálny výter
3. tampón na drôte
TK Iný klinický materiál – Kultivácia, mikroskopia
PRIAMA DIAGNOSTIKA TBC (PCR)
TS Spútum
Sterilný kontajner – Priama diagnostika TBC
TB Bronchoalveolárny výplach
Sterilný kontajner – Priama diagnostika TBC
TP Punktát
Sterilný kontajner, skúmavka – Priama diagnostika TBC
TL Likvor














Sterilná skúmavka – Priama diagnostika TBC

Laboratórna diagnostika 33 Mikrobiológia
TBC
QUANTIFERON
–IMUNOLOGICKÝ TEST NA DÔKAZ INTERFERÓNU GAMA (NEPRIAMY DÔKAZ TBC)
QS Quantiferon NIL 22 °C (+/−5 °C) – IGRA Test (Quantiferon)


Quantiferon QTB1 22 °C (+/−5 °C)
Quantiferon QTB2 22 °C (+/−5 °C)
QF Quantiferon MITOGEN 22 °C (+/−5 °C)
ŽIADANKA O VYŠETRENIE − MYKOLÓGIA
DERMATOMYKÓZY (dermatofytózy, kandidózy, keratomykózy)
61 Vlasy
Sterilný kontajner, skúmavka – Kultivácia, mikroskopia – Citlivosť
62 Nechty
Sterilný kontajner, skúmavka – Kultivácia, mikroskopia – Citlivosť
63 Šupiny
Sterilný kontajner, skúmavka – Kultivácia, mikroskopia – Citlivosť
64 Chlpy
Sterilný kontajner, skúmavka – Kultivácia, mikroskopia – Citlivosť
65 Iný materiál
Sterilný kontajner, skúmavka – Kultivácia, mikroskopia – Citlivosť
DÔKAZ DERMATOFYTOV (PCR)
MV Vlasy
Sterilný kontajner, skúmavka – Dôkaz DNA dermatofytov
MN Nechty
Sterilný kontajner, skúmavka – Dôkaz DNA dermatofytov
MS Šupiny
Sterilný kontajner, skúmavka – Dôkaz DNA dermatofytov
MH Chlpy

Sterilný kontajner, skúmavka – Dôkaz DNA dermatofytov
MK Iný materiál
Sterilný kontajner, skúmavka – Dôkaz DNA dermatofytov
INVAZÍVNE MYKÓZY
Poznámka: V prípade pozitívneho kultivačného nálezu laboratórium automaticky poskytuje citlivosť na relevantné antimykotiká.
BL Bronchoalveolárny
výplach
Sterilný kontajner (2-8 °C)
– Kultivácia, mikroskopia
BD Bronchoalveolárny
výplach
Sterilný kontajner (2-8 °C)
– DNA Aspergillus species kvalitatívne
– DNA Pneumocystis jirovecii kvalitatívne
– DNA Cryptococcus neoformans kvalitatívne
– DNA Mucorales species kvalitatívne
L2 Bronchoalveolárny
výplach
Sterilný kontajner (2-8 °C)
– Aspergillus galactomannan antigén
31 Spútum
Sterilný kontajner, skúmavka (2-8 °C)
Poznámka: Spútum musí byť z dolných ciest dýchacích.
– Kultivácia, mikroskopia
SD Spútum
Sterilný kontajner, skúmavka (2-8 °C)
Poznámka: Spútum musí byť z dolných ciest dýchacích.
– DNA Cryptococcus neoformans kvalitatívne
– DNA Mucorales species kvalitatívne
VN Výplach prínosových dutín
Sterilný kontajner, skúmavka (2-8 °C)
– Kultivácia, mikroskopia
9B Likvor




Sterilná skúmavka (2-8 °C)
– Cryptococcus neoformans antigén











Laboratórna diagnostika 34
LD Likvor
Sterilná skúmavka (2-8 °C)
– DNA Aspergillus species
kvalitatívne
– DNA Cryptococcus neoformans kvalitatívne
38 Moč
Sterilná skúmavka (2-8 °C)
– 1. vzorka:
– 2. vzorka:
– Kultivácia, mikroskopia
*Bez prítomnosti močového katétra
65 Iný materiál
Sterilný kontajner, skúmavka
– Kultivácia, mikroskopia
01 Krv na sérum
Antigény
– Aspergillus galactomannan antigén
– Candida mannan antigén
– Cryptococcus neoformans antigén
Protilátky
– Anti Aspergillus IgG
– Anti Candida albicans IgM, IgA, IgG
SE Krv na sérum
– DNA Aspergillus species kvalitatívne
– DNA Cryptococcus neoformans kvalitatívne
– DNA Mucorales species kvalitatívne
ŽIADANKA INFEKČNÁ SÉROLÓGIA, PRIAMY DÔKAZ MIKROORGANIZMOV
INFEKČNÁ SÉROLÓGIA
01 Krv na sérum
VÍRUSOVÉ HEPATITÍDY
Hepatitída A
– Anti HAV IgM




– Anti HAV total
Hepatitída C
– Anti HCV IgG (skríning, konfirmácia Line Blot)
Hepatitída B
– HBsAg
– Anti HBs
– Anti HBc IgM
– Anti HBc total
– HBeAg
– Anti HBe
SYFILIS
– RRR, anti Treponema pallidum
AIDS
– Anti HIV 1/2, p24 HIV antigén
HERPETICKÉ VÍRUSY
CMV
– Anti CMV IgM, IgG (skríning)
– Anti CMV IgG avidita
– Anti CMV IgM, IgG (konfirmácia, Line Blot)
EBV
– Anti EBV – VCA IgM, IgG, EBNA-1 IgG (skríning), IM test
– Anti EBV – heterofilné protilátky: IM test
– Anti EBV IgM (konfirmácia Line Blot)
– Anti EBV IgA (konfirmácia Line Blot)
– Anti EBV IgG (konfirmácia Line Blot)
Iné
– Anti HSV 1/2 IgM, IgG (Herpes simplex)
– Anti VZV IgM, IgG (Varicella zoster)
RESPIRAČNÉ VÍRUSY
Chrípka
– Anti Influenza A, B, IgM, IgG
Iné
– Koronavírus SARS-CoV-2 protilátky €
– Anti Adenovirus IgM, IgG
– Anti RSV IgM, IgG (respiračný syncyciálny vírus)
INÉ VÍRUSY
– Anti Rubeola IgM, IgG
– Anti Morbilli IgM, IgG
– Anti TBEV (kliešťová encefalitída) IgM, IgG
– Anti Parotitis IgM, IgG
– Anti Parvovirus B19 IgM, IgG
BORÉLIE
– Anti Borrelia spp. IgM, IgG (skríning + konfirmácia, Line Blot)
– Anti Borrelia spp. IgM, IgG (konfirmácia Line Blot)
CHLAMÝDIE A MYKOPLAZMY
– Anti Chlamydia trachomatis IgM, IgA, IgG (skríning)
– Anti Chlamydia pneumoniae IgM, IgA, IgG (skríning)
– Anti Chlamydia spp. IgA, IgG (konfirmácia Line Blot)
– Anti Mycoplasma pneumoniae IgM, IgA, IgG (skríning)
– Anti Mycoplasma pneumoniae IgM, IgA, IgG (konfirmácia Line Blot)
INÉ BAKTÉRIE
– Anti Bordetella pertussis IgA, IgG (odobrať 2 vzorky s odstupom 2 – 4 týždňov)
– Anti Bordetella parapertussis (aglutinácia) (odobrať 2 vzorky s odstupom 3 týždňov)
– Anti Legionella pneumophila IgM, IgG
– Anti Helicobacter pylori IgM, IgA, IgG
– Anti Yersinia spp. IgA, IgG (skríning)









– Anti Yersinia spp. IgA, IgG (konfirmácia Line Blot)






– Anti Salmonella (Widalova reakcia)
ANTROPOZOONÓZY
Toxoplasma gondii
– Anti Toxoplasma gondii IgM, IgG (skríning)
– Anti Toxoplasma gondii IgG avidita
– Anti Toxoplasma gondii KFR
– Anti Toxoplasma gondii IgA (ELISA)
– Anti Toxoplasma gondii IgE (ELISA)
Laboratórna diagnostika 35 Mikrobiológia
– Anti Toxoplasma gondii IgM, IgA (konfimácia Line Blot)
– Anti Toxoplasma gondii IgG (konfirmácia Line Blot)


Toxocara canis
– Anti Toxocara canis IgG
– Anti Toxocara canis IgA
– Anti Toxocara canis IgG avidita
Iné
– Anti Brucella abortus IgM, IgG (ELISA)

– Anti Listeria monocytogenes, anti Listeria ivanovii (aglutinácia)
– Anti Francisella tularensis (aglutinácia)
– Anti Echinococcus IgG



– Anti Trichinella spiralis IgG
– Anti Schistosoma mansoni IgG
– Anti Taenia solium IgG







– Anti Entamoeba histolytica IgG
FUNGÁLNE PATOGÉNY
– Candida – mannan antigén

– Candida – mannan protilátky IgM, IgA, IgG
– Aspergillus fumigatus galactomannan antigén
– Aspergillus protilátky IgG
– Cryptococcus neoformans antigén (aglutinácia)
04 Moč
– Legionella pneumophila – antigén
QUANTIFERON – IMUNOLOGICKÝ TEST NA DÔKAZ INTERFERÓNU
GAMA (NEPRIAMA DIAGNOSTIKA TBC)
QS Quantiferon NIL

22 °C (+/- 5 °C)
IGRA test (Quantiferon)
QTB1 Quantiferon QTB1
22 °C (+/- 5 °C)
IGRA test (Quantiferon)
QTB2 Quantiferon QTB2
22 °C (+/- 5 °C)
IGRA test (Quantiferon)
QF Quantiferon MITOGEN
22 °C (+/- 5 °C)
IGRA test (Quantiferon)
PRIAMY DÔKAZ MIKROORGANIZMOV
NO Výter
tampóny v transportnom médiu (4 ˚C)
VÝTER Z NAZO A OROFARYNGU
– RNA Koronavírus SARS-CoV-2



– RNA Influenza vírus A, B RNA RSV A, B
FD Výter
tampón v prízdnej skúmavke (2 – 8 ˚C) mraziť > 12 hod.
VÝTER Z NAZOFARYNGU
– DNA Chlamydia pneumoniae
kvalitatívne
– DNA Mycoplasma pneumoniae
kvalitatívne
CH Výter z cervixu na HPV
tampón na hlien + odberová súprava na HPV (2 – 8 ˚C)
VÝTER Z CERVIXU NA HPV
– Dôkaz vysokorizikových HPV
UH Ster + výter
uretrálny tampón + odberová súprava na HPV (2 – 8 ˚C)
STER Z GLANS PENISU + VÝTER
Z URETRY NA HPV
– Dôkaz vysokorizikových HPV
DNA €
CD Výter
cobas PCR Media Dual Swab Sample Kit (2 – 8 °C)
VÝTER Z CERVIXU
– DNA Chlamydia trachomatis
kvalitatívne
– DNA Neisseria gonorrhoeae
kvalitatívne
– DNA Mycoplasma hominis
kvalitatívne
– DNA Mycoplasma genitalium
kvalitatívne
– DNA Ureaplasma species
kvalitatívne
– DNA HSV 1 kvalitatívne
– DNA HSV 2 kvalitatívne
VD Výter
cobas PCR Media Uni Swab Sample Kit (2 – 8 °C)
VÝTER Z VAGÍNY
– DNA Chlamydia trachomatis
kvalitatívne
– DNA Neisseria gonorrhoeae
kvalitatívne
– DNA Mycoplasma hominis kvalitatívne
– DNA Mycoplasma genitalium
kvalitatívne
– DNA Ureaplasma species kvalitatívne
– DNA HSV 1 kvalitatívne
– DNA HSV 2 kvalitatívne
UD Výter
cobas PCR Media Dual Swab Sample (2 – 8 °C)
VÝTER Z URETRY NA DNA
– DNA Chlamydia trachomatis
kvalitatívne
– DNA Neisseria gonorrhoeae kvalitatívne
– DNA Mycoplasma hominis kvalitatívne
– DNA Mycoplasma genitalium kvalitatívne
– DNA Ureaplasma species kvalitatívne
– DNA HSV 1 kvalitatívne
– DNA HSV 2 kvalitatívne
MD Moč
sterilný kontajner + cobas PCR Urine
Sample Kit (2 – 8 °C)
STERILNÝ MOČ
– DNA Chlamydia trachomatis kvalitatívne
– DNA Neisseria gonorrhoeae
kvalitatívne
– DNA Mycoplasma hominis kvalitatívne
– DNA Mycoplasma genitalium kvalitatívne
– DNA Ureaplasma species kvalitatívne
OL Výter
tampón v prázdnej skúmavke (2 – 8 °C) mraziť > 12 hod.
VÝTER Z ĽAVÉHO OKA
– DNA Chlamydia trachomatis kvalitatívne
– DNA VZV kvalitatívne
– DNA HSV 1 kvalitatívne
– DNA HSV 2 kvalitatívne
OP Výter z pravého oka
tampón v prázdnej skúmavke (2 – 8 °C) mraziť > 12 hod.
VÝTER Z PRAVÉHO OKA
– DNA Chlamydia trachomatis kvalitatívne
– DNA VZV kvalitatívne
– DNA HSV 1 kvalitatívne
– DNA HSV 2 kvalitatívne
JD Ejakulát
sterilná skúmavka, 1 ml, 2 – 8 °C < 12 hod., mraziť > 12 hod. Ejakulát
– DNA Chlamydia trachomatis kvalitatívne
– DNA Neisseria gonorrhoeae kvalitatívne
Laboratórna diagnostika 36
€ Vyšetrenia označené týmto symbolom nie sú hradené zdravotnou poisťovňou a je možné ich objednať len na priamu úhradu.
– DNA Mycoplasma hominis kvalitatívne
– DNA Mycoplasma genitalium kvalitatívne
– DNA Ureaplasma species kvalitatívnePD
Punktát na DNA
sterilná skúmavka, 1 – 2 ml, 2 – 8 °C < 12 hod., mraziť > 12 hod.
PUNKÁT NA DNA
– DNA Chlamydia trachomatis kvalitatívne
– DNA Chlamydia pneumoniae kvalitatívne
– DNA Borrelia burgdorferi s. l. kvalitatívne
– DNA Mycoplasma pneumoniae kvalitatívne
– DNA Neisseria gonorrhoeae kvalitatívne
– DNA Mycoplasma hominis kvalitatívne (PCR)

– DNA Mycoplasma genitalium kvalitatívne
– DNA Ureaplasma species kvalitatívne
MD Moč
sterilný kontajner
2 – 8 °C < 12 hod., mraziť > 12 hod.
STERILNÝ MOČ
– DNA Borrelia burgdorferi s. l. kvalitatívne (PCR)
– DNA CMV kvantitatívne
– DNA EBV kvantitatívne
– DNA HSV 1 kvantitatívne
– DNA HSV 2 kvantitatívne
BD Bronchoalveolárna laváž
sterilná skúmavka, 2 – 3 ml, 2 – 8 °C < 12 hod., mraziť > 12 hod.

BRONCHOALVEOLÁRNA LAVÁŽ
– DNA CMV kvantitatívne
– DNA EBV kvantitatívne
– DNA HSV1 kvantitatívne
– DNA HSV2 kvantitatívne
– DNA VZV kvantitatívne
– DNA Chlamydia pneumoniae kvalitatívne
– DNA Mycoplasma pneumoniae kvalitatívne
RD Ster
dakrónový tampón + prázdna skúmavka (2 – 8°C), mraziť > 12 hod.
STER Z RANY
– DNA VZV kvalitatívne
– DNA HSV 1 kvalitatívne
– DNA HSV 2 kvalitatívne
ED Krv s EDTA

2 – 8 °C < 12 hod., mraziť > 12 hod. KRV s EDTA
















– DNA CMV kvantitatívne
– DNA EBV kvantitatívne
– DNA VZV kvantitatívne
– DNA HSV 1 kvantitatívne
– DNA HSV 2 kvantitatívne
– DNA Borrelia burgdorferi s. l. kvalitatívne (PCR)
– DNA Chlamydia pneumoniae kvalitatívne (PCR)
SD Spútum na DNA sterilný kontajner, 2 – 8 °C < 12 hod., mraziť > 12 hod.
SPÚTUM NA DNA
– DNA Chlamydia pneumoniae kvalitatívne
– DNA Mycoplasma pneumoniae kvalitatívne
XX Iný materiál na DNA Špecifikujte materiál
ŽIADANKA DIAGNOSTIKA COVID-19
NO, KLS Výter alebo KLS – Koronavírus SARS-CoV-2 RNA – Koronavírus SARS-CoV-2 RNA (PCR, kloktací test)
01 Krv na sérum – Koronavírus SARS-CoV-2 protilátky
01 Krv na sérum – Koronavírus SARS-CoV-2 postvakcinačné protilátky IgG €
Žiadanka na stiahnutie: www.unilabs.sk/ziadanky-tlaciva
Laboratórna diagnostika 37 Mikrobiológia
Genetika

Diagnostika ochorení v odbore lekárskej genetiky je vykonávaná v rámci vzájomnej spolupráce troch odborných pracovísk: ambulancie lekárskej genetiky, cytogenetického laboratória a laboratórií molekulárnej genetiky.
Pri podozrení na ochorenie, pri ktorom by mohol pacient profi tovať z genetickej laboratórnej diagnostiky, sú dve možnosti postupu. Len pri relatívne úzkej skupine molekulárno-genetických vyšetrení nazývaných aj rutinná diagnostika (potravinové intolerancie, trombofílie, celiakia a niektoré iné) je možná indikácia vyšetrenia viacerými špecialistami a odobratý materiál sa odošle priamo do genetického laboratória. Pri podstatne väčšej skupine ochorení defi novaných ako zriedkavé ochorenia je nutný manažment pacienta prostredníctvom ambulancie lekárskej genetiky.
Okruh pacientov v oblasti lekárskej genetiky je rozsiahly, rôznorodý a neustále rastie. K najbežnejším indikáciám patria nasledovné: – dieťa s vrodenou vývojovou chybou, – zaostávanie dieťaťa v psychomotorickom vývine, závažné poruchy reči, správania, učenia, – partnerský pár trpiaci primárnou neplodnosťou, opakovanými potratmi, narodením mŕtveho dieťaťa, – plánovanie gravidity v rodinách s genetickým ochorením,
– onkologické ochorenie u pacienta v mladom veku, – opakovaný výskyt onkologických ochorení v rodine,
– tehotenstvo so zvýšeným genetickým rizikom (patologické výsledky skríningu, USG, vysoký vek rodičov), – neurodegeneratívne ochorenia, – patologicky nízky vzrast, obezita, poruchy sluchu, zraku, – pacienti s výskytom atypického tromboembolizmu (mladý vek, neobvyklá lokalizácia, rekurencia), – pacienti s poruchami trávenia, suspektnými potravinovými intoleranciami, vrodenou hepatopatiou, – prognóza terapie niektorými cytostatikami, warfarínom a inými liečivami.
V prípade pochybností o najvhodnejšom postupe je optimálne konzultovať prípad so špecialistom v ambulancii lekárskej genetiky.
AKTUALIZOVANÉ














Cytogenetické laboratórium je vybavené modernými mikroskopmi Olympus, Nikon a Leica. Na urýchlenie kultivácie využívame CO2 inkubátor Memmert a N-BIOTEK. Na hodnotenie karyotypov používame hodnotiaci softvér LUCIA. Analýzu karyotypov realizujeme z leukocytov periférnej krvi a z amniocytov plodovej vody. Karyotypy sú hodnotené podľa medzinárodného štandardu ISCN 2020, podľa slovenských a medzinárodných štandardov sa hodnotí konvenčné farbenie, G- a C-prúžkovanie chromozómov.


V rámci molekulárnej genetiky využívame štandardné techniky PCR, real-time PCR, MLPA , MS-MLPA , fragmentačnú analýzu, ďalej metódu priameho sekvenovania (metóda sekvenovania podľa Sangera, ktorá je v súčasnosti považovaná za zlatý štandard v molekulárnej genetike), ako aj najmodernejšie diagnostické prístupy, akými sú napríklad sekvenovanie novej generácie, SNP microarray a onkogenetická FISH analýza. Pracoviská molekulárnej genetiky disponujú týmto prístrojovým vybavením: real-time PCR cykléry (LightCycler 480, Cobas z 480 od firmy Roche, Rotor-Gene 3000 od Corbett, Bio-Rad CFX96 a CFX Opus Real-Time PCR Systems), genetické analyzátory (3130xl od firmy Applied Biosystems) a najmodernejší, plne automatizovaný systém myCrobe od fi rmy GeneProof. Do laboratória v Banskej Bystrici pribudol minulý rok špičkový analyzátor 3500 Dx Genetic Analyzer (CE-IVD, IVDR).

Laboratórna diagnostika 38
ŽIADANKA O
− GENETIKA – RUTINNÁ DIAGNOSTIKA
RUTINNÁ DIAGNOSTIKA
Vyšetrovaný biologický materiál:
– Periférna krv (K3/K2 EDTA)
Ponuka vyšetrení:
TROMBOFILNÉ VARIANTY
Faktor II (Protrombín)
– F2 : 20210G>A (rs1799963)
Faktor V
– F5: 1691G>A − Leiden (rs6025)
Metyléntetrahydrofolátreduktáza
– MTHFR : 677C>T (rs1801133)
– MTHFR : 1298A>C (rs1801131)
Inhibítor aktivátora plazminogénu 1
– PAI1 : -675 4G⁄5G (rs1799768)
Faktor XIII
– F13A1 : Val34Leu (rs5985)
Doštičkové glykoproteíny
– ITGA2 : 807C>T (rs1126643)
– ITGB3 : Leu33Pro (rs5918)
Faktor XII
– F12 : 46C>T (rs1801020)
β -fibrinogén
– FGB : -455G>A (rs1800790)
FARMAKOGENETIKA
Metabolizmus tiopurínov
–TPMT: 238G>C, 460G>A, 719A>G (rs1800462, rs1800460, rs1142345)
Metabolizmus warfarínu
– CYP2C9 : 430C>T, 1075A>C; VKORC1 : -1639G>A (rs1799853, rs1057910, rs9923231)
ONKOHEMATOLÓGIA
– JAK2 : detekcia patogénneho variantu Val617Phe (rs77375493)
STANOVENIE MIKRODELÉCIÍ
– Mikrodelécie chromozómu Y (delécie v AZF oblasti)
DEDIČNÉ OCHORENIA
Celiakia
– HLA typizácia DQ2 a DQ8
Cystická fibróza
– CFTR : detekcia 67 patogénnych variantov
– CFTR : Phe508del (rs113993960)
Gilbertov syndróm
– UGT1A1 : promótor (A(TA)nTAA) (rs3064744)
Hereditárna hemochromatóza
1. typu
– HFE: His63Asp, Ser65Cys, Cys282Tyr (rs1799945, rs1800730, rs1800562)
HLA-B27 –Vyšetrenie prítomnosti rizikových alel
Intolerancia fruktózy
– ALDOB : ∆4E4, Ala149Pro, Ala174Asp, Asn334Lys (rs387906225, rs1800546, rs76917243, rs78340951)
Intolerancia laktózy
– LCT: -13910C>T (rs4988235)
Wilsonova choroba
– ATP7B : detekcia najčastejších patogénnych variantov (His1069Gln, Gln447Leufs*50, Ala1135Glnfs*13, Trp779Ter, Arg778Gly ) (rs76151636, rs1057517444, rs137853281, rs137853282, rs137853284)
ZRIEDKAVÉ OCHORENIA
Vyšetrovaný biologický materiál:
– Periférna krv (K3/K2 EDTA)
– Iný materiál
Typ diagnostiky:









– Prenatálna
– Postnatálna
Ponuka vyšetrení:
– Analýza aneuploídií
– Analýza genómu metódou SNP MICROARRAY / ARRAY CGH
– Analýza vybraného génu / génov / variantov
– Segregačná analýza
– NGS analýza panelu génov (podľa aktuálnej ponuky)
(Zoznam vyšetrení dostupný na: https://www.unilabs.sk/ziadanky-tlaciva)
SOMATICKÉ MUTÁCIE
Vyšetrovaný biologický materiál:
– Tkanivo
– Iný materiál
Ponuka vyšetrení:
– BRCA1, BRCA2 (všetky exóny)
– BRAF (kodóny 600 a 601)
– KRAS (kodóny 12, 13, 59, 61, 117 a 146)
– NRAS (kodóny 12, 13, 59, 61, 117 a 146)
– EGFR (exóny 18, 19, 20 a 21)
– MSI (mikrosatelitová nestabilita), treba dodať aj zdravé tkanivo
– ctDNA- KRAS (12,13,59,61,117 a 146 kodóny)
– ctDNA- NRAS (12,13,59,61,117 a 146 kodóny)
– ctDNA- BRAF (kodón 600)
– ctDNA- EGFR (18, 19, 20 a 21 exón)
– IDH1 (kodón 132)
– IDH2 (kodón 172)
– Metylácia promótora MLH1, treba dodať aj zdravé tkanivo
– Oblasť IS 6110 – Mycobacterium complex
– KIT (exóny 9, 11, 13, 17 a 18)
– PDGFRA (exóny 12, 14 a 18)








– POLE (286, 297, 367, 411, 436, 456, 459 kodóny)

– NSCLC- ALK, ROS1, RET, NTRK1/2/3 fúzie, MET ex14 skipping
– FOXL2 (c.402C>G)
– Somatický NGS panel génov
– CGP
FISH VYŠETRENIA
Vyšetrovaný biologický materiál:
– Tkanivo
– Iný materiál
Ponuka vyšetrení: Adenoidný cystický karcinóm
– t(6;9)(q22-23;p24.1) MYB/NFIB
– MYB (6q23.3)
Laboratórna diagnostika 40
VYŠETRENIE
Adenokarcinóm pľúc
– RET (10q11.21)
– KIF5B (10p11.22)
Burkittov lymfóm
– MYC (8q24.21)
Dermatofibrosarcoma protuberans – t(17;22)(q22;q13) COL1A1-PDGFB
– COL1A1 (17q21.33)
– PDGFB (22q13.1)
















Dezmoplastický tumor z malých okrúhlych buniek
– WT1 (11p13)
Dobre diferencovaný liposarkóm – delécia RB1
Endometriálny stromálny sarkóm, high-grade
– YWHAE (17p13.3)
Endometriálny stromálny sarkóm, low-grade – JAZF1 (7p15.1-p15.2)
Endometriálny stromálny tumor
– PHF1 (6p21.32)
Extraskeletal myxoid chondrosarcoma
– NR4A3 (9q22.33-q31.1)
Ewingov sarkóm – t(11;22)(q24;q12) EWSR1-FLI1
– ERG (21q22)
– EWSR1 (22q12.2)
Fibromyxoidný sarkóm
– FUS (16p11.2)
Folikulový lymfóm, Lymfóm z B-buniek
– BCL2 (18q21.33)
Glióm
– kodel. 1p/19q
– delécia CDKN2A/B – ampl. EGFR
Inflamatórny myofibroblastický tumor
– ALK (2p23)
Karcinóm prsníka – ampl. CTNNB1 (3p21)
Karcinóm prsníka a ovárií – BRCA1/CEN17q
Karcinóm prsníka a žalúdka – ampl. HER2
Karcinóm vaječníka
– trizómia chromozómu 12
Liposarkóm
– ampl. MDM2
Melanóm a iné zhubné nádory kože
– CCND1 (11q13.3) /2q11/CEN6
– CCND1 (11q13.3)
– ALK /2q11
– IRF,DUSP22 (6p25) – ampl. MYB
– KMT2A (11q23.3) – delécia CDKN2A/B
Mnohopočetný myelóm – t(11;14)(q13.3;q32.3)
CCND1-IGH
– IGH (14q32.33)
Mukoepidermoidny karcinóm – t(11;19)(q21;p13.1)
MAML2
Myxoidný liposarkóm
– DDIT3 (12q13.3)


Nemalobunkový karcinóm pľúc – ROS1 (6q22.1)
Nezhubný lipomatózny tumor, bližšie neurčený – delécia RB1
Non - Hodgkinov lymfóm
– BCL6 ( 3q27.3)
Osteosarkóm, Atypický lipomatózny tumor, Liposarkóm – ampl. CDK4
Papilárny karcinóm štítnej žľazy – RET (10q11.21)
Pilocytický astrocytóm
– BRAF/KIAA
– BRAF (7q34)
Pleomorfný lipóm/ lipóm vretenovitých buniek – delécia 13q – delécia 16q
Rabdomyosarkóm – ampl. MYOD1
Renálny bunkový karcinóm
– TFE3 (Xp11.23)
– TFEB (6p21.2)
Sarkóm mäkkých tkanív
– ETV6 (12p13.2)
Sarkómy s prestavbou génu BCOR
– BCOR (Xp11.4)
Solídne nádory
– NTRK1 (1q23.1)
– NTRK2 (9q21.33)
– NTRK3 (15q25.3)
Synoviálny sarkóm
– t(X;18)(p11;q11) SS18-SSX
– SS18 (18q11.2)
Mola hydatidosa (numerické aberácie chromozómov)
– CEN17 (alpha satellites)
– X (Xp11.1-q11.1)
– t(X;Y)(p11.1-q11.1;p11.1-q11.1) X/Y
Zhubný nádor maternice
– ampl. GLI1
CYTOGENETIKA
Vyšetrovaný biologický materiál:
– Periférna krv (Lítium heparín)
– Plodová voda
Ponuka vyšetrení:
– Karyotyp (periférna krv)
– Karyotyp (plodová voda)
SKRÍNINGOVÉ VYŠETRENIA
Vyšetrovaný biologický materiál:
– Periférna krv (K3/K2 EDTA)
– Guthrieho karta
Ponuka vyšetrení:
Ťažká kombinovaná imunodeficiencia
/agamaglobulinémia
– TREC/KREC
Spinálna svalová atrofia
– SMN1 : exón 7
Žiadanka na stiahnutie: www.unilabs.sk/ziadanky-tlaciva
Laboratórna diagnostika 41
Genetika
Patológia
Na rozdiel od iných laboratórnych pracovísk, kde hrá významnú úlohu prístrojová diagnostika, na pracoviskách patológie sú prístroje síce významným pomocníkom, ale výsledok vyšetrenia je najmä produktom individuálneho procesu diagnostiky lekárom – kvalifikovaným patológom. Ten definuje konečnú diagnózu, na základe ktorej klinickí lekári stanovujú ďalší postup liečby pacienta. Naše pracoviská – Diagnostické centrum patológie Bratislava, Diagnostické centrum patológie Košice, Diagnostické centrum patológie Banská Bystrica, Diagnostické centrum patológie Prešov a Patológia Topoľčany – sú výlučne laboratórnymi pracoviskami.
ROZSAH ČINNOSTI
Biopsia








Vyšetrenie tkanív a častí orgánov z operácií pacientov.
Peroperačná biopsia
Rýchla biopsia počas operácie pacienta. Operujúcemu lekárovi oznámi lekár – patológ výsledok bioptického vyšetrenia do 10 – 15 minút a ten podľa výsledku vyšetrenia modifikuje ďalší postup operácie.
Imunohistochemické vyšetrenia
Sú pomocné vyšetrenia k bioptickému a cytologickému vyšetreniu a pomáhajú vizualizovať:
• komponenty určujúce stupeň diferenciácie a histogenézy tkanív (svalový aktín, desmín, vimentín, epitelový-cadherín, cytokeratíny 5/6, 7, 8 a 20),
• markery onkogenézy, resp. dediferenciácie tkanív (karcinoembryonálny antigén, epitelový marker EMA, melan-A, lambda a kappa reťazec imunoglobulínu, molekula CD34, antigén PSA prostaty, proteín S-100, proteín Her2),
• proteohormóny a neuroendokrinné peptidy (gastrín, synaptophysín, somatostatín, chromogranín



A), proteíny regulujúce bunkové delenie (onkogény a anti-onkogény) a anti-apoptotické bielkoviny (proteíny p53, Ki-67, p16, bcl-2, receptor pre rastový faktor EGF, PCNA, survivin a iné).
Cytológia
Predstavuje vyšetrenie buniek získaných aktívnym odberom alebo spontánne uvoľnených z tela pacienta.
Gynekologická cytológia sa zameriava na prevenciu karcinómu krčka maternice, vyšetruje sa z náterov alebo metódou LBC (liquid based cytology). Iné cytologické vyšetrenia sa robia z punkcie orgánov či dutín a takisto možno spomenúť vyšetrenie telových tekutín na prítomnosť buniek a ich posúdenie hlavne z hľadiska prítomnosti zápalu alebo nádoru.
Imunofluorescenčné vyšetrenia







Pri diagnostike niektorých ochorení treba kombinovať ďalšie špeciálne vyšetrovacie metódy. Imunofl uo rescenciu využívame najmä v prípade, ak treba zvýrazniť prítomnosť a druh depozitov v štruktúrach tkanív a orgánov alebo séra pacientov. Ich prínos je teda najmä pri vyhľadávaní prítomnosti protilátok proti štruktúram buniek, tkanív a ich subštruktúr, ako aj pri stanovení druhu (auto) protilátok:
• antinukleárnych protilátok (ANA), protilátok proti bunkovým, tkanivovým a orgánovým komponentom, hlavne pri autoimunitných (systémových) ochoreniach, kolagenózach,
• protilátok proti spermiám, protilátok proti trofoblastu, proti ovariálnym štruktúram, hlavne pri vyšetrení neplodnosti,
• protilátok pri ochoreniach GITu, hlavne pri podozrení na celiakiu, autoimunitné hepatitídy, na diferenciálnu diagnostiku ulceróznej kolitídy, Crohnovej choroby a iných.
Imunofluorescenciu používame – okrem tejto diagnostiky – aj na tkanivách pri punkčnom vyšetrení obličiek, pri diferenciálnej diagnostike kožných chorôb a iných orgánov.
Histochemické vyšetrenia
Vykonávame aj vyšetrenie enzýmovej aktivity v natívnych vzorkách z tenkého čreva. Toto vyšetrenie sa vykonáva pri rôznych intoleranciách.
Za vopred dohodnutých podmienok realizujeme aj vyšetrenia vzoriek priečne pruhovaného svalu na diagnostiku myozitíd.
Podľa potrieb a požiadaviek klinických lekárov realizujeme aj ďalšie vyšetrenia.
Laboratórna diagnostika 42
– Stanovenie profilu protilátok pri autoimunitnom ochorení pečene: AMA-M2, M2-3E(BPO), Sp 100, PML, gp 210, LKM-1, LC-1, SLA/LP, Ro-52
– Stanovenie profilu protilátok pri Systémovej skleróze (SSc) profil (IgG): Ro-52, PDGFR, Ku, PM-Scl 75, PM-Scl-100, Th/To, NOR-90, Fibrillarin, RP 155 (RNAP-III), RP 11 (RNAP-III), CENP B, CENP A, Scl-70
– Stanovenie profilu ANCA protilátok: MPO (Myeloperoxidáza), PR3 (Proteináza 3)
– Stanovenie profilu neuronálnych protilátok (IgG): amfifyzín, CV2, PNMA2 (Ma-2/Ta), Ri, Yo, Hu


– Diferenciálna diagnostika colitis ulcerosa a morbus Crohn (stanovenie protilátok proti pankreasu, intestinal goblet cells, Saccharomyces cerevisiae, pANCA)
BIOPSIA
BVPLU – biopsia pľúc









BVKOS – biopsia kosti
BVLUZ – biopsia lymfatickej uzliny
BVSVA – biopsia svalu
BVMOZ– biopsia mozgu






BVPRS – biopsia prsníka
BVCER – biopsia cervixu
BVUTE – biopsia uteru
BVOVA – biopsia ovária
BVOBL – biopsia obličiek
BVPEC – biopsia pečene
BVPAN – biopsia pankreasu

BVPER – biopsia peritonea
BVPLE – biopsia pleury
BVPRO – biopsia prostaty
BVREK – biopsia rekta
BVKOZ – biopsia kože
BVSLE – biopsia sleziny
BVZAL – biopsia žalúdka
BVSEM – biopsia semenníka
BVSZL – biopsia štítnej žľazy
BVTKN – biopsia tkaniva
BVMOM – biopsia močového mechúra
BVNAD – biopsia nadobličky
BVKDR – biopsia kostnej drene
BVMAX – biopsia maxilofaciálnej oblasti
BVNFO – biopsia nazofaryngeálnej oblasti
BVLAR – biopsia laryngu
BVSLI – biopsia slinných žliaz
BVPBS – biopsia pankreatiko-bilárneho systému
BVMED – biopsia mediastina
BVPEN – biopsia penisu
BVVZG – biopsia vonkajšieho
ženského genitálu
BVVAJ – biopsia vajíčkovodu
BVNSD – biopsia nadsemenníka a semenných duktov
BVSTC – biopsia steny ciev
Bioptické vyšetrenie gastrointestinálneho traktu
PAZBI – biopsia pažeráka
GEFBI – biopsia gastroezofageálneho prechodu
KARBI – biopsia žalúdoka – kardia
TELBI – biopsia žalúdoka – telo
ANTBI – biopsia žalúdoka – antrum
INEZBI – biopsia žalúdoka – iné
DUOBI – biopsia tenkého čreva – duodenum
JEJBI – biopsia tenkého čreva – jejunum
ILEBI – biopsia tenkého čreva – ileum
INTCBI – biopsia tenkého čreva – iné
CEKBI – biopsia hrubého čreva – cekum
ASCBI – biopsia hrubého čreva – colon ascendens
TRANBI – biopsia hrubého čreva – colon transversum
DESCBI – biopsia hrubého čreva – colon descendens
SIGBI – biopsia hrubého čreva – sigma
RESIGBI –biopsia hrubého čreva – rektosigma
RECBI – biopsia hrubého čreva – rectum
INEBI – biopsia iné
BIINE – biopsia iné
DUODBI – biopsia tenkého čreva – duodenum DAO
TERBI – biopsia tenkého čreva – term. Ileum DAO
ENZÝMO-HISTOCHEMICKÉ VYŠETRENIE
LAKTEN – enzýmohistochémia – laktáza
SACHEN – enzýmohistochémia – sacharáza
TREHEN – enzýmohistochémia – trehaláza
MALTEN – enzýmohistochémia – maltáza
ALKFEN – enzýmohistochémia – alk. fosfatáza
TUKPEN – enzýmohistochémia – tuky
ACHEE – ehch. rectum – acetylcholínesteráza
Negynekologická cytológia
CVBAL – cytológia bronchoalveolárnej laváže
CVTEL – cytológia telesnej tekutiny
CVDLP – cytológia duktálnej laváže prsníka
CVTAP – cytológia tenkoihlov. aspirátu prsníka
CVBRU – cytológia bronchiálneho steru (BRUSH)
CVVZB – cytológia výtoku z bradavky
CVSPU – cytológia spúta
CVASZ – cytológia aspirátu štítnej žľazy
CVTAT – cytológia aspirátu z tkaniva
CVMOC – cytológia moču
CVLIK – cytológia likvoru
CVPAN – cytológia aspirátu pankreasu
CVALU – cytológia aspirátu lymfatickej uzliny
Gynekologická cytológia
CVCVS – cytológia cervik. alebo vagin. steru KC
CVSPA – cytológia cervik. alebo vagin. steru LBC
Žiadanka na stiahnutie: www.unilabs.sk/ziadanky-tlaciva
Laboratórna diagnostika 44
2. Odber















Spoločnosť Unilabs Slovensko ponúka
svojim klientom široké spektrum
odberového materiálu najvyššej kvality, a to celkom zdarma.
Z ponuky špičkového odberového materiálu si vyberie každý
U praktických lekárov i špecialistov je odber biologického materiálu na dennom poriadku. Naša spoločnosť Unilabs Slovensko zabezpečuje nielen transport odobratých vzoriek, ale aj kompletný sortiment uzavretého odberového systému Vacutest. Môžete sa pritom spoľahnúť na dostatočne širokú ponuku materiálu a stabilitu vzoriek. Ďalšou prednosťou je označovanie vzoriek čiarovými kódmi a práca s moderným informačným systémom, ktorý umožňuje zasielanie laboratórnych výsledkov v elektronickej podobe.
Dostatočne široká ponuka pre každého lekára
V ponuke uzavretého odberového systému Vacutest
nájdete:
• 24 typov skúmaviek na odber krvi a moču skúmavky s objemom pre dospelých i pediatrických pacientov
• skúmavky na vyšetrenia krvného obrazu ako antikoagulačné činidlo sa používa K2-EDTA alebo K3-EDTA
• skúmavky na sérologické vyšetrenia skúmavky so separačným gélom a s aktivátorom zrážania krvi
• skúmavky na odber a vyšetrenie koagulačných
parametrov

skúmavka obsahuje antikoagulant citrát sodný
• odberové sústavy potrebné na vybrané imunotesty skúmavky obsahujúce heparinát lítny
• špeciálne skúmavky s uzavretým systémom, ktoré slúžia na odber vzoriek moču pre dialýzy, kde hrozí väčšie riziko nákazy
• 8 druhov ihiel vrátane pediatrických ihiel a tzv. fly-ihiel


• zelené lancety, mikropipety, skúmavky na sliny či plastové i hliníkové tyčinky
• špeciálne súpravy s technológiou quantiferon na nepriamu diagnostiku tuberkulóznej infekcie
VÝHODY OD NÁS DODÁVANÝCH
ODBEROVÝCH SYSTÉMOV
– odberové systémy dodávame bezplatne – skúmavky so stabilizačnými činidlami – škrtidlá a FW stojany
ZABEZPEČÍME EDUKÁCIU
Lekárom a sestrám zabezpečujeme edukáciu so zameraním na postupy a metódy analýzy vzorky, spôsob realizácie správnej predanalytickej fázy a význam a interpretáciu výsledkov vo vzťahu ku klinickému stavu pacienta. Súčasťou vzdelávania sú aj praktické ukážky odberu materiálu určeného na laboratórne použitie, informácie o spôsobe objednania odberového materiálu či podmienkach vykonávania odberu.
Pracujeme efektívnejšie a bezpečnejšie Označovanie vzoriek prešlo nedávno do predanalytickej fázy, čím sa znížilo riziko zámeny vzorky na minimum. Čo je však oveľa dôležitejšie, značenie vzoriek štítkami sme vo väčšine odberov nahradili čiarovými kódmi (tzv. barcode). Lekár nielenže ušetrí na nakupovaní štítkov, keďže čiarové kódy dodávame zadarmo, ale tento spôsob identifikácie ešte viac eliminuje možnosť zámeny vzorky. Pri klasických žiadankách sa využíva dvojitý barcoding (jeden čiarový kód s číslom ide na žiadanku a druhý na skúmavku), zatiaľ čo v prípade elektronických žiadaniek stačí jeden čiarový kód, ktorý je po nalepení na vzorku ihneď po odbere v ambulancii nasnímaný čítačkou čiarových kódov. Prioritné vzorky STATIM sa označujú červeným kódom, bežné vzorky čiernym čiarovým kódom.
Objednanie odberového materiálu
Odberový materiál si môžu lekári objednať prostredníctvom:
1. online formulára na našej webovej stránke,
2. objednávkového listu, ktorý sa pribalí k vzorkám na vyšetrenie.
Vďaka zavedenej centrálnej expedícii je lekárovi objednaný materiál doručený vo veľmi krátkom čase.
Laboratórna diagnostika 45
2
Žiadanka na odberový materiál
ELEKTRONICKÉ ŽIADANKY
Sme prvá a zatiaľ jediná spločnosť na Slovensku, ktorá ambulantným lekárom
ponúka:







– AlphaLAB /unilabs.pro – moderné elektronické laboratórium poskytujúce výsledky aj žiadanky na jednom mieste; viac na www.alphalab.sk/unilabs.pro,

D1650 Antigén Chlamydia –












Chlamydia trachomatis – žena
D2030 Suspenzné médium na urogenitálne mykoplazmy (kultivácia) D1503 Trichomonas vaginalis (kultivácia)
DNA Chlamydia trachomatis (PCR) + DNA urogenitálne mykoplazmy, ureaplazmy, gonokoky (PCR)


07958021190 Cervix Vagína

– možnosť využívať elektronické žiadanky prostredníctvom modulu v ambulantnom systéme. Tieto moderné formy komunikácie umožňujú urýchliť a zefektívniť prácu v ambulancii, čo vedie k výraznému progresu v spolupráci lekárov s naším laboratóriom.

Objednajte si odberový materiál elektronicky www.unilabs.sk/objednanie-odberoveho-materialu

Laboratórna diagnostika 46 ŽIADANKA NA ODBEROVÝ MATERIÁL KIMA BIOCHÉMIA, HEMATOLÓGIA, MIKROBIOLÓGIA, SÉROLÓGIA, BAKTERIOLÓGIA, DÔKAZ DNA MIKROORGANIZMOV, TBC, GENETIKA Meno lekára Adresa ambulancie/zariadenia (ulica č., mesto) Dátum BIOCHÉMIA (sérum, likvor, punktát) Hormóny, onkomarkery, imunológia, sérológia 10178 Skúmavka – gélom 8,0 ml Skúmavka – gélom 3,5 ml Skúmavka – gélom 800 m – ped. HEMATOLÓGIA (K EDTA) KO, renín, HbA1c, HLA-B27, homocysteín, ACTH, CD znaky EDTA 3,0 ml 13501 Skúmavka K EDTA 1,0 ml 813510 Skúmavka K EDTA 500 – ped. KS, Rh faktor, Anti-ery protilátky 135420 Skúmavka K EDTA 6,0 ml 13510 Skúmavka K EDTA 3,0 ml – ped. KOAGULÁCIA (CITRÁT SODNÝ) 14084 Skúmavka 9NC 2,5 ml ŠPECIÁLNA IMUNOLÓGIA (heparinát lítny FA, FI 12005 Skúmavka 2,0 ml INÝ MATERIÁL Glukóza 13808 Skúmavka KF + Na 2 ml venózna glukóza 813805 Skúmavka KF + Na 250 m – kapilárna glukóza Sedimentácia (FW) Skúmavka 4NC 1,6 ml Moč ranný/zbieraný BSP0720 Skúmavka moč ml (žltá) Stolica BSC128p Kontajner lopatkou (červený) –Odberová ihla Ihla žltá 1526502 dospelý Ihla zelená 1526504 dospelý 15213 dieťa 1526506 dospelý 15225 dieťa KLINICKÁ BIOCHÉMIA, HEMATOLÓGIA A INFEKČNÁ SÉROLÓGIA Počet ks Pečiatka lekára (s kódom ambulancie) podpis reg. značka: ŽnOM/02/2021/09 Platná od 15. 2021 Na objednanie môžete použiť formulár na www.unilabs.sk Máte otázky či problém? Volajte Centrálne laboratórium ZÁPAD Bratislave 02/32 25 20 05, 02/32 25 20 13, JUH Nových Zámkoch 035/691 25 04, STRED Ružomberku 044/321 13 23, VÝCHOD Stropkove 054/321 13 22
STERILNÝ TAMPÓN D1601 Plastová tyčinka (modrá) – aktívne uhlie tyčinka (modrá) –D1611 Hliníková tyčinka (sivá) – AMIES (na výtery z oka, ucha, uretry) Hliníkový drôt – (chrípka RSV) MOČ NA KULTIVÁCIU A CITLIVOSŤ – STERILNÁ SKÚMAVKA – (červená) LIKVOR – STERILNÁ SKÚMAVKA BSM422 Likvor – skúmavka 10 ml STERILNÝ KONTAJNER D1211 Spútum – kontajner ml D1084 Odber stolice – kontajner s lopatkou (biely) UROGENITÁLNE PATOGÉNY D1637 Antigén
05170486190/D1211 Moč 05619637190/0030/D1672 HPV – žena 05619637190/D1631/D1672 HPV – muž DNA INÝCH MIKROORGANIZMOV (PCR) D1631 Výter nazofaryngu D1211 Spútum, punktát, moč, bronchoalveolárna laváž D1631 Výter spojivkového vaku 5170516190 Stery kože, (HSV1/2, VZV) HEMOKULTÚRY 410851 Bio Hem Bact/Alert FA Plus – aerobic Bact/Alert Plus – anaerobic Bact/Alert – pediatric 450181 Klobúčik násadec hemokultúru TBC 429927.10 Kontajner – ml D1660 Hliníkový – (Tampón TBC) 622526 Set skúmaviek Quantiferon LAB0220 Glukóza 20 % 7568 Lancety zelené 169018 Klobúčik/násadec ihlu D10001 Sklíčko – perianálny zlep 511534002 Skúmavka sliny 026 Dvojkódy štandardné (1 bal. 1100 ks) 029 Dvojkódy malé (1 bal. 1100 ks) 027 EDI Jednokódy červené STATIM (1 bal. 4400 ks) 028 EDI Jednokódy biele RUTINA (1 bal. 4400 ks) Jednokódy malé (1 bal. ks) Iné odberové súpravy (po dohode medicínskym reprezentantom Unilabs Slovensko, o.) KLINICKÁ MIKROBIOLÓGIA, BAKTERIOLÓGIA, DÔKAZ DNA MIKROORGANIZMOV A TBC ŠPECIÁLNE ODBEROVÉ SÚPRAVY ŽIADANKY (1 bal = 100 ks) ČIAROVÉ KÓDY RUTINNÁ DIAGNOSTIKA A ZRIEDKAVÉ OCHORENIA 13510 Skúmavka EDTA 3,0 ml na periférnu krv LEKÁRSKA GENETIKA Vysvetlivky: ped. pediatrická Na objednanie môžete použiť formulár na www.unilabs.sk Máte otázky či problém? Volajte Centrálne laboratórium ZÁPAD Bratislave 02/32 25 20 05, 02/32 25 20 13, JUH Nových Zámkoch 035/691 25 04, STRED Ružomberku 044/321 13 23, VÝCHOD v Stropkove 054/321 13 22 Preventívne prehliadky, základné vyšetrenia Dôvera hematológia Diabetológia Biochémia – prenatálny skríning Špeciálna hematológia Trombotest Vyšetrenia likvoru Imunológia alergológia alergénov Mikrobiológia – bakteriológia parazitológia Mikrobiológia – diagnostika TBC a mykológia Infekčná sérológia, priamy dôkaz mikroorganizmov Žiadanka COVID 19 Genetika – rutinná diagnostika Genetika – zriedkavé ochorenia – cytogenetika –COVID 19 – ODBEROVÉ SÚPRAVY PIVTM kloktací set bZZ-CN-NMJ-T-E/2 súprava odber hrdla
Uloženie skúmavky s biologickým materiálom do prepravného vrecúška (jedna časť vrecúška je na vzorku a druhá na žiadanku).
Umiestenenie biologického materiálu do skúmavky.
Vypísaná žiadanka.
Po vypísaní a označení žiadanky sa realizuje samotný odber.
ŽIADANKY A ODBER MATERIÁLU 1 4 2 5 3
Označenie žiadanky a skúmavky čiarovým kódom.
VYPÍSANIE
3. Transport
Unilabs Slovensko zabezpečuje
bezplatný zvoz biologického materiálu od svojich klientov (ambulantní lekári, špecialisti, polikliniky, nemocnice)
vlastnou dopravnou službou už od svojho vzniku. Naše zvozové trasy pokrývajú vyše 90 % okresov Slovenska.
Logistika jednotlivých zvozových trás je plánovaná s cieľom doručenia biologického materiálu do laboratórií v čo najkratšom čase. Materiál je podľa typu
vzoriek prevážaný v termoboxoch, chladničkách či mrazničkách tak, aby boli zabezpečené optimálne podmienky pre transport.
V prípade potreby akútneho vyšetrenia mimo plánovaného denného zvozu zabezpečujeme urgentný zvoz po predchádzajúcom telefonickom dohovore lekára s call centrom 0850 150 000, prípadne priamo s vodičom danej zvozovej trasy.
Stredisko dopravy Bratislava
vedúci dopravy: Pavol Dávid
Mobil: 0910 211 721
E-mail: pavol.david@unilabs.com
Stredisko dopravy Nové Zámky
vedúci dopravy: Dušan Zaťko
Mobil: 0911 994 131
E-mail: dusan.zatko@unilabs.com
Stredisko dopravy Bánovce nad Bebravou
vedúci dopravy: Ján Gieci
Mobil: 0910 270 405
E-mail: jan.gieci@unilabs.com













Stredisko dopravy Žiar nad Hronom
vedúci dopravy: Roman Zaťko
Mobil: 0911 403719
E-mail: roman.zatko@unilabs.com

Stredisko dopravy Likavka
vedúci dopravy: Roland Štrofek
Mobil: 0915 545 952
E-mail: roland.strofek@unilabs.com
Stredisko dopravy Stropkov
vedúci dopravy: Gabriel Gondek
Mobil: 0910 888 933
E-mail: gabriel.gondek@unilabs.com




Stredisko dopravy Košice
vedúci dopravy: Marek Čelko
Mobil: 0915 907 567
E-mail: marek.celko@unilabs.com
Spádové oblasti pre jednotlivé strediská dopravy sú farebne zaznačené na mape na nasledujúcich stranách.
Laboratórna diagnostika 47
Kontakty na zodpovedných pracovníkov pre jednotlivé strediská dopravy 3
4. Registrácia a príprava vzorky















Vzorka sa hneď po príchode do laboratória eviduje v laboratórnom informačnom systéme, kde sa podľa priloženej žiadanky od lekára zaznamenávajú všetky požadované vyšetrenia k danej vzorke.

Na presnú evidenciu a nastavenie procesov na vyhodnocovanie využívame tzv. barcoding – značenie čiarovými kódmi (s výnimkou patologických vyšetrení).

Barcoding



Pri klasických žiadankách sa využíva dvojitý barcoding (jeden čiarový kód s číslom ide na žiadanku a druhý na skúmavku), zatiaľ čo v prípade elektronických žiadaniek stačí jeden kód, ktorý sa nalepí na materiál a naskenuje do NIS (nemocničný informačný systém), resp. AIS (ambulantný informačný systém).
JEDNODUCHŠIA ELEKTRONICKÁ REGISTRÁCIA
Naša spoločnosť ponúka možnosť využívať elektronické žiadanky. Táto výhoda umožňuje urýchliť a zefektívniť prácu v nemocniciach aj ambulanciách, čo vedie k výraznému progresu v spolupráci lekárov s laboratóriami. Momentálne je Unilabs Slovensko jediná spoločnosť, ktorá prostredníctvom partnerov dodávajúcich AIS ponúka možnosť využívať výhody elektronickej žiadanky.
Laboratórna diagnostika 50
Bežné vyšetrenia majú čierne čiarové kódy, prioritné vzorky STATIM sa označujú červeným kódom.





Značenie žiadaniek a vzoriek čiarovými kódmi má viacero výhod. Azda najväčšou z nich je zefektívnenie práce, pretože čiarový kód je sám o sebe dostačujúcim identifikačným znakom. A čo z toho vyplýva? Nielenže sa zvýši efektivita práce, ale sa aj eliminuje nebezpečenstvo zámeny vzorky.











Spracovanie a príprava vzorky Po zaevidovaní vzorky a vyšetrení zo žiadanky dochádza k samotnému spracovaniu vzorky. Tá sa pripravuje na testovanie priamo v laboratóriu alebo pre transport do príslušného laboratória v sieti, kde budú realizované špeciálne vyšetrenia. Spracovanie vzorky je realizované prostredníctvom scentrifugovania a vytvorenia alikvóty tak, aby boli dodržané podmienky stability pre stanovované parametre. Každá alikvóta sa takisto značí čiarovým kódom, vďaka čomu je možné presne identifikovať, do ktorého laboratória vzorka smeruje.
Objednajte si odberový materiál elektronicky www.unilabs.sk/objednanie-odberoveho-materialu




Laboratórna diagnostika 51
1. 3.
2.
4
5. Komplexná diagnostika
Logistika našej spoločnosti sleduje jednoznačný cieľ – vyšetriť vzorky v čo najkratšom čase a čo najrýchlejšie poskytnúť lekárovi výsledok.
Naša laboratórna sieť je postavená na:
• troch veľkokapacitných centrálnych laboratóriách, ktoré v sebe integrujú minimálne 2 odbory laboratórnej medicíny,

• troch desiatkach satelitných laboratórií v rámci logistického zabezpečenia spádovej oblasti,
• piatich patologických centrách a ich detašovaných pracoviskách.
Vďaka precízne stanovenému procesu spracovania vzorky, od momentu jej odberu cez transport až po analýzu s vyhodnotením výsledkov, dokážeme realizovať komplexnú laboratórnu diagnostiku.
Komplexná diagnostika
Satelitné laboratóriá poskytujú lekárom urgentné analýzy a predanalytické spracovanie biologického materiálu pred jeho odvozom a analytickým spracovaním v centre, kde sa obyčajne realizujú špeciálne vyšetre-
nia (ale aj rutinné). Ak je teda potrebné špeciálne vyšetrenie, ktoré sa vyšetruje v inom laboratóriu v rámci siete, pripravia sa zo vzorky alikvóty (spomínané vo štvrtej kapitole), ktoré sa následne vložia do prepravných vrecúšok. Na prepravných vrecúškach je nalepený štítok s označením, odkiaľ a kam daná vzorka smeruje a pri akej teplote je potrebný jej prevoz (zmrazené, chladené alebo v termoboxoch). Spracované a rozdelené vzorky sú teda podľa požiadaviek predanalytickej fázy zasielané na vyšetrenie raritnejších parametrov do centrálneho laboratória na ďalšiu analýzu. Vďaka tejto distribúcii a následnej centralizácii sme schopní realizovať takmer všetky vyšetrenia v rutinnom režime, a to aj tie, pri ktorých sa čas dodania výsledkov meral v týždňoch. Lekár tak môže bez ohľadu na lokalitu ordinovať plnú paletu vyšetrení a takmer všetky písomne vyhodnotené výsledky dostávať do 24 hodín.
do hod. 24






















Písomne vyhodnotené výsledky do 24 hodín.







Laboratórna diagnostika 52
Doordinovanie vyšetrení















Ošetrujúci lekár, prípadne ním poverená zdravotná sestra, môže dodatočne telefonicky doordinovať vyšetrenie niektorých parametrov z už odobratej krvi, ktorá bola predtým poslaná do nášho laboratória. Telefonické doordinovanie je možné prostredníctvom call centra na čísle 0850 150 000, resp. vo vybraných prípadoch aj priamo v laboratóriu, pričom identita volajúceho musí byť verifi kovateľná (údaje o kóde poskytovateľa, RČ pacienta, č. telefónu, z ktorého sa hovor uskutočňuje sú obsiahnuté v informačnom systéme našej spoločnosti). Pri doordinovaní vyšetrenia treba zohľadniť stabilitu požadovaného parametra pri skladovaní za daných podmienok, pôvodný dátum odberu vzorky, ako aj dobu skladovania vyšetrených vzoriek v laboratóriu. Záznam o doordinovaní bude uvedený aj na výsledkovom liste v rámci komentáru k žiadanke. Vyšetrenia koagulačných parametrov a vyšetrenia krvného obrazu je možné doordinovať pri dodržaní špecifických podmienok stability vzorky. Vyšetrenia zo séra a zbieraného moču sa môžu dodatočne objednať najneskôr do dvoch pracovných dní (48 hodín) od doručenia vzorky do laboratória. Je to doba, počas ktorej sa vyšetrené vzorky séra a moču skladujú. Takmer všetky vyšetrované parametre stanovované zo séra sú pri chladničkovej teplote 2 – 8 °C stabilné najmenej 2 dni. Každé laboratórium má vypracované pracovné postupy pre možnosť doordinovania jednotlivých parametrov. V prípade nesplnenia týchto podmienok nemôžeme doordinovanie akceptovať, o čom bude ošetrujúci lekár ako objednávateľ vyšetrení telefonicky informovaný.





























Laboratórna diagnostika 53
do hod. do 4 hod. do hod. do hod.
ODBERU VZORKY
VYŠETRENIA NA DOOBJEDNANIE V HODINÁCH OD
↓
koagulačné faktory, proteín C
↓ krvný
↓
fibrinogén APTT, TT, D-dimér, Pro C Global
obraz
VYŠETRENIA
MOČU ↓ MOŽNO DOOBJEDNAŤ DO DVOCH DNÍ (48 HODÍN) OD DORUČENIA VZORKY DO LABORATÓRIA 3 5 6 5
antitrombín III, PT-ratio, INR
ZO SÉRA A ZBIERANÉHO
AKTUALIZOVANÉ

6. Kvalita a akreditácia
V garancii správnosti výsledkov sa môže spoločnosť Unilabs Slovensko oprieť o vykonávanie pravidelnej internej (IQC) a externej kontroly kvality (EQC). Povinnosť vykonávať pravidelné merania IQC a EQC vyplýva z dodržiavania pravidiel správnej laboratórnej praxe a je základným predpokladom pre udelenie osvedčenia o akreditácii pre laboratórium. Interná kontrola kvality slúži na kontinuálnu revíziu správnosti a presnosti merania. V procese externej kontroly kvality preukazuje laboratórium nadväznosť svojich výsledkov merania jednotlivých parametrov na medzinárodné štandardy.
Spoločnosť Unilabs Slovensko má v súčasnosti väčšinu laboratórií akreditovaných Slovenskou národnou akreditačnou službou (SNAS). Všetky laboratóriá našej spoločnosti sú akreditované podľa medzinárodne platnej normy ISO 15189. Akreditované sú aj naše laboratóriá lekárskej genetiky v Bratislave, v Banskej Bystrici a v Košiciach, cytogenetiky v Spišskej Novej Vsi a takisto pracoviská diagnostických centier patológií (DCP) v Bratislave, Košiciach, Banskej Bystrici a v Prešove.
Výhody akreditovaného laboratória
Rozdiel medzi akreditovanými a neakreditovanými laboratóriami, ktoré sú certifi kované podľa požiadaviek na systém manažérstva kvality (QMS) ISO 9001, je najmä v tom, že akreditácia je potvrdenie kompetentnosti laboratórií vykonávať odborné činnosti, ktoré sú akreditované a že v laboratóriu bol zavedený systém manažérstva kvality v súlade s ISO 15189 a certifikácia je potvrdenie, že v laboratóriu bol zavedený QMS podľa ISO 9001, avšak certifikácia nepotvrdzuje odbornú kompetentnosť/spôsobilosť
Všetky procesy v akreditovanom laboratóriu sú podrobne zdokumentované a laboratórium má:
• zavedený kvalitný systém internej a externej kontroly/riadenia kvality,

• prístroje/zariadenia/pomôcky certifikované a validované ich výrobcami, pravidelne verifikované autorizovanými servisnými organizáciami a kde je treba, tak aj kalibrované kompetentnými poskytovateľmi metrologických služieb,
• výlučne certifikované reagencie, kalibrátory a kontrolné materiály,
















• kvalifikovaný a kompetentný personál,
• stanovené politiky a ciele kvality zamerané na neustále zlepšovanie starostlivosti o pacientov a služieb pre lekárov.
Akreditované pracoviská sú pravidelne posudzované počas dohľadov zo strany národného akreditačného orgánu (SNAS). Osvedčenie o akreditácii sa udeľuje na obdobie 5 rokov. Akreditované pracoviská sú zárukou maximálnej spoľahlivosti a presnosti, hoci si to mnohí lekári, ktorí akreditované a neakreditované laboratóriá neodlišujú, neuvedomujú.
Interná kontrola
V rámci systému internej kontroly kvality (IQC) sa v laboratóriách pravidelne monitorujú výsledky kalibrácii, variácia v stanovovaní kontrolných látok a správna funkciu jednotlivých analyzátorov. Denná frekvencia IQC je závislá od objemu vzoriek, ktoré laboratórium počas dňa spracováva.
Pri vyhodnocovaní IQC sa postupuje nasledovne:
• pred spustením rutinnej prevádzky sa vykonáva kontrola kvality na každom analyzátore a pre každú metódu, ktorá bude v daný deň používaná,
• po analýze kontrolných látok skontroluje zodpovedná osoba výsledky kontrolných látok v číselnej, resp. grafickej forme.
Metódy vyhodnocovania
Výsledky meraní IQC sa vyhodnocujú podľa Westgardových pravidiel a Six sigma metriky. Hodnota six sigma je mierou kvality metódy a je kľúčová pre nastavenie kontrolných pravidiel. Hodnoty 6 a viac predstavujú „svetovú“ triedu kvality. Hodnoty pod 3 signalizujú nedostatočnú kvalitu a malo by sa uvažovať o výmene vyšetrovacej metódy. Všeobecne platí, že čím vyššia je six sigma, tým sú jednoduchšie pravidlá pre kontrolu kvality.
Laboratórna diagnostika 54
Externá kontrola kvality
Externá kontrola kvality (EQC) začína doručením špeciálnej testovacej sady vzoriek do laboratória, ktorých analýza sa uskutočňuje v rutinnej prevádzke s ostatnými vzorkami štandardným spôsobom. Namerané výsledky kontrolnej vzorky sa zadajú online na webovej stránke dodávateľa externej kontroly kvality. Vyhodnotenie kontrolného cyklu je zasielané e-mailom na kontaktnú adresu laboratória, a to najneskôr 2 dni po STOP termíne. Výsledky vyhodnoteného EQC skontroluje zodpovedný pracovník za danú prevádzku. V prípade potreby urobí nápravné opatrenia, ktoré vyplynú z vyhodnotenia EQC a všetko zaznamená v ISOhelpe.
Akreditácia











V roku 2019 sme rozbehli nový systém akreditácie laboratórií na úseku operácií. V predošlých rokoch boli akreditované jednotlivé prevádzky samostatne. Akreditačná dokumentácia sa vedie elektronicky, čím prispievame k ochrane životného prostredia.
Začiatkom roku 2020 sme obdržali prvé osvedčenia v novom systéme akreditácie pre laboratórium v Likavke (klinická biochémia a hematológia, klinická mikrobiológia), Banská Bystrica, Spišská Nová Ves a Žiar nad Hronom a pre Centrálne laboratórium
VÝCHOD – laboratóriá Stropkov a Rožňava. V Likavke je špeciálne konfirmačné pracovisko. V Stropkove boli akreditované biochemické, hematologické a sérologické vyšetrenia, ktoré sa robia na novej linke APTIO, a široká paleta novozavedených špeciálnych hemokoagulačných vyšetrení. Na mikrobiológii pribudli k širokej palete akreditovaných kultivačných a sérologických ELISA vyšetrení nové kultivačné a PCR vyšetrenia na TBC. V priebehu roka 2022 sa nám podarilo pod Úsekom operácií (Osvedčenie M-082) zakreditovať 3 centrálne a 3 satelitné laboratóriá.
V roku 2023 pripravujeme akreditáciu cytogenetického laboratória v Bratislave.
NAŠE LABORATÓRIÁ SA AKREDITUJÚ
UŽ OD ROKU 2006






– Prvé akreditované laboratóriá našej spoločnosti boli Laboratórium klinickej biochémie a hematológie a Laboratórium klinickej mikrobiológie v Ružomberku.
– Tieto laboratóriá sa v júni 2006 ako prvé na Slovensku akreditovali podľa medzinárodne platnej normy ISO 15189, ktorá je vytvorená práve pre klinické laboratóriá.
Naše nové laboratórium biochémie, hematológie a patologickej anatómie v nemocnici Bory dodáva od marca 2023 laboratórne služby pre Nemocnicu Bory, a. s., ktorá je najmodrenejšou nemocnicou v strednej Európe. Naše laboratóriá zaberajú plochu viac ako 500 m2. Máme ambíciu vyšetriť až 200 000 vzoriek ročne. Staneme sa tak dominantným poskytovateľom laboratórnych služieb v rámci Bratislavy.

Laboratórna diagnostika 55
6
Nové laboratórium vBratislave
7. Analýza








Deväťdesiat percent zariadení v laboratóriách Unilabs Slovensko tvorí technika SIEMENS, ktorú dopĺňajú značky Roche, Beckman coulter, Sysmex, BIOMERIEUX, Brucker, Becton Dikinson a iné. Zabezpečujeme komplexnú modernú laboratórnu diagnostiku s vysokou kvalitou a širokou dostupnosťou. Naše služby poskytujeme prostredníctvom siete viac než 40 laboratórií na území celého Slovenska.
ADVIA 1800
Biochemický systém ADVIA® 1800 je automatický analyzátor pre klinickú biochémiu, ktorý analyzuje vzorky ľudského séra, plazmy alebo moču s kapacitou 1 200 fotometrických a 600 ISE testov za hodinu. Dokáže stanoviť mnohé parametre od glukózy cez enzýmy, lipidy, špecifické proteíny, stopové prvky ako Fe, Mg, Li až po terapeutické hladiny liekov.
ADVIA Centaur XP
Je automatizovaný imunoanalytický analyzátor ponúkajúci optimálnu produktívnu účinnosť. Skupiny testov zahŕňajú diagnostiku z oblasti fertility, ochorení štítnej žľazy, onkológie, kardiovaskulárnych ochorení, monitorovania liekových hladín, infekčných chorôb , alergií , f unkcie nadobličiek a kostného metabolizmu.

Immulite 2000XPi
Vysokocitlivý plnoautomatický imunochemický analyzátor, ktorý pracuje na princípe chemiluminiscencie. Je určený na stanovenie hormónov, kardiomarkerov, onkomarkerov, rastových hormónov, diabetu, markerov anémie, sérologických parametrov infekcií, hladiny liekov a markerov zápalu. Je kľúčovým v diagnostike alergií – analyzuje obrovské spektrum špecifických IgE alergénov (vyše 400).
ADVIA 2120
Hematologický systém ADVIA 2120 je plne automatický diagnostický prístroj s kapacitou 120 vzoriek za hodinu (CBC/diff). Analyzátor používa vzorky plnej krvi a poskytuje nasledovné druhy výsledkov:
• kompletný krvný obraz (CBC),
• CBC plus rozdielové počty bielych krviniek (CBC/diff),
• absolútne, percentuálny a indexové počty retic,
• CBC/diff plus retic (CBC/diff/retic),










• CBC/retic.
Sysmex® CA-1500
Plne automatizovaný koagulačný analyzátor pre in vitro diagnostiku umožňuje rýchlo a s veľkou presnosťou spracovať veľký objem vzoriek. Je založený na koagulačnej, chromogennéj a imunologickej metóde.
Laboratórna diagnostika 56
CentraLink™















Laboratórna diagnostika 57
Advia 1800 VersaCell®
Advia Centaur XP 7
Immulite 2000XPi
CentraLink™
Systém správy údajov poskytuje výkonnú platformu pre centrálne riadenie laboratórnych dát a nástrojov , pričom automatizuje manuálne procesy a workflow.
VersaCell®
Je to kompaktný robotický systém, ktorý spája až 2 samostatné nástroje flexibilnej konfigurácie.
ROCHE Cobas e411
Plne automaticky analyzátor určený na imunochemickú analýzu založenú na ECL. Využitie má najmä v diagnostike napríklad kostných markerov.
BN II ProSpec
Umožňuje plne automatizované stanovenie plazmatických proteínov nefelometrickou analýzou séra, plazmy, moču a likvoru.
Sysmex UF-1000i a Sysmex UF-4000i Prietokové cytometre na bakteriologický skríning. Dnes sú už štandardnou výbavou všetkých našich laboratórií. Umožňujú efektívne využitie kultivačných vyšetrení a výrazne zrýchľujú čas diagnostiky.
Sysmex U-WAM
Plne automatizovaná linka na analýzu moču. Zahŕňa prietokovú cytometriu, mikroskopiu a chemické stanovenie moču na stripoch.
Mindray BC 6200 a 6000
Analyzátor MINDRAY BC 6000 a BC 6200 je určený na in vitro vyšetrovanie krvného obrazu (KO) s 5-parametrovým diferenciálnym rozpočtom leukocytov (neutrofily, lymfocyty, eozinofily monocyty, bazofily). Princípy, ktoré používa analyzátor pre merania, sú nasledujúce: impedančná metóda s tieneným prietokom, laserový rozptyl a patentovaná technológia SF Cube (3D analýza využívajúca informácie z rozptylu laserového svetla v dvoch uhloch a z fluorescenčných signálov pre rozlíšenie a počítanie buniek).
Beckman Coulter NAVIOS
Prietokový cytometer na imunofenotypizáciu lymfocytov. Výsledky sú k dispozícii do 24 hodín.
TECAN EVO Clinical 200
Pipetor na riedenie a následne rozpipetovanie vzoriek do mikrotitračných testovacích platničiek, ktoré sú ďalej spracované pomocou analyzátora BEP III metodikou ELISA.
BEP III
Dokáže stanoviť vírusové hepatitídy, syfilis, herpetické vírusy, respiračne vírusy, borélie, chlamýdie a mykoplazmy.















MALDI TOF



Analyzátory umožňujúce rýchlu a presnú druhovú identifikáciu mikroorganizmov pomocou hmotnostnej spektrofotometrie.
VITEK 2 BIOMERIEUX
Plnoautomatické analyzátory na stanovenie kvantitatívnej citlivosti, ktoré okrem stanovenia citlivosti detegujú aj mechanizmy rezistencie testovaného bakteriálneho kmeňa. Výsledky testov citlivosti sú interpretované a každoročne aktualizované podľa medzinárodnej antibiotickej smernice EUCAST. Vďaka VITEK-u sú výsledky našich vyšetrení rýchlejšie, presnejšie a kvalitnejšie.
BACT/ALERT® 3D
Umožňuje automatizované kultivačné vyšetrenie hemokultúr so signalizáciou pozitívnej hemokultúry.
Tissue-Tek Xpressx120
Plnoutomatický tkanivový procesor, ktorý umožňuje spracovať bioptické vzorky v „zrýchlenom“ procese (do 1,5 hodiny oproti štandardným 15 hodinám) pomocou kombinácie mikrovlnovej technológie a presycovacích reagencií.
Tissue-Tek AutoTEC
Plnoautomatický zalievací prístroj umožňujúci zaliať spracovanú vzorku do paraformu bez manuálneho zásahu – čiže oproti štandardnému postupu s orientáciou vzorky pri zalievaní, prípadne stratou materiálu počas tohto procesu.
Laboratórna diagnostika 58
Aptio® Automation







– Umožňuje zlepšiť využitie laboratórnych zdrojov, zvýšiť efektivitu, urýchliť spracovanie vzoriek.
– Ponúka rozsiahle diagnostické portfólio: biochemickú analýzu, imunoanalýzu, hematologickú analýzu, analýzu hemostázy a testovanie plazmatických proteínov.

– Poskytuje maximálnu automatizáciu v pred-, posta analytickej fáze.
Aptio Automation – automatizácia v predanalytickej fáze
• Input/Output Modul



Rutinný a statimový riadiaci vstup a výstup skúmaviek. Kapacita 780 skúmaviek, 15 stojanov, 48 polôh.
• Bulk Input Modul Vysokorýchlostný nakladač skúmaviek. Kapacita 1 000 skúmaviek za hodinu.
• Centrifúga Modul
Kapacita 80 skúmaviek. Priechodnosť až 300 skúmaviek za hodinu s 10-minútovým odstreďovaním.
• Decapper Modul
Kapacita 2 000 odpadových vrchnákov. Priechodnosť 800 skúmaviek za hodinu.
Aptio Automation – automatizácia v postanalytickej fáze
• Aliquotter Modul



Kapacita: z 1 primárnej skúmavky dokáže odpipetovať 4 alikvotačné skúmavky. Priechodnosť 400 skúmaviek za hodinu.
• Tube Sealer Modul


Modul uzatvárania skúmaviek. Priechodnosť 800 skúmaviek za hodinu.
• Tube DeSealer Modul
Modul otvárania skúmaviek. Priechodnosť 200 skúmaviek za hodinu.
• Storage/Chladiaci









skladovací modul
Automatické skladovanie, vyhľadávanie a likvidácia
skúmaviek. Kapacita 15 360 skúmaviek. Priechodnosť 800 skúmaviek za hodinu.
Laboratórna diagnostika 59 7
Aptio Analýza











Atellica® Sample Handler
Komponent na spracovanie vzoriek pre vstup/výstup rutinných, statimových vzoriek, kalibrátorov a kontrol (QC). Pomocou komponentu spája Atellica Magline biochemický (CH) a imunoanalytický (IM) analyzátor. Kapacita až 500 skúmaviek za hodinu.
Analyzátor Atellica IM 1600
Imunologický analyzátor s metódou testovania chemiluminiscencie s využitím pokročilého akridínu esterovej technológie.
• Prevádzkuje až 440 testov za hodinu.
• Kapacita palubného systému: 42 primárnych stanovení (35 pomocných reagencií).
Typ vzoriek: sérum, plazma, plodová voda, moč, celá krv (špecifi cké pre test). Automatická kontrola hladiny vzoriek, detekcia zrazeniny, detekcia bublín, hemolýza, ikterus, kontrola lipémie (HIL). Automatické opakovanie vzorky a automatické riedenie, závislé od testu. Doba testu 10 až 54 minút.
Analyzátor Atellica® CH 930
Biochemický systém, ktorý prevádzkuje až 1 800 testov za hodinu.
• Fotometrické: 1 200 testov za hodinu.


• Integrovaná multisenzorová technológia (IMT): 600 testov za hodinu.
• Kapacita palubného systému: 70 testov. Typ vzoriek: sérum, plazma, CSF, moč. Automatická kontrola hladiny vzoriek, detekcia zrazeniny, detekcia bublín, hemolýza, ikterus a kontrola lipémie (HIL). Automatické opakovanie vzorky, automatické riedenie vzorky 1 : 5. Požadovaný objem vzorky: 0,4 µl až 5,0 µl (mení sa podľa analýzy). Doba testu 3 až 10 minút. Metóda: potenciometrická, fotometrická, turbidimetrická.
Analyzátor Sysmex CS-5100




Široké optické spektrum spracováva širokú
škálu testov.
• Vysoká výkonnosť až 400 testov PT/APTT za hodinu.
• Kapacita palubného systému: až 3 000 testov a až 40 reagencií.
• Metóda: chromogénna, imunoanalýza a agregácia.





Laboratórna diagnostika 60
Sekvenovanie novej generácie
NextSeqTM 550
• sekvenovanie 30 – 120 Gb/run
• 400 miliónov čítaní
• celkový čas sekvenovania 12 – 30 h
• sevenovanie 300 bp v 1 čítaní
• veľké panelové analýzy, analýza klinického exómu, exómu
Genetický analyzátor (sekvenátor)
Umožňuje získať informácie o poradí nukleotidov (báz) v molekule DNA (stanovenie primárnej štruktúry DNA).
Inými slovami, pomocou sekvenátora je možné „prečítať“ gén a nájsť v ňom mutáciu zodpovednú za genetické ochorenie, prípadne predispozíciu k ochoreniu.
Real-Time PCR cykler (LightCycler 480)


Meraním fluorescencie pri určitých vlnových dĺžkach umožňuje stanoviť genotyp pacienta (detegovať prítomnosť mutácie), napríklad v súvislosti s trombofilnými stavmi, hemochromatózou a s mnohými ďalšími.
IdyllaTM
iSeq™ 100
• sekvenovanie 1,2 Gb/run
• 4 milióny čítaní
• celkový čas sekvenovania 9 – 17 h
• maximálna dĺžka čítania 300 bp
• malé panelové analýzy, analýza veľkých génov




IdyllaTM, Biocartis je plne automatický real-time PCR molekulárny diagnostický systém navrhnutý pre rýchle získanie klinických molekulárnych informácií. IdyllaTM zahŕňa kompletný proces od vloženia vzorky až po zobrazenie výsledku (od 35 do 150 minút). IdyllaTM je použiteľná pre široké spektrum klinických typov vzoriek: FFPE (formalínom fixované, v parafíne zaliate) tkanivové rezy, krv, moč, stolica, spútum alebo tkanivo. Plne integrovaný systém umožňuje klinickému laboratóriu uskutočňovať široké spektrum onkologických, infekčných a ďalších vyšetrení. Ďalšie výhody systému: mimoriadne jednoduché použitie, vysoká špecificita a senzitivita a krátky čas na prípravu vzorky (menej ako 2 minúty).
Využívame testy:












• IdyllaTM NRAS/BRAF Test


• IdyllaTM KRAS Test
• IdyllaTM EGFR Test
• IdyllaTM MSI Test
• IdyllaTM ctNRAS/BRAF Test
• IdyllaTM ctKRAS Test
• IdyllaTM ctEGFR Test
• najnovšie aj IdyllaTM GeneFusion Test
Laboratórna diagnostika 61 7
8. Validácia a distribúcia výsledkov
Každý výsledok pacienta pred odoslaním z laboratória podlieha dvojstupňovej kontrole – technickej aj klinickej. Naše procesy sú nastavené tak, aby sme v maximálne možnej miere eliminovali pravdepodobnosť pochybenia na strane automatického spracovania alebo ľudského faktora.
Distribúcia výsledkov












Výsledky sa štandardne zasielajú v tlačenej podobe (aby mohli byť evidované v karte pacienta), čo okrem iného vyplýva aj zo zákona. Popri tejto základnej forme ponúkame možnosť dostávania výsledkov aj elektronicky, prípadne telefonicky.
Rozlišujeme dva výsledkové listy:







1. priebežný výsledkový list












– vzťahuje sa na rutinné denné vyšetrenia
– na konci výsledkového listu sa uvádzajú neukončené vyšetrenia s popisom „vyšetríme“ + text (konkrétne parametre)
2. konečný výsledkový list


– vzťahuje sa na dovyšetrované parametre (označené znakom „««“)
– konečný výsledkový list sa považuje za skompletizovaný prehľad zahŕňajúci všetky vyšetrenia, ktoré boli ordinované v deň prijatia žiadanky do laboratória
Zasielanie písomných výsledkov Čo sa týka štandardných písomných výsledkov, tie sa okamžite po schválení oprávnenou osobou, ktorej skratkové meno je uvedené na výsledkovom liste, vytlačia a vyexpedujú ošetrujúcemu lekárovi, resp. sú k dispozícii v elektronickom režime. V každom laboratóriu sú určené kompetencie jednotlivých pracovníkov, čím je zabezpečená jednoznačná zodpovednosť za technické, respektíve klinické, uvoľnenie výsledkov vyšetrení.
Zasielanie výsledkov elektronicky
Laboratóriá Unilabs Slovensko zároveň poskytujú možnosť bezplatného prístupu k elektronickým výsledkom prostredníctvom internetu s využitím kryptovanej komunikácie bežného internetového prehliadača. Klient tak po zadaní svojich prihlasovacích údajov (meno, heslo) získava možnosť prístupu k výsledkom laboratórnych vyšetrení z ktoréhokoľvek počítača pripojeného na internet, a to v identickom vizuálnom formáte voči papierovému výsledku. Elektronický výsledok je umiestený v dispozičnej sfére klienta bezprostredne po jeho klinickej validácii v laboratóriu. Ak lekár disponuje ambulantným IS, je možné laboratórne výsledky automaticky prepojiť s kartou pacienta, čím je zabezpečený komplexný prehľad o zdravotnom stave pacienta.
Telefonické hlásenie výsledku
O výsledkoch vyšetrení sa možno informovať prostredníctvom call centra 0850 150 000. Môže tak urobiť iba príslušný ošetrujúci lekár alebo ním poverená zdravotná sestra. Vyšetrenia krvných skupín, Rh protilátok, antierytrocytových protilátok a výsledky z patológie nie je možné telefonicky poskytnúť. Každá telefonická informácia o výsledkoch vyšetrení je v laboratóriu zaznamenaná v LIS. Výsledky vyšetrení, ktoré sú označené ako STATIM (urgentné vyšetrenia), sa hlásia ošetrujúcemu lekárovi čo najrýchlejšie po obdržaní výsledku a jeho klinickej kontrole, a to na číslo oddelenia alebo ambulancie priamo ošetrujúcemu lekárovi alebo zdravotnej sestre. Pri hlásení je nevyhnutná presná identifikácia pacienta a odberu.
Laboratórna diagnostika 62
Výsledkový list
Meno a priezvisko pacienta
Rodné číslo pacienta
Meno a priezvisko ordinujúceho lekára
Dátum narodenia pacienta
Dátum a čas príjmu materiálu
Dátum a čas odberu materiálu Komentár klinická informácia k prijatej vzorke
Konečný výsledkový list k žiadanke číslo RK/39385106
Unilabs Slovensko, s. r. o., Záborského 2, 036 01 Martin


OR OS Žilina, oddiel: Sro vložka č.63112/L
Klinická informácia k pacientovi
Realizačné laboratórium kontaktné údaje
Pacient: Ordinujúci lekár:
TEST TEST Lekár NEUVEDENÝ
Rod.číslo: Nar.: Zariadenie a adresa:
Dátum a čas odberu:
Adresa ordinujúceho lekára Kód lekára Kód diagnózy Kód poisťovne
Poisťovňa: Diagnózy:











111111/111 11. 11. 1911 Alpha medical, s.r.o. Laboratórium ZH Sládkovičova 11 965 01, ŽIAR NAD HRONOM
18. 01. 202108:30 D500
Príjem: Komentár k prijatému materiálu: Kód lekára / PZS :
18. 01. 2021 15:58






XX X12345678 / X00020ZH1101

Centrálne laboratórium STRED LIKAVKA,
Akreditované prevádzky podľa ISO 15 189:2012
Laboratórium klinickej biochémie a hematológie
J. Bellu 66, 034 95 LIKAVKA
hviezdička sú neakreditované * Vyšetrenia označené symbolom
ZáverVýsledokJednotkyRef.rozsah Schválil EDTA krv ZáverVýsledokJednotkyRef.rozsah Schválil
Výsledok vyšetrenia druh klinického materálu, záver (+ nad ref. rozsahom, - pod ref. rozsahom, OK v ref. rozsahu), výsledok (číselné vyjadrenie), jednotky, ref. rozsah, schválil (skratkové meno)
Laboratórna diagnostika 63 8
EDTA krv Leukocyty [WBC] + 10^9/l BST 18.01.21 16:03 12.00 3.80-10.70 Erytrocyty [RBC] OK 10^12/l BST 18.01.21 16:03 5.00 4.40-5.80 Hemoglobín [HGB] OK g/l BST 18.01.21 16:03 150.00 135.00-175.00 Hematokrit [HCT] OK pomer BST 18.01.21 16:03 0.50 0.38-0.52 * Stred.obj.RBC [MCV] OK fL BST 18.01.21 16:03 95.00 82.00-98.00 * Stred.hmot.HGB v RBC [MCH] OK pg BST 18.01.21 16:03 30.00 27.00-33.00 * Stred.farebná konc. HGB v RBC [MCHC] OK g/l BST 18.01.21 16:03 320.0 320.0-370.0 * Šírka distr. RBC [RDW] OK % BST 18.01.21 16:03 12.00 11.60-15.10 Trombocyty [PLT] OK 10^9/l BST 18.01.21 16:03 350.0 140.0-420.0 * Stredný objem PLT [MPV] + fL BST 18.01.21 16:03 12.00 7.10-11.50 * Šírka distr. PLT [PDW] OK fl BST 18.01.21 16:03 12.00 9.0-17.0 * Neutrofily [NE] OK70.00%35.0-74.0 BST 18.01.21 16:03 * Lymfocyty [LY] OK30.00%15.5-50.0 BST 18.01.21 16:03 * Eozinofily [EO] OK1.00%0.00-5.00 BST 18.01.21 16:03 * Monocyty [MO] OK2.00%2.0-11.0 BST 18.01.21 16:03 * Bazofily [BA] OK1.00%0.00-1.50 BST 18.01.21 16:03 * Neutrofily abs.počet OK1.8010^9/l1.70-6.90 BST 18.01.21 16:03 * Lymfocyty abs.počet OK2.010^9/l1.00-3.60 BST 18.01.21 16:03 * Eozinofily abs.počet OK0.310^9/l0.0-0.43 BST 18.01.21 16:03 * Monocyty abs.počet OK0.110^9/l0.10-0.80 BST 18.01.21 16:03 * Bazofily abs.počet OK0.1010^9/l0.00-0.10 BST 18.01.21 16:03 ZáverVýsledokJednotkyRef.rozsah Schválil Plazma ZáverVýsledokJednotkyRef.rozsah Schválil Plazma P- INR (liečení pacienti) BST 18.01.21 16:03 1.02 Terapeutickú hladinu pri liečbe kumarínmi určuje ošetrujúci lekár. Odporúčaná hodnota: 2,0 - 3,5 ZáverVýsledokJednotkyRef.rozsah Schválil Sérum ZáverVýsledokJednotkyRef.rozsah Schválil Sérum S-Glukóza OK mmol/l BST 18.01.21 16:03 4.60 3.30-5.59 S-Močovina + mmol/l BST 18.01.21 16:03 25.20 2.5-10.9 S-Kreatinín OK70.00µmol/l52.00-110.00 BST 18.01.21 16:03 S-Kyselina močová + 580.00µmol/l150.0-420.0 BST 18.01.21 16:03 ZáverVýsledokJednotkyRef.rozsah Schválil Sérum ZáverVýsledokJednotkyRef.rozsah Schválil Sérum S-Sodík OK mmol/l BST 18.01.21 16:03 142.00 132.00-146.00 S-Draslík OK mmol/l BST 18.01.21 16:03 5.40 3.70-5.40 S-Chloridy OK110.00mmol/l97.00-111.00 BST 18.01.21 16:03 Strana č. RK/39385106 1 z 2 0850 150 000 www.unilabs.sk, call centrum: 2021-1-20 Ver 3.117 11093C03.uds
Unilabs Slovensko, s. r. o.
9. Kontakty
+421 2 32 11 22 22
Digital park II, Einsteinova 23 www.unilabs.sk
unilabs@unilabs.com
Call Centrum
0850 150 000
• za cenu miestneho hovoru
• v pracovných dňoch od 7.00 — 16.30



















Sídlo spoločnosti
Záborského 2
036 01 Martin
Slovenská republika
IČO: 31647758
DIČ: 2020577603
IČ DPH: SK2020577603
Riaditeľstvo
Digital park II, Einsteinova 23
851 01 Bratislava
tel: +421 2 32 11 22 22
Administratíva
Záborského 2
036 01 Martin
tel: +421 43 422 00 41
Adresa na fakturáciu
Unilabs Slovensko, s. r. o. Záborského 2
036 01 Martin
















Slovenská republika
IČO: 31647758
DIČ: 2020577603
IČ DPH: SK2020577603
Bankové spojenie: UniCredit Bank
č. účtu: 6602253029/1111
IBAN: SK59
1111 0000 0066 0225 3029
Spoločnosť zapísaná v Obchodnom registri Okresného súdu Žilina, oddiel: Sro, vložka č. 63112/L.
Medicínski reprezentanti Obchodný manažér
RNDr. Alexandra Malaníková
Veľkí klienti: nemocnice – vedenie
Digital park II
Einsteinova 23, 851 01 Bratislava
0903 160 894 I alexandra.malanikova@unilabs.com
Špecialista predaja a
Mgr. Lukáš Lednický
Digital park II
Einsteinova 23, 851 01 Bratislava
0902 529 992 I lukas.lednicky@unilabs.com
Klientské centrum
(lab.online, B2C klienti)









Ing. Monika Kalčíková
Manažérka klientského centra
Šancová 110, 831 04 Bratislava
0910 972 176 I monika.kalcikova@unilabs.com
Podpora predaja
Mgr. Monika Vernarská
Covid-19 (PCR, Atg, Protilátky) – firmy

BabyLab (Trec/Krec, SMA) – celá SR
Záborského 2, 036 01 Martin 0910 138 972 I monika.vernarska@unilabs.com
1 Diana Kemp
Digital park II, Einsteinova 23, 851 01 Bratislava 0910 139 477
2 Mgr. Mária Chotváčová
Nová nemocnica 511, 958 01 Partizánske 0911 066 515
3 Mgr. Mária Majtánová
J. Bellu 66, 034 95 Likavka 0902 829 481
4 Mgr. Annamária Mališová
Horná 67, 974 01 Banská Bystrica 0910 994 229
5 Ing. Jana Mišíková
J. Bellu 66, 034 95 Likavka 0911 102 740
6 Mgr. Liana Hríbová
Jánskeho 1, 952 01 Spišská Nová Ves 0904 604 193
7 Mgr. Iveta Varadzinová
Gorkého 2, 040 01 Košice 0911 820 568
Laboratórna diagnostika 64
analytik kontroly
2 6 3 5 1 7 4
Manažment



























Alpha medical – a teraz Unilabs Slovensko – plní svoj počiatočný sľub poskytovať kvalitnú a dostupnú laboratórnu diagnostiku už 25 rokov. Každým rokom nášho pôsobenia prinášame nové atribúty, ktoré sú s týmto záväzkom spojené – ďalšie odbory diagnostiky, rozšírenie laboratórnej siete, nové moderné metódy testovania, rýchlejšie výsledky, vzájomnú kompatibilitu a porovnateľnosť v rámci siete, komfortnejší servis. Sme silným a spoľahlivým partnerom, s ktorým môžete počítať – kdekoľvek na Slovensku a kedykoľvek, keď to váš pacient práve potrebuje. Spoločne sa staráme, aby ľudia v našej krajine mali svoje zdravie pod kontrolou. To je to, čo nás motivuje byť každým dňom o kúsok lepší v tom, čo robíme.







Laboratórna diagnostika 65 9
Mgr. Stanislav Čársky Generálny riaditeľ (CEO) stanislav.carsky@unilabs.com
Ing. Jozef Karlík Finančný riaditeľ (CFO) jozef.karlik@unilabs.com
RNDr. Ľubomír Gallik Obchodný riaditeľ (CSO) lubomir.gallik@unilabs.com
Ing. Katarína Rumanová Výkonný riaditeľ pre patológie a genetiky katarina.rumanova@unilabs.com
RNDr. Jozef Marčišin, MSc. Prevádzkový riaditeľ (COO) jozef.marcisin@unilabs.com
Ing. Gabriel Gajdoš IT riaditeľ (CIO) gabriel.gajdos@unilabs.com
Mgr. Lívia Franková Marketingový riaditeľ (CMO) livia.frankova@unilabs.com
Dominika Petrová Riaditeľ projektovej kancelárie (CPO) dominika.petrova@unilabs.com
Ing. Lucia Sýkorová Riaditeľ nákupu (CPO) lucia.sykorova@unilabs.com
Ing. Peter Kelčík Riaditeľ ľudských zdrojov (HR Director) peter.kelcik@unilabs.com
RNDr. Viera Zboňáková, MSc. Manažér pre dane a účtovníctvo viera.zbonakova@unilabs.com





Tibor Majer Senior koordinátor logistiky tibor.majer@unilabs.com


Ing. Ivan Zaťko Manažér logistiky ivan.zatko@unilabs.com


















Ing. Róbert Lamoš Projektový manažér TaHO robert.lamos@unilabs.com

RNDr. Alexandra Malaníková Obchodný manažér alexandra.malanikova@unilabs.com
Ing. Kristína Langerová Manažér pre styk so zdravotnými poisťovňami kristina.langerova@unilabs.com
MUDr. Ivana Revayová, MPH, MBA Manažér prevádzky ambulancií ivana.revayova@unilabs.com
Manažment rutinných laboratórií
Mgr. Katarína Dudová, MPH Manažér Centrálneho laboratória – ZÁPAD katarina.dudova@unilabs.com
Mgr. Stanislava Vargová Manažér Centrálneho laboratória – VÝCHOD stanislava.vargova@unilabs.com
Mgr. Bibiana Straková, MPH Manažér kvality (rutinné laboratóriá) bibiana.strakova@unilabs.com


Laboratórna diagnostika 66
MUDr. Ľubomír Straka



Manažér DCP Prešov a odborný zástupca lubomir.straka@unilabs.com
MUDr. Iveta Mečiarová, PhD.




Manažér DCP Bratislava a odborný zástupca iveta.meciarova@unilabs.com
MUDr. Jozef Bodnár
Manažér DCP Košice a odborný zástupca jozef.bodnar@unilabs.com
RNDr. Jana Verebová, PhD.



Manažér Laboratória lekárskej genetiky Košice jana.verebova@unilabs.com
MUDr. Viliam Gábriš






Manažér DCP Banská Bystrica a odborný zástupca viliam.gabris@unilabs.com
MUDr. Miroslav Žatko
Manažér DCP Topoľčany a odborný zástupca miroslav.zatko@unilabs.com
RNDr. Renáta Zemjarová Mezenská
Manažér Laboratória lekárskej genetiky Bratislava – Polianky renata.zemjarova@unilabs.com
MVDr. Eva Drusová
Manažér Laboratória lekárskej genetiky Spišská Nová Ves eva.drusova@unilabs.com











Mgr. Lenka Tomášiková
Manažér Laboratória lekárskej genetiky Banská Bystrica lenka.tomasikova@unilabs.com
RNDr. Jaroslava Veljačiková
Manažér Laboratória lekárskej genetiky Bratislava – Šancová jaroslava.veljacikova@unilabs.com
Mgr. Zuzana Kmentová
Centrálny manažér kvality pre patológie a genetiky zuzana.kmentova@unilabs.com
Laboratórna diagnostika 67 9
Manažment špecializovaných laboratórií patológie a genetiky
Sieť laboratórií a pracovísk

Centrálne laboratórium − ZÁPAD
Laboratórium klinickej biochémie a hematológie
Laboratórium klinickej mikrobiológie
Laboratórium klinickej imunológie a alergológie
Polianky 7, 841 01 Bratislava
Laboratórium lekárskej genetiky
Patologická anatómia − DCP Bratislava
Unilabs Slovensko, s. r. o.
Polianky 7, 841 01 Bratislava
Laboratórium klinickej biochémie a hematológie Bory
Unilabs Slovensko, s. r. o.
Ivana Kadlečíka 2, 841 06 Bratislava
Laboratórium klinickej biochémie a hematológie
Unilabs Slovensko, s. r. o.
Tematínska 3778/5A, 851 01 Bratislava
Laboratórium klinickej biochémie a hematológie
Unilabs Slovensko, s. r. o.
Hviezdoslavova 23/3, 957 01 Bánovce nad Bebravou
Laboratórium klinickej biochémie a hematológie
Unilabs Slovensko, s. r. o.
Nová nemocnica 511, 958 01 Partizánske
Laboratórium klinickej biochémie a hematológie
Unilabs Slovensko, s. r. o.
Veľkoblahovská č. 23, 929 01 Dunajská Streda
Laboratórium klinickej biochémie a hematológie
Unilabs Slovensko, s. r. o.
Hodská 373/38, 924 22 Galanta
Laboratórium klinickej biochémie a hematológie
Unilabs Slovensko, s. r. o.
Pavlovova 17, 955 20 Topoľčany
Laboratórium klinickej biochémie
Unilabs Slovensko, s. r. o.
Piešťanská 1184/24, 915 01 Nové Mesto n. Váhom

centrálne laboratórium
patologická anatómia – DCP
laboratórium v rámci nemocnice
Centrálne veterinárne laboratórium laboratórium patológia
laboratórium lekárskej genetiky ambulancie
územie pokryté pravidelnými zvozovými trasami centrá hemostázy a trombózy
Pracovisko jednodňovej zdravotnej starostlivosti v odbore gynekológia a pôrodníctvo
Laboratórium klinickej biochémie
Unilabs Slovensko, s. r. o.
Ivana Krasku 2464/38, 926 01 Sereď










Laboratórium klinickej biochémie
Unilabs Slovensko, s. r. o.
Slovenská 11, 940 02 Nové Zámky

Laboratórium klinickej biochémie
Unilabs Slovensko, s. r. o.
Fatranská 12, 949 01 Nitra
Laboratórium klinickej biochémie
Unilabs Slovensko, s. r. o.
Senný trh 6, 945 01 Komárno
Laboratórium klinickej biochémie
Unilabs Slovensko, s. r. o.
Komenského 36, 937 01 Želiezovce





Patologická anatómia
Laboratórium patologickej anatómie
Unilabs Slovensko, s. r. o.
Antolská 11, 851 07 Bratislava
Patologická anatómia
Unilabs Slovensko, s. r. o.
Ružinovská 6, 826 06 Bratislava, areál FNsP
Patologická anatómia
Unilabs Slovensko, s. r. o.
Pavlovova 17, 955 20 Topoľčany
Laboratórium lekárskej genetiky
Unilabs Slovensko, s. r. o.
Šancová 110, 831 04 Bratislava
Laboratórna diagnostika 68
Topoľčany
Pracovisko jednodňovej zdravotnej starostlivosti v odbore
gynekológia a pôrodníctvo
Unilabs Slovensko, s. r. o.
Šancová 110, 831 04 Bratislava
Laboratórium klinickej biochémie a hematológie
Laboratórium klinickej mikrobiológie
J. Bellu 66, 034 95 Likavka
Centrálne veterinárne laboratórium
Unilabs Slovensko, s. r. o.
J. Bellu 66, 034 95 Likavka








Laboratórium klinickej biochémie a hematológie
Unilabs Slovensko, s. r. o.
Janského 1, 052 01 Spišská Nová Ves
Laboratórium klinickej biochémie a hematológie
Unilabs Slovensko, s. r. o.
Sládkovičova 11, 965 01 Žiar nad Hronom
Laboratórium klinickej biochémie
Unilabs Slovensko, s. r. o.
Bratská 17, 969 01 Banská Štiavnica
Laboratórium klinickej biochémie
Laboratórium klinickej imunológie a alergológie
Unilabs Slovensko, s. r. o.
Horná 67, 974 01 Banská Bystrica
Laboratórium klinickej biochémie
Unilabs Slovensko, s. r. o.
Československej armády 3, 036 01 Martin
Laboratórium klinickej biochémie
Unilabs Slovensko, s. r. o.
Školská 153/2, 034 91 Ľubochňa
Patologická anatómia – DCP Banská Bystrica
Unilabs Slovensko, s. r. o.
Námestie L. Svobodu 1, 974 01 Banská Bystrica
Laboratórium lekárskej genetiky
Unilabs Slovensko, s. r. o.
Námestie L. Svobodu 1, 974 01 Banská Bystrica
Laboratórium lekárskej genetiky
Unilabs Slovensko, s. r. o.
Janského 1, 052 01 Spišská Nová Ves
Centrálne laboratórium − VÝCHOD
Laboratórium klinickej biochémie a hematológie
Laboratórium klinickej imunológie a alergológie
Laboratórium klinickej mikrobiológie
Unilabs Slovensko, s. r. o.
Hviezdoslavova 37/46, 091 01 Stropkov
Laboratórium klinickej biochémie a hematológie
Unilabs Slovensko, s. r. o.
MUDr. Pribulu 412/4, 089 01 Svidník
Laboratórium klinickej biochémie
Unilabs Slovensko, s. r. o.
Masarykova 9, 040 01 Košice
Laboratórium klinickej biochémie a hematológie
Unilabs Slovensko, s. r. o.
Garbiarska 19, 060 01 Kežmarok
Laboratórium klinickej biochémie a hematológie
Unilabs Slovensko, s. r. o.
Sama Chalupku 5, 071 01 Michalovce
Laboratórium klinickej biochémie a hematológie
Laboratórium klinickej mikrobiológie
Unilabs Slovensko, s. r. o.
Špitálska 1, 048 01 Rožňava
Laboratórium klinickej biochémie a hematológie
Unilabs Slovensko, s. r. o.
SNP 1079/76, 075 01 Trebišov









Laboratórium klinickej biochémie a hematológie
Laboratórium lekárskej genetiky
Unilabs Slovensko, s. r. o.
1. mája 2045, 066 01 Humenné
Laboratórium klinickej biochémie a hematológie
Unilabs Slovensko, s. r. o.
M. R. Štefánika 187/177B, 093 27 Vranov nad Topľou
Laboratórium klinickej biochémie a hematológie
Unilabs Slovensko, s. r. o.
Šrobárova 1, 979 01 Rimavská Sobota
Laboratórium klinickej biochémie
Unilabs Slovensko, s. r. o.
Jurkovičova 19, 080 01 Prešov
Patologická anatómia – DCP Košice
Unilabs Slovensko, s. r. o.
Gorkého 8, 040 01 Košice
Patologická anatómia – DCP Prešov
Unilabs Slovensko, s. r. o.
Dilongova 11239, 080 01 Prešov
Laboratórium lekárskej genetiky
Unilabs Slovensko, s. r. o.
Gorkého 8, 040 01 Košice
Ambulancia lekárskej genetiky
Unilabs Slovensko, s. r. o.
Šustekova 2, 851 04 Bratislava
Ambulancia lekárskej genetiky
Unilabs Slovensko, s. r. o.
Horná 67, 974 01 Banská Bystrica
Ambulancia lekárskej genetiky
Unilabs Slovensko, s. r. o.
Janského 1, 052 01 Spišská Nová Ves
Ambulancia lekárskej genetiky
Unilabs Slovensko, s. r. o.
Dilongova 11239, 080 01 Prešov
Ambulancia lekárskej genetiky
Unilabs Slovensko, s. r. o.
Gorkého ulica 8, 040 01 Košice
Ambulancia lekárskej genetiky
Unilabs Slovensko, s. r. o.
1. mája 21, 066 01 Humenné
Ambulancia hematológie a transfúziológie
Unilabs Slovensko, s. r. o.
Garbiarska 19, 060 01 Kežmarok
Centrum hemostázy a trombózy
Ambulancia hematológie a transfúziológie
Unilabs Slovensko, s. r. o.
Šustekova č. 2, 851 04 Bratislava
Centrum hemostázy a trombózy
Ambulancia hematológie a transfúziológie
Unilabs Slovensko, s. r. o.
Prieložtek 1, 036 01 Martin
Centrum hemostázy a trombózy
Ambulancia hematológie a transfúziológie
Unilabs Slovensko, s. r. o.
Jurkovičova 19, 080 01 Prešov
Centrum hemostázy a trombózy
Ambulancia hematológie a transfúziológie
Unilabs Slovensko, s. r. o.
Strojárenská 11/A, 040 01 Košice
Laboratórna diagnostika 69 9
DCP
= Diagnostické centrum patológie


















Laboratórna diagnostika 70
NOVÉ REAL-TIME PCR
VYŠETRENIA V OBLASTI INVAZÍVNYCH MYKÓZ!
Invazívne mykotické infekcie si aj naďalej vyberajú značnú daň na ľudskom zdraví. Včasná diagnostika a rýchle nasadenie antimykotickej terapie sú preto hlavnými faktormi ovplyvňujúcimi prognózu pacientov s invazívnou mykotickou infekciou.
Všetky uvedené vyšetrenia vrátane cieleného kultivačného vyšetrenia pôvodcov invazívnych mykóz a citlivosti na antimykotické zlúčeniny sú dostupné na novej žiadanke spoločnosti Unilabs – Žiadanka o vyšetrenie – Mykológia – Invazívne mykózy.
Najbežnejšími medicínsky dôležitými hubovými patogénmi v zdravotníckych zariadeniach sú popri Candida spp. aj Aspergillus spp., Mucor spp., Pneumocystis jirovecii a Cryptococcus neoformans. Práve na základe uvedeného sme zaviedli rýchlu laboratórnu real-time PCR diagnostiku do portfólia našich mykologických vyšetrení.



AsperGenius® species multiplex PCR
Invazívna pľúcna aspergilóza patrí medzi najčastejšie invazívne mykotické infekcie imunokopromitovaných pacientov a je spôsobená najmä druhom Aspergillus fumigatus. AsperGenius® species multiplex PCR dokáže detegovať všetky klinicky relevantné druhy rodu Aspergillus priamo z klinického materiálu (BAL, likvor, sérum).
PneumoGenius® Real-TM
Pneumocystová pneumónia, závažná pľúcna oportúnna infekcia u imunokomprimtovaných pacientov, najmä u pacientov s HIV, je spôsobená hubou Pneumocystis jirovecii. PneumoGenius® Real-TM dokáže detegovať a kvantikovať P. jirovecii a jeho viackópiový gén mtLSU a jednokópiový gén DHPS fas priamo z BAL-u.
MucorGenius® species multiplex PCR
Mukormykóza je zriedkavá fungálna infekcia s vysokou mierou mortality oslabených pacientov. MucorGenius® species multiplex PCR dokáže detegovať všetky relevantné druhy radu Mucorales vrátane Rhizopus spp., Mucor spp., Lichtheimia spp., Cunninghamella spp. a Rhizomucor spp. priamo z klinického materiálu (BAL, spútum, sérum).
Cryptococcus neoformans® Real-TM
C. neoformans je pôvodcom kryptokokózy u osôb inkovaných HIV a býva charakteristickým ochorením pre AIDS u 60 – 70 % pacientov inkovaných vírusom HIV. C. neoformans Real-TM je určená na kvalitatívnu detekciu DNA C. neoformans z klinického materiálu, ako je likvor, BAL, spútum alebo sérum, a to použitím hybridizačnej uorescenčnej detekcie amplikovaných produktov.
V prípade akýchkoľvek otázok sa môžete
obrátiť na: RNDr. Ing. Ivana Charousová, PhD., vedúca pracoviska klinickej mykológie
Tel.: 0910 738 977
E-mail: Ivana.Charousova@unilabs.com
www.unilabs.sk
AlphaLAB sa mení na Unilabs Pro!
Prečo? Síce meníme názov portálu a aktualizovali sme aj grafické prostredie, ale stále máme na zreteli, aby sa vám pracovalo čo najlepšie. Systém ostáva rovnako pohodlný, ako ste zvyknutí, vrátane obľúbených výhod. Odteraz však máte k dispozícii ešte viac funkcionalít, ktoré vám zrýchlia a zefektívnia prácu.
Od vás pre vás
Návrhy vylepšení pochádzajú od vás. Počas prevádzky AlphaLAB-u sme zbierali vašu spätnú väzbu, aby sme ju implementovali do vylepšeného riešenia.
Zároveň sme odstránili všetky slabé stránky, ktoré vás najviac rušili. Výsledkom je druhá generácia online portálu – Unilabs.pro
Na aké vylepšenia sa konkrétne môžete tešiť? určenie priority pri spracovaní vzorky kombinácia hradených a nehradených vyšetrení na jednej žiadanke vlastné nastavenie prístupového hesla už čoskoro verzia v anglickom jazyku
Prečo Unilabs.pro rozhodne ÁNO?
Ako na to
Aby ste sa v novom prostredí rýchlo zorientovali a objavili všetky jeho výhody, pripravujeme pre vás: Rýchly používateľský návod – stručný návod s navigáciou v základných úkonoch, ktorý môžete mať stále poruke (dostupný v tlačenej forme).
Používateľský manuál – podrobný sprievodca celým prostredím, bude priebežne aktualizovaný (dostupný v elektronickej forme).
Inštruktážne video – rozdelené podľa funkčných prvkov na samostatné kapitoly s názornými ukážkami, ako sa zorientovať v jednotlivých sekciách portálu (bude dostupné na www.unilabs.sk).
Je to bezplatná, moderná a efektívna platforma pre jednoduchší a rýchlejší systém práce v ambulancii. Kedykoľvek a kdekoľvek.
Spoľahlivo a vždy vtedy, keď potrebujete Viac možností personalizácie vašej agendy
Stále bezplatná služba s technickou podporou nášho call centra
Šetrí váš čas v ambulancii, eliminuje administratívu a chybovosť
Obráťte na našich medicínskych reprezentantov, ktorí vám poskytnú všetky informácie a materiály.
Nepoužívali ste AlphaLAB a radi by ste prešli rovno na Unilabs Pro?
Kontaktujte naše call centrum na 0850 150 000 – ozve sa vám jeden z našich medicínskych reprezentantov a dohodne sa s vami na ďalšom postupe.








 časopis o laboratórnej diagnostike | 2. číslo, 11. ročník | jún/2023
časopis o laboratórnej diagnostike | 2. číslo, 11. ročník | jún/2023

























 Pazdera, CSc. Objective Source E-Learning www.osel.cz
Pazdera, CSc. Objective Source E-Learning www.osel.cz






























 motorke prešli
s Ivanom bezpečne takmer celý svet. Osudnou sa im stala bratislavská Petržalka.
motorke prešli
s Ivanom bezpečne takmer celý svet. Osudnou sa im stala bratislavská Petržalka.

 Viacnásobná zlomenina nohy si vyžiadala niekoľko operácií.
Viacnásobná zlomenina nohy si vyžiadala niekoľko operácií.






































































































 MUDr. Zuzana Jedináková, PhD. Hematológ Ambulancia hematológie a transfuziológie Centrum hemostázy a trombózy, Martin Unilabs Slovensko
MUDr. Zuzana Jedináková, PhD. Hematológ Ambulancia hematológie a transfuziológie Centrum hemostázy a trombózy, Martin Unilabs Slovensko